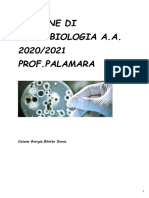

Sbobinature Microbiologia 2012-13
Caricato da
Antonio RizzoneSbobinature Microbiologia 2012-13
Caricato da
Antonio RizzoneMicrobiologia - Medicina e Chirurgia polo A 2012/2013 - sbobinature lezioni
Microbiologia - Medicina e Chirurgia polo A 2012/2013 - sbobinature lezioni
Sommario
Microbiologia lezioni batteriologia ................................................................................................................... 3
Lezione 1 ANALOGIE TRA BATTERIOLOGIA, MICOLOGIA, PROTOZOLOGIA E VIROLOGIA ............................ 3
Lezione 2 ...................................................................................................................................................... 7
Lezione 3 .................................................................................................................................................... 10
Lezione 4 La chemioterapia antimicrobica ................................................................................................ 17
Lezione 5 RESISTENZE AI CHEMIOANTIBIOTICI ........................................................................................... 25
Lezione 6 GRAM-POSITIVI .......................................................................................................................... 31
Lezione 7 .................................................................................................................................................... 37
Lezione 8 .................................................................................................................................................... 44
Lezione 9 I GRAM -NEGATIVI. ..................................................................................................................... 50
Lezione 10 .................................................................................................................................................. 57
Lezione 11 .................................................................................................................................................. 62
Lezioni secondo semestre micologia - ......................................................................................................... 70
Lezione 1 .................................................................................................................................................... 70
Lezione 4 Meccanismi di Patogenicit ........................................................................................................ 73
Lezione 5 .................................................................................................................................................... 80
Lezione 8 .................................................................................................................................................... 94
Lezione 9 .................................................................................................................................................. 103
Lezione 13 Il controllo delle infezioni ....................................................................................................... 108
Lezioni secondo semestre virologia-.......................................................................................................... 114
Lezione 2 .................................................................................................................................................. 114
Lezione 3 DIFFERENZIARE L'INFEZIONE VIRALE DA QUELLA INDOTTA DA ALTRI MICRORGANISMI ......... 123
Lezione 6 Definire la natura dei virus .................................................................................................... 131
Lezione 7 .................................................................................................................................................. 139
Lezione 10 ................................................................................................................................................ 148
Lezione 11 ................................................................................................................................................ 153
Lezione 12 ................................................................................................................................................ 162
Lezione 14 ................................................................................................................................................ 170
Lezioni secondo semestre parassiti ........................................................................................................ 177
Lezione 15 PARASSITI (protozoi) ............................................................................................................... 177
Lezione 16 ................................................................................................................................................ 185
Microbiologia - Medicina e Chirurgia polo A 2012/2013 - sbobinature lezioni
Microbiologia lezioni batteriologia
Lezione 1 ANALOGIE TRA BATTERIOLOGIA, MICOLOGIA, PROTOZOLOGIA E
VIROLOGIA
Che cosa i microbi? Penso che nella vostra vita abbiate avuta lesperienza di uninfezione, abbiate preso
della sostanze antimicrobiche, vi sarete disinfettati in qualche modo.
I microbi sono delle entit unicellulari, o perlomeno, unicellulari sono:
- i batteri che hanno una cellula procariote
- i funghi
- i protozoi
- non hanno cellula e sono delle entit totalmente differenti i virus.
Oggi ci dedichiamo a parlare di quali sono le analogie tra queste branche: batteriologia, micologia,
protozologia, virologia.
Microbo cosa significa? Micro=piccolo, bios=vita quindi la pi piccola parte di materiale vivente.
E quali sono le funzioni del materiale vivente? Nascita, crescita, riproduzione e morte; e per quello che
riguarda le cellule (batteri, funghi e protozoi) osserviamo tutte queste caratteristiche, sono cellule come
tante altre con il loro metabolismo e le loro caratteristiche.
I virus, invece, non hanno nessuna di queste funzioni: non nascono, non crescono, non si riproducono, non
muoiono. Per i virus si usano termini particolari: si replicano e di affine con il materiale vivente hanno solo
una caratteristica essenziale: la possibilit di mutare . I virus sono parassiti endocellulari obbligati.
Quello che accomuna batteri, funghi e protozoi la capacit di causare infezioni. Ma mi sono trattenuta nel
dire infezioni nelluomo, tant vero che tutti i libri di testo sono microbiologia medica. Noi siamo in
medicina e studiamo una piccola componente dei microbi che con luomo stabiliscono dei rapporti,
vedremo quali: positivi, negativi, parassiti, ovvero se hanno rapporti di simbiosi o parassitismo con luomo;
ma sono una piccola fetta di tutti i microrganismi che troviamo nellambiente esterno.
I batteri
I batteri, per causare infezioni nelluomo, devono essere adattati a vivere nelluomo, ovvero ad utilizzare i
tessuti umani, la temperatura umana , le sostanza presenti nelle cellule umane; ma se pensiamo, sono
pochi nel complesso di tutti i batteri esistenti, quelli che hanno queste caratteristiche. Noi viviamo ad una
temperatura di 36/37 e quindi studiamo quei batteri che vengono detti mesofili che crescono tra i
22/25-40/44 (addirittura un piccolo settore di quelli mesofili! Perch, per altro, abbiamo batteri che
crescono nei ghiacci, nei surgelatori, a 80, nelle fonti termali, ma sicuramente non ce li troveremo in
medicina perch non possono adattarsi allambiente uomo). Analogamente il ph umano compreso tra
7,35-7,45, per cui un limite molto ristretto e troveremo batteri che vivono a pH 1, ma non avranno
minimamente alcun impatto con luomo perch non trovano le condizioni per causare infezioni. La stessa
cosa si pu dire per la pressione atmosferica, per lossigeno, noi siamo adattati ad una certa tensione.
Microbiologia - Medicina e Chirurgia polo A 2012/2013 - sbobinature lezioni
Quindi la microbiologia medica studia i microrganismi che hanno solo rapporti con luomo.
La microbiologia studia, per altro, le infezioni nelle piante, le applicazioni che si fanno dei batteri, tanti
aspetti della scienza di oggi; ma un settore quello che riguarda noi come medici. Infatti, nel momento in
cui dobbiamo osservare questi batteri in laboratorio, dobbiamo fornire proprio le sostanze e le condizioni
che trovano nelluomo; quando studierete tutti i capitoli del vostro testo, troverete batteri che vengono
incubati a 37, un motivo c! Se tutti i terreni di coltura avranno un pH molto limitato, un motivo c!
Quindi quello che riguarda la coltivazione, e che vedremo, prende spunto dal fatto che dobbiamo ricreare
in laboratorio le stesse condizioni che questi batteri trovano nel corpo umano.
I microrganismi eucarioti
Miceti e protozoi sono microrganismi eucaryoti, ovvero hanno un nucleo ben delimitato e che ha molti
cromosomi. Vi ricorderete che al regno vegetale appartenevano i funghi, al regno animale i protozoi. Sono
cellule eucariote entrambe, per, qual la differenza di significato della presenza di questi microrganismi in
patologia medica?
I funghi
Che cosa avevano di differente i funghi (funghi o miceti lo stesso termine) dalle altre piante? Perch
hanno, per altro, una struttura vegetale, hanno la parete vegetale, hanno delle sostanze che non sono
presenti nelle cellule animali (addirittura quelli filamentosi si poggiano su un substrato, le muffe, infatti
alcune muffe sono importantissime in medicina). Ma qual il significato dei funghi? Quali sono le
condizioni che favoriscono la presenza dei funghi? O delle muffe nel mondo esterno? Lumidit e il calore.
Dove nascono i funghi? Ovunque. Dove crescono le muffe? Dove ci sia umidit, calore e sostanze nutritizie.
Anche i funghi umani hanno questo carattere di opportunismo. Quindi nascono e crescono laddove trovano
condizioni metaboliche adatte e di carente immunit.
Anche qui la maggior parte dei funghi non li abbiamo in medicina, abbiamo solo tra i lieviti, la candida (ma i
lieviti incidono nel mondo esterno per tutti gli alimenti che siamo abituati a mangiare, vino, birra, aceto,
pane, pizza ecc). Le muffe ce ne sono 2-3 importanti in medicina; per se c una causa di morte per i
soggetti HIV positivi in cui subentra lAIDS, sono proprio le infezioni da candida allesofago o tutte le
infezioni sistemiche da funghi e proprio questi funghi vivono nellambiente esterno senza causare infezioni.
Ovviamente ( e cos mi aggancio a protozoi) sono cellule eucariote.
Qual il significato genetico di una cellula eucariota? Come si riproduce?
Si riproduce normalmente per mitosi e la riproduzione sessuale, gamica si effettua per meiosi ed essendo
organismi eucarioti anche i miceti hanno questa alternanza di ciclo, specialmente le muffe, quindi hanno la
fase sessuata e la fase asessuata (le spore funginee rientrano in uno dei due cicli fondamentali; anche nei
funghi pluricellulari vediamo , nelle lamelle, le spore). Quindi anche i funghi hanno questa necessit e i cicli
sono molto complessi e , per altro, sono cellule molto grosse per cui con un normale microscopio ottico
possiamo avere molte informazioni.
I protozoi
La stessa cosa dicasi per i protozoi che sono, come dice la stesa parola, il gradino pi basso degli animali e
come gli animali si nutrono, hanno alternanza di ciclo gamico ed agamico, nellambiente esterno hanno un
significato importantissimo. Tanto per fare un esempio: il termine depuratore biologico cosa significa?in
Microbiologia - Medicina e Chirurgia polo A 2012/2013 - sbobinature lezioni
natura i protozoi si nutrono di batteri. (la prof ha lasciato il discorso in sospeso ) Mentre le muffe sono
ferme con il loro substrato, i protozoi sono mobili, pertanto, in medicina, il ciclo gamico ed agamico va
considerato come cisti, come presenza di cellule con determinate funzioni che assicurano la possibilit che
la cellula di divida per via aploide e diploide. ( secondo me questa frase non ha senso.. a vostra
interpretazione!)
Ci sono per i protozoi adattati alluomo in cui notiamo questa alternanza di cicli e sono protozoi molto
caratteristici, pericolosissimi, alcuni di importanza sociale tipo: il plasmodium che lagente etiologico della
malaria e vive tra ospite zanzara e ospite uomo ( in uno ha un ciclo e nellaltro ne ha un altro); il toxoplasma
ha anchesso alternanza di cicli e di cisti ed di grande interesse nei muscoli e anche nelle lettiere dei gatti,
in gravidanza, basti pensare alla diagnostica degli agenti TORCH, tra cui c il toxoplasma; nella malattia del
sonno, la quale legata alla circolazione di un dittero, una mosca causa torpore e per questo motivo
detta malattia del sonno; tale mosca veicola un protozoo, appartenente al flagellati (i quali vanno nel
sangue e per questo chiamati emoflagellati tra cui abbiamo la leishmania e il tripanosoma, tutte infezioni
comunque legate a climi tropicali e alla circolazione di insetti che vivono in quei climi), con una grande
geograficit perch legato al movimento della mosca; infine ci sono i protozoi opportunisti ad es. il
pneumocystis e pneumocystis opportunista sono importanti in soggetti immunodepressi perch non hanno
un tipo di immunit che contrasta miceti e protozoi). Anche i protozoi li osserviamo molto bene al
microscopio.
La parassitologia comprende:
-
Parassiti unicellulari che sono i protozoi;
Parassiti pluricellulari che sono tecnicamente anche i topi, scarafaggi, parassiti dellambiente e
come parassiti umani abbiamo tutti i vari vermi (ascaridi, tenie ecc.) e gli insetti (pidocchi, cimici, scabbia,
acari ecc.)
I parassiti pluricellulari, teoricamente, non appartengono alla microbiologia, per, siccome oggi rientrano
nei programmi della parassitologia, la microbiologia estende le sue competenze pure allo studio di questi
organismi. Tant vero che, mentre per miceti, batteri, protozoi e virus usiamo il termine disinfettare, per i
parassiti pluricellulari usiamo il termine di disinfestazione e in ogni caso cambia limpostazione.
Altra componente della microbiologia sono i virus
I virus
Che storia hanno i virus? E come abbiamo visto la loro presenza? Con il microscopio elettronico. Datiamo
questi organismi:
-
I protozoi furono visti dagli studiosi olandesi per la prima volta nelle pozzanghere nel 600/700
Per poter vedere i batteri, il microscopio si dovuto evolvere!
Il massimo potere di ingrandimento del microscopio ottico 1000, ovvero vediamo di 1 mm un
microrganismo che ha le dimensioni di 1 e lo vediamo con artefizi particolari. Da tutto ci capiamo che
visualizzare i batteri col microscopio ci da poche informazioni e pertanto, quando studieremo i batteri, in
tutto questo primo semestre, si parler di coltivarli, ovvero mettendoli in terreni adeguati in laboratorio e
facendoli moltiplicare.
Microbiologia - Medicina e Chirurgia polo A 2012/2013 - sbobinature lezioni
Per i virus il discorso diverso. Infatti non sempre abbiamo il microscopio elettronico, per cui i virus devono
essere coltivati sulle cellule e la loro presenza la valutiamo solo per il fatto che la cellula ne subisce un
danno. Per cui o si fa lo studio sugli effetti citopatogeni dei virus in laboratori di microbiologia specializzati,
oppure la diagnostica virologica oggi si fa su altri presupposti che sicuramente non sono la coltivazione ( la
diagnostica la faremo lanno prossimo nellambito della medicina di laboratorio). Quindi coltivazione e
isolamento si utilizza solamente per i batteri perch non abbiamo modo, altrimenti, di studiarli. Per i virus
le indagini sono diverse, nel senso che cerchiamo di vedere nelluomo la risposta anticorpale da virus.
Il microscopio elettronico arriva ad ingrandimenti enormi e visualizza anche i virus ( vedi immagini con il
microscopio a scansione nelle prime slides) ( vedi immagini che sono le prove che i batteri sn antecedenti
alluomo)
I globuli bianchi servono nei rapporti con i batteri, per la fagocitosi ( immagini)
(immagini dellescherichia coli)
(immagine di cellula batterica e virus)
Nonostante la differenza di dimensioni questi microrganismi hanno in comune delle armi e il fatto che
devono instaurare dei rapporti col nostro organismo. Ciascuno infatti trova le condizioni migliori per
causare patogenicit: i batteri ne utilizzeranno alcuni, i protozoi altri e i virus altri ancora. Ma in generale
tutti questi microrganismi nel loro complesso causano infezione, ovvero penetrano nellorganismo
attraverso diverse vie, poi che siano funghi, protozoi, batteri o virus, avremo momenti potogenetici
differenti, ma le vie di penetrazione sono sempre quelle.
La diagnostica
Quali sono le vie attraverso le quali i microrganismi vengono in rapporto con lorganismo?
-
La pelle a seguito di morsi, punture dinsetti, tagli, punture accidentali;
Via aerea come il raffreddore, la meningite, linfluenza, la tubercolosi, la triptococtosi;
Apparato digerente ad es. il colera, la dissenteria, la poliomelite;
Via sessualmente trasmessa ed es. sifilide, gonorrea, candida, i papillomi, gli herpes genitali.
La terapia
La terapia per tutti gli organismi della microbiologia si chiama chemioterapia antimicobica:
-
Gli antibiotici sono la chemioterapia contro i batteri;
Chemioterapia antifunginea studia farmaci attivi contro i funghi;
Chemioterapia antiprotozoaria studia farmaci attivi contro i protozoi;
Chemioterapia antivirale studia farmaci attivi contro i virus.
La prevenzione
Un termine sinonimo di prevenzione, ma non in microbiologia profilassi.
Microbiologia - Medicina e Chirurgia polo A 2012/2013 - sbobinature lezioni
La profilassi pi immediata, la prevenzione quella che si fa nella popolazione per esempio i vaccini e di
vaccini ce ne sono sia batterici (ci sono ad esempio i vaccini obbligatori che si fanno nellinfanzia e che
hanno scardinato numerose malattie) che virali (sono la maggior parte ad es. contro la poliomelite, la
pertosse , il morbillo, la varicella, lepatite,ecc ), non abbiamo vaccini funginei perch sono opportunisti, per
qualche protozoo invece ci sono.
Quindi il momento di prevenzione uguale per tutti anche se i vaccini batterici sono centenari, basti
pensare a Pasteur, mentre quelli virali sono molto recenti.
Breve cenni storici:
A quando risale il primo isolamento di un batterio? Alla seconda met del XIX secolo quando un certo Koch
copr il carbonchio e la microbiologia si evoluta da allora. La virologia, invece nata molto dopo, a seguito
della scoperta dellacido nucleico negli anni 50. Se il termine virus significa veleno perch studiando i
batteri, queste entit patogene sfuggivano ai primi scienziati, non le riuscivano a vedere e quindi sono
relativamente nati ieri. Quindi per i batteri abbiamo 120-130 anni di conoscenza e visualizzazioni al
microscopio, per i virus meno, ma le malattie in microbiologia sono vecchie quanto il mondo (ad es. la
lebbra, il vaiolo, la poliomelite, la peste, la sifilide solo che allora non si conosceva la causa etiologica e si
attribuivano allintervento divino, streghe, fatture, esiti di guerra).
Come scienza la microbiologia potuta esistere quando il primo scienziato, Koch per lappunto, ha potuto
visualizzare il primo batterio, il bacillo del carbonchio. Il carbonchio era uninfezione delle mucche che,
chiaramente, economicamente aveva molti riflessi.
La riabilitazione
Di riabilitazione in microbiologia ce n poca.
Relazione tra microbiologia, patologia e immunologia
Linfezione non altro che un equilibrio come due piati di una bilancia tra difese immunitarie e batteri.
Quanto pi sono carenti le difese dellorganismo, tanto pi il microbo pi banale pu causare infezione. Le
condizioni nelle quali le difese immunitarie sono carenti sono rappresentate dalla chemioterapia
antitumorale, terapie immunosoppressive, trapianti, HIV, pazienti ematologici, ma non solo, neonati,
bambini, anziani, malati, donne in gravidanza, soggetti con diabete, cardiopatici, ovvero la maggior parte
dei soggetti che vengono osservati in un qualunque ambulatorio medico o ospedale.
La microbiologia studia, per definizione, i microbi patogeni veri e propri, le malattie infettive classiche, ma,
oltre le malattie infettive classiche, ci sono tutte le malattie da infezione che si riscontrano oggi in relazione
alle condizioni immunitarie dei soggetti. Quindi la microbiologia deve essere sempre tenuta in
considerazione in relazione alla patologia generale.
Lezione 2
La batteriologia speciale lo studio delle diverse famiglie di microrganismi, come cocchi e bacilli, talvolta
incontriamo gli spirilli tipo elicobacter pilori, vibrione colera. Unaltra forma che studieremo sono le
spirochete che hanno caratteristiche diverse dalle altre.
Come si dividono i batteri? I batteri hanno 1 solo cromosoma e si dividono per scissione binaria e la
scissione un processo di divisione del cromosoma in due parti, laddove sia miceti che protozoi hanno
Microbiologia - Medicina e Chirurgia polo A 2012/2013 - sbobinature lezioni
necessit di avere due divisioni: sessuata, asessuata, apolide diploide; i batteri si dividono per scissione
binaria.
Inizia il setto traverso e da 1 cellula se ne hanno due. il setto inizia da un punto della membrana che il
mesosoma che anche sede degli enzimi respiratori per i batteri che respirano. Si apre il DNA e
immediatamente viene rimpiazzato dal nuovo DNA di formazione.
A seconda di dove viene posto il setto di divisione i batteri hanno diversi stadi di
aggregazione. Se si dividono al centro si chiamano diplococchi, se si dividono in
questo modo (indica limmagine) avremo una collana di cocchi ovvero streptococchi
se si dividono in modo disordinato avremo stafilococchi.
I bacilli anche questi si aggregano, a secondo che si aggregano dal lato lungo o
dallestremit li chiamiamo streptobacilli, a mazza di sigari, a palizzata, e se sono
scomposti a lettere cinesi.
A cosa devono la forma i batteri? devono la loro morfologia allinvolucro
esterno che la parete cellulare. Una sola famiglia esiste tra i batteri che non
possiede parete sono i micoplasmi. La loro forma come goccioline grasse che
assumono forme diverse e si chiamano pleomorfi.
Per convenzione alcuni batteri sono rossi alcuni sono blu. Deriva tutto dalla
colorazione di GRAM. importante perch condiziona la sensibilit agli
antibiotici, la crescita, limmunit nelluomo, la patogenicit dei germi che si
mantiene questa differenza. La colorazione la sapete e la possiamo saltare,
anche la cellula la salter. Il DNA piccolo rispetto al nostro, ma si adatta a tutti gli ambienti. Farmaci
sostanze chimiche alimentazioni mondiali esiste perch c la possibilit genetica dei batteri.
Il DNA costituito dal cromosoma che si addensa quando si deve riprodurre la cellula, diventa cromatina
quando la cellula in fase di metabolismo, ci sono pezzi di cromosoma fuori. Quindi il cromosoma
organizzato in cromosoma e frammenti singoli autonomi chiamati plasmidi che li vedremo importantissimi
nei fenomeni di resistenza agli antibiotici, frammenti che conferiscono patogenicit ai batteri. Ribosomi li
sappiamo, i ribosomi batterici differiscono per le dimensioni rispetto a quelli umani. La sintesi proteica
frenetica nelle cellule batteriche. La cosa importante la presenza del mesosoma. Nel batterio che ha il
mesosoma la funzione della cellula anche la divisione della membrana cellulare e la respirazione.
La cosa importante esternamente la parete cellulare che costituita da una molecola di
acetilglucosamina pi una molecola di acido N acetil muramico e linsieme dei due il peptidoglicano. Se
volessimo studiare la formula chimica ci sono formule lunghe ma la cosa importante che tra catena
peptidica del peptidoglicano e laltra si allunga una catena di 5 zuccheri (nb. Dal Murray ho letto che la
catena di 4 amminoacidi Ale Bella) che fanno da collante.
Come si forma il peptidoglicano? Fa vedere un filmatino...quello che abbiamo visto con il filmatino succede
nella cellula. Se vogliamo essere pi precisi, la formazione 5 aminoacidi una molecola si perde per
formare energia, si forma il peptidoglicano. Il peptidoglicano da la forma alla cellula soprattutto contrasta
la differenza osmotica. La pressione osmotica dentro i GRAM negativi 4 volte pi grande rispetto ai
GRAM positivi e quindi previene la lisi osmotica. Il batterio se allesterno trova un ambiente ipotonico
perch ha elevata pressione osmotica si rigonfia e muore quindi la parete ha una importante sistema per
consentire di sopravvivere in un ambiente ipotonico come pu trovare nelluomo.
Microbiologia - Medicina e Chirurgia polo A 2012/2013 - sbobinature lezioni
Per la parte antigenica seguitemi un attimo! come vedete c membrana citoplasmatica e parete cellulare
attraversata da sostanze che si chiamano acidi teicoici e acidi lipoteicoici che saranno responsabili delle
differenze tra ceppo e ceppo dei due determinanti antigenici che fanno riconoscere come diverso il
microrganismo, quindi sono prevalenti proteine. Come tutti gli antigeni i lipidi non sono immunogeni quindi
sono in genere di natura polisaccaridica. Il trasporto nei batteri GRAM positivi avviene in modo pi
rallentato rispetto ai GRAM negativi.
Nei GRAM negativi invece questo strato spesso
diventa invece sottilissimo, questo strato si trova
esternamente alla membrana citoplasmatica e
oltre questo strato c unaltra membrana
lipopolisaccaridica. Quindi la parete dei GRAM
negativi ha peptidoglicano ed esternamente ha una
doppia membrana citoplasmatica. Il fatto che sia
sottile significa avere pressione minore e i GRAM
negativi li troviamo pi facilmente nellambiente,
nei disinfettanti, nellacqua, hanno una vita molto
pi semplice.
A cosa affidato lo scambio delle sostanze? alle porine, sono regolate da complessi meccanismi che le
fanno allargare o stringere in relazione alla maggiore o minore permeabilit. Questa membrana ancora
grazie alle proteine di Brown ,spazio periplasmico esterno e spazio periplasmico interno. La cosa
importante dei GRAM negativi che questa membrana lipopolisaccaridica che fa parte della parete ha
strutture molto caratteristiche, la parte esterna sono catene laterali specifiche cio con una funzione
antigene, quindi antigene somatico dei batteri GRAM negativi.
gli antigeni sono di tre tipi. la cosa importante dei GRAM negativi che internamente si chiama
lipopolisaccaride o lipide A ed il costituente quello che conferisce patogenicit ai GRAM negativi. Nella
membrana esterna lipopolisaccaridica abbiamo delle strutture esternamente antigene somatico
internamente il lipide A. questo lipide A viene definito anche endotossine e in tutti i GRAM negativi gi da
solo basta per conferire patogenicit. il termine endotossine in contrapposizione ad esotossina. Le
esotossine sono prodotte, le endotossine sono costitutive del batterio. Nel GRAM negativo la patogenicit
data dal lipide A ed esotossine. Il lipide A, c un core con sostanze differenti e terminazioni
polisaccaridiche diverse da germe a germe che rendono ragione dellantigenicit.
Che funzioni ha la membrana esterna? la membrana delimita lo spazio periplasmico evita la fagocitosi
costituisce una barriera a numerosi agenti tossici. I GRAM negativi vivono nellambiente esterno anche i pi
ostili. Le porine possono essere selettive o non selettive, si aprono e si chiudono con fibre elastiche e cos
via. Il peptidoglicano batterico c n filamtino che fa vedere la differenza fra GRAM posiviti e GRAM negativi
con strato piccolo elastico con le porine che si aprono.
Cosa ha il batterio esternamente? ancora pi esternamente della parete c la capsula con vari stati di
aggregazione nel senso che pu essere una capsula dura o spessa o uno strato mucoso (nel capitolo strato
mucoso c il capitolo della produzione del biofilm che condiziona tutta una branca che microbiologia
delle protesi legata al consumo di resine di polimeri con maggiore o minore possibilit di fare crescere il
biofilm, pensiamo ai cateteri, alle protesi). La capsula di natura polisaccaridica come anche lo strato
mucoso ,gelatinoso o anche i biofilm. La capsula facilita ladesivit, la capsula si oppone alla fagocitosi in un
certo senso nasconde il batterio e opponendosi alla fagocitosi unarma in pi. la capsula anche da un
Microbiologia - Medicina e Chirurgia polo A 2012/2013 - sbobinature lezioni
10
punto di vista antigenico un altro antigene, quindi lantigene somatico lantigene O, lantigene capsulare
il K. Ci spieghiamo perch laccrescimento sia cos
rapido.
Altra parte che riguarda i batteri sono i flagelli gli organi di
movimento. I flagelli possono essere 1, un ciuffo
(lofotrichi) possono essere due ciuffi o possono essere
tanti attorno al corpo batterico come molti enterobatteri
si chiamano peritrichi. I flagelli hanno movimento
vorticoso e serve a spostarsi velocemente in un liquido
quindi solamente rotatorio e non ondulatorio.
costituito da flagellina con rivestimento esterno e
linserzione corpo basale cambia a seconda che sia un GRAM positivo o negativo. Poi abbiamo fimbrie. Le
fimbrie servono per ladesivit alcune fimbrie si chiamano pili F. si chiamano pili fertilit che sono organelli
che consentono di scambiare materiale genetico conferendo resistenza. La cosa importante che ciglia e
flagelli meglio anzi i flagelli sono sede di un altro antigene che lantigene H. Si chiama H perch il
materiale in cui cerano flagellate formavano una pellicola che in tedesco si chiama haut.
Lezione 3
Premessa
Virus, batteri, miceti e protozoi hanno in comune il fatto che possono causare delle infezioni. Il controllo, la
prevenzione, il concetto di chemioantibiotico terapia sono comuni a tutte e quattro le discipline della
microbiologia. Per cui gli argomenti generali vengono trattati in batteriologia.
Vaccinazione
Cosa sono i vaccini?
Servono a stimolare limmunizzazione contro un determinato antigene. Nellambito del controllo delle
infezioni vi il settore dei vaccini e dei sieri.
1. IMMUNIT NATURALE ATTIVA: In natura normalmente se si ha una malattia, che ha un certo
decorso (decorso acuto, cronico o fulminante),se il decorso non fulminante, luomo supera la
malattia e lorganismo sviluppa gli anticorpi ( limmunit naturale attiva).
Quale l immunit naturale passiva?
2. IMMUNIT NATURALE PASSIVA: Sono gli anticorpi che passano in maniera verticale dalla madre al
figlio; ovvero l acquisizione naturale di anticorpi gi formati. Invece nellimmunit naturale attiva e
lorganismo che forma anticorpi a seguito della malattia.
La stessa immunizzazione che avviene naturalmente si chiama acquisita se si danno dallesterno le sostanze
per limmunizzazione stessa. Si divide anche in questo caso:
1. Immunizzazione acquisita passiva: se si forniscono gli anticorpi gi preformati ( ad esempio la
globuline, le immunoglobuline). In questo caso si parla di siero che pu essere o umano, per cui si
parla di siero omologo, o da animali e in questo caso il serio eterologo. Si forniscono anticorpi
preformati contro un determinato antigene: per lo pi si forniscono immunoglobuline contro
Microbiologia - Medicina e Chirurgia polo A 2012/2013 - sbobinature lezioni
11
malattie gravi come tetano, botulismo, rabbia o epatite. Questo perch gli anticorpi immunizzano
subito.
2. Immunizzazione acquisita attiva: se si forniscono antigeni dallesterno per stimolare lo sviluppo di
anticorpi. La vera e proprio vaccinazione.
Il termine vaccinazione un termine molto antico che risale ai primi del 1700 quando Jenner ( un medico
che viveva per strada). Allepoca la malattia che decimava era il vaiolo ( deturpava visi, volti).
Jenner osserv che chi aveva avuto il vaiolo ( la mattia endemica) e lo superava pur avendo il volto
deturpato era immune alle malattie successive. Ci doveva essere qualcosa che determinava questa
immunizzazione. Si accorse che il liquido preso dalle pustole creava lo stato di immunit in un altro
individuo se a questo si somministrava.
Il termine vaccino deriva da vacca in quanto il virus vaiolo che infettava le vacche era meno pericoloso di
quello umano.
Quali sono i pro e i contro dellimmunizzazione acquisita attiva e passiva o vaccinoprofilassi e
sieroprofilassi?
I pro della sieroprofilassi che subito gli anticorpi, che vengono dati allorganismo, possono essere usati
ma essendo esogeni vengano altrettanto subito degradati. Non vi memoria, un kit di pronto soccorso.
Limmunit acquisita attiva ( pur con schemi posologici differenti) permane per tutta la vita ( ci sono
richiami, si pu potenziare lattivit di queste cellule immunologiche). Ma lo svantaggio sia che non
rapida sia che si pu fare la somministrazione del vaccino solo se si in condizioni di salute ottimali.
Che differenza c tra vaccino e siero?
SIERO: del siero si parlato molto negli anni 80 quanto sono state scoperti le epatiti o lHIV. Vi
erano pool di sangue di volontari da cui trarre le immunoglobuline e somministrarle. Ma ancora
molti virus e batteri non si conoscevano per cui molte trasfusioni e sieroprofilassi hanno causate
altre malattia. Questo ha fatto si che oggi sono somministrate le antitetaniche o le
immunoglobuline con minore leggerezza. Prima se si cadeva subito si somministrava lantitetanica.
Allargomento della sieroprofilassi appartiene anche quello sugli anticorpi monoclonati.
La sieroprofilassi utilissima per malattia gravi.
VACCINI: vi sono vaccini preparati con batteri , con virus e alcuni con protozoi.
Vi sono tre tipologia di vaccini perch essendo degli antigeni dobbiamo essere sicuri che gli antigeni non
causano la malattia pur svolgendo funzioni antigeniche ( ad esempio il virus della poliomielite). Vi sono tre
casi:
1. il vaccino inattivo morto o denaturato;
2. il vaccino vivo ma attenuato nella sua patogenicit:
3. i vaccini ricombinati formati in laboratorio con tecniche biomolecolari ( come quello contro
lepatite).
Microbiologia - Medicina e Chirurgia polo A 2012/2013 - sbobinature lezioni
12
Prima vi era il vaccino di Salk: un virus ucciso ma posto in delle cellule manteneva le sue caratteristiche
antigeniche. Dopo vi fu il vaccino di Sabin : un vaccino vivo che per questo era molto pi efficace, avendo
maggiore memoria, durata, e tollerabilit ( ad esempio il vaccino antipolio vivo ma attenuato nella sua
patogenicit grazie a dei determinati sistemi).
Consideriamo vaccino morto
Ad esempio quello antipolio somministrato allinfanzia. Lantigene ucciso la struttura cellulare distrutta
con mezzi fisici ( temperatura) o con mezzi chimici ( acido formico, formolo); Vengono distrutti o la cellula
stessa, o parti della cellula batterica , o prodotti della cellula cio le tossine di batteri ( tossina tetanica,
batteriche con dosi letali molto elevati). Le tossine non vengono somministrate normalmente ma viene
inattivata e diventa tossoide.
VACINAZIONI OBBLIGATORIE IN ITALIA
vaccino antitetanica:
vaccino antidifterico:
entrambe sono tossine denaturate.
vaccino antipolio:
vaccino antiepatite B per i bambini.
La normative sulla vaccinazione derivano da norme sanitarie che possono essere diverse fra i vari stati a
secondo delle condizioni di un paese. Ad esempio in brasile obbligatorio il vaccino contro la febbre gialla.
Se si va in brasile per due anni meglio farla.
Se si deve andare in India per molto tempo necessario fare il vaccino anticolera. In Europa vi sono degli
schemi vaccinali che possono essere recepiti dal ministero della salute o dalla regione Sicilia ( che regione
a statuto speciale).
In Italia quelle consigliate sono: anti pertosse, antimorbillo o anti-menengite, anti- pneumococco.
Vi sono poi quelle consigliate in certe situazioni ad esempio:
Vaccino anti peste per chi lavora con le pelli di animali come i veterinari . Hanno a che fare con
malattie gravi causate da contatto stretto con animali malati; sono dette malattie zonose.
Vaccino Antiturbercolare che interessa chi lavora in ambito sanitario se gli accertamenti
dimostrano che lindividuo non immunizzato dal germe tubercolare.
Vaccini antiinfluenzali sono consigliati per gli anziani;
Antiemofilus;
Antirosolia ( per le donne in quanto la rosolia diventa grave per le donne gravide). Bisogna
somministrarle prime di una gravidanza.
Microbiologia - Medicina e Chirurgia polo A 2012/2013 - sbobinature lezioni
13
Vaccini attenuati: ad esempio quello della tubercolosi; viene usato il ceppo di che Calmette-Gurin. Il
batterio perde la patogenicit passandolo 230 volte in un terreno apposito pur mantenendo le sue
caratteristiche antigeniche.
Come si attenuano?
Sono mutanti ottenuti con modificazione di alcune caratteristiche metaboliche e di alcune caratteristiche
della cellula batterica.
Vaccini ricombinanti
I vaccini antivirali sono molto di pi; sono quelli che sfruttano la ricombinazione genetica. Si utilizzano
frammenti responsabili di patogenicit come vaccini e immunogini.
Il vaccino per lepatite b obbligatoria ovviamente non difende da epatite c o A ne dallHIV. I vaccini per
lHIV non sono stati ottenuti ma si stanno studiando delle tecniche ricombinanti.
La vaccinazione una materia antica ma sempre aggiornata. La scoperta di un nuovo vaccino un evento
che si sente spesso in TV.
Perch non lascia immunit il vaccino antiinfluenza?
Perch i patogeni dellinfluenza variano sempre per cui i nuovi ceppi non possono essere trattati con i
vaccini dellanno prima i quali erano contro un ceppo diverso. Limmunit per quel ceppo ( quello dellanno
precedente) rimane ma il ceppo cambia.
Prima vi unepidemia, poi si isola il patogeno, si coltiva, si attenua, si prepara il vaccino, si imbottiglia e si
distribuisce. Ma passa un anno, quindi il tempo che ci vuole per preparare un vaccino molto spesso non
combacia non la nuova epidemia per cui il vaccino non pi valido a rispondere ai virus che hanno mutato
il loro RNA e sono diversi dal punto di visto antigenico. Questo fa si che i vaccini antiinflenzali sono
preparati ogni anno contro un nuovo ceppo. Cosa che non per il colera, per tubercolosi, per la rabbia e in
generale per gli altri vaccini.
Vaccino antitifico : durava un anno e lo facevano i ragazzi che facevano il militare perch le occasioni per
prendere la salmonella erano numerose.
(Gli aspetti immunologici dei vaccini si fanno in immunologia noi facciamo gli aspetti microbiologici).
Abbiamo detto che in microbiologia sono presenti microorganismi che sono in grado di alterare le difese
dellorganismo, larma che causa le infezioni. Le strategie messe in atto dai virus sono diversi da quelle
messe in atto dai protozoi, dai miceti, o dai batteri. Le infezioni sono comune a tutti i microorganismi e le
vie di trasmissione sono varie. chiaro che il modo di comportarsi dei batteri diverso da quello degli altri
microorganismi.
Consideriamo i batteri
Patogenicitt dei batteri:
Un batterio si definisce patogeno quando capace di invadere i tessuti di un organismo e di moltiplicarsi
danneggiando il normale funzionamento
Microbiologia - Medicina e Chirurgia polo A 2012/2013 - sbobinature lezioni
14
Cosa ci vuole per avere queste armi?
Il batterio si deve moltiplicare: ovvero deve colonizzare un distretto.
Deve elaborare sostanze in grado di essere dannose: le tossine. Non sono solo la neurotossina
tetanica ma anche le citotossine capaci di danneggiare le cellule vicino al batterio.
La colonizzazione o moltiplicazione dipende da altri fattori:
prima di moltiplicarsi il batterio deve evadere le difese antibatteriche per lo pi aspecifiche
come il flusso dellurina o le ciglia del apparato respiratorio o la peristasi intestinale.
Successivamente deve colonizzare le mucose.
Il batterio deve poter penetrare sempre pi in fondo
Come fa a penetrare pi in fondo?
Delladesivit ci basta sapere che vi sono le adesine.
Per quanto riguarda la penetrazione nei tessuti invasivi i batteri per esprimere la loro patogenicit devono
ledere le cellule. Alcuni hanno proteine che ledono le cellule ospiti.
Le sostanza che fungono da armi (citotossine o esoenzimi) sono caratteristiche di certi microrganismi; ad
esempio gli stafilococchi hanno le lipasi, fosfolipasi, coagulasi ,desossiribonucleasi, proteasi, ribonucleasi,
permeasi, enzimi che consentono alla cellula di fare un varco allinterno della cellula ospite.
Quale lobbiettivo dei microorganismi ?
giungere nel sangue per distribuirsi ai vari tessuti. Se mancassero le difese dellorganismo il
microorganismo arriverebbe nel torrente ematico da dove pu giungere ai vari organi e causare degli shock
che possono portare a morte.
Da una parte le difese lo impediscono ma dallaltro lato vi sono i microorganismi che cercano di raggiungere
il loro obbiettivo.
Meccanismi di invasivit che consentono di invadere le cellule e i tessuti circostanti.
I meccanismi che permettono di evadere le difese si faranno in immunologia ad esempio la capsula e la
formazione dello slive ( non so cosa sia)
Dopo che i batteri penetrano devono moltiplicarsi: dove?
O si moltiplicano dentro le cellule o negli spazi tra cellule e cellula.
Questo importante per gli antibiotici in quanto alcuni devono penetrare dentro le cellule per i batteri
intracellulari mentre altri non necessitano di penetrare la membrana cellulare.
Batteri intracellulari
I batteri che penetrano possono:
Essere obbligati a vivere dentro le cellule come le Clamidiae le Richettsie
Microbiologia - Medicina e Chirurgia polo A 2012/2013 - sbobinature lezioni
15
altri prediligono dentro le cellule ( come le brucelle che attaccano il sistema del reticolo
endoteliale).
Altri si trovano transitoriamente dentro le cellule.
Le salmonelle occasionalmente a secondo delle esigenze sono capaci di penetrare nelle cellula della
sottomucosa dellintestino.
ENDOTOSSINE
A parte le esotossine ( che sono le vere tossine) abbiamo come patogenicit dei batteri intracellulari le
endotossine. Le endotossine fanno parte della parete cellulare, il lipide A. Il lipide A , presente nel foglietto
interno della membrana esterna liposaccaridica dei gram-negativi ha unelevata tossicit.
Ad esempio possiamo considerare il complesso di azione della LPS (lipopolisaccaride) della cellula gramnegativa che determina uno scompenso tale , se liberata, da determinare shock settico fino a morte.
Cosa fa unendotossina?
LPS agisce su quasi tutti gli organi e apparati ma in particolare:
sulle piastrine causando una trombosi e coagulazione intravasale disseminata;
sulla permeabilit vascolare attraverso gli endoteli, lazione sul fegato, il tumor necrosis factor
(TNF). LPS agisce quindi aumentando la permeabilit e quindi causando ipotensione da causare
shock settico e infine morte.
sullattivazione del complemento.
ESOTOSSINE
I gram-negativi oltre ad avere le endotossine sono capaci di produrre le esotossine.
Le esotossine ve ne sono molte e agiscono in vari modi; esplicano la loro azione o dopo la penetrazione
nella cellula bersaglio o a livello della membrana.
Sono tutte tossine che si legano a un recettore e liberano la porzione attiva.
Queste tossine sono dette di tipo A/B per sottolineare che una porzione si lega a un recettore e laltra si
libera. In realt possono essere formate non solo da due subunit ma anche da pi subunit ( ma vi sar
una parte della tossina legata al recettore e una libera).
Quali agiscono sulla superfice della cellula?
1. Le tossine emolitiche, dette emolisine ( ad esempio sono rilasciate dai streptococchi o stafilococchi
): portano allo scompaginamento delle porine e quindi delle morte della cellula. Le emolisine son
monomeriche. Le emolisine sono le tossine che danno il nome degli streptococchi alfa-emolitici o
beta-emolitici. Le emolisine sono prodotte anche dal Clostridium perfringens che idrolizza le
membrane cellulari.
Microbiologia - Medicina e Chirurgia polo A 2012/2013 - sbobinature lezioni
16
2. Le tossine esfogliative: tipica degli stafilococchi che determina lepidermolisi bollosa o sindrome
della cute ustionata. Questa tossina causa scollamento dei tessuti.
3. Tra quelle dimeriche che si legano alla membrana ci sono quelle che alterano il contenuto dellAMP
ciclico ( lo fanno con diverse strade) : tossine colerica e tossina pertossica o quella carborcchiosa.
La tossine colerica la pi classica delle tossina che hanno un unit che si lega e circa 5 o 6 unit che
scompagino il secondo messaggero AMP ciclico. La tossina colerica aumenta lattivit delladenilato ciclasi
che quindi produce pi cAMP; se lcAMP aumenta si ha aumento della fuoriuscita di ioni Cl-, di Na+ e
quindi di liquidi causando la diarrea.
Le tossine che causano lo scompenso dellcAMP sono per lo pi enterotossine ovvero tossine che attaccano
gli enterociti ( la sintomatologia quella delle intossicazioni alimentari).
Gli stafilococchi hanno sei enterotossine.
La tossina pertossica altera sempre laldenilato ciclasi; si lega a un recettore, diffonde, si pu legare a
diversi tipi di cellule. Media la proliferazione dei linfociti e agglutina gli eritrociti.
La tossina carbonchiosa formata da tre fattori ciascuno dei quali ha una sua funzione ma nessuno dei tre
pu agire da solo:
Lethal factor;
Edema factor;
protective antigen: questo protegge i due antigeni precedenti.
4) tossine che inibiscono la sintesi proteica o pantrope perch colpiscono il metabolismo dellintera cellula (
inibiscono la sintesi proteica):
tossina difterica: ostacola la respirazione perch si formano delle membrane che occludono il
passaggio dellaria. una tossina cha ha una porzione che si lega e una attiva ,libera ( tossina
dimerica). La tossina blocca il fattore di allungamento quindi la sintesi proteica viene bloccata e
sopraggiunge la morte.
tossina di Shiga;
Pseudomonas aeruginosa
5) tossine neurotrope:
La tossina tetanica;
Tossina botulinica prodotta dal clostridium botulinum.
Agiscono entrambe sul meccanismo di trasmissione dellimpulso nervoso ma in maniera antagonista.
Microbiologia - Medicina e Chirurgia polo A 2012/2013 - sbobinature lezioni
17
La tossina tetanica inibisce gli antagonisti causando la paralisi spastica. Quando si trasmette un impulso
contrattile si hanno degli antagonisti che bloccano la trasmissione dellimpulso, ma se questi sono inibiti il
muscolo rimane contratto. La componente attiva della tossina ( ovvero una dei due monomeri) si chiama
antetano spasmina determina la stimolazione continua da parte dei neurotrasmettitori eccitatori mentre
bloccata la liberazione dei neurotrasmettitori inibitori che agiscono sul muscolo antagonista. Si ha la tipica
risata sardonica o tetanica. La tossina tetanica ha lazione della stricnina ma ha come antagonista il curaro.
La tossina denaturata, il tossoide, usato per la vaccinazione.
Tossina botilinica da una paralisi flaccida. Ha come antagonista la stricnina mentre ha unazione simile al
curaro. Questa tossina impedisce il rilascio dellacetilcolina, il muscolo non si muove perch la fibra
muscolare non riceve il neurotrasmettitore che stimola lattivit contrattile. La tossina botulinica agisce sul
bulbo causando la mancata contrazione dei muscoli respiratori per cui sopraggiunge la morte.
6) tossine che agiscono come super antigeni:
Le tossine streptococciche, Le tossine da shock tossico, Le enterotossine stafilococciche, tutte da
stafilococco aureus.
Sono dette super antigeni perch stimolano la proliferazione della propria popolazione cellulare.
In sintesi le tossine si dividono in :
Tossine pantrope;
Enterotossine;
Neurotossine;
Citotossine, ovvero le tossine a livello della cellula che deve essere scavata.
Lemolisine non le consideriamo tossine ( non capisco il perch).
DIFFERNZA DI UN BATTERIO PATOGENO O VIRULENTO.
BATTERIO PATOGENO: un batterio che CAPACE di invadere il tessuto e moltiplicarsi ovvero ha le armi per
farlo ( tossine, capsula, membrana lipolisaccaridica).
BATTERIO VIRULENTO: un batterio che esprime in vivo la sua patogenicit e quindi lorganismo ospite non
ha bloccato la patogenicit del batterio.
Lezione 4 La chemioterapia antimicrobica
Oggi parliamo di un argomento che ha unestrema importanza in microbiologia e come sempre quando si
parla di chemioterapia antimicrobica normalmente una pensa agli antibiotici, che quello che faremo fra
un attimo. La chemioterapia antimicrobica riguarda, in realt, luso e la conoscenza delle sostanze che
servono per tutti quelli che sono i microbi, quindi nellambito della chemioterapia antimicrobica ci sono:
-
La chemioterapia antibatterica cio i famosi ANTIBIOTICI
La chemioterapia antimicotica
La chemioterapia antiprotozoaria
Microbiologia - Medicina e Chirurgia polo A 2012/2013 - sbobinature lezioni
-
18
La chemioterapia antivirale
Le ultime tre classi le tratterete durante il secondo semestre.
La chemioterapia antimicrobica racchiude quindi tutti questi diversi sottotipi di chemioterapici, per c
una differenza e un presupposto che alla base di tutta la chemio antibiotico terapia e che deriva dal fatto
che i chemioterapici antimicrobici sono dei farmaci ma si differenziano per una caratteristica essenziale,
tutti i farmaci agiscono sulluomo e sono regolati da un lato dalle caratteristiche farmacocinetiche,
lassorbimento, la distribuzione, dallaltro ogni farmaco somministrato alluomo ha una serie di effetti
collaterali e una tossicit variabile, un rapporto detto farmaco-somministrazione-uomo.
Per tutto quello che riguarda la chemioterapia antimicrobica, il discorso un po diverso, perch non pi il
rapporto tra chemio antibiotico, cio tra farmaco e uomo, o per lo meno lantimicrobico v somministrato
alluomo ma deve andare a colpire, non delle cellule umane, un tessuto o dei recettori, ma degli altri esseri
viventi che sono i batteri e i microrganismi in generale, per cui a questo punto si parla di come agisce
lantibiotico (il chemioterapico in genere), che caratteristiche ha, le resistenze che i batteri elaborano e non
ci scordiamo che i microrganismi causano infezioni nelluomo, quindi c un rapporto tra la patogenicit e la
virulenza dalla parte dei batteri e dalla parte dellorganismo limmunit, la fagocitosi e le difese. Quindi
studiare i chemioterapici antimicrobici non facile. A prescindere dal fatto che tutte queste cose sono vere
a seconda del punto di vista dei diversi scienziati cambia limpostazione degli antibiotici, e dei
chemioterapici in generale, quindi si pu osservare pi laspetto farmacologico per quello che riguarda
tutte le caratteristiche che un farmaco dovrebbe avere, quali:
- la presenza del sito
- la capacit di penetrare negli organi
- il mantenimento di adeguate concentrazioni
- la battericidia, non deve essere tossico
- non deve scatenare reazioni di ipersensibilit
- non deve alterare i parametri ematologici e chimici
- non deve essere facilmente rimosso per la classica e fisiologica clereance
- deve essere assorbito bene e molto
- non deve essere modificato o metabolizzato
- deve essere escreto al 100 per 100
- dovrebbe avere una lunga emivita
buona distribuzione
Insomma le caratteristiche farmacologiche che regolano il rapporto farmaco microrganismo - uomo.
Dal punto di vista della farmacocinetica, cio il movimento del farmaco nellorganismo, questo dipende per
esempio da:
il tipo di somministrazione
- la via di somministrazione
la posologia
- la durata
- le tecniche
tutte queste sono considerazioni che si fanno anche per i chemioterapici antimicrobici ma sono regolati
dallaspetto della farmacocinetica. Parlando di chemioterapici antimicrobici si deve tener conto anche di:
- gli effetti indesiderati,
- lipersensibilit
Microbiologia - Medicina e Chirurgia polo A 2012/2013 - sbobinature lezioni
19
- manifestazioni varie, epatiche, renali, ematologiche, chi pi ne ha pi ne metta,
- incompatibilit fisiche, chimiche
- interazioni con altri farmaci
Sono cose importantissime ma non largomento di questa lezione, tratterete questi temi in farmacologia.
Dobbiamo analizzare la chemio antibiotico terapia considerando microrganismi e uomo, non
dimenticandoci che in natura c un rapporto tra esseri viventi, microrganismi inseriti in un individuo che ha
da un lato la sua attivit immunologica, dallaltro le sue difese e dallaltro ancora le condizioni
dellorganismo, la presenza di malattie concomitanti, condizione dei tessuti, pH e quantaltro. Quindi il
chemio antibiotico dal punto di vista delluomo dovrebbe essere di sicuro impiego in gravidanza, neonati,
anziani, immunodepressi, soggetti che fanno chemioterapia tumorale, soggetti sottoposti ad interventi
chirurgici, dovrebbe essere adatto a risolvere le infezioni in tutti gli organi e tessuti, dovrebbe essere
efficace in tutti i pazienti, questo per dirvi che sono tante le considerazioni fatte da un clinico che prescrive
un antibiotico, ma le rimandiamo per voi con le cliniche.
Gli antibiotici e i chemioterapici non sono solo di interesse in microbiologia ma riguardano tutte le
discipline mediche e chiaramente ognuno con il suo lato di interesse, quindi fermo restando che le
tematiche appena fatte di farmacologia e clinica sono estremamente importanti, noi ci dedicheremo
allaspetto microbiologico, quindi il rapporto tra farmaco e microrganismo.
Dal punto di vista del microbiologo lantibiotico si valuta dalla presenza o meno di determinate
caratteristiche, quali:
- resistenza agli enzimi
- non deve indurre resistenza
- dovrebbe saper discernere tra microrganismo patogeno e flora non patogena
- dovrebbe penetrare dentro la cellula
- dovrebbe superare le resistenze classiche dei batteri
- dovrebbe avere una corrispondenza tra attivit in vitro e in vivo
- dovrebbe avere un ampio spettro di attivit
- soprattutto il chemioterapico antimicrobico, non solo lantibiotico, dovrebbe avere una tossicit
altamente selettiva, che il presupposto della chemioterapia antimicrobica (antibiotica, antivirale,
antiprotozoaria, ecc)
Lantibiotico ideale ovviamente non esiste, quindi se chiediamo dei presupposti dobbiamo accontentarci di
alcuni svantaggi, necessaria una valutazione rischio-beneficio, questo spiega perch si hanno tanti
antibiotici ma pochi antivirali, antimicotici, antiprotozoari ecc perch cos che manca? Perch antivirali
ne abbiamo cos pochi e questi vengono somministrati in casi cos estremi come lHIV? LHIV giustifica luso
della zidovudina, ma quanti antivirali conoscete? Si, c laciclovir, ce ne sono una serie ma vengono
utilizzati in piccole quantit e attraverso vie di somministrazione con un piccolo assorbimento, una persona
in ospedale con encefalite erpetica o muore per lencefalite oppure subisce gli effetti dannosissimi del
ganciclovir somministrato per via endovenosa. Voglio dire che nel somministrare determinate sostanze
bisogna fare una valutazione rischio-beneficio, cosa che per gli antibiotici si tende a non fare perch si
crede che non facciano male, fanno male comunque come vedremo con le resistenze, ma cos che hanno
di differente i farmaci antivirali da quelli antibatterici e in una via di mezzo i farmaci antimicotici e
antiprotozoari? Per esempio un farmaco antiprotozoario contro la malaria era il chinino, questo era
meravigliosamente valido contro la malaria ma provocava sordit. Questa tipologia di farmaci sono da
somministrare solo nei cadi di reale necessit grave, perche agiscono sulle componenti delle cellule
Microbiologia - Medicina e Chirurgia polo A 2012/2013 - sbobinature lezioni
20
eucariotiche. I farmaci antimicotici hanno unattivit nei confronti dei miceti ma sono aggravati da effetti
collaterali pesanti, ancora di pi gli antivirali perch i virus sono parassiti endocellulari obbligati, in vitro
troviamo tantissime sostante valide contro i virus che sono tra laltro labilissimi, ma in pratica
somministrando un farmaco antivirale questo agisce contro il virus che dentro la cellula, ma lede anche la
cellula stessa.
La chemioterapia viene utilizzata in medicina anche come antitumorale, molti di questi sono tecnicamente
antibiotici e sono sostanze che non agiscono solo sulle cellule tumorali, ma anche su quelle sane, non
hanno quindi tossicit selettiva (ricordiamo che il presupposto della chemio antibiotico terapia la tossicit
selettiva). La presenza di un numero cos elevato di antibiotici si spiega analizzando le cellule procariote
che hanno caratteristiche esclusive che servono come bersagli per lazione degli antibiotici. Per gli
antibiotici il problema andare a razionalizzare, come scegliere gli antibiotici per determinati
microrganismi? Fermo restando tutte le considerazioni fatte per i microrganismi, si deve considerare:
- lattivit sul germe,
- la resistenza che il germe elabora,
- Il tessuto in cui presente linfezione
Facendo un esempio pratico: analizzando uninfezione al tessuto polmonare non detto che lantibiotico
adatto al germe che ha causato linfezione sia adatto anche a quel particolare, oppure non sempre
lantibiotico per il germe X va bene per le infezioni sostenute da questo germe nelle meningi, perch per
esempio non supera la barriera ematoencefalica, ci sono cio tante considerazioni da fare prima della
prescrizione di un antibiotico.
La tossicit selettiva
Il concetto della tossicit selettiva proprio quello che alla base della differenza tra i chemioterapici
antimicrobici e unaltra categoria di sostanze che hanno la stessa azione (anche maggiore) ma che non
avendo la tossicit selettiva si usano solo esternamente, cio gli antisettici, un esempio lacqua
ossigenata, gli acidi del cloro o lipoclorito di sodio che se somministrati sono mortali, usatissimi per altri
scopi per esempio prima di un intervento per leliminazione dei germi esternamente.
Ritornando alla tossicit selettiva, i disinfettanti non ne hanno alcuna mentre gli antibiotici e i
chemioterapici ce lhanno invece. vero che non esistono antibiotici ideali, ma dobbiamo considerare che
un antibiotico per entrare in commercio impiega mediamente10 anni perch identificare molecole attive
facilissimo, il problema valutare lattivit microbiologica in vitro, trovare le sostanze idonee, valutare
lattivit farmacocinetica prima in vitro poi nellanimale successivamente nei volontari, poi i test preclinici,
poi si immette nel mercato, mediamente passano 10/15 anni per avere una buona sostanza, quindi prima si
fanno le prova di laboratorio poi si passa alle prove di tollerabilit, la teratogenicit, insomma tutte quelle
che sono le informazioni che ci sono nei foglietti illustrativi.
Cenni storici
Hehrlich e la teoria del proiettile magico
Quando nato il concetto della tossicit selettiva? nato da Paul Hehrlich nella seconda met del XIX
secolo (cercando su google molti siti danno come periodo gli inizi del 900!) a partire dallo studio della
sifilide, che in quel periodo turbava molto la societ e veniva curata con farmaci come il mercurio,
larsenico o i Sali di bismuto, validissimi come antisettici ma senza tossicit selettiva (basti pensare che il
mercurio stato oggi eliminato dai termometri mentre una volta venivano effettuati i bagni di mercurio).
Hehrlich elabor la teoria del proiettile magico, riflettendo sulla selettivit che hanno i coloranti che
Microbiologia - Medicina e Chirurgia polo A 2012/2013 - sbobinature lezioni
21
permettevano di osservare le cellule al microscopio grazie allaffinit di queste sostanze per determinate
strutture cellulari. Hehrlich arriv alla conclusione, che cos come i coloranti, dovevano eistere delle
sostanze che aveva selettivit specifica per i batteri e che agivano di conseguenza senza danneggiare le
cellule umane.
Fleming, la penicillina e il fiorire degli antibiotici
La svolta nello studio degli antibiotici si ebbe, casualmente, nel 1927 quando Fleming su una piastra di
studio di stafilococchi osserv la presenza di una muffa che aveva creato un alone attorno al quale non
crescevano gli stafilococchi, lui si limit ad osservare il fenomeno, che fu successivamente ripreso durante
la seconda guerra mondiale da due americani, Florey e Chain che, questi grazie a dei finanziamenti
governativi misero a punto la prima produzione di penicillina, dopo una sequela enorme di purificazioni
fino ad arrivare alla penicillina valida e purificata, la cosiddetta penicillina g. Con luso della penicillina si
ebbe effettivamente una riduzione delle infezioni, questa si rivel utilissima durante la seconda guerra
mondiale per la cura di tutte le ferite di guerra. Qualcuno disse che le infezioni si sarebbero risolte e in tutto
il mondo non ci sarebbero pi state malattie da batteri perch lantibiotico aveva sconfitto questa
problematica, ovviamente cos non perch i batteri, che sono materiale vivente, hanno manifestato la
loro resistenza. Dopo Fleming nel 1927 si ebbe un fiorire di antibiotici, la seconda tappa rappresentata
nel 1951 dalla scoperta della streptomicina, un amino glicoside tuttora in uso nella terapia antitubercolare.
Gli antibiotici oggi
Oggi il bersaglio selettivo degli antibiotici sono strutture presenti nei procarioti e non negli eucarioti, quali:
1. la sintesi del Cell Wall, che unica e pertanto rappresenta un bersaglio unico.
2. La sintesi proteica
3. La sintesi degli acidi nucleici, ovviamente questi non sono esclusivi dei batteri ma lo la girasi,
lenzima che consente la circolarizzazione del Dna batterico
I farmaci si dividono in famiglie, allinterno di queste esistono differenti farmaci con differenti
caratteristiche.
Antibiotici che agiscono sulla sintesi della parete cellulare
1.
2.
3.
4.
Cicloserina
Bacitracina
Glicopeptidi, quali Vancomicina e Teicoplamina
Beta- lattamine, di cui fanno parte le penicilline, le cefalosporine, i carbopenemici e i
monobattamici
La parete cellulare costituita dal peptidoglicano, ne abbiamo gi parlato, ma ci tengo a ricordarvi che
viene sintetizzato allinterno del citoplasma dove, per esempio, la cicloserina inibisce la formazione di
questo componente della parete.
Passando attraverso la membrana lacido muramico esclusivo viene trasferito attraverso un carrier, un
antibiotico particolare, la bacitracina, impedisce questo passaggio.
Il carrier bersaglio della vancomicina e teicoplamina, antibiotici glicopeptidici, molto pesanti dal punto di
vista della tollerabilit, utilissimi per laddove gli altri non agiscono.
Microbiologia - Medicina e Chirurgia polo A 2012/2013 - sbobinature lezioni
22
Lultima fase quella della transpeptidazione, tipico bersaglio di un gruppo enorme di molecole dette betalattamine. La transpeptidazione vi ricordo, operata dalla trans peptidasi che si lega alle due unit facendo
perdere un peptide e legando saldamente le due catene ed proprio questo enzima bersaglio
dellantibiotico.
In relazione alle sue caratteristiche farmacologiche la trans peptidasi viene chiamata Penicillin-BindingProtein. Quando la penicillina si lega allenzima, pi correttamente alla PBP, questo non ha pi il sito libero
per funzionare e quindi la parete cellulare non si pu formare in questo modo il batterio v incontro a lisi,
infatti il meccanismo dazione delle beta-lattamine generalmente un meccanismo che porta alla lisi della
cellula. In condizioni osmotiche favorevoli la cellula pu per conservarsi come sfenoplasma o come
plasma, quindi pu rimanere in equilibrio osmotico, caso impossibile in vivo e realizzato in vitro solo per
studio. Le beta-lattamine non hanno solo un meccanismo di rottura, in certi casi possono portare
allallungamento dove il batterio non va incontro a lisi ma si allunga a dismisura fino a quando non si
filamentizza, ma sono casi pi rari.
Le sostanze beta-lattamiche, per essere tali,
devono avere un anello beta lattamico che
rappresenta il nucleo principale e il bersaglio
degli enzimi prodotti dai batteri, quali le betalattamasi che scindono lanello.
.
Lanello beta-lattamico pu essere unito a
tante sostanze, in base a questo si
differenziano gli antibiotici. importante
sapere che ogni antibiotico ha una sua
struttura chimica, ma ritengo che ad un medico
interessi poco sapere la struttura chimica degli antibiotici, ricordate per che lesistenza di milioni di
antibiotici dipende appunto dalle diverse strutture chimiche.
Se allanello beta-lattamico si aggiunge lacido 6-amino penicillamico si ha la classica penicillina g, quella di
Fleming. Le penicilline sono caratterizzate dallavere tutte questo anello con un gruppo tiazolinidico.
Unaltra categoria di beta-lattamine, le cefalosporine allanello beta-lattamico aggiungono un anello
diidrotiazinico.
Usando la vecchia penicillina si ci accorse che questa aveva delle caratteristiche sfavoreli, in quanto era
sensibile allambiente acido e quindi doveva essere somministrata per via parenterale e soprattutto
ripetutamente, a causa delle sue caratteristiche farmacologiche, appena usata oltretutto si manifestarono
le prime resistenze, la scienza e le case farmaceutiche hanno fatto quindi in modo di creare un antibiotico
con le caratteristiche ideali, quali:
- la somministrazione dilazionata, in questo modo nascono le penicilline ritardo, ottenute
modificando i radicali
- lacido-resistenza, quindi somministrabili per via orale.
- Ampio spettro dazione, sono nate una serie di penicilline funzionanti anche sui Gram -, in quanto le
prime penicilline erano limitate solo a stafilococchi e streptococchi
- Resistenza agli enzimi inattivanti
Microbiologia - Medicina e Chirurgia polo A 2012/2013 - sbobinature lezioni
23
In base a queste caratteristiche si hanno tanti gruppi differenti di penicilline create in laboratorio.
Oggi esistono penicilline resistenti allacido gastrico ma a spettro simile alla prima penicillina, oppure
abbiamo penicilline resistenti alle beta-lattamasi (un esempio rappresentato dalla meticillina per gli
stafilococchi) tra queste ci sono diversi gruppi quali le isossazolilpenicilline per esempio, molto utilizzati
negli altri continenti, come la cloxacillina che ha aggiunto alle caratteristiche del beta-lattamico la
gastroresistenza, grazie al radicale che si lega allacido gastrico permettendo alla molecola di agire.
Le amino penicilline, le carbossipenicilline, le sulfossipenicilline, le ureidopenicilline fanno parte del
gruppo delle penicilline ad ampio spettro dazione, ognuna con caratteristiche differenti. Molte sono
utilizzate anche oggi quali lamoxicillina o lampicillina.
Le Cefalosporine sono un gruppo molto numeroso ma non aggiornatissimo, che contiene molecole
parenterali, resistenti alle beta-lattamasi a spettro classsico, resistenti allo spettro diversificato, short e long
acting, ciascuna con i suoi rappresentanti.
Altri beta-lattamici sono i Carbopenemici e i Monobattamici.
Esistono anche delle penicilline che inibiscono la beta-lattamasi quali lAcido Clavulanico, il Sulbactam e il
Tazobactam che compongo farmaci di grande uso commerciale quali gli inibitori suicidi, cio sostanze che
bloccano le beta-lattamasi consentendo alla molecola non resistente alle beta-lattamasi di agire.
Antibiotici glicopeptidici
- Vancomicina
- Tecoplamina
- Altri in via di sviluppo
Alcuni hanno anche azione sulla sintesi proteica, come il liezodil.
Tanto per darvi unidea la bacitracina non si utilizza in terapia, agendo sulla membrana che presente
anche nelle nostre cellule, non ha la tossicit selettiva adeguata, quindi nelluso sono pi comuni la
vancomicina, i glicopeptidi e le beta-lattamine
Antibiotici che agiscono sulla sintesi proteica
Gli antibiotici che agiscono sulla sintesi proteica sono farmaci che inibiscono la sub unit 30S o la subunita
50S, ne esistono alcuni che agiscono anche fuori dai ribosomi come lacido fusidico.
Quelli che agiscono sulla sub unit 30S sono:
- amino glicosidi
- tetracicline
Gli antibiotici che agiscono inibendo la subunit 50S sono:
- cloramfenicolo
- macrolidi
- lincosamidi
AMINOGLICOSIDI
Molecole rappresentate da zuccheri e proteine, sono gli unici batterici che agiscono sulla sintesi. Tutti
parenterali, qualcuno orale, generalmente sono tutti ad ampio spettro
Microbiologia - Medicina e Chirurgia polo A 2012/2013 - sbobinature lezioni
24
TETRACICLINE
Molecole classiche o di nuova sintesi, costituite da un anello tetra ciclico, capace anche di agire su
microrganismi endocellulari.
CLORAMFENICOLO
il meno utilizzato a causa dei numerosi effetti collaterali. Supera al barriera ematoencefalica cos come il
tiamfenicolo
LINCOSANIDI
Molecole che agiscono sui batteri anaerobi
MACROLIDI
sono la classe pi numerosa insieme ai ketolidi, sono classificati in base:
- allorigine, naturali o di sintesi
- alla struttura chimica, in relazione al numero di atomi di C, si distinguono macrolidi a 14C, 15C e
16C
- allutilizzo clinico
- alla farmacocinetica
I macrolidi si distinguono anche in:
- Macrolidi a breve azione. Che necessitano quindi di somministrazione ripetuta
- Macrolidi long acting
- Macrolidi non pi utilizzati
Tra i macrolidi i farmaci pi utilizzati sono Eritromicina, Claritromicina e Azitromicina.
Parenti dei macrolidi i ketolidi di ultima generazione e con una struttura molto simile a quella dei macrolidi.
Simili anche gli antibiotici polipetidici, un esempio sono polimixine (come il bimixin utilizzato per le
gastroenteriti) che vengono utilizzate per via orale senza assorbimento, altrimenti sarebbero tossiche.
VARI
Tra questi la Fosfomicina che insieme al Trometamolo si utilizza nelle infezioni urinarie, o la
Spectinomicina utilizzata nelle infezioni causate da Neisseria Gonorrhoeae
Antibiotici che agiscono sulla sintesi degli acidi nucleici
Si dividono in:
- Inibitori della sintesi dei precursori, quali i Sulfamidici e il Trimetoprim, che agiscono sulla via
metabolica che dallacido paraminobenzoico va allacido tetraidrofolico, precursore di purina e
pirimidina. Un esempio di questa classe di farmaci il Bactrim.
- Inibitore dellRNApol batterica, come le Rifamicine impediscono allenzima di effettuare la
trascrizione, impedendo la formazione dellRNAm impedendone di fatto la sintesi. Utilizzati anche
nella terapia antitubercolare
- Inibitori della girasi, quali i fluorchinoloni, chemioterapici che inibendo lenzima responsabile della
spiralizzazione del DNA impedisce lavvio della divisione cellulare. I chinoloni nascono come
antisettici urinari a spettro selettivo, cio attivi solo sugli stafilococchi e streptococchi, una seconda
Microbiologia - Medicina e Chirurgia polo A 2012/2013 - sbobinature lezioni
25
generazione li vide a spettro pi ampio ma sempre con attivit a livello urinario, fino a quando
laggiunta di un atomo di fluoro ha determinato la diffusibilit, lassorbimento e la presenza in tutti
gli organi e tessuti, sono presenti una terza e una quarta generazione con spettro molto mirato.
Hanno una serie di effetti collaterali che ne impediscono luso nei bambini, nelle donne in
gravidanza e in soggetti con malattie neurologiche concomitanti.
Tenendo conto degli effetti collaterali le penicilline sono senza ombra di dubbio gli antibiotici
maggiormente tollerabili.
Lezione 5 RESISTENZE AI CHEMIOANTIBIOTICI
Abbiamo parlato dei chemioantibiotici analizzandone il meccanismo dazione, quindi abbiamo trattato i
batteri come bersagli; ora, cambiando ottica, analizzeremo lantibiotico come bersaglio dei microrganismi;
in una parola, parleremo di cosa sono le resistenze ai chemioantibiotici. Ovviamente, quello che abbiamo
detto per tutta la chemioterapia valido anche per le resistenze e, cio, il fatto che anche i funghi possono
essere resistenti ai farmaci antimicotici e anche i protozoi ai farmaci antiprotozoari e in questi casi la
situazione risulta problematica. Per quello che riguarda i batteri, essendo molto pi numerosi ed essendo
molto pi diffusi gli antibiotici, la resistenza si studia per quello che riguarda i chemioantibiotici. La
resistenza si pu studiare sotto infiniti aspetti; illustreremo il concetto generale delle resistenze agli
antibiotici.
Come si valuta la sensibilit di un antibiotico su un microrganismo in vitro? (in vitro significa in un
laboratorio di microbiologia; in vivo ci sono problematiche che interessano lo studio degli antibiotici dal
punto di vista clinico). In vitro saggiamo queste due sole componenti: germe e microrganismo, fermo
restando che sono infinite le variabili che condizionano in vitro lo stesso microrganismo, non ultimi i
problemi immunitari, la clearance fisiologica e quantaltro. Quindi, esclusivamente in vitro la sensibilit di
un antibiotico si misura con delle metodiche differenti: la pi classica la MIC (Minima Concentrazione
Inibente), ma viene anche utilizzata la MBC (Minima Concentrazione Battericida). Come si valuta? Ci sono
tanti sistemi: miniaturizzati, in pozzetto, nelle piastre quello pi facile da descrivere quello classico in
cui ci sono una serie di provette nelle quali si inocula una quantit standard di una brodo-coltura (un germe
che fatto crescere in quantit abbastanza fisse con un inoculo costante che abbia un 5x10 4 cellule
batteriche) e nella provetta con il brodo di coltura e il germe si mettono delle diluizioni scalari a raddoppio
(si fa una soluzione tra antibiotico e acqua e iniziando dalla prima provetta si mette lo stesso quantitativo,
spipettando, per es. si mettono 2 ml in 2 ml di brodo presente; la diluizione si dimezza; quindi, 2 ml di
soluzione di antibiotico, 2 ml di brodo dopodich si prelevano altri 2 ml (saranno diluiti), si mettono
nellaltra provetta e via via si continua fino a che si arriva a diluizioni molto spinte. Quindi dalla prima
provetta in cui abbiamo 100 g/ml arriviamo allultima: 16, 8, 4, 2, 1 a secondo del punto di partenza
dovrebbe riferirsi alla slide).
Noi parliamo di g quando consideriamo lattivit in vitro, e in particolare di g/ml, ma se prendiamo in
considerazione un farmaco si parla di mg che si distribuiscono in tutto lorganismo, visto che non hanno
specificit dazione; quindi, affinch, in un distretto vada un quantitativo riferibile a g/ml dobbiamo
essere sicuri che lantibiotico venga inibito da quelle concentrazioni (ecco il perch di scale cos differenti).
In g considerata la MIC, mentre mg vengono somministrati alluomo per fare in modo che in quella zona
i batteri trovino le loro adeguate concentrazioni.
Si mette in incubazione e si osserva dopo 24 ore; si noter che ci sono delle provette che sono rimaste
incolori e delle provette in cui il microrganismo cresciuto (il brodo sar torbido).
Microbiologia - Medicina e Chirurgia polo A 2012/2013 - sbobinature lezioni
26
Quale sar tra queste la Minima Concentrazione Inibente?
La MIC questa (fa riferimento ad una slide), ovviamente su un ceppo; se si vuole lavorare in maniera pi
scientifica si osservano diversi ceppi e si calcola la MIC 50 quella che inibisce il 50% dei ceppi o la MIC90 che
inibisce il 90% dei ceppi.
Per stabilire il valore della MBC preleviamo il materiale della provetta inibita, magari di due provette inibite,
e si mette linoculo su un terreno senza antibiotico. Se il germe stato solamente inibito, crescer sul
terreno in cui assente lantibiotico; se ucciso, non crescer. Si prepara una serie di campioni di questo
tipo e si calcola la minima concentrazione che uccide il microrganismo; molto spesso MIC e MBC
coincidono, altre volte no; altri studi permettono di osservare gli effetti sui germi in vivo delle dosi subinibenti di antibiotico (il batterio inibito ma come modifica il suo metabolismo?).
Oltre alle provette ci sono anche macchinari per svolgere questo lavoro, ma il significato identico.
Pi rudimentale un metodo e minore la necessit di standardizzare e minori sono le variabili; pi
automatizzato meno semplice e richiede una maggiore precisione.
Il modo pi facile con cui si definisce la sensibilit agli antibiotici lantibiogramma; in cosa differisce?
Questo (dovrebbe riferirsi al precedente metodo di valutare la sensibilit) la differenza che c tra un
antibiotico su uno stesso microrganismo (un solo antibiotico, un solo microrganismo); lantibiogramma
quello che clinicamente si effettua sui germi isolati dalle infezioni ed un paragone tra un germe che
piastrato in tutto il terreno di coltura della piastra e i dischetti di antibiotici differenti posti su esso.
Sintetizzando, lalone pi grande indica che lantibiotico pi attivo; di fatto non cos perch dipende
tutto dalla diffusione dellantibiotico, dalla concentrazione che si ha nel dischetto, dalle diverse varianti tra
il profilo di resistenza intermedio attivit. La penicillina pu essere tarata con metodi particolari, laddove un
altro antibiotico pu avere altra scala di millimetri; quindi, non detto che quel dischetto sia pi attivo di
un altro. Un antibiogramma fatto bene questo (fa riferimento a una slide) e un antibiogramma fatto male
questo (sempre riferimento a slide), dove non c una crescita a patina e i germi sono minori.
Una cosa importante da notare la presenza di mutanti.
RESISTENZA
La resistenza pu essere di diversi tipi:
Naturale;
Acquisita.
Resistenza naturale: ad es. gli aminoglicosidi richiedono un trasporto attivo aerobico; gli anaerobi non
possiedono questo tipo di trasporto perch vivono senza ossigeno, quindi, non esiste lattivit
dellaminoglicoside verso i germi sporigeni perch sono naturalmente resistenti. Il medico deve sapere
queste cose; ad es. ci sono dei germi che sono senza parete cellulare, se le -lattamine agiscono sulla
parete e il medico somministra antibiotici che agiscono sulla parete per trattare germi privi di essa, chiaro
che non si otterranno risultati e che il germe intrinsecamente resistente.
Resistenza acquisita: quella che i batteri acquisiscono; prima essi sono sensibili, poi, man mano,
acquisiscono la capacit di non rispondere allantibiotico.
Da dove origina la resistenza agli antibiotici? Ha diverse origini. Lespressione si chiama fenotipo, lorigine
deve essere genetica.
ORIGINI DELLA RESISTENZA
Microbiologia - Medicina e Chirurgia polo A 2012/2013 - sbobinature lezioni
27
Mutazioni spontanee: ceppi mutanti sono comunissimi in microbiologia e clinica. Se si prende
in esame una popolazione sensibile e si usa un antibiotico per 24 ore, sembra che tutto va bene
ma dopo 48 ore torna linfezione. Basta che un solo batterio elabori resistenza e nel giro di 24
ore si sar riformato in quantit di miliardi e miliardi come progressione logaritmica.
Quale il tasso di mutazione in una cellula qualsiasi? Una media di 107 cio una volta su un miliardo. Nel
caso di una cellula eucariota o di un organismo ci vuole del tempo per un evento come una mutazione su
un miliardo di mitosi e meiosi, mentre, nelle cellule batteriche, che hanno un ciclo riproduttivo che dura 10
minuti e che si riproducono in maniera tumultuosa, nel giro di 24 ore si formano dei mutanti ed essi non
sono un evento raro. Nelle cellule normali il DNA per evolvere deve modificarsi, si deve scambiare
(ricombinazione del DNA). Quali sono i casi di ricombinazione del DNA nelle cellule eucariote? Ad es. il
crossing over, mentre la mutazione spontanea (perdita o acquisizione di qualche cosa); ma il crossing over
sar per i miceti e per i protozoi.
Per i batteri ci sono 3 vie di ricombinazione genetica (meccanismi attraverso i quali i batteri possono
ricombinare, quindi cambiare, il loro materiale genetico); la resistenza riguarda soprattutto uno di questi
meccanismi. Non descriveremo linduzione perch costituita da meccanismi e prove effettuati in
laboratorio (essa pu essere one-step o multi-step); pensiamo come origine alle mutazioni spontanee o
alle ricombinazioni del genoma.
Quindi, quali sono i meccanismi di ricombinazione?
1. Trasformazione: esso prende il nome da un esperimento fatto prima del 1930 da un certo Griffit e
fatto sullo Pneumococco; non si conosceva ancora lacido nucleico ma Griffit osserv che dei
batteri morti capsulati, e quindi virulenti, messi insieme a batteri vivi non capsulati, e quindi non
virulenti (scientificamente si parla di fase S per i capsulati e fase R per gli altri, perch la capsula d
un aspetto liscio smooth, S), si ricombinavano e si aveva un microrganismo in grado di dare
infezione, pertanto virulento e, dunque, caspulato. Questo meccanismo genetico molto studiato
in microbiologia ma noi lo sorvoliamo e ne parliamo soltanto nel novero dei meccanismi di
ricombinazione del genoma; Griffit non conosceva il genoma n era stato scoperto il DNA, ma oggi
noi sappiamo cosa il fenomeno da lui osservato: un meccanismo di inserzione e perdita di basi
che conferiscono questo carattere alla progenie.
2. Transduzione: un infezione ad opera di un virus; poich linfezione colpisce un batterio, il virus lo
chiamiamo batteriofago. Ne esistono molti tipi; il tipo VI, lultimo, se entra e inocula il suo genoma
nel batterio ha due possibilit, come tutti i virus delle cellule: o induce la cellula, quindi il genoma
cellulare in cui si integrato, a produrre per il virus e pertanto, la produzione di migliaia e migliaia
di virus, inducendo la cellula a morire in questa produzione ( un ciclo litico); o nel caso, invece, dei
virus oncogeni o dei virus che trattiamo adesso, il virus riesce a iniettare e a integrare nel genoma
del batterio un frammento di DNA, che inevitabilmente modifica la vita della cellula, perch il
genoma nella riproduzione produrr tante copie di questo DNA integrato. In virologia verranno
trattati il ciclo litico e litogeno; il ciclo litico porta a morte la cellula con produzione virale (virus
dellinfluenza e del morbillo hanno un ciclo litico), il ciclo lisogeno dato dal virus che integra il
genoma virale nel genoma cellulare e la progenie della cellula avr i caratteri iniziali e lintegrato
genoma virale (oncogenesi e virus oncogeni trattati in patologia generale e situazioni relative sono
dovute al ciclo lisogeno). In microbiologia il ciclo litico non ci riguarda, ma il ciclo lisogeno induce
nella cellula batterica, che vive e trasmette alla sua progenie, dei caratteri ricombinati; tra essi c
la produzione di molte tossine (quando studieremo la difterite, studieremo che la tossina difterica
deriva da transduzione fagica: un iniziale ceppo di corynebacterium difteriae nel corso della sua
iniziale esistenza stato infettato da un batteriofago che ha inoculato il suo genoma nel genoma
Microbiologia - Medicina e Chirurgia polo A 2012/2013 - sbobinature lezioni
28
della cellula batterica; il ciclo non porta a morte la cellula un ciclo lisogeno ma la progenie di
quel corynebacterium difteriae ha avuto la capacit di esprimere la tossina a seguito dellinfezione
col virus; questo fenotipicamente, mentre da un punto di vista genetico c stata una
ricombinazione).
3. Coniugazione: un meccanismo di ricombinazione che prevede che una cellula batterica donatrice,
chiamata cos perch possiede un plasmidio (materiale extracromosomiale) che geneticamente ha
conferito a questo ceppo la capacit di formare il suo pilo F, una fimbria specializzata per conferire
il trasferimento di materiale genetico, quale il plasmidio, da una cellula donatrice a una ricevente
(cellula F-); la cellula ricevente, a seguito della coniugazione, diventa F+ : la cellula donatrice con il
suo pilo di coniugazione trasferisce il suo materiale genetico extracromosomiale, il suo plasmidio, e
una volta trasferita la singola elica, che si riforma, le due cellule sono diventate entrambe donatrici
(la cellula donatrice rimasta tale, mentre la ricevente diventata donatrice, cio F+, con questo
plasmidio acquisito e la capacit genetica di produrre il suo pilo F). Il plasmidio spesso si pu
trovare anche integrato nel cromosoma; se libero nel citoplasma si chiama plasmidio, se
integrato si chiama episoma, e i ceppi che possono fare questo si chiamano High Frequency
Resistency Recombination (HFR).
Nellambito della RESISTENZA PLASMIDIALE, il plasmidio dalla cellula resistente passa alla cellula sensibile
che a sua volta diventa resistente; considerando questa possibilit, da una cellula si diffonde a tutte le
cellule in maniera quasi epidemica, in maniera orizzontale (in una coltura se c un ceppo che scambia e
trasmette il suo plasmidio, entro mezzora ci saranno dieci ceppi, in quattro ore ce ne saranno in maniera
logaritmica). E una caratteristica della resistenza plasmidiale il fatto di una grande diffusione in tempi
oltremodo rapidi; quindi, quando parliamo di resistenza plasmidiale o extracromosomiale, parliamo del
90% di tutte le resistenze acquisite (cio acquisite a seguito di trasmissione del plasmidio e, quindi, tramite
meccanismi di coniugazione). Il trasferimento di plasmidi avviene molto velocemente e riguarda, per, non
solo microrganismi della specie ma tutti i microrganismi in generale; dunque, il plasmidio e il pilo F non
sono selettivi nei confronti di microrganismi della stessa specie, ma in quel momento, in quel sito, in quella
brodo-coltura, in vivo se si scambia un plasmidio lo si scambia a tutti i microrganismi presenti che
acquisiscono quel carattere di resistenza e, poich si trasmette un plasmidio, che DNA
extracromosomiale, d caratteri di patogenicit ma non essenziale per le cellule; quindi, i microrganismi
che acquisiscono il plasmidio non hanno modificazioni metaboliche e rimangono patogeni come lo erano
prima. La resistenza plasmidiale pu anche essere chiamata resistenza contagiosa, infettiva o trasmissibile;
una resistenza acquisita per il passaggio di un plasmidio a seguito della coniugazione. la resistenza che
viene pi comunemente valutata quando si parla di germe resistente a un determinato antibiotico.
Il restante 10-15% della resistenza acquisita costituito dalla RESISTENZA CROMOSOMIALE. Essa
differente da quella plasmidiale perch, essendo cromosomiale, implica che si trasmette inevitabilmente
alla progenie (quindi, a microrganismi della stessa specie). Non contagiosa o diffusibile come la
precedente, ma si trasmette verticalmente. una resistenza pi stabile, pi duratura, laddove quella
plasmidiale si perde se manca limpatto con lantibiotico; per, questa resistenza comporta delle carenze
metaboliche. I batteri resistenti acquisiscono la resistenza, si scambiano geneticamente queste
informazioni ma il cromosoma resta tale; il passaggio di questa resistenza comporta delle carenze
metaboliche o delle carenze in altri ambiti come la produzione di tossine, fattori di patogenicit, in modo
tale che il ceppo resistente spesso meno attivo da un punto di vista metabolico e di patogenicit. La
resistenza cromosomiale di due tipi: si pu avere o progressivamente (induzione a formare la resistenza
Microbiologia - Medicina e Chirurgia polo A 2012/2013 - sbobinature lezioni
29
un po alla volta da parte degli antibiotici) o immediatamente (antibiotici che al contatto col germe
inducono lo sviluppo di resistenza tutta in una volta sola); il primo tipo chiamato resistenza multi-step (
legata a pi mutazioni ed tipica di tutte le -lattamine, dei macrolidi, degli aminoglicosidi e delle
tetracicline), il secondo tipo chiamato resistenza one-step (ad es. tra gli aminoglicosidi tipicamente onestep la resistenza della streptomicina; questo antibiotico usato nella terapia antitubercolare che deve
essere sempre modificata un mese dopo laltro).
Per la resistenza il meccanismo di origine pi interessante la coniugazione, pur tenendo presente la
possibilit di mutazioni spontanee e la presenza di ceppi mutanti, oltre che la resistenza indotta del
cromosoma e trasferita alla progenie.
ESPRESSIONE FENOTIPICA DELLE RESISTENZE
Passiamo ad analizzare laltro aspetto delle resistenze, ovvero la loro espressione fenotipica, in quanto,
geneticamente sono dovute a quanto detto sopra; fenotipicamente lantibiotico-resistenza si manifesta con
7 meccanismi principali.
1. Inattivazione dellantibiotico
Consiste nellinattivazione enzimatica dellantibiotico (ad es. enzimi come le -lattamasi che inattivano le lattamine, oppure come gli enzimi fosforilanti che fosforilano, come gli enzimi acetilanti che acetilano, gli
enzimi adenilanti che rompono gli altri legami). I bersagli per questi enzimi sono tipici di molti farmaci: ad
es. gli aminoglicosidi contengono dei siti bersaglio di enzimi fosforilanti, acetilanti e adenilanti, prodotti dai
germi resistenti; alcuni ne producono uno, altri due, altri ancora hanno pi meccanismi ma gli
aminoglicosidi, le tetracicline, il cloramfenicolo, tutti gli antibiotici hanno bersagli per questi enzimi.
Ovviamente le -lattamasi inattivano solo le -lattamine, che non sono poche; ci sono due tipi -lattamasi:
le eso--lattamasi e le endo--lattamasi; infatti, facendo riferimento alla parete cellulare i gram-positivi
hanno la parete spessa e quindi le -lattamasi sono prodotte esternamente, mentre, nei gram-negativi
sono prodotte allesterno del peptidoglicano che ne il bersaglio, ma rimangono incluse nello spazio
periplasmico perch c la membrana esterna (saranno endo--lattamasi). Il significato clinico diverso
perch se si tratta un gram-negativo, le endo--lattamasi agiscono in questo spazio, nel caso dei grampositivi agiscono esternamente alla cellula. La -lattamasi il meccanismo pi comune che blocca
lantibiotico; se non ci fossero le -lattamasi lantibiotico arriverebbe tranquillamente al suo sito bersaglio
che la PBP (transpeptidasi citata parlando della cellula batterica; essa quando diventa bersaglio delle
penicilline prende il nome di Penicillin Binding Protein); invece, se ci sono le -lattamasi lantibiotico rimane
bloccato.
2. Diminuita penetrazione intracellulare (modifica delle porine)
Avviene quando la cellula chiude i pori e il batterio non entra; questo meccanismo prende il nome di
modifica delle porine.
3. Modificazione delle strutture bersaglio e diminuita affinit per strutture prima recettive
Si ha quando il batterio modifica le sue strutture bersaglio, facendo in modo da far diminuire la sua
sensibilit nei confronti dellantibiotico (nonostante lingresso dellantibiotico, esso non pu agire perch
non trova il suo sito). il meccanismo delle PBP; esso impedisce alla penicillina di agire.
4. Aumentata produzione di enzimi inibiti dallantibiotico
Se un batterio produce enzimi che gli servono e lantibiotico agisce inibendo lenzima, il batterio produce
una quantit enorme dellenzima, che gli consente di deviare lopera dellantibiotico: nonostante
lantibiotico continui a funzionare, pu bloccare solo parte degli enzimi prodotti.
Microbiologia - Medicina e Chirurgia polo A 2012/2013 - sbobinature lezioni
30
5. Superamento del blocco metabolico con iperproduzione del prodotto carente
Se c un blocco metabolico (per es. ai sulfamidici), il batterio non pu avere una vita normale; se esso in
grado (grazie ad una capacit genetica, e cio dopo aver acquisito il plasmide) di iperprodurre il prodotto
che era carente a seguito del blocco metabolico, evade la presenza dellantibiotico. Sono delle possibilit
che dal punto di vista metabolico il batterio acquisisce a seguito di resistenza e contatto con lantibiotico.
Quindi anche se c un blocco metabolico e, di conseguenza, un prodotto carente, se il batterio produce
tanto prodotto carente, il blocco agisce solo su una parte, mentre il resto serve alla vita del batterio.
6. Iperproduzione di enzimi inattivanti che si legano allantibiotico formando una barriera non
idrolitica (effetto spugna)
opposto al precedente; i batteri producono una serie enorme di enzimi che rilasciano allesterno,
bloccando immediatamente lantibiotico. Iperproduzione che non soltanto linattivazione ma una
produzione abnorme.
7. Rapido efflusso dellantibiotico
lopposto del rapido ingresso dellantibiotico e, cio, una rapida uscita di esso; si ha la modifica delle
pompe da efflusso da parte di batteri che acquisiscono questa possibilit.
I meccanismi pi importanti sono i primi tre.
necessario aggiungere delle notizie riguardo alla modificazione delle strutture bersaglio: le pi importanti
sono le PBP, ovvero le transpeptidasi, che consentono una reazione importantissima; infatti, chiaro che se
non si forma il complesso tra acido muramico e catene, normalmente formato dalle traspeptidasi, il
batterio non forma la parete e, avendo una pressione osmotica elevatissima, va incontro a lisi e muore. La
modificazione delle PBP comporta che la PBP perde laffinit per la penicillina, che rimane, mentre la PBP
continua la sua opera e lega come transpeptidasi le catene adiacenti, consentendo al batterio di vivere. A
questo punto e per ovviare tutti i problemi relativi agli enzimi e ai siti bersaglio, si cercato di mettere
appunto dei meccanismi che permettessero agli antibiotici di funzionare.
Ci sono degli antibiotici -lattamici come lamoxicillina, lampicillina (sono penicilline semisintetiche), la
piperacillina che ad ampio spettro, i quali sono molto efficaci ma sono sensibilissimi alle -lattamasi, che
se vengono uniti in ununica compressa a delle sostanze quali il sulbactam, il tazobactam e lacido
clavulanico che sono -lattamine e che, quindi, hanno una grande affinit per le -lattamasi, e utilizzati su
una popolazione di batteri resistenti perch producono -lattamasi, danno ottimi risultati. Infatti, usando,
ad es. la combinazione amoxicillina-acido clavulanico su una popolazione di batteri resistenti perch
producono -lattamasi, lacido clavulanico funge da bersaglio per le -lattamasi, lasciando lamoxicillina
libera di agire e di andare al suo sito bersaglio, che la PBP. Le sostanze associate agli antibiotici citati
sopra vengono chiamate inibitori suicidi delle -lattamasi e sono utili per trattare popolazioni di batteri
resistenti, mentre sono inutili per trattare popolazioni sensibili. Dunque, lunione tra inattivazione
dellantibiotico e modificazione delle strutture bersaglio ha fatto in modo di creare antibiotici validi.
Per quanto riguarda gli altri gruppi di antibiotici: per le tetracicline il meccanismo non chiaro anche se si
parla di pompa di efflusso e quindi di maggiore efflusso dellantibiotico; il cloramfenicolo possiede enzimi
acetilanti; i macrolidi alterano il loro sito bersaglio, non consentendo lazione dei macrolidi ( cos nella
registrazione); i sulfamidici intervengono bloccando una via metabolica (se la via metabolica viene bloccata,
essi non hanno azione); i fluorochinoloni bloccano ancheessi una via metabolica; le rifamicine alterano le
polimerasi. Questi farmaci o eliminano i germi resistenti tramite il sistema della pompa di efflusso o
modificano lenzima bersaglio.
Microbiologia - Medicina e Chirurgia polo A 2012/2013 - sbobinature lezioni
31
CURIOSITA
Se le -lattamasi agiscono su un substrato (-lattamine) ed entra una -lattamina, si producono -lattamasi
in maniera tale che vengono inattivate mille molecole di -lattamine in un secondo; se vero ci, la
modificazione della transpeptidasi consente linattivazione di una -lattamina allora. Linattivazione
enzimatica sicuramente il meccanismo di resistenza plasmidiale acquisita pi importante che venga
descritto e nel caso degli inibitori suicidi consente leliminazione del blocco causato dalle -lattamasi.
Ometteremo le percentuali. Nei lavori che si possono consultare per curiosit esistono delle sigle come
MRSA, MRSE, MRSCN che indicano gruppi di antibiotici testati per le resistenze (MRSA = stafilococco aureo
meticillina resistente; MRSE = stafilococco epidermis meticillina resistente; MRSCN = stafilococchi coagulasi
negativi meticillina resistenti; VRE = enterococchi vancomicina resistenti).
Oggi la maggior parte di infezioni sono attribuite agli stafilococchi resistenti alla meticillina e ci sono tanti
stafilococchi coagulasi negativi multi-resistenti (resisenza incredibile per gli stafilococchi). Emergono
enterococchi resistenti ai glicopeptidi e fra i gram-negativi si parla di ESBL, cio di -lattamasi a spettro
esteso.
Lezione 6 GRAM-POSITIVI
STAFILOCOCCHI
Cocchi Gram-positivi a grappolo resistenti nellambiente. La caratteristica del gruppo che resistono a
elevate concentrazioni di cloruro di sodio. Sono considerati germi alofili e pertanto si coltivano su terreni
che hanno il 7,5% di sale. Hanno anche caratteristiche emolitiche. Terreno standard di coltura quello che
contiene lagar (unalga addensante che d compattezza al tessuto), il sale (tipico di tutti i terreni per
stafilococchi), il mannitolo (zucchero, che serve a definire i mannitolo-fermentanti dai mannitolo-non
fermentanti). Lunico stafilococco mannitolo-fermentante lo Staphylococcus aureus.
Gli Stafilococchi vivono per lo pi nel nostro organismo sulla cute e sulle mucose.
Patogenicit
Il vero patogeno del gruppo lo Staphylococcus aureus che d patologie conclamate, classiche; ma tutti gli
altri stafilococchi sono lo stesso patogeni perch si possono comportare da opportunisti.
La patogenicit dello stafilococco legata a tutti gli enzimi (coagulasi, ialuronidasi, lipasi, le fibrinolisine
-lattamasi) che sono elementi di patogenicit per la cellula. Lo
Staphylococcus aureus produce una serie di tossine (esotossine) di cui ricordiamo le enterotossine, TSST
(toxic shock staphylococcal toxin) e lesfoliatina. Altri elementi di patogenicit sono il glicocalice e il biofilm
tipici di tanti altri microrganismi. La coagulasi che trasforma il fibrinogeno in fibrina molto importante
perch permette di distinguere gli stafilococchi in coagulasi-positivi (aureus) e coagulasi-negativi (non
aureus).
Le lesioni classiche da stafilococco sono: il foruncolo (il favo un grosso foruncolo tutto raccolto), lascesso
(raccolta di pus), le infezioni da ferite chirurgiche, piodermite, impetigine pustolosa da staphylococcus
aureus; questultimo produce anche tossinfezioni alimentari con le enterotossine. Tipica dello Stafilococco
la sindrome da shock tossico dovuta alla tossina TSST, legata alluso dei tamponi interni. Unaltra
sindrome la SSS (scalded skin syndrome, sindrome da pelle ustionata o epidermolisi bollosa) in cui gli
Microbiologia - Medicina e Chirurgia polo A 2012/2013 - sbobinature lezioni
32
stafilococchi producono una esfoliatina che responsabile di questa malattia, dovuta alla tossina SSST.
Quindi le patologie dovute allo Straphilococcus aureus sono: affezioni della cute, tossinfezioni, sindrome da
shock tossico, sindrome da cute ustionata.
Tutti gli altri stafilococchi, coagulasi-negativi, mannitolo-non fermentanti, non aureus, cutanei e cos via
hanno come capo classe lo Staphylococcus epidermidis e causano tutti nel complesso infezioni diverse:
infezioni da protesi e cateteri, infezioni urinarie nosocomiali, infezioni respiratorie ed ematogene (quindi la
prima causa di endocarditi sono anche gli stafilococchi coagulasi-negativi).
I classici patogeni sono in linea di massima pi resistenti agli antibiotici di quelli che fanno parte della flora
dellorganismo perch negli anni hanno subito un continuo contatto con gli antibiotici.
Quindi unaltra definizione dal punto di vista della resistenza la seguente: MRSA (staphylococcus aureus
meticillino-resistente) e MRSE (staphylococcus epidermidis meticillino-resistente).
Gli stafilococchi sono importantissimi in medicina per la grande quantit di infezioni negli ospedali dovute
agli stafilococchi. La maggior parte degli stafilococchi vivono nellambiente, sono responsabili per esempio
del sapore, dellodore dei salumi (vivono in presenza di sale); solo una parte responsabile di patologie
umane.
Le varie specie di stafilococchi presenti in tutto lorganismo sono ad esempio: saprophiticus, capitis ecc... Le
specie rare nelluomo e pi presenti negli alimenti sono i micrococchi.
STREPTOCOCCHI
Cocchi Gram-positivi disposti a catenelle o a coppie. Sono immobili, asporigeni, hanno la capsula; la parete
da classici Gram-positivi e le terminazioni antigeniche si trovano allesterno.
Una pi facile, pi rapida e pi clinica classificazione si basa sulla caratteristica emolisi degli streptococchi
(che non sono gli unici germi emolitici). Crescono su un terreno che lagar sangue, dove si osservano 3
tipologie di emolisi: vi sono streptococchi che dimostrano unemolisi completa -emolisi, che si presenta
come un alone trasparente), chiamati
-emolitici; vi sono streptococchi che presentano unemolisi
incompleta
-emoglobina), che sono chiamati -emolitici
(poich lalone di -emolitici o
viridanti); il terzo tipo di emolisi lanemolisi data dagli streptococchi anemolitici (che non provocano
emolisi).
Unaltra classificazione (che quella pi accreditata e pi scientifica) quella di Lancefield che classifica
tutti gli streptococchi in base al possesso di una sostanza e li suddivide in relazione a diversi antigeni per
gruppi antigenici di Lancefield da A ad H e da K a V. A noi interessano fondamentalmente 2 gruppi: gruppo
A e gruppo B di Lancefield; un altro streptococco caratteristico del genere che lo pneumococco
(Streptococcus Pneumoniae) esula da questa classificazione.
Le classificazioni sono diverse, ci sono anche classificazioni biochimiche ma quella pi utilizzata quella che
tiene conto dellemolisi.
-emolitico di gruppo A di Lancefield sinonimo di Streptococcus Pyogenes;
-emolitico di gruppo B di Lancefield sinonimo di Streptococcus Agalactiae.
Microbiologia - Medicina e Chirurgia polo A 2012/2013 - sbobinature lezioni
33
Il Pyogenes il pi importante fra tutti gli Streptococchi per la frequenza di malattie di cui responsabile,
come la faringite, piodermite, erisipela, cellulite (infezione del tessuto connettivo dovuta alla produzione
delle citotossine), fascite necrotizzante, febbre reumatica, glomerulonefrite e scarlattina. Lo Streptococcus
Agalactiae invece il responsabile della vecchia sepsi puerperale che portava a morte madri e figli al
momento della nascita ed tornato di grande attualit.
-emolitici (20 gruppi di Lancefield) ma si comportano pi da
opportunisti o da patogeni minori.
Gli
streptococco
-emolitici sono tipici nel cavo orale (lagente eziologico della carie uno
-emolitico o viridante) e sono anche la principale causa di endocardite, quindi sono
-emolitici ci aiuta a distinguerli dal
-emolitico nello stesso cavo orale.
Altro patogeno classico lo Streptococcus Pneumoniae, che un diplococco disposto come due lancette
unite.
Caratteristiche di patogenicit degli Streptococchi
Gli Streptococchi hanno diverse sostanze: le proteine tipo-specifiche, proteina M e proteina T, la capsula; e
soprattutto i fattori di virulenza degli Streptococchi sono 2 lisine: la streptolisina S e la streptolisina O che
lisano i linfociti e si utilizzano per una importante reazione diagnostica che il titolo antistreptolisinico, TAS
(anticorpi che si sviluppano contro la streptolisina).
Vi sono tante esotossine e una classica la tossina responsabile della scarlattina, detta anche tossina
eritrogenica; la scarlattina (di cui prima si moriva nella prima infanzia) uninfezione faringea da
strept
-emolitico produttore di tossina eritrogenica con laspetto classico di malattia esantematica
con la lingua a fragola.
-emolitico di gruppo A sono moltissime: angina, faringotonsillite
streptococcica acuta, otite, meningite, polmonite, mastoidite e cos via; la complicazione principale di
queste infezioni che a distanza di decenni vi sono delle sequele suppurative e non suppurative. Le
sequele non suppurative, cio non legate allinfezione, sono la glomerulonefrite post-streptococcica e la
febbre reumatica acuta; sono dette non suppurative perch non sono legate al microrganismo ma sono
delle reazioni da immunocomplessi che si svolgono nellorganismo contro gli stessi anticorpi formati verso il
microrganismo. Le sequele suppurative sono invece quelle legate al microrganismo, che si hanno a livello
del SNC, delle ossa, delle articolazioni a seguito della migrazione dal sangue.
La faringotonsillite da streptococchi si trasmette per via aerea.
La diagnosi consiste nel tampone faringeo (si coltiva su agar sangue, si nota lemolisi, si identifica il ceppo)
oppure si fa un test rapido, al fine di evitare somministrazioni di antibiotico inutili perch la faringotonsillite
da streptococco frequente, ma la met delle faringiti virale e laltra met batterica.
Solo lo
-emolitico di gruppo A ultrasensibile alla penicillina e quindi dovrebbe essere
trattato sempre al cento per cento con la penicillina G; nel caso in cui non si possa fare, si ricorre agli
antibiotici di seconda scelta: i macrolidi, leritromicina (usati se c allergia alla penicillina).
Microbiologia - Medicina e Chirurgia polo A 2012/2013 - sbobinature lezioni
34
Anche la scarlattina unangina streptococcica complicata e da quando c la penicillina anche la scarlattina
molto contenuta.
Lo
-emolitico di gruppo B
microrganismo che viene monitorato attentamente in gravidanza e deve essere presente in determinate
quantit, altrimenti la paziente pu presentare complicanze gravi: se linfezione viene trasmessa al neonato
si localizza nel SNC e porta a meningite ecc... con mortalit seria. La resistenza un po diversa, quindi si
usa p
-lattamici per eliminarlo o ridurlo di molto.
Lo Streptococco Pneumoniae ha la forma di diplococco a lancetta ed responsabile di una grave forma di
polmonite pneumoniae (polmonite lobare acuta); i microrganismi pneumoniae causano tutti affezioni
polmonari (la tubercolosi in primis): micoplasma pneumoniae, clamidia pneumoniae, klebsiella
pneumoniae, legionella pneumofila, streptococcus pneumoniae ecc..., si localizzano in vari tratti
dellapparato respiratorio, causando quindi vari tipi di polmonite: interstiziale, lobare ecc... Gli
-emolitici.
Il materiale patologico nel caso della polmonite sarebbe lespettorato, ma nel lavaggio bronchiale passano
tutti i vari viridanti del cavo orale; quindi ci sono delle prove per misurare la sensibilit dello Pneumococco,
tra le quali vi loptochina. Vi sono tantissimi fattori di virulenza: la pneumolisina, la capsula, gli acidi
teicoici. La cosa tipica che vi sono 81 sierotipi di pneumococco, alcuni dei quali pi patogeni e verso i quali
attualmente la ricerca e lindustria hanno fatto in modo di mettere a punto dei vaccini che sono oggi quasi
obbligatori nellinfanzia e che sono utili per prevenire le complicanze a livello del SNC (vaccino antipneumococcico).
Le patologie sono: bronchite, polmonite (i batteri in questo caso si moltiplicano negli spazi alveolari);
sintomo la tosse produttiva. La cosa importante che si forma un materiale purulento perch sia gli
streptococchi che gli stafilococchi sono considerati germi piogeni, che spesso interagiscono con i fagociti,
con i leucociti; quindi il primo impatto di queste infezioni si ha a livello dellimmunit aspecifica.
Altre affezioni delle vie aeree sono la sinusite e lotite da pneumococco, la meningite nei neonati e negli
adulti immunodepressi.
La diagnostica attuata mediante esame microscopico, esame culturale su terreni al sangue ed
evidenziazione dello pneumococco optochina-sensibile, per differenziarlo dagli altri streptococchi.
La terapia: la maggior parte sono sensibili alla penicillina, ma la resistenza anche molto comune e quindi
lantibiogramma o dei saggi preliminari sono obbligatori.
Gli Streptococchi viridanti causano endocarditi successive alle estrazioni dei denti soprattutto in soggetti
immunodepressi o con valvulopatie ecc. Tra tutti il pi importante lo Streptococcus mutans.
Lultimo gruppo di streptococchi sono quelli anemolitici, che venivano chiamati streptococchi di gruppo D
oppure enterococchi; di fatto vi sono 2 streptococchi: Streptococcus fecalis e Streptococcus fecium che
sono responsabili di infezioni, resistenti a tutti gli antibiotici.
Per quanto riguarda gli streptococchi, le classificazioni sono tante, i gruppi sono moltissimi, ma i principali
da un punto di vista clinico sono: patoge
-
Microbiologia - Medicina e Chirurgia polo A 2012/2013 - sbobinature lezioni
35
emolitici e cos via. Unaltra classificazione degli streptococchi, quella biochimica (poco usata) in relazione
alla fermentazione di ippurato, esculina, uso del sale ecc... Quindi si usa la classificazione che si basa sulla
presenza dellemolisi.
Altri Gram-positivi sono i corynebacteri che sono dei germi a clava, di cui il pi importante del gruppo il
corynebacterium diphteriae, agente eziologico della difterite, malattia oggi rarissima perch c il vaccino
preparato con la tossina purificata (a seguito della trasduzione fagica viene acquisita la caratteristica
genetica di formare la tossina). Laccertamento caratteristico perch per il corynebacterium diphteriae c
una colorazione particolare e la crescita su particolari terreni.
I corynebacteri sono numerosi sulla cute come gli stafilococchi epidermidis cutanei, sono frequentissimi e
di grande impatto nelle infezioni ospedaliere; corynebacteri anaerobi sono responsabili dellacne. Tra i
corynebacteri vi sono sia gli anaerobi che gli aerobi come anche tra gli streptococchi; la componente
anaerobia molto significativa: fra gli anaerobi pi importanti vi sono i corynebacteri e tra i cocchi anaerobi
vi sono: peptococcus e peptostreptococcus.
Nellambito della stessa famiglia dei corynebacteri vi sono altri microrganismi, uno di questi la listeria, che
si trova anche negli alimenti, resiste in frigorifero e causa delle patologie molto caratteristiche nel tratto
genito-urinario.
Un altro gruppo di Gram-positivi quello dei bacilli che hanno la spora e appartengono a 2 generi: 1)
genere bacillus, il cui microrganismo patogeno pi importante il bacillus anthracis, agente eziologico del
carbonchio; 2) genere sporigeno ma anaerobio il gruppo dei clostridi, che vivono nellintestino delluomo
e degli animali, da commensali senza dare alcun fastidio, sono mobili per la presenza di flagelli, sono lunghi,
hanno laspetto classico di bacilli Gram-positivi, ed essendo anaerobi hanno un metabolismo particolare: in
anaerobiosi si svolge la fermentazione anaerobia (scissione delle proteine in ambiente anaerobio con
formazione di altre sostanze anaerobie: putrefazione).
Le spore vengono formate quando i microrganismi escono dallambiente che consono; allesterno
lossigeno fa in modo che formino la spora che rimane nellambiente a tempo indeterminato (anni, secoli,
decenni); questa spora, quando si va a localizzare in un distretto dellorganismo congeniale (in cui si trova
ambiente anaerobio, 37 C, pH ottimale, sostanze da degradare), colonizza e causa danni.
I clostridi sono moltissimi (una cinquantina); i patogeni classici sono il Clostridium Tetani, il Clostridium
Botulinum, il Clostridium Difficile; il principale del gruppo il Clostridium Perfringens, ma tutti gli altri
clostridi (compresi questi) si chiamano tutti clostridi istotossici (clostridi della mionecrosi, clostridi della
gangrena gassosa) che causano patologie nei tessuti molli (dalla cellulite anaerobia alla gangrena gassosa).
Le spore si trovano nellambiente esterno e, a seguito di traumi o lesioni, o a seguito di patologie varie
(come il diabete), spesso si localizzano in un anfratto e, trovandosi in un ambiente anaerobio e in condizioni
di metabolizzare, utilizzano le sostanze che sono presenti (ad esempio il piede diabetico o una lesione
causata da un incidente o un trauma causano unalterazione del microcircolo con scarso apporto di sangue
e ossigeno), germinano, quindi riformano i batteri che iniziano a riprodursi in maniera notevole utilizzando
le sostanze presenti nellarea di necrosi. La fermentazione anaerobia genera gas (gangrena gassosa),
responsabile del famoso crepitio che il medico avverte quando tocca la parte interessata, rossa ed
Microbiologia - Medicina e Chirurgia polo A 2012/2013 - sbobinature lezioni
36
edematosa (in passato era necessario amputare larto per salvare la vita del paziente). Se la lesione
profonda nel muscolo, si parla di mionecrosi, se rimane nel connettivo si parla di cellulite anaerobia (sono
tutte infezioni dei tessuti molli in cui vi e la fermentazione di sostanze da parte dei clostridi con
produzione di gas, che occlude ancora di pi i vasi sanguigni con conseguente ischemia e successiva necrosi;
la parte interessata va in putrefazione e si deve ricorrere a sistemi drastici di drenaggio o di rimozione).
Il Clostridium Perfringens produttore anche di tossine intestinali, quindi causa anche tossinfezioni
alimentari.
Il Clostridium Difficile vive pure nellintestino normalmente, un commensale e diventa opportunista in
determinate condizioni: a seguito di somministrazione di antibiotici, di sterilizzazione dellintestino o altro,
poich tutti gli altri microrganismi scompaiono, prolifera in maniera abnorme e, producendo le sue
esotossine, causa una patologia non comunissima, ma molto grave che la colite pseudomembranosa; il
principale responsabile di epidemie di diarrea in ospedale, a seguito di manovre iatrogene; quindi la colite
pseudomembranosa una patologia iatrogena perch la causa unazione o una terapia medica.
I ceppi producono delle tossine molto potenti che spesso nei soggetti immunodepressi ledono
completamente la mucosa con gravi complicanze (emorragie, diarrea sanguinolenta) e anche la morte.
La terapia difficile perch la patologia stata causata proprio dalla terapia quindi gli unici utilizzabili sono
i glicopeptidi come la vancomicina. Molti sono gli antibiotici che causano la colite pseudomembranosa
alterando la componente anaerobia: la flora intestinale rappresentata per il 99% da anaerobi e viene
soppressa da questi antibiotici, mentre il Clostridium Difficile resiste.
Clostridium Tetani: la spora penetra accidentalmente nei tessuti, si localizza nel luogo della lesione ma non
diffonde, metabolizza con produzione di una tossina potentissima, verso la quale c un vaccino preparato
con la tossina purificata (anatossina).
Il quadro clinico del tetano caratterizzato da contrattura dei muscoli: paralisi spastica, opistotono, riso
sardonico dovuto al trisma (mandibola serrata).
La diagnosi pu essere clinica ma il clostridium tetani si pu isolare dalla ferita molto facilmente. La terapia
consiste nellantibiotico ma bisogna somministrare farmaci molto pi importanti come il curaro, il siero.
Clostridium Botulinum: esistono diversi tipi di botulismo: da ferita, da inalazione, infantile, alimentare.
Quello che ci interessa maggiormente il botulismo alimentare che dovuto alla classica tossina botulinica;
ne esistono diverse forme in relazione anche ai diversi tipi di alimento, alle diverse zone geografiche; la
malattia dovuta allingestione di alimenti in cui viene prodotta la tossina botulinica.
Il clostridium botulinum vive nellintestino, viene eliminato, forma la spora che si trova negli alimenti: se
lalimento sottovuoto, conservato (manca lossigeno), la spora germina, trova condizioni idonee (fattori
nutrienti, mancanza di ossigeno) e forma il batterio, che a sua volta forma la tossina; lingestione della
tossina produce il botulismo a seguito di eventi (manca la liberazione di acetilcolina) che portano alla
paralisi flaccida. La tossina botulinica viene sfruttata anche in chirurgia plastica con adeguate
concentrazioni.
Microbiologia - Medicina e Chirurgia polo A 2012/2013 - sbobinature lezioni
37
Dalla spora si forma il batterio, ma la tossina si forma in determinate condizioni (ambiente neutro),
pertanto la formazione si ostacola abbassando il pH, mettendo nelle conserve sale, aceto; la tossina
termolabile e col calore viene eliminata.
Il termine Botulinum deriva dal fatto che i primi casi di morte, osservati in Germania, furono dovuti
allingestione di wurstel, salsicce.
Il sintomo classico nel caso del botulismo la visione doppia (diplopia); un altro sintomo la difficolt di
linguaggio.
La tossina non facile da ricercare, si pu trovare nel sangue, nelle feci, nel contenuto gastrico e negli
alimenti contaminati.
Lincubazione in media 12-36 h dopo lingestione del cibo ma ci sono incubazioni anche pi lunghe.
Difficilmente si danno antibiotici, ma si deve provvedere immediatamente con un siero che contenga gli
anticorpi o con stricnina.
Il Clostridium Perfringens responsabile di tossinfezioni alimentari perch elabora una tossina particolare. I
cibi in cui si pu trovare questa tossina sono le carni cotte, insaccati, polpette ecc...
Lalimento contaminato in cui si moltiplicano i batteri e si produce tossina viene ingerito, quindi si hanno
tossinfezioni o intossicazioni (non infezione come nel colera): intossicazione quando c una sindrome
tossica, quando si ingerisce la tossina (intossicazione stafilococcica o botulismo); tossinfezione invece
quando c la tossina preformata o la produzione di tossine nellorganismo (gli sporigeni hanno la tossina
preformata).
Lezione 7
(nb. Secondo me si parla di micobaterri no microbatteri Ale Bella- )
Oggi rimaniamo nei gram positvi per, i microbatteri di cui parleremo saranno differenti in quanto hanno
delle caratteristiche molto particolari.
Insieme a questi microbatteri, troviamo anche un gruppo di microrganismi, fra i quali lactinomyces, il
nocardia, la streptomyces, che hanno come suffisso il nome mices, mico che mette gi in evidenza una
caratteristica particolare, ovvero il tipo di rapporto con limmunit che non sar pi aspecifica, ma sar di
tipo specifico e precisamente cellulo-mediata.
Le lesioni e la stessa immunit, la diagnostica dei microbatteri e la clinica hanno delle caratteristiche
differenti, e per la prima volta sentiremo parlare di macrofagi e granuloma.
Vedremo quindi implicate cellule immunitarie specifiche come i macrofaci e tutto un complesso di reazioni
studieremo approfonditamente pi in avanti.
Microbiologia - Medicina e Chirurgia polo A 2012/2013 - sbobinature lezioni
38
Quando faremo i virus, o anche qualche microrganismo, vedremo che questi prendono rapporto con
lorganismo scatenando unaltra immunit sempre specifica, ma di tipo umorale (gli anticorpi).
Nel caso dei cocchi, abbiamo visto che limmunit era di tipo aspecifico, rappresentata dal tipico foruncolo,
il pus pieno di granulociti.
Questo al medico serve perch, nei soggetti affetti da AIDS o che fanno chemioterapia antisoppressiva,
immunosoppressiva in corso di trapianti, oncologica, guarda caso le infezioni che subentrano pi
frequentemente, sono quelle legate proprio alla mancanza di queste cellule immunitarie.
Non a caso, la tubercolosi e tutte le infezioni da microbatteri che vedremo, sono spesso complicanze dei
malati di AIDS, la cui morte sopravviene per le infezioni profonde da candida, da miceti ed inoltre,
linfezione pi grave la pneumocistosi (pneumocisti scarini). Sono quindi tutti microrganismi che vengono
contrastati normalmente dallimmunit specifica cellulare.
Le lesioni che scateneranno i microbatteri saranno differenti, perch non avremo tossine, e la famiglia pi
importante rappresentata da batteri gram positivi, asporigeni, aerobi obbligati che quindi necessita di
ossigeno e crescono in superficie.
Nella loro parete cellulare, da gram positivi, hanno un elevatissimo numero e contenuto di lipidi. Questi
sono molto complessi e li troveremo elencati nel libro.
Non per importante conoscere la composizione dei singoli lipidi, quanto il fatto che questo elevato
contenuto di lipidi, cere, sostanze particolari, condiziona tutte le caratteristiche relative alla coltura e alla
patogenesi dei microbatteri.
Infatti, hanno una parete in cui, per la presenza di questi lipidi, gli scambi metabolici vengono molto
rallentati, crescono con dei tempi enormemente pi lunghi degli altri batteri.
Ad esempio, un medico che chiede la risposta dopo le classiche 24 ore, per sapere se sia cresciuto al
laboratorista il microbatterio, dimostra che non li conosce in quanto, per dare risposta negativa sono
necessari almeno 20 giorni se non un mese.
quindi importante per la diagnostica perch, per far crescere questi microbatteri che richiedono molto
tempo, necessario evitare la crescita degli altri microrganismi. Questo lo si fa sfruttando unaltra
caratteristica, sempre derivante dalla presenza delle cere e dei lipidi, che conferiscono ai microbatteri una
grande resistenza agli agenti chimici e fisici.
Questo vuol dire che nella diagnostica per far crescere questi microbatteri in laboratorio, evitando lo
sviluppo degli altri germi contaminanti pi rapidi che sommergerebbero la coltura, addirittura si usano acidi
forti, quali acido cloridrico, e basi forti come lidrossido di sodio.
I microbatteri sono resistenti anche a molti altri disiffettanti e nellambiente resistono per mesi ed anni
nella polvere e nelle pareti.
Le infezioni si contraggono per via aerea.
Oltre a condizionare la diagnostica e la capacit di poterli vedere in laboratorio, questi microbatteri hanno
unaltra caratteristica, ovvero quella della colorazione sempre determinata dalla parete ricca di lipidi.
Microbiologia - Medicina e Chirurgia polo A 2012/2013 - sbobinature lezioni
39
Si usa una delle due colorazioni essenziali in microbiologia che molto complessa, utilizza pi di un
colorante e sfrutta la bacillo acido alcol resistenza (ziehl-neelsen).
Utilizza delle sostanze particolari, ma la caratteristica data dal fatto che, trattando il vetrino fissato e
colorato con il primo colorante (blu-violetto per convenzione) e poi con acidi ed alcali, questi si decolorano
e assumono il secondo colorante che fa assumere queste caratteristiche (fa riferimento alla slide).
Si tratterebbe di gram positivi, ma vengono pi comunemente identificati con questa colorazione.
Facendo riferimento alle slide:
Bacilli tubercolari insieme alle cellule infiammatorie,
Bacilli antitubercolari insieme alle cellule,
Bacilli tubercolari (in rosso) dentro le cellule.
Quindi, la presenza di queste cere influenza diverse caratteristiche ed anche la patogenicit.
Ovviamente, hanno una serie di antigeni superficialmente come tutti i batteri.
Questi antigeni vengono utilizzati nel test alla tubercolina (reazione di Mantoux):
essa mette in evidenza se in un soggetto che ha avuto contatto con il bacillo tubercolare, esista
unimmunit. Questo un tipo di immunit cellulare che determina, nel soggetto in cui i macrofagi sono
stati attivati con la risposta al primo contatto dellantigene, il fatto che questi macrofagi si localizzano e
vanno a formare un ammasso di cellule, un granuloma, nei punti in cui stata iniettata la tubercolina,
ovvero il nuovo antigene. quindi unimmunit che si richiama e che si mette in evidenza con la presenza di
questo ammasso di cellule immuni.
Nella reazione della tubercolina, ovviamente vi sono i falsi positivi perch la reazione si ha nel caso dei
microbatteri.
I microbatteri hanno un habitat enormemente rappresentato, in quanto resistono al sole, allessiccamento,
alla disidratazione e chiaramente li troviamo nelle acque e nel suolo.
Sono anche presenti in moltissimi animali:
Omeotermi (mammiferi)
Eterotermi (uccelli, insetti)
Dal punto di vista della tassonomia andiamo a vedere i microbatteri che ci interessano. Ovviamente, il
principale del gruppo il mycobacterium tuberculosis variet homini che lagente eziologico della
tubercolosi polmonare.
In effetti, la maggior parte delle infezioni, determinate da questo microbatterio, sono infezioni che
scatenano dei processi localizzati al polmone e a diversi altri organi.
Microbiologia - Medicina e Chirurgia polo A 2012/2013 - sbobinature lezioni
40
Esiste per anche una forma di tubercolosi causata da microrganismi diversi, mycobacterium tuberculosis
var bovis, che causavano spesso tubercolosi renale e la si acquisiva specialmente a seguito di ingestione di
cibi in cui era presente il microbatterio di questa variet.
Viene definito bovis perch la tubercolosi una malattia che condividiamo con tanti animali, tra cui i
bovini (oggi sono vaccinati).
Oggi difficile assumere il mycobacterium tuberculosis var bovis con il latte, in quanto, anche se proviene
da mucche affette da tubercolosi, questo viene pastorizzato.
Il mycobacterium tuberculosis var bovis inoltre un ceppo di tubercolosi leggermente attenuato e
costituisce il BCG (Bacillo di Calmette e Gueren) che il prodotto di una lunga serie di passaggi (236) su un
terreno solido, biliato e glicerinato, per ottenere un ceppo diminuito nella virulenza in grado di svolgere
azione immunogena (scatenare limmunit), usato nella vaccinazione.
La vaccinazione deve essere fatta da coloro che hanno specialmente contatto con gli animali, ma anche da
coloro che fanno parte del personale sanitario e parasanitario, che deve risultare indenne da tubercolosi,
ovvero che alla reazione di Mantoux non manifesta questo granuloma o ammasso di cellule che mi
dimostra invece che il soggetto ha avuto contatto con la tubercolosi.
Contatto con la tubercolosi: molto spesso, per tutta la vita ed in et scolare si ha, a seguito di inalazione
per via aerea di goccioline infette, la formazione del complesso primario o tubercolo primario nel
polmone, ovvero di una lesione nodulare granulomatosa, vale a dire un ammasso di cellule immuni che si
localizzano e vanno a circoscrive i bacilli nel parenchima polmonare e nei linfonodi.
Il complesso primario una volta che si forma, calcifica e rimane a vita, il che vuol dire che avvenuto il
contatto con la tubercolosi (reazione di Mantoux positiva).
Non si ha quindi bisogno di vaccinarsi, tuttavia, nel corso della vita, questo tubercolo va incontro a necrosi e
le possibilit sono diverse: il tubercolo calcifica e rimane a vita oppure, a seguito di nuova infezione o
riattivazione, ha unevoluzione. Levoluzione pu essere rappresentata dal fatto che arriva ad erodere i vasi
sanguigni, passano in circolo i microbatteri che si diffondono in varie sedi, quali meningi, ossa, apparato
renale.
Di fatto, non vi un organo o un apparato in cui non sia descritta fra tutte le patologie anche la tubercolosi.
Con il tubercolo si pu per anche avere una fluidificazione, ovvero il materiale allinterno si riattiva, si
moltiplica, si formano quindi catene polmonari e quindi si innesca la vera malattia tubercolare. I sintomi
sono chiaramente il sangue, lemottisi e la difficolt respiratoria.
La tubercolosi polmonare arriva a causare in un paziente questo aspetto (fa riferimento alla slide).
Essa molti diffusa, in Europa pi controllata tanto che, nel periodo successivo alla II Guerra Mondiale
stata tanto ridotta che tutti i tubercolosari sanatori dellepoca sono stati chiusi.
Nellultimo decennio invece tornata con grande frequenza, con grande antibiotico-resistenza e, a causa
anche della presenza di immigrati non immuni come noi alla tubercolosi, ha raggiunto una diffusione
veramente notevole.
Microbiologia - Medicina e Chirurgia polo A 2012/2013 - sbobinature lezioni
41
Le zone rosse (nella slide) sono quelle in cui pi frequente ma, come precedentemente detto,
limmigrazione e i viaggi ormai sono tali che il contatto con la tubercolosi comunissimo, specialmente in
ambito sanitario dove maggiormente concentrato.
La terapia: non abbiamo un solo antibiotico adatto, ne abbiamo diversi. Tuttavia, dal momento che per
crescono lentamente, queste terapie devono durare mesi e di conseguenza, in questi mesi i batteri
elaborano resistenza. Pertanto i protocolli per la tubercolosi sono sempre diversi e vengono sempre
aggiornati, e prevedono antibiotici (streptomicina ad esempio) e chemioterapici tipici e specifici.
Come detto la volta scorsa, la streptomicina per la resistenza, abbiamo detto che la induce spessissimo e
quindi nei protocolli bisogna tenerne conto di queste resistenze. Di conseguenza, la terapia antitubercolare
un capitolo a se stante.
Lo strato esterno lipidico quindi anche importante perch gli antibiotici entrano in maniera molto
stentata. Molto spesso queste cellule in vivo sono circondate da questo materiale in colliquazione che si
disgrega, e quindi lantibiotico arriva con ancora pi difficolt, crescono lentamente e quindi emergono
resistenze.
Nella slide esempi di terapia e farmaci antitubercolari: non sono pochi, molto spesso si usano in
associazione; troviamo quelli di prima e seconda scelta, si alternano fra di loro per evitare le resistenze, ma
sicuramente al primo posto troviamo la streptomicina (fa parte degli amminoglicosidi) e la rifamicina
(agisce sui ribosomi). Troviamo anche sostanze chimiche, chemioterapici veri e propri che hanno i loro
meccanismi dazione che impareremo nelle prossime materie.
La durata: un trattamento prima non durava meno di 4 mesi, oggi con determinate associazioni si pu
ridurre ma sempre opportuno fare terapie di mantenimento.
Slide: Kock che ha scoperto sia il bacillus anthracis che quello tubercolare.
Slide: le forme di tubercolosi ai vari apparati: sistema nervoso, endocrino, respiratorio, genitourinario,
intestinale, ossa, polmoni e linfoghiandole.
Sintomi: tosse, dolore, perdita di peso, sangue.
Diagnosi: viene fatta in laboratorio di microbiologia. Si semina, si tratta questo materiale patologico,
addirittura nelle forme renali si raccoglie lurina di 1-2 giorni, si centrifuga e si concentra.
Un tempo la tubercolosi era una delle malattie che richiedeva per la conferma, in quanto sono molti i
microbatteri che possono crescere, la prova biologica che veniva fatta nellanimale di laboratorio: se la
cavia moriva di tubercolosi allora lidentificazione era precisa.
Oggi non si utilizzano pi gli animali, per cui lidentificazione viene fatta con le sonde a DNA (gli animali
prima venivano utilizzati anche per la presenza delle tossine stafilococciche: veniva presa una rana
decerebrata, si inoculava il materiale, e se questa invertiva il movimento peristaltico, voleva significare che
vi era la presenza della tossina. Lo stesso veniva fatto con i gattini neonati).
Tutto questo per dire che il problema della tubercolosi non facilmente risolvibile e richiede unattenzione
a s.
Microbiologia - Medicina e Chirurgia polo A 2012/2013 - sbobinature lezioni
42
Lincidenza pi alta la troviamo in Africa, seguono poi lAsia e il Brasile.
Laltro microbatterio classicamente patogeno il mycobacterium leprae.
lagente eziologico della lebbra, detto anche Morbo di Hansen, per cui attualmente non si chiamano pi
lebbrosi ma di ansenisti quelli che ne sono colpiti.
La lebbra abbastanza diffusa nel mondo, in Brasile, India, Madagascar e anche in Italia, dove vi sono i
luoghi in cui viene curata e vi anche unassociazione italiana.
La lebbra si trasmette sempre per via aerea attraverso le secrezioni, infatti i lebbrosi venivano coperti ed
isolati ed erano considerati impuri (non si conosceva il germe e quindi si pensava fosse una disgrazia a
seguito di punizioni divine o di eventi naturali).
In ogni citt vi erano i lazzaretti dove mettere quelli che avevano la peste isolati, e i lebbrosari dove invece
venivano messi i lebbrosi, recintati, chiusi e lontani da tutti.
La lebbra esiste in diverse forme, ma si basa pure sulla formazione di noduli, di tubercoli, di processi che
portano allo sviluppo di tre forme: indeterminata, tubercoloide o nervosa e la lebbra nodulare o
lepromatosa.
Anche la lebbra ha delle terapie particolari, con antibiotici e chemioterapici. Anche in questo caso si tratta
di un microbatterio lentissimo, per cui avremo terapie lentissime.
Slide: la lebbra nervosa quella che fa in modo che si perdano pezzi interi di mani, naso, in quanto si perde
la sensibilit. Si va anche incontro ad atrofia muscolare.
Slide: la lebbra nodulare questo ammasso di tubercoli.
Infine, oltre alla lebbra e alla tubercolosi, abbiamo una marea di altri microbatteri che vengono definiti con
varie dizioni: microbatteri atipici, microbatteri non tubercolari, MOTT (mycobacteria other than tubercle
bacilli), microbatteri diversi e microbatteri minori.
Fra i pi importanti abbiamo: il mycobacterium marinum, il cansasi, lintracellulare ed il mycobacterium
avium (degli uccelli), lafricanum, lasiaticum, il chelone, il fortuitum, scrofulaceum, lulcerans, ecc..)
Ne troviamo per molti altri e vengono divisi secondo classificazioni interessanti (fotocromogeni, scoto
cromogeni, ecc..).
Tutti quanti nel loro complesso sono diffusi nellambiente ma causano malattie, soprattutto in ospiti
immuno-compromessi per i motivi visti prima.
Le malattie vanno dalle forme polmonari allinteressamento dei linfonodi inguinali e regionali.
Questi microbatteri atipici sono di grande attualit in considerazione delle manovre terapeutiche che
consentono a certi pazienti di sopravvivere in condizioni anche di immuno-depressione marcata.
Grassi e cere sono suddivisibili, tipico il nicolil-3-alosio che troveremo nei nostri testi come fattore
cordale che tutti i microbatteri patogeni posseggono.
Microbiologia - Medicina e Chirurgia polo A 2012/2013 - sbobinature lezioni
43
I lipidi facenti parte del batterio lipidico non hanno funzione antigenica, cio produzione di immunit, che
invece posseggono i batteri proteici.
I terreni per fare crescere i microbatteri devono contenere luovo ricco di lipidi, glicerina, verde di
marachite e altre componenti (a Catania importante conoscere il terreno di Petragnani che stato il
primo professore di igiene a creare la branca di microbiologia).
chiaro, che dovendo coltivare i microbatteri, che crescono molto lentamente, non si usano le piastre ma
delle provette dove si evita, quanto pi possibile, lintroduzione di aria che potrebbe inquinare con
microrganismi provenienti dallesterno.
Inoltre, i microbatteri crescono in superficie con aspetto caratteristico grazie alla presenza del fattore
cordale.
Chiaramente vi sono anche: i microbatteri a rapida crescita, quelli a lenta crescita, quelli che crescono al
buoi e quelli che crescono in presenza di luce.
Slide: gruppo dei MOT, con un elevato numero di microbatteri per cui, quelli che fanno da capofila sono i
mycobacterium avium complex (ne racchiude due) e i mycobacterium fortuitum complex.
Danno tutti infezioni dei tessuti molli, infezioni disseminate, infezioni respiratorie, polmoniti, infezioni
cutanee e linfadeniti.
Mostra diverse slide:
Slide: aspetto che hanno tutti i microbatteri.
Slide: 500 lebbrosi presenti in Italia.
Slide: lebbra lepromatosa con la perdita di parti del corpo.
Slide: anche animali, selvatici o meno, possono essere infettati dal microbatterio della lebbra come
da altri, e molto spesso vengono trasmessi alluomo.
Slide: mano ad artiglio tipica della lebbra e la faces leonina successiva.
Slide: perdit della sensibilit e di varie parti del corpo.
Slide: lesione classica con il tubercolo leproni.
Rapporti tra microrganismo e uomo
Simbiosi: rappresentato dalla foto del paguro Bernardo e della conchiglia.
Il termine simbiosi vuol dire vivere assieme, e questo vivere assieme pu essere configurato in tre modi
diversi:
Con vantaggio reciproco delluno e dellaltro, e verr definita come simbiosi mutualistica;
Microbiologia - Medicina e Chirurgia polo A 2012/2013 - sbobinature lezioni
44
In maniera indifferente, cio un organismo fornisce cibo e ricovero, mentre laltro ringrazia come
un commensale e non causa danno. Parleremo di simbiosi commensale (dalla flora microbica
ricaviamo un vantaggio perch, con la presenza dei commensali come colonizzatori impediamo che
altri microrganismi trovino la breccia per colonizzare e causare infezioni. Ci vuol dire che la flora
batterica ci aiuta non perch fornisca sostanze particolari, ma perch con la sua presenza
impedisce che altri microrganismi ne approfittino. Luomo per sfornisce loro temperatura, grasso,
alimenti, umidit, ecc...);
Con beneficio solo di uno dei due, che prolifera a danno dellospite. Verr definito parassitismo.
Il parassita quello che utilizza una struttura (animale o piante) per causare danno ed ottenerne
sostentamento.
Fra i parassiti abbiamo: i virus (parassiti delle cellule), i pidocchi (parassiti delluomo), tutti i germi patogeni
che indubbiamente diventano parassiti perch, ricavano vantaggio e si moltiplicano a svantaggio
dellindividuo.
Fra i rapporti biologici pi intimi che vi siano, abbiamo quello fra il corpo umano ed i batteri che lo
colonizzano fin dalla nascita. Questo rapporto poi si modifica diverse volte, per svariati motivi.
Nelle varie zone si formano degli habitat omogenei: la flora commensale dellintestino, del cavo orale e del
tratto vaginale. Il che vuol dire che le mucose ospitano una grande variet di microrganismi che possiamo
dividere in due gruppi principali:
I residenti, che sono i veri commensali;
Quelli di passaggio che, anche patogeni o potenzialmente patogeni, si trovano l ma non
colonizzano se presente la flora commensale residente.
Se quindi facciamo una fotografia della flora, vedremo che questa composta da differenti elementi ma,
dei microrganismi solo i residenti saranno commensali, gli altri infatti non trovano spazio, e se lo trovano
diventano patogeni.
Lezione 8
Facciamo oggi una parte di gram negativi.
Gram negativi: caratteri tipici.
FAMIGLIA ENTEROBACTERIACEAE
La famiglia pi importante quella delle Enterobacteriaceae, che la pi numerosa. Habitat: intestinale. Gli
antigeni sono: K, H e O.
Tassonomia: una famiglia molto numerosa e comprende diversi generi, per di questi generi quelli
patogeni classici sono il genere Salmonella e il genere Shigella.
Genere Citrobacter, Klebsiella, Enterobacter e Serratia hanno una grande importanza come microorganismi
ospedalieri che causano infezioni in ospedale, specialmente in soggetti immunodepressi; quindi gruppo KES
(Klebsiella, Enterobacter, Serratia).
Microbiologia - Medicina e Chirurgia polo A 2012/2013 - sbobinature lezioni
45
Gli altri come il Proteus, la Providencia, la Morganella, sono microorganismi che si ritrovano sia in ospedale
sia anche in tutti i soggetti con infezioni urinarie.
Il genere Yersinia tra gli enterobatteri, ma di fatto un batterio differente, un coccobacillo gram negativo,
agente eziologico della peste (Yersinia pestis). Quindi sono presenti tanti generi con diversi gradi di
patogenicit.
Un genere che racchiude tutti i gradi di patogenicit lEscherichia coli, nellambito del quale troviamo: i
patogeni potenziali, specialmente nellapparato urinario, perch hanno delle fimbrie adesive particolari, e
troviamo anche gli opportunisti.
Se dislocati dallintestino (e vale per tutti) si ritrovano in altri organi o apparati; non sono patogeni che
rispondono ai postulati di Koch con le classiche leggi dei patogeni, ma causano infezioni anche molto gravi.
Coshanno in comune tutti questi microorganismi? La diagnostica, con tante differenze che derivano
dalluna o dallaltra specie, dalluno o dallaltro genere e hanno un differente profilo di antibiotico
sensibilit. Se per i patogeni classici bastano (e non solo per questa famiglia) antibiotici come le tetracicline,
le penicilline, i macrolidi, quindi di non grande spettro, per i microorganismi che invece sono di pertinenza
intestinale, ma possono essere patogeni in altri distretti (in ospedale) in determinati soggetti, poich la
pressione selettiva a cui sono stati abituati ha creato resistenze notevoli, paradossalmente devono essere
utilizzati antibiotici pi ad ampio spettro, pi attivi, tipo fluorochinoloni, aminoglicosidi e cos via.
GENERE ESCHERICHIA
Sono bacilli; questo genere racchiude un po tutte le patogenicit. I patogeni per lintestino sono ceppi
particolari che hanno la capacit di produrre tossine o di manifestare unazione invasiva.
Ceppi: enterotossigeni, enterovasivi, enteropatogeni, enteroadesivi, enteroemorragici. Tranne questi ceppi,
ma di grande impatto, patogeni potenziali sono quei ceppi di escherichia che nel 90% dei casi sono patogeni
per esempio per lapparato urinario, perch hanno adesine specifiche. Quindi patogeni potenziali o
opportunisti determinano infezioni del sistema nervoso centrale, peritoniti, setticemie, infezioni ustionate
cos via. Gli antibiotici sono sempre quelli. Mentre questi ceppi possono essere trattati con tetracicline o
altro, gli altri vogliono cefalosporine seconda e terza, monobattamici, carbapenemici fluorochinoloni e
aminoglicosidi , gli antibiotici pi importanti che ci sono.
GENERE KLEBSIELLA
Non patogeno intestinale. Ci sono diverse specie (tipo K. ozaenae, ecc ), la pi importante Klebsiella
pneumoniae. Le patologie sono le stesse di escherichia coli: setticemia, infezioni urinarie, tutte ma non
intestinali; inoltre con laggiunta che i ceppi nosocomiali sono spesso resistenti.
Come la Klebsiella abbiamo anche l Enterobacter, la Serratia, il Citrobacter.
Caratteristica: capsula che conferisce aspetto mucoso alle colonie.
GENERE PROTEUS
Importante per le infezioni urinarie, perch produce ureasi, quindi in quellhabitat si trova molto bene. E
presente dove vi siano calcoli o patologie renali.
Vi sono diverse specie: P. vulgaris, P. morganii, e tante altre.
Microbiologia - Medicina e Chirurgia polo A 2012/2013 - sbobinature lezioni
46
Idem per gli antibiotici.
Caratteristica dei Proteus: flagelli. Per cui in coltura hanno un aspetto sciamante.
Come la Klebsiella e il proteus abbiamo la Serratia. Per quanto riguarda Citrobacter e Enterobacter, hanno
grosso modo le stesse caratteristiche.
Parliamo dei patogeni veri: SALMONELLA, SHIGELLA E YERSINIA.
GENERE SALMONELLA
La tassonomia continuamente rimaneggiata, per cui pu essere che nei diversi testi vi siano diversi
raggruppamenti. C la salmonella enterica con diverse sottospecie e le varie altre salmonelle minori che
sono tantissime: S. enteriditis, S. choleraesuis, S. typhimurium.
Le pi importante sottospecie della salmonella enterica, che d il nome alla malattia, la salmonella typhi e
poi ci sono le salmonelle paratyphi A,B,C, tutti agenti eziologici di salmonellosi dette maggiori, per
distinguerle dalle minori.
Salmonellosi maggiori: trasmissione a circuito oro-fecale, perch sono eliminate dallintestino (ci sono i
portatori sani) e ingerite direttamente o indirettamente, tramite mosche, vettori, alimenti, mani, scarsa
igiene, e vanno a localizzarsi nella mucosa dove svolgono la loro patogenicit caratteristica, passano poi nel
sangue e si distribuiscono ai diversi organi, compresa la cistifellea, il fegato, e si ritrovano infatti anche nella
bile, nel sangue in determinati periodi quando c il rialzo febbrile.
Salmonellosi minori: sono un po pi blande, per sono trasmesse con meccanismi anche differenti, in
quanto essendo presenti nellintestino di tanti animali come i polli (pollami), ed essendo presenti nei
mangimi degli animali gli antibiotici, queste salmonelle sono resistenti e, se rimangono nei prodotti di
animali (uova, carni) riescono a causare forme di patologie gastrointestinali dove la differenza un po nella
diagnostica ma soprattutto negli antibiotici perch essendo resistenti devono essere trattati con antibiotici
ad altissimo spettro tipo il cloramfenicolo, cefalosporine, monobattamici, carbapenemici.
Per tifo e paratifo bastano antibiotici anche a minore spettro come cotrimossazolo, ampicillina,
cloramfenicolo, tetracicline, cio antibiotici meno energici, tutto in relazione al fenomeno della resistenza.
Quindi un circuito per via alimentare, non proprio oro-fecale, ma alimentare per ingestioni di alimenti
contaminati con materiale fecale degli animali di allevamento (conigli, polli, uova e derivati come il gelato).
GENERE SHIGELLA
E un patogeno classico di cui vi sono diverse specie. E agente eziologico di una patologia gravissima che
la dissenteria bacillare (per distinguerla dalla dissenteria medica che farete tra i protozoi).
Questa pure a circuito oro fecale classico e sensibile a tetracicline, ampicillina, aminoglicosidi.
Quali sono le specie pi importanti? La S. dysenteriae, S. boydii, S. flexneri, S. sonnei.
GENERE YERSINIA
Microbiologia - Medicina e Chirurgia polo A 2012/2013 - sbobinature lezioni
47
Vi sono diverse specie. Era la vecchia Pasteurella, ora questa rimasta un genere a s e la yersinia stata
spostata.
La Yersinia pestis lagente eziologico della peste.
Le altre specie di yersinia, tra cui Y. enterocolitica, sono responsabili di gastroenteriti classiche (latte,
cioccolato, carni suine).
Antibiotici: tetracicline, aminoglicosidi, beta-lattamici come lampicillina e cos via.
La peste una malattia che rientra tra gli enterobatteri, ma non un vero e proprio enterobatterio. Dal
punto di vista genetico hanno visto che lomologia base purina-pirimidina pi simile agli enterobatteri che
ai coccobacilli con cui era imparentata prima per caratteri fenotipici.
La yersinia un coccobacillo con una classica colorazione bipolare, cos come si vede vicino a questi globuli
rossi (slide). Fa assumere laspetto a spilla di balia a questo preparato. La peste non comune da noi, ma ha
importanza storica ed caratteristica la trasmissione, perch i batteri invadono pulci e roditori, tra cui i
topi, e luomo. I roditori trasmettono la peste. La peste diffusa in: Brasile, Africa, Asia, e Stati Uniti per
quanto riguarda la peste trasmessa da animali, in zone agricole soprattutto.
La peste polmonare la forma peggiore, la peste setticemica si distribuisce agli organi, la peste bubbonica
la forma pi eclatante.
Come si fa ad accertare la presenza degli enterobatteri in laboratorio? Lesame microscopico serve a poco,
perch non si distinguono. Per quanto riguarda la salmonella, o si isola dal sangue e dalle feci, ma si deve
ben isolare dagli altri organismi contaminanti utilizzando terreni molto selettivi e identificandola con tutti i
vari test biochimici. Oppure nel caso della salmonella c uno dei tre esami-siero logici che si fanno in
microbiologia, detto tecnica di Widal, che ricerca anticorpi nel siero e si vanno a mettere in evidenza gli
antigeni H e O della salmonella, ciliari e somatici.
La profilassi ovviamente ligiene.
GENERE BRUCELLA
Altro genere di cui possiamo parlare vicino agli enterobatteri la Brucella, perch la brucellosi spesso si
confonde con il tifo e la diagnosi utilizza la seconda delle reazioni sierologiche che si fanno in batteriologia
che la Wright. Molto spesso si fanno assieme Widal e Wright.
E un microorganismo differente, pi simile alla Yersinia.
Agente eziologico: la Brucella, di cui ci sono diverse specie. La pi classica la Brucella melitensis. La
brucellosi una delle tante zoonosi, una patologia che condividiamo con gli animali. B. abortus, B. suis sono
tutte brucelle che causano patologie gravi negli animali. Luomo come si infetta? Con i prodotti animali
(latte, latticini non pastorizzati) o dal contatto con le secrezioni degli animali (veterinari).
Cosa fa la brucella? Da noi trova un serbatoio particolare (la Sicilia ha un livello di brucellosi elevato), e i
serbatoi sono gli animali domestici.
Forme di brucellosi: la forma di brucellosi pi tipica lalimentare ma non a circuito oro-fecale, proprio
alimentare, come per le salmonellosi minori; c anche la via transcutanea, aerogena (inalazioni),
transcongiuntivale, ma riguardano categorie professionali a rischio. Le brucelle possono sopravvivere anche
Microbiologia - Medicina e Chirurgia polo A 2012/2013 - sbobinature lezioni
48
a temperature di frigorifero. Laspetto delle colonie questo (slide), laspetto al microscopio quello di
cocco bacilli con una colorazione particolare (31:22 qualcuno tossisce).
Anche questi entrano attraverso i cibi, vanno nel sangue, si riproducono nei linfonodi (macrofagi) e si
localizzano negli organi del sistema reticolo endoteliale tra cui fegato, milza, midollo, linfonodi. Ovviamente
c una risposta immunitaria cellula-mediata (la prof dice che la salta perch non labbiamo fatta) e
riguarda interleuchine, linfociti, ecc, attivati, e questi microorganismi vengono poi distrutti dai macrofagi.
Anche qui c una risposta immunitaria ben specifica. La reazione di Wright viene sfruttata per la
diagnostica.
Patogenesi, labbiamo gi descritta: polimorfonucleati, linfonodi, sangue, distribuzione. Da dove si isola?
Come la salmonella o dal sangue o dalle feci. Dal sangue durante il rialzo febbrile. Si pu isolare anche dalla
milza, dalla bile, dai linfonodi, insomma una malattia che ha un decorso particolare e una sintomatologia
caratteristica.
Ci sono una forma tipica e delle forme atipiche. E una malattia lunga, e lunga anche lincubazione.
Le caratteristiche sono:
artromialgie (dolore alle articolazioni);
sudorazioni notturne;
linfoadenomegalie, quindi linteressamento dei linfonodi;
epato-splenomegalia;
la tipica febbre ondulante (febbre che ha un andamento a denti di sega: va via e torna con
escursioni anche molto alte).
Complicanze: dal sangue si pu localizzare anche in altri distretti, come nelle meningi.
Diagnosi: si effettua in laboratorio, dal sangue o dal midollo, ma soprattutto si utilizza la reazione
sierologica, ovviamente c anche la possibilit di conferma con le sonde e la Xar (??34:40); esame dal
sangue quantitativo, la ricerca degli anticorpi dal siero. Quindi diagnosi diretta e indiretta.
Identificazione: sono organismi che crescono difficilmente, e richiedono anzi dei supporti nutritivi molto
particolari e anidride carbonica.
FAMIGLIA VIBRIONACEAE, GENERE VIBRIO
Vediamo un altro organismo che ha a che fare con lintestino: il vibrione del colera. Anche qui ci sono una
marea di microorganismi del genere Vibrio; a noi interessa la specie V. cholerae, anche se altre specie sono
importanti come V. alginolyticus, V. parahaemolyticus, per le patologie ospedaliere. Molti vibrio e molto
germi sono tipici delle infezioni da sushi. Si trovano nelle acque di mare, nelle acque dolci e possono
causare gastroenteriti.
Tra i diversi generi della famiglia ci interessa il Vibrio cholereae, ma anche lAeromonas , che ha
unimportanza crescente.
I generi della famiglia Vibrionaceae sono tantissimi, alcuni neanche di pertinenza umana, ma tra quelli di
pertinenza umana abbiamo Plesiomonas, Vibrio e Aeromonas.
Microbiologia - Medicina e Chirurgia polo A 2012/2013 - sbobinature lezioni
49
Caratteristiche: sono vibrioni, cio hanno la forma a virgola, sono gram negativi, sono molto sensibili
allacidit e quindi devono crescere su terreni con pH leggermente alto.
Specie: Vibrio cholerae
E un patogeno classico, tipico perch produce una esotossina potentissima e una enterotossina di cui
abbiamo parlato, formata dalla subunit attiva e dalle altre subunit leganti, e agisce alterando il ciclo
delladenilato ciclasi, con fuoriuscita di acqua dal lume intestinale, e determina una diarrea che porta a
morte lindividuo per disidratazione in mancanza di una terapia.
Qual la terapia? Gli antibiotici sono: tetracicline, macrolidi.
C anche un vaccino, cos come c un vaccino per la salmonella, e sono dei vaccini molto utilizzati. Il colera
diffuso in Bangladesh, india.
Per quanto riguarda il V. cholerae, tralasciando le altre specie, possiamo identificare sierogruppi e sierotipi.
C un seriogruppo1, un sierogruppo detto bengala e altri sierogruppi che danno casi sporadici di colera. Il
sierogruppo che ci interessa luno, in cui esistono due biotipi: classico e El tor.
Sulla tossina e sulla sintomatologia abbiamo gi detto. La terapia richiede anche una cura sintomatica per
ristabilire le condizioni del paziente.
Si coltiva in laboratorio, non ci sono indagini anticorpali.
HELICOBACTER PYLORI
Un altro microorganismo che ha importanza tra i gram negativi nellapparato gastro intestinale
lHelicobacter pylori. Ha una forma a virgola e faceva parte prima di un altro genere, Helicobacter. La specie
Helicobacter pilori poi diventata un genere a s. Ci sono diverse specie di Helicobacter, tra cui H. pilori la
pi importante. Ha una storia caratteristica: un certo Marshall in Australia, per dimostrare che era
patogeno, lo inger per fare un esperimento.
E un microorganismo tra i pochissimi in grado di vivere, grazie alle sue caratteristiche, nel pH acido
presente nella mucosa gastrica, perch ha la caratteristica di avvolgersi quasi in una bolla, in cui c una
maggiore alcalinit e una minore acidit grazie al fatto che produce ureasi. La patologie che provoca sono:
gastrite cronica attiva e lulcera gastrica ma anche lulcera duodenale e molti dicono che scateni processi di
carcinoma gastrico duodenale, ma non stato accertato; tuttavia un fattore che aumenta la prognosi di
determinati stati di ulcera e di patologie gastriche in generale. Purtroppo, poich forma questa bolla
resistente agli antibiotici, perch lo raggiungono difficilmente. Vi la recidiva molto spesso; devono essere
fatte terapie in associazione, che prevedano sia antiacidi come il bismuto colloidale, sia antibiotici come il
macrolide claritromicina o lampicillina.
Perch lHelicobacter patogeno? Aderisce allepitelio, penetra nelle cellule e si infiltra tra le cellule
(questo ovviamente lo fanno tuti i batteri che danno infezione) e ha dei fattori di adesivit e degli enzimi
che degradano le cellule. Lureasi produce NH3, tampona lacidit gastrica e impedisce che questi ioni liberi
aumentino e ?(47:00) lacidit. Lureasi importante perch viene sfruttata anche a livello diagnostico.
Ovviamente per danneggiare le cellule delle membrane ha fosfolipasi, ATPasi.
Microbiologia - Medicina e Chirurgia polo A 2012/2013 - sbobinature lezioni
50
Possiede una citotossina vacuolizzante che induce vacuolizzazione, cio crea comparti nel citoplasma delle
cellule della mucosa gastrica e si nota quando si fa la biopsia e lesame anatomopatologico delle cellule. Ha
anche unallucinasi.
Scatena linfiammazione che alla base dellinsorgenza dei tumori.
La diagnostica: usa metodiche invasive e non invasive.
Metodiche invasive: endoscopia e biopsia; lanatomopatologo colora i frammenti bioptici e vede la
conformazione della cellule e colora il materiale che fa vedere tipicamente le virgolette gram negative nel
tessuto.
LHelicobacter si pu coltivare, e ha bisogno anche di vivere in una ridotta anaerobiosi e in terreni ricchi;
dalla biopsia si procede allesame diretto microbiologico.
Diagnostica non invasiva: ce n una che si fa come screening, come il breath test e lurea test, cio la
ricerca dellureasi, quindi una quantit di urea che con certe apparecchiature viene messa in evidenza, e la
ricerca dellantigene nelle feci. Lantigene si ricerca anche nelle urine.
LHelicobacter lo troviamo nella saliva, nei denti, nel contenuto dellintestino, e non si sa quale sia il cibo
che lo trasmette, ma deve essere acquisito per via alimentare (il vero ingresso non ancora noto).
Mondo occidentale: pare che due terzi della popolazione siano infettati dal batterio.
Ci sono infezioni legate alla scarsa igiene tipica del terzo mondo e le infezioni del mondo occidentalizzato
dovute proprio allHelicobacter e alla Clavidia.
Trattamento antibiotico: terapie combinate, inibitori di acidit, claritromicina, amoxicillina, antiacidi
inibitori della pompa protonica.
LHelicobacter ha un aspetto flagellato, ed un microaerofilo che cerca da solo la sua protezione dentro le
cellule gastriche.
Test del respiro: si fa anche nel laboratorio del medico. Ci sono pro e contro (falsi negativi e falsi positivi). E
importante la gastroscopia in caso di dubbio.
Lezione 9 I GRAM -NEGATIVI.
HAEMOPHILUS
Tra i Gram- negativi hanno un ruolo importante le specie del genere HAEMOPHILUS. Questi sono
pertinenza soprattutto di chi far l'otorino, il pediatra perch facendo parte della flora delle prime vie
aeree, sono tra i microrganismi maggiormente responsabili di tutte le affezioni delle prime vie aeree
nonch la prima causa di visita e di terapia in Italia delle infezioni delle vie respiratorie superiori.
Ricordiamo che le vie respiratorie superiori sono: faringe, orofaringe, naso, orecchie e gola.
Limitatamente ad alcune specie, verso le quali ci sono attenzioni e vaccino, descritto un ruolo patogeno
importante come agenti eziologici di meningite soprattutto in et pediatrica.
Microbiologia - Medicina e Chirurgia polo A 2012/2013 - sbobinature lezioni
51
La morfologia tipica dell'haemophilus quella di bacilili pleomorfi, cio hanno diverse forme anche se
solitamente sono coccobacilli .
Caratteristiche: sono immobili e fermentanti e pertanto, fermentando, sono aerobi , anaerobi facoltativi.
Vi sono diverse specie di isolamento umano.
Una delle caratteristiche peculiari dell'haemophilus un'esigenza di fattori nutrienti presenti nel sangue
che sono essenziali per la sua crescita.
Anche i nomi come haemophilus emoglobinophilus,haemophilus emoliticus mettono in evidenza la
necessit di avere nei terreni di coltura il fattore decimo e il fattore quinto.
Dove si trovano?
Nella flora normale del tratto, ma ovviamente anche nella flora vaginale e nel canale intestinale.
COLONIZZAZIONE
La colonizzazione avviene sempre e pi dell'80% della popolazione ha l'haemophilus.
Tali batteri sono dei germi esigenti: devono avere sangue, ma anche altri fattori nutrienti , altrimenti non
crescono.
La specie sicuramente pi importante l'haemophilus influenzae.
Tra le altre specie spiccano l'haemophilus ducreyi in quanto responsabile dell'ulcera venerea molle e altre
come l'haemophilus parainfluenzae anch'esse responsabili di influenze respiratorie.
Un'altra specie da ricordare l'aegyptus.
HAEMOPHILUS INFLUENZAE:
un microrganismo particolare, ve ne sono diverse variet.
Esistono ceppi capsulati (patogeni) e non capsulati.
Esistono diversi sierotipi, ma il pi patogeno il sierotipi B.
La trasmissione avviene tramite loa via aerea.
Le patologie, specialmente quelle conseguenti all'haemophilus influenzae sieritipo B riguardano sia malattie
dell'albero respiratorio sia meningiti.
Anche i ceppi non capsulati possono essere patogeni, ovviamente non saranno gli agenti eziologici della
meningite, ma sono responsabili di malattie dell'albero respiratorio.
Dobbiamo ricordare qual il materiale patologico: nel caso delle infezioni respiratorie sono gli essudati
(orale, nasale..), ma dato che l'haemophilus fa parte,assieme allo streptococco beta emolitico e al
Microbiologia - Medicina e Chirurgia polo A 2012/2013 - sbobinature lezioni
52
pneuomocco, di questa flora, ritrovare in un tampone nasale l'haemophilus non ci dice proprio nientee si
tende a presupporre che l'eziologia sia da riscontrare in questo microrganismo.
Cosa voglio dire? Si isola da queste secrezioni, ma nel momento in cui so deve andare a riconoscere quello
che fa parte della flora e quello che fa parte dell'infezione difficile, quindi solitamente non si fa
l'accartamento riguardante il materiale patologico. Invece, come abbiamo detto, lo streptococco isolabile
dal cavo orale.
Lo haemophilus inoltre agente eziologico delle otiti, ma le otiti sono: le otiti esterne maligne (come dei
grossi foruncoli) che risalgono alla flora cutanea , e le otiti medie che riguarda ci che c' all'esterno del
timpano quindi (a meno che il timpano sia perforato) internamente non si pu risalire all'essudato. Anche
questa quindi una diagnosi presuntiva.
Nel caso della meningite invece il materiale patologico liquor cefalorachidiano in cui la colorazione di
gram ci aiuta.
VACCINO
Dal 1995 tra le vaccinazioni raccomandate nella prima infanzia. E' preparato con l'haemophilus capsulato
di tipo B che quello maggiormente patogeno.
Un altro agente eziologico della meningite lo pneumococco con diversi sierotipi e verso i quali vi un
vaccino raccomandato nell'infanzia.
NEISSERIE
Le neisserie sono dei microrganismi Gram-negativi, cocchi , che si dispongono a chicchi di caff ( a 2 a 2,
appaiati).Sono abbastanza labili e tutte fanno parte della nostra flora (mucose boccale,genitale).
Due sono le specie patogene:
1: Neisseria meningitidis: agente eziologica di una meningite, nota da pi tempo rispetto l'haemophilus ;
2: Neisseria gonorrhoeae: agente eziologico della gonorrea, trasmessa per via sessuale ( solo tramite questa
via le neisserie possono sopravvivere all'ambiente esterno nel quale non sopravviverebbero se non ci fosse
immediatamente il contatto con un organismo recettivo).
Le neisserie necessitano di diversi fattori : il sangue deve essere lisato (parliamo di agar sangue
cotto/cioccolato) cos da vivere in una condizione di una leggera microaerofilia e capnifilia perch devono
avere piccoli concentrazioni di CO2.
In coltura si presentano come delle colonie piccole, luminiscenti e in vivo hanno la caratteristica di entrare
all'interno dei granulociti. Ovviamente la manifestazione evidente per il contatto con i granulociti il pus.
MENINGITE
Vi sono diverse forme cliniche di meningite. Si tratta di un'affezione del SNC. Nel caso della neisseria
meningitidis o i microrganismi si moltiplicano tumultuosamente con conseguenze quali la coagulazione
Microbiologia - Medicina e Chirurgia polo A 2012/2013 - sbobinature lezioni
53
intravasale disseminata, shock, morte; oppure se si moltiplicano pi lentamente si hanno conseguenze
meno devastanti.
Tali batteri entrano quindi dalle vie aeree superiori, passano nel sangue e si localizzano nelle meningi.
Ricorderete la presenza della barriera ematoencefalica che condiziona la terapia di molte infezione del SNC
in quanto non consente a molti farmaci la penetrazione. Tale barriera pu essere integra o lesionata.
Nel caso della meningite batterica il liquor torbido poich ci sono i leucociti, cellule e pus che sono
rendono chiara l'infezione batterica, in questo caso parliamo di meningite settica.
Se il liquor limpido ci saranno virus,protozoi,miceti, cio altri microrganismi che non sono inglobati nei
granulociti con decorso asettico.
Quindi la tipica manifestazione delle neisserie ritrovarle nelle cellule.
Quali sono le manifestazioni del batterio?
Oltre la ricerca del microrganismo vi sono diversi valori biochimici.
Sintomi della meningite
I sintomi sono gravi perch a parte alcuni segni classici che identificano la meningococco, vi sono tutte le
patologie a carico del sistema nervoso: vomito, cefalea, opistotono, sintomi motori, sintomi sensiti e
neurovegetativi.
Un altro sintomo la porpora meningococciga, cio la manifestazione cutanea dell'infezione sistemica con
carattere emorragico.
Cosa si fa dal materiale patologico? Si effettua una colorazione di Gram su un vetrino. Vi sono anche
metodiche rapide, ma la diagnosi deve essere molto particolare e serve da conferma.
TERAPIA
Vi sono molti antibiotici, ma dobbiamo tenere presente che i farmaci devono attraversare la barriera
ematoencefalica. Anche i surfa medici sono utili.
GONORREA
La gonorrea un'infezione sessualmente trasmessa con una serie di complicanze gravi, sia maschili che
femminili, a livello dell'apparato genitale.
La manifestazione caratteristica, il prelievo fatto con tamponi e la diagnosi si basa, oltre che sulla
colorazione, sull'esame culturale . Inoltre si compie la ricerca mediante sonde di DNA.
Le complicanze sono anche extragenitali: occhi. Per prevenire l'oftalmo al neonato ad esempio, che si
trasmette tramite il canale del parto dalla madre al figlio, si effettua una profilassi con collirio a base di
grani d'argento.
Altre complicazioni sono a livello delle articolazioni e delle ossa.
Microbiologia - Medicina e Chirurgia polo A 2012/2013 - sbobinature lezioni
54
La sensibilit agli antibiotici vede soprattutto la prystinamicine , la spectinomycina e anche le penicilline.
Non si ha una particolare difficolt di trattamento.
LEGIONELLA
E' un Gram-negativo molto particolare. Ha la caratteristica di vivere in natura soprattutto in presenza di
acqua
ad
una
determinata
temperatura.
L'habitat
infatti
rappresentato
da
rubinetti,docce,fontane,impianti di raffreddamento, nelle acque di rete.
Negli ospedali e in determinati soggetti immunodepresse (in rianimazione) i respiratori di ossigeno e
l'acqua possono trasmettere la legionella determinando delle malattie: legionellosi.
Le legionelle sono frequenti nei serbatoi perch vivono in alcuni protozoi ciliati, come amebe, che li
proteggono e li trasmettono.
Trasmissione
La trasmissione avviene attraverso la respirazione. Sono dei microrganismi esigenti, difficili da coltivare,
necessitano di molte sostanze nutrienti e di tempo pari a una settimana per crescere.
Fattori di rischio
La legionellosi colpisce maggiormente gli anziani, i malati cronici, i soggetti con immunodeficienza acquisita.
La legionella pi importante la legionella pneumophila che agente eziologico di una polmonite
caratteristica: malattia dei legionari.
Le patologie associate alla legionella sono legate all'apparato respiratorio.
Della legionella pneumophila vi sono 14 sierotipi e il pi patogeno il sierotipo 1.
LEGIONELLOSI
Le legionelle penetrano tramite le vie respiratorie, raggiungono i polmoni, vengono fagocitati dai
macrofagi, eludono i primi meccanismi di difesa e si moltiplicano all'interno dei macrofagi.
Quali sono le malattie?
Tutte le infezioni si chiamano legionellosi, ma la pi caratteristica la malattia dei legionelli, ma anche la
polmonite di bradstreet e altri casi sporadici.
Da cosa sono sostenute? Sono abbastanza recenti tali malattie e devono essere notificate alle autori
competenti .
Malattia dei legionari
Durante un raduno di legionari nel 1976 a Philadelphia, 221 persone si ammalorono e 34 morirono.
Responsabile della malattia era la legionella, ma non si conosceva la sua fonte. Oggi sappiamo che l'origine
della legionella era da addebitare all'impianto di condizionamento.
Microbiologia - Medicina e Chirurgia polo A 2012/2013 - sbobinature lezioni
55
E' una malatti a grave, la pi grave tra le legionellosi. Inizia come un'influenza per poi aggravarsi. Anche la
diagnostica per immagini aiuta nella diagnosi.
Simile alla malattia dei legionari la polmonite di bradestreet. Si verific nelle vicinanze dell'albergo di
Philadelphia.
Un'altra malattina simile la febbre di Pontiac.
Le misure di prevenzione devono essere compiute a livello delle tubature , mentre a livello del singolo
bisogna evitare che in caso di rianimazione vi siano respiratori o acqua, infatti si usa acqua sterile e
respiratori monouso per evitare il contatto con l'ambiente.
ANTIBIOTICI
La legionella non particolarmente resistente. Gli antibiotici utilizzati sono le tetracicline e i macrolidi
PSEUDOMONAS
Altrettanto presente nell'acqua, ma totalmente differente il genere pseudomonas di cui vi sono
moltissime specie differenti.
E' tra i pi resistenti (anche a sostanza disinfettanti) e ubiquitari microrganismi presenti.
Vive e si moltiplica nei disinfettanti, negli sciroppi ecc. Cresce su tutti i terreni.
La specie pi importante la pseudomonas aeruginosa.
La pseudomonas subisce tanti rimaneggiamenti. E' un microrganismo che ha una particolare gravit e
incidenza nei reparti di ventilazione assistita.
Alcune specie erano responsabili delle complicazioni della fibrosi cistica (la mucoviscidosi).
Un altro microrganismo spesso presente lo stenotrophomonas maltophilia che prima era pseudomonas
maltophilia. Che vuol dire? Nel corso degli anni vi sono stati molti cambiamenti nella classificazione degli
pseudomonas, ma in ogni caso vengono trattati come bacilli Gram-negativi non fermentanti.
NB: sono gli enterobatteri i bacilli Gram-negativi fermentanti.
CARATTERISTICHE
Non fermentano, si procurano l'energia tramite la respirazione. Sono quindi aerobi e hanno il ciclo di Krebs,
sono ossidanti. Nel citocromo hanno l'ossidasi che utile per distinguerli dagli enterobatteri.
Gli pseudomonas sono mobili, privi di capsula, presentano un ciuffo di flagelli ad un'estremit e producono
pigmenti. Tali pigmenti sono verdi se producono pioverdina.
Un altro nome della pseudomonas aeruginosa bacillo piocianeo (del pus verde). Anche in coltura gli
pseudomonas crescono con tale aspetto verde.
Altri pigmento sono la piorubina e la fluorescein o pioverdina .
Microbiologia - Medicina e Chirurgia polo A 2012/2013 - sbobinature lezioni
56
Le colonie sono flagellati ed enormi, crescono su tutti i terreni.
HABITAT
Quanto pi ubiquitario possibile. Inolte gli pseudomonas sono tra i maggiori produttori di biofire.
Colonizzano le plastiche e le resine.
Gli pseuodomonas sono inoltre resistenti agli antibiotici difatti sono tra i principalo responsabili di infezioni
in campo ospedaliero.
INFEZIONI PRINCIPALI
Non sono patogeni, nell'ambito degli pseudomonas vi sono due specie infettive per gli animali. Causano
nell'uomo infezioni nelle vie urinarie, alle ferite, a seguito di ustioni, oculari (vivono nei liquidi per lenti a
contatto), del sangue,respiratorie, del SNC,gastointestinali.
Hanno una grande invasivit: producono tossine che ledono la cellula (proteasi ecc) e in particolare
l'esotossina A.
Si tratta quindi di un patogeno opportunista.
Reparti a rischio: cardiochirurgia, centro ustioni, rianimazione e cos via.
Aspetto: bacilli Gram-negativi che si coltivano sia in terreni specifici che aspecifici.
L'identificazione degli pseudomonas avviene principale avviene tramite l'ossidasi ( hanno anche un odore
caratteristico).
ANTIBIOTICI
Ovviamente gli pseudomonas sono molto resistenti agli antibiotici, quelli di elezione sono le penicilline
resistenti e di altissimo spettro ( di ultima generazione); i carbapenemici; gli aminoglicosidi; il
fluorochinoloni e cos via.
Lo pseudomonas produce in modo massiccio la beta-lattamasi.
I microrganismi ambientali, cio quelli che si trovano in ambiente ospedaliero, presentano una resistenza e
un'attivit che altri patogeni non hanno. Hanno subito una pressione selettiva cos elevati che gli
ambientali, oggi, sono pi resistenti dei patogeni. I facenti parte della nostra flora altrettanto.
La necessit dell'utilizzo razionale degli antibiotici parte anche da queste considerazioni.
BORDETELLA
Vi sono diverse specie, ma la pi importante la bordetella pertussis ,l'agente eziologico della pertosse.
E' difficile da crescere e produttore della tossina pertossica (ha diverse subinit)
Microbiologia - Medicina e Chirurgia polo A 2012/2013 - sbobinature lezioni
57
Lezione 10
Le clamidie e le rickettsie , che facciamo oggi , sono dei microrganismi a tutti gli effetti . Sono batteri molto
piccoli e non in grado di vivere una vita autonoma come abbiamo visto per tutti gli altri batteri . Non in
gradi di svolgere alcun processo metabolico se non allinterno delle cellule.
Come tutti i virus , sono parassiti endocellulari obbligati , che la stessa definizione che serve per definire la
particella virale. Ma sono chiaramente dei batteri , tecnicamente sarebbero gram negativi , hanno la parete
da gram negativi , svolgono la patogenicit da batteri. Hanno una forma rotondeggiante e hanno una specie
di bitorzolo da un solo lato ma non si sa il perch. Hanno la loro parete in peptidoglicano .
La clamidia , come tutti i virus , deve avere una fase dentro la cellula e una di trasporto nel mondo esterno.
Nel virus la parte esterna serve solo da collegamento e inietta il genoma , le clamidie sono per batteri ed
hanno due forme morfologiche completamente diverse. Allesterno c il corpo elementare che
infettante, che si attacca e serve per la sopravvivenza nel mondo esterno. All interno c invece il corpo
reticolare che non infettante ma serve alla moltiplicazione delle clamidie dentro le cellule .
Non possono vivere da sole perch non producono ATP, non sono in grado di procurarsi l energia
necessaria per svolgere il loro metabolismo e quindi la cellula serve loro per questo motivo . Il corpo
elementare quello che serve per la trasmissione , piccolo , rotondo e si lega ai recettori presenti sulla
superficie delle cellule . Inoltre, esso penetra nel fagosoma dove inibisce la fusione del fagosoma con i
lisosomi e quindi impedisce la lisi . Una volta che il corpo elementare entra nella cellula , i corpi elementari
si allargano , si ingigantiscono e si trasformano nei corpi reticolari . Per l energia utilizzano quella cellulare
ma sono in grado di sintetizzare tutti gli acidi nucleici , le proteine e cos via.
Sono batteri e quindi si dividono per scissione binaria. Il fagosoma , guardandolo alla colorazione , viene
scambiato per inclusione ed visibile al microscopio ottico e , ovviamente , i corpi reticolari si evolvono in
corpi elementari che vengono liberati dalla cellula come i virus . I corpi elementari servono per il trasporto e
per le successive infezioni nelle altre cellule .
Questo il ciclo della clamidia : l attacco alla cellula , la
fusione con il fagosoma , la riorganizzazione in corpi
reticolari grandi . Il corpo reticolare si moltiplica per
scissione : si rompe , si allarga , moltiplica tutte queste
clamidie , moltiplica tutti questi corpi elementari ,
finalmente la cellula si rompe e queste clamidie sono
pronte per andare ad attaccare le altre cellule . Questo
processo , con altre modalit , lo vedrete per i virus . Qua
vediamo il corpo reticolare grande , i corpi elementari
piccolini , queste sono le immagini al microscopio
elettronico . Osserviamo anche i vari cicli , tutto questo in
48 ore dalla prima infezione .
Hanno gli antigeni LPS come tutti gli altri gram negativi e
hanno anche degli antigeni specifici del genere e della
specie. Non hanno tossine , ( come non ce le avranno tutti i virus ) . Le malattie causate da clamidia
tendono a cronicizzare perch non sono in grado di evocare una risposta immunitaria in grado di eliminarli .
Microbiologia - Medicina e Chirurgia polo A 2012/2013 - sbobinature lezioni
58
Le specie di clamidia pi importanti sono quattro e di queste quattro , due sono essenziali in medicina . Una
la chlamydia trachomatis e l altra la chlamydia pneumoniae e la terza la chlamydia psittaci . Psittacus
il pappagallo , si tratta di un parassita di uccelli e mammiferi che a loro causa una malattia respiratoria
che si chiama psittacosi .
La chlamydia pneumoniae agente eziologico di una polmonite che, vedremo , ha caratteristiche simili a
quelle del mycoplasma ( pneumoniae ) che soprattutto importante nei ragazzini , bambini e giovani adulti
. Si dice andamento benigno e autolimitante , perch non un infezione gravissima e spesso
asintomatica . Per ha una diagnostica particolare .
Laltra specie la chlamydia psittaci che viene trasmessa dal contatto con colombe , pappagalli , tacchini .
Causa psittacosi , una specie di polmonite interstiziale . Non frequentissima . Sia la pneumoniae sia la
psittacosi sono trasmesse per via aerea e , ovviamente , per la psittacosi , i soggetti a rischio sono quelli che
lavorano con gli animali .
La specie pi importante la chlamydia trachomatis di cui la specie una ma vi sono tre diverse tipologie ,
chiamate biotipi o biovar . Una , come dice il nome , l agente eziologico del tracoma che un
infezione oculare gravissima . Una , l agente eziologico del linfogranuloma venereo , che un infezione
acquisita per via sessuale . La terza , il terzo biovar , responsabile di una polmonite fulminante ( murina ) .
Qual il problema ? un problema di adesivit dei corpi elementari . Tutte le cellule della mucosa del
tratto respiratorio , dell uretra , della cervice , dell endometrio , delle tube di Falloppio , del retto e della
congiuntiva possiedono i recettori per i corpi elementari . Per cui , il tracoma ,rarissimo , la polmonite
murina , il linfogranuloma venereo ( raro ) , e le infezioni dal clamidia sono tante che condizionano oggi
gran parte della ginecologia . Le uretriti da chlamydia trachomatis evolvono in malattie molto pi rare e
permanenti .
Il tracoma un infezione grave dovuta al fatto che le congiuntive si induriscono e indurendosi causano
lesioni della cornea . Alla lesione segue la formazione di una membrana che si pu anche infettare . Questa
membrana , ingrossandosi , porta alla cecit. E una malattia molto brutta con delle immagini
impressionanti e ovviamente il tracoma endemico , non da noi , ma in Medio-Oriente , Nord Africa e in
India . Si trasmette attraverso le mani , gli insetti , le mosche . E una malattia frequente in condizioni di
scarsa igiene .
Vediamo le infezioni da chlamydia trachomatis invece nell uomo e nella donna . Molto spesso le infezioni
da chlamydia trachomatis sono contemporanee o successive a quelle da Neisseria . Come anche la
Gonorrea , la sintomatologia passa inosservata . Nell uomo per motivi anatomici chiari molto pi
evidente , nella donna sono asintomatiche . Quindi le pi gravi complicanze, nella donna , sono la salpingite
, l endometrite e la malattia infiammatoria pelvica . Il neonato non da meno : se la madre portatrice di
chlamydia , passando per il canale del parto , le mucose genitale , oculare e respiratoria sono a rischio di
contrazione della chlamydia . Per cui , bisogna trattare i neonati con antibiotici e soprattutto saper
riconoscere l infezione da chlamydia . Nella diagnostica che normalmente si fa in laboratorio , se non viene
espressamente richiesta dal medico , non si cercheranno mai le clamidie perch richiedono delle
diagnostiche particolari .
L ultima delle patologie il linfogranuloma venereo , a trasmissione sessuale , rara qui da noi , molto
frequente in centro Africa . E percicolosa . Diagnosi: ovviamente , trattandosi di un batterio che vive all
interno della cellula , per isolare la clamidia , bisogna avere una coltivazione di cellule . Poi vedrete ,
Microbiologia - Medicina e Chirurgia polo A 2012/2013 - sbobinature lezioni
59
facendo virologia , che i virus si possono coltivare ma per coltivarli bisogna coltivare e mantenere in vita le
cellule . Bisogna comprarle nelle banche e poi si devono mantenere queste cellule vitali , forti . Quindi la
coltivazione in vitro della clamidia dentro le cellule fattibilissima per non facilmente disponibile in tutti
i laboratori , quindi si deve arrivare ad una diagnostica un po pi facile . O , per un sospetto diagnostico
ben preciso si pu fare la PCR , ricerca del DNA di una determinata specie , oppure , la pi semplice delle
reazioni , la ricerca di antigeni mediante reazioni immunoenzimatiche .
( A questo punto la professoressa mostra delle immagini con varie colorazioni di cui si limita ad elencare i
nomi , aggiunge pure che le ritroviamo in tutti i testi ) .
Il materiale patologico nel caso delle infezioni da clamidia , dato che bisogna prelevare delle cellule , ci sono
dei campioni da prelevare mediante endoscopia . Si prende un endoscopio e un piccolo spazzolino che
raschiando sulla mucosa va a prelevare delle cellule da utilizzare per l indagine . Il campione pu essere
ottenuto mediante rettoscopia o laparoscopia , con manovre endoscopiche atte al prelievo di un po di
cellule . La pi semplice delle diagnostiche , a parte la PCR , la colorazione al microscopio a fluorescenza
mediante anticorpi monoclonali fluorescenti .
Se si vogliono coltivare , bisogna sapere che le cellule sono specifiche e che non sono tutte uguali . Ci sono
colture cellulari che in relazione ai tipi diversi di virus ,si utilizzano per uno scopo o per un altro . Per
esempio , un ceppo che si utilizza sono le cellule HeLa , cellule tumorali di una donna che negli anni 60 si
chiamava Henrietta Lacks e si sono mantenute nelle banche delle cellule fino a ora . Sono molto usate in
virologia .
Antibiotici : ovviamente sono insensibili al trattamento con i farmaci attivi sulla parete perch questi non
passano all interno della cellula . Farmaco di elezione saranno le tetracicline e i macrolidi . La stessa cosa
sar per il micoplasma che non ha la parete cellulare e pertanto i farmaci di elezione saranno tetracicline a
macrolidi . Anche il micoplasma se non lo si cerca, non lo si trover mai . E d , parallelamente , lo stesso
tipo di infezioni .
RICHETTSIE
Quelle delle rickettsie una problematica molto importante e che desta moltissima attenzione anche nei
confronti delle strutture sanitarie . Per esempio , per le malattie trasmesse da zecche ci sono tante circolari
della regione siciliana che tendono a valutare la possibilit di prevenire queste infezioni . Non sono infezioni
nuove . Sono legate alla scarsa igiene , alla circolazione di animali parassiti come le zecche , i pidocchi , le
cimici e quantaltro .
In comune hanno il fatto che sono trasmesse da insetti e il fatto che hanno un tropismo particolare per gli
endoteli , il che vuol dire che la lesione caratteristica una specie di addensamento emorragico cutaneo
che si chiama petecchia . Questo lavoro dice che nel corso degli anni , gli organi mondiali che si
interessano di organizzazione tassonomica rimaneggiano la tassonomia e pertanto , se voi vedete , la
tassonomia si fa sull omologia basi purine , pirimidiniche ecc , le specie ,tipo la rochalimaea quintana
diventata bartonella quintana. La rickettsia tsutsugamushi diventata orentia . Cio si cambia genere e
appartenenza a un gruppo e a un altro . Quindi , vi una tassonomia classica ( che ritroviamo in tutti i testi )
e una tassonomia che invece si basa sulla omologia delle basi purine e pirimidiniche . L anaplasma
marginale stato accorpato a un altro gruppo . Quindi , famiglia rickettsiacee , famiglia bartonellacee ,
famiglia anaplasmatacee .
Microbiologia - Medicina e Chirurgia polo A 2012/2013 - sbobinature lezioni
60
La bartonella d una patologia che si chiama malattia da graffio di gatto . Quella delle rickettsiaceae si
deve studiare per alcuni generi particolari che sono la rickettsia , la rochalimaea , la coxiella .
Se dobbiamo andare a definire le patologie , le rickettsiae sono cos numerate ciascuna con la sua brava
malattia , lartropode associato e la distrubuzione.
Quello che si nota la geograficit estrema . La distribuzione dei microrganismi in relazione alla
distribuzione geografica dei parassiti . Ci sono malattie che interessano il mondo intero o altre localizzate , (
Thailandia , Russia ) , a seconda della distribuzione dei parassiti . Un altra cosa importante : i sintomi .
Questi molto spesso sono in comune , molto spesso tipici di un determinato microrganismo .
Rickettsia deriva da Ricketts che all inizio del 900 scopr la febbre bottonosa delle montagne rocciose .
Quindi , appartiene alla famiglia del genere rickettsia un gruppo di batteri intracellulari obbligati ( come le
clamidie ) , responsabili di alcune infezioni a carattere endemico trasmesse da artropodi che fungono da
serbatoio e ne amplificano il ciclo vitale .
L ordine del rickettsiales diviso in famiglie : rickettsiacee , bartonellacee e anaplasmatacee . Siccome c
grande confusione , per le rickettsie , prima di arrivare il genere , la famiglia viene divisa in trib .
A questo punto la famiglia delle rickettsie ha tre generi . La coxiella burnetii , la rochalimeae e il genere
rickettsia .
Noi ci limitiamo a fare il genere rickettsia , anzi la trib delle rickettsie .
Aspetti microbiologici : sono piccoli bacilletti , gram negativi , piccolissimi , hanno anche questi la parete
cellulare dei gram negativi e le LPS . Ovviamente , s tecnicamente sono gram negativi per all interno
della cellula la gram non va bene , e quindi si colorano con le colorazioni istologiche tipo la GIEMSA . Come
le clamidie avevano tropismo per le mucose , questi invece hanno tropismo per le cellule endoteliali .
Hanno diversi antigeni alcuni di questi si utilizzano per la diagnostica .
Ciclo di sviluppo : sono dei microrganismi molto particolari e molto caratteristici . Ovviamente , l uomo
un mammifero . Gli artropodi vettori sono zecche , acari , pidocchi , pulci e il ciclo di sviluppo avviene tra i
mammiferi . Quindi sono microrganismi adattati alle temperature umane . Nei parassiti , zecche , acari ecc.
ecc. i microrganismi si trasmettono anche alla progenie . Quindi la trasmissione verticale negli artropodi .
In genere , sono tutti trasmessi da artropodi , la coxiella invece fa eccezione perch la patologia che
determina si chiama febbre Q , non trasmessa dagli artropodi . Ci sono anche , in letteratura , tante
infezioni da richettsia acquisite in laboratorio perch siccome sono piccoli , anche gli aerosol dei prelievi , le
provette , i tappi possono trasmettere le rickettsie .
La via di ingresso delle diverse specie dovuta al passaggio dei diversi artropodi : pulci , acari , zecche e
pidocchi . Essi passano l ingresso , anche se sono insetti che non pungono , il grattamento dovuto al
prurito la stessa cosa . Quindi attraverso il grattamento questi microrganismi entrano nel sangue . Si
diffondono nel sangue e dal sangue passano ai diversi organi in cui causano la loro malattia che pu essere
encefalite , polmonite , insufficienza renale , patologie gastrointestinali e alla cute , la sintomatologia
classica , il rush cutaneo . Nell uomo in genere non si trasmette ad altri . Questi microrganismi entrano
all interno quindi chiaro che le cellule sono danneggiate , ecco perch sono le cellule endoteliali quelle
colpite . Quindi indotta la fagocitosi , anche qua il fagosoma . Si ritrovano all interno di queste cellule e
ovviamente devono moltiplicarsi e uscire . Si devono diffondere . Lo fanno e i meccanismi con cui
Microbiologia - Medicina e Chirurgia polo A 2012/2013 - sbobinature lezioni
61
fuoriescono saranno differenti , come anche saranno differenti per i virus , per le diverse specie . A noi
interessa sapere che fuoriescono dalle cellule con diversi meccanismi . Al microscopio li vediamo aderenti
alla cellula , e con un ingrandimento , osserviamo le rickettsie all interno della cellula . Quindi la
trasmissione avviene attraverso gli artropodi . Le zecche pungono , le pulci saltano e danno prurito .
Attraverso il raschiamento o la puntura , invadono il torrente del sangue . Dal sangue , si localizzano agli
endoteli di tanti altri organi . Si infiltrano , danno localmente fenomeni trombotici e necrotici e anche
piccole emorragie . Vediamo la classificazione : trib delle rickettsie , genere rickettsia . Quindi siamo nell
ambito del genere rickettsia e abbiamo diverse specie . Sono tante queste rickettsie che devono essere
distinte in tre diverse patologie che sono molto simili . Una la febbre maculosa , uno il gruppo del tipo ,
uno il gruppo della febbre fluviale del giappone . Il tifo quello esantematico ed la malattia classica
delle rickettsie . Il gruppo genere rickettsia responsabile di febbre maculosa sono la rickettsia conorii (
attraverso le zecche, agente eziologico della febbre bottonosa ), rickettsii provoca la febbre delle Montagne
Rocciose attraverso le zecche, akari , ( sono le pi frequenti ) , attraverso gli acari . Quindi , la geograficit e
la distribuzione in relazione sia ai vettori , gli insetti , sia agli ospiti intermedi ( serbatoi ) ovvero i roditori ,
conigli , ratti , topi . Le patologie sono quelle elencate a fianco . Gruppo della febbre maculosa perch la
sintomatologia consiste in queste macchie . Il gruppo del tifo comprende tre specie . Una lo pseudotifo
della California , le altre sono quelle che danno il nome alle rickettsie . La rickettsia prowazekii che l
agente eziologico del tifo esantematico trasmesso dai pidocchi . I pidocchi sono ubiquitari nel mondo e
quindi la distribuzione geografica estremamente allargata , anche da noi . Dopo la Prima Guerra Mondiale
, chi riusci a scappare alla guerra , tornando a casa , la povert , la scarsa igiene , la debilitazione fecero s
che molti morissero prima di arrivare nel Meridione . Le altre , la rickettsia tifi che invece pure ubiquitaria
, trasmessa dalle pulci ed lagente eziologico del tifo murino . L ultimo gruppo delle patologie quello
della febbre fluviale del Giappone per prevede un solo genere e una sola specie . Prima si chiamava
rickettsia , poi vi ho fatto vedere il rimaneggiamento , ora diventato un genere a s ed ora il genere
Orentia tsutsugamusci che non una nostra patologia ed un acaro il vettore , il serbatoio animale sono
sempre i topi .
La presenza di rash cutaneo al 90 -97 -100 % laddove altri sintomi sono pi o meno presenti a seconda
della malattia . Mancano l interessamento ai linfonodi , la mortalit molto diversa .
La febbre bottonosa si trasmette anche alla progenie . E visibile il rash cutaneo .
Poi abbiamo la rickettsia akari trasmessa da acaro .
La rickettsia conorii quella classica del mediterraneo , trasmessa dalla zecca del cane e causa febbre
bottonosa mediterranea .Non difficile curarla , gli antibiotici ci sono ( tetracicline ) , il problema
riconoscerla .
Quella che pi importante la rickettsia prowazekii del gruppo del tifo o petecchiale , trasmessa dal
pidocchio . I paesi a rischio sono l Africa , l India , Vietnam , Filippine , Sud-America . L agente eziologico
del tifo murino la pulce .
La coxiella pure una rickettsia per non trasmessa da un artropode e pertanto , essendo un parassita
endocellulare obbligato , deve avere un modo di distribuirsi all esterno , di viaggiare . Anche questa , come
la clamidia , ha due fasi . Il fatto della cellula infettante e quella di moltiplicazione c anche nei protozoi , lo
vedrete come cisti . Una la fase 1 , virulenta che si trova in natura ed infettante . L altra la fase 2 . La
febbre Q venne scoperta in Australia . L uomo si infetta inalando la polvere che contiene queste particelle
Microbiologia - Medicina e Chirurgia polo A 2012/2013 - sbobinature lezioni
62
emanate dagli animali . Le cellule bersaglio sono macrofagi dei vari organi come polmoni , milza ecc , ecc .
La via di trasmissione quella aerea .
In Italia nel 2005 , la Sicilia in testa tra le regioni pi colpite con 298 casi su 462 . A seguire il Lazio con 41
casi . La fascia di et quella tra i 25 e i 64 , perch le zecche circolano in campagna , quindi la fascia
lavorativa attiva ad essere colpita . Il periodo Aprile Ottobre quando circolano le zecche . Catania ha 55
casi , Palermo ne ha 52 .
Indagini di laboratorio : non facile . Certo si deve isolare . Come ? Allo stesso modo delle clamidie , si pu
coltivare sulle cellule . La diagnosi a risposta diretta avviene con la PCR , altrimenti con
immunofluorescenza su vetrino . Un altra indagine di laboratorio consiste nella ricerca degli anticorpi . Ci
sono diverse metodiche . La reazione di Weil Felix la terza e ultima diagnostica con ricerca di anticorpi in
microbiologia . Una era la Vidal per il tifo addominale , l altra la Wright per la brucella e la terza la
reazione di Weil felix che va a cimentare degli antigeni che non sono veri e propri antigeni di rickettsie ma
sono accumunati ad antigeni di Proteus , un altro microrganismo .
Lisolamento difficilissimo . E molto pericoloso il rischio che si generino aerosol . Le coltivazioni pertanto
non si fanno quasi mai .
Sensibilit agli antibiotici . Sono inattivi le betalattamine perch non entrano all interno della cellula , Sono
attivi invece le tetracicline , i macrolidi e i fluorochinoloni . Tutti antibiotici che entrano all interno delle
cellule .
Profilassi . Vaccino non ce n . La profilassi si fa o lottando i parassiti o lottando i topi e quantaltro o
curando l igiene personale , evitando che si abbiano pidocchi o altro . O , nel caso di zecche , questo lo si fa
anche per i cani , la corretta rimozione onde evitare che pungano e lascino , infettando , il loro pungiglione .
Ci vogliono dalle 8 alle 16 ore per la loro moltiplicazione . Le colorazioni che le mettono in evidenza dentro
la cellula sono tutte istologiche .
Ehrlichia : lasciatela stare ! Quelle che ci interessano maggiormente sono il genere Richettsia , Coxiella e
genere Orentia . Importante il genere richettsia con le diverse specie e le diverse patologie .
Lezione 11
Ora trattiamo altri due gruppi di microrganismi che hanno una grande importanza in medicina. Iniziamo dai
micoplasmi, come dice anche il nome sono le pi piccole cellule capaci di vita autonoma, sono piccolissimi
ma mentre clamidie e rickettsie sono parassiti endocellulari obbligati quindi non sono capaci di vita
autonoma e necessitano dei processi metabolici delle cellule. I micoplasmi sono invece dei batteri che
hanno una loro vita autonoma, sono quindi capaci di formare proteine, di duplicarsi e di vivere
nellambiente esterno. Spesso vengono indicati anche con la sigla PPLO( Pleuro pneumonia-Like
Organisms).
Il micoplasma che pi ci interessa il micoplasma hominis che lagente eziologico di una grave malattia a
carico dei polmoni, come la clamidia pneumoniae.
Hanno delle piccole dimensioni ma non hanno una forma ben definita sono pleomorfi e la loro
caratteristica principale che in essi manca la parete cellulare. Infatti la classe a cui appartengono i
micoplasmi quella dei Mollicutes. Hanno naturalmente la membrana cellulare e questa deve sostituire
Microbiologia - Medicina e Chirurgia polo A 2012/2013 - sbobinature lezioni
63
anche la parete cellulare, per questo motivo la membrana ricca di steroli che sono dei lipidi che
forniscono elasticit e sostegno alla cellula.
Non dobbiamo confondere i micoplasmi con i batteri forme L, queste forme si generano in laboratorio
quando per certi motivi impedita la costituzione della parete cellulare. Questo pu accadere se i batteri
hanno un contenuto osmotico molto elevato, la parete va incontro a lisi e se in laboratorio si fornisce un
ambiente isotonico riescono a vivere senza parete cellulare. Questo succede perch rimangono in equilibrio
osmotico e prendono il nome di forme L, che in vivo o in natura non esistono.
Si riproducono come gli altri per scissione binaria.
Caratteristiche biologiche: sono microrganismi aerobi o anaerobi facoltativi; anche se in determinati
habitat possono crescere senza ossigeno. Li troviamo molto abbondantemente nella flora del cavo orale,
nelle mucose e in particolare in quella genitale. Crescono formando delle colonie piccole con un aspetto
particolare, proprio per lassenza della parete cellulare, dette a uovo fritto poich presentano una parte
bassa e un centro rigonfio. I terreni di coltura devono essere dotati di steroli e di acidi grassi in modo che si
possono sintetizzare i componenti della membrana cellulare.
Sono responsabili di varie patologie soprattutto insieme alle clamidie, ma essendo privi di parete cellulare
sono resistenti a vari antibiotici che agiscono inibendo la sintesi della parete cellulare, come le penicilline,
cefalosporine, monobattamici, carbapenemici non vanno bene per i micoplasmi.
Hanno una particolare caratteristica di aderire allepitelio respiratorio e la patogenicit consiste nel fatto
che danneggiano le cellule della mucosa respiratoria, esse iniziano con la presenza di questi batteri un
processo flogistico dove interviene il sistema immunitario.
I micoplasmi hanno anche delle caratteristiche emolitiche ci si nota nei terreni al sangue e interferiscono
spesso con i processi immunitari e causando anche fenomeni di autoimmunit.
Quello che ci interessa dal punto di vista clinico di tutti questi microrganismi sono il genere micoplasma e
secondariamente il genere ureaplasma. Sono importanti perch spesso le infezioni di micoplasma hominis a
livello uretrale e quelle di ureaplasma ueralyticum si confondono.
Questi microrganismi non penetrano allinterno delle cellule ma vivono liberi sui mammiferi, sulluomo, ma
anche nel suolo, nelle acque. Vivono nella nostra flora da commensali ma possono diventare patogeni in
certe situazioni. Alcuni esempi di micoplasmi sono: il M. genitalium, M. salivarium, il M. orale, sono tutti
microrganismi che fanno parte della nostra flora ma che in determinate circostanze possono diventare dei
patogeni opportunisti. Mentre quelli che causano maggiormente patologie nelluomo sono: il M. hominis e
il M. pneuomoniae.
Il M. pneumonie lagente eziologico della polmonite atipica primaria questa un infezione detta
polmonite ambulante perch non molto grave ma molto frequente e tipica di una fascia giovanile come
quelle da clamidia.
Il M. salivarium un commensale del cavo orale ed presente nelle tasche gengivali perch c una leggera
anaerobiosi e danno infenzioni del parodonto.
Il M. hominis un commensale dellapparato genito urinario, ma si trova anche nelle altre mucose, sulla
pelle, associato a numerose infezioni dellapparato genitale delladulto. Anche durante il parto pu essere
trasmesso dalla madre al neonato.
Microbiologia - Medicina e Chirurgia polo A 2012/2013 - sbobinature lezioni
64
Il M. genitalium un normale commensale dellapparato genitale.
Il M. orale un normale commensale del cavo orale non patogeno, solo occasionale.
Il M. incognitus ha una relazione con lAIDS, si visto che nei soggetti con AIDS vi sono spesso infezioni da
micoplasmi, ancora non si conosce bene il motivo, ma molti pazienti HIV positivi presentano queste
infezioni.
Ureaplasma si chiama cos perch produce ureasi, il pi importante lU. urealyticum che si trova
nellapparato genitale.
La polmonite atipica si trasmette per via aerea tipica nei giovani frequentemente asintomatica ci vuol
dire che si presenta in forma blanda. Si presenta come uninfluenza e d un riscontro dal punto di vista
radiologico. Si guarisce facilmente e raramente vi sono complicazioni,infatti prende il nome di polmonite
ambulante naturalmente nei casi di immunodeficienza la malattia diventa pi grave.
La risposta immunitaria consiste nella formazione di anticorpi, vi sono 3 categorie di anticorpi le IgM, le IgG
e le IgA. Le IgA sono di tipo secretorio e si trovano nelle mucose; le IgM sono gli anticorpi precoci che
vengono ricercate in caso di infezione e se ci sono vuol dire che linfezione in corso; le IgG rimangono. I
micoplasmi quindi prima portano alla formazione di IgM e poi di IgG questi per non hanno attivit
protettiva, poi troviamo le IgA a livello delle mucose.
Epidemiologia:la polmonite diffusa in tutto il mondo una tipica polmonite frequente in autunno e in
inverno.
Diagnosi: con le solite tecniche o si isola,quindi accertamento microbiologico direttamente dal materiale
patologico che essendo una polmonite sar il BAL ( liquido di lavaggio bronchiale), si semina in un terreno
per micoplasmi ricco in lipidi e se ci sono si identificano con dei sistemi biochimici di routine, oppure
direttamente nel materiale patologico si pu ricercare lantigene con dei kit che sono in commercio, oppure
si possono utilizzare delle sonde a DNA ed effettuare una P.C.R.
Essendo resistenti alla maggior parte degli antibiotici gli unici utilizzati sono le tetracicline e i macrolidi che
sono gli antibiotici di elezione anche di clamidia pneumoniae che hanno grosso modo le stesse
caratteristiche, sono pi frequenti nella fascia giovanile e hanno grosso modo la stessa difficolt nella
diagnosi perch se non si richiedono espressamente ovviamente sfuggono.
Il M. hominis si trova nellapparato genitale e si trasmette anche per via sessuale per non appartiene alla
malattie sessualmente trasmesse. Tutte le infezione a livello dellapparato genitale se risalgono possono
essere pi gravi e portare endometriti,infertilit oppure in gravidanza possono raggiungere il prodotto del
concepimento e causare una rottura precoce delle acque. Quindi possono dare conseguenze serie. In
questo tratto troviamo anche gli streptococchi di tipo B gli agalactiae, clamidia e nesserie che si devono
differenziare dai micoplasmi. Ovviamente il materiale patologico cambia e si pu isolare dai secreti vaginali
e uretrali.
Anche lureaplasma urealyticum si studia perch responsabile di infezioni in gravidanza anche questo causa
di uretriti non gonococciche.
Ovviamente come tutti i microrganismi che causano infezioni neonatali sono gravi le complicanze a livello
delle meningi o del sistema nervoso centrale, in genere dei [Link] questo vale per tutti quelli che
abbiamo visto finora,non ci sono grandi [Link] urealyticum produce [Link]
Microbiologia - Medicina e Chirurgia polo A 2012/2013 - sbobinature lezioni
65
antibiotici sono sempre [Link] cosa pi importante da ricordare che erano definiti col termine PLEURO
PNEUMONIA-LIKE ORGANISMS,come gi detto.I micoplasmi fermentano il glucosio,altrimenti non
sarebbero aerobi o anaerobi facoltativi.
Filogenesi:micoplasma e ureaplasma sono una branca a s rispetto a tutte le altre da cui sono formati gli
streptococcus,lo staphylococcus etc,tutti gram [Link] altri si differenzieranno negli altri phylum,i gram
[Link] classe dei mollicutes divisa in 4 ordini,anche se noi tratteremo solo una o due [Link] ordini
sono divisi in famiglie. Le famiglie sono divise in generi. I generi sono divisi in [Link] dicendo che
appartiene alla classe dei mollicutes abbiamo saltato gli ordini,che sono tanti,tutti rappresentati da
microrganismi mollicutes,privi di parete [Link] altri ordini li troviamo entomoplasmatales,ovviamente
negli insetti [Link] ordine ha diverse famiglie,una di questa quella dei mycoplasmataceae a cui
appartiene il genere micoplasma.
Patogenesi: non hanno tossine e creano danni alla cellula;rimangono tra cellula e cellula perch con la loro
presenza e con linterposizione dellimmunit causano appunto proprio danni alle cellule del tessuto ospite
e impiantandosi il danno produce la patologia classica.
Mycoplasma pneumoniae:aderisce alle cellule epiteliali grazie alle adesive,questo generale per tutti i
microrganismi, e produce [Link] penetra allinterno,ma rimane fuori dalle cellula e la
altera,distruggendola con le sue [Link] interferenza con le reazioni immunitarie e non
[Link] eziologico della polmonite atipica [Link] let pi [Link]
manifestazioni cliniche sono inizialmente quelle tipiche [Link] diagnostica per immagini
effettuata sul polmone permette di distinguere e di indirizzare alla diagnosi, con tutte le eziologie che ci
sono delle varie forme di polmonite.
Terapia:tetracicline ,macrolidi.
A propositio del micoplasma hominis,le conseguenze sono diverse,alcune le abbiamo gi viste ,altre sono
uguali a quelle di tutte le infezioni che agiscono e intervengono sul tratto genito-urinario,quindi uretrite,in
[Link] presenti spessisimo in soggetti con AIDS,non hanno una grande patogenicit,come si
riscontrano altre specie,c quindi una stretta analogia tra infezione da HIV e presenza di [Link]
tutte specie che non hanno un grande riscontro,tuttavia vi una netta corrispondeza con i soggetti HIV
[Link] certo Montagnier vide, partendo dal punto di vista che molti micoplasmi sono isolati dai soggetti
con AIDS,che sono carenti dellimmunit,perch lHIV un virus il cui effetto si ha alterando lassetto
immunitario,una certa correlazione tra pazienti affetti da AIDS e presenza di [Link] che ci sia
questa correlazione certo,non si sa per se siano i micoplasmi ad innescare la possibilit che il virus HIV
agisca sulla cellule immunitarie,aumentando cos la patogenicit,oppure se la condizione di
immunodeficienza e quindi lo scardinamento delle cellule a seguito delle infezioni da HIV siano permissive
nei confronti dei [Link],in poche parole, se il micoplasma a creare le condizioni per la
patologia e ad aumentarla oppure se la condizione immunitaria carente dellAIDS a creare il substrato per
la presenza [Link] oggi nessua certezza,tranne quella che via sia una netta correlazione tra linfezione
e presenza di micoplasma,anche delle specie di raro isolamento umano,e presenza di [Link]
limmunodepressione gioca un ruolo importantissimo per le infezioni da micoplasma.
Anche lureaplasma urealyticum causa infezioni,dette uretriti non gonococciche,perch quelle
classiche,quelle specifiche,sono quelle [Link] cos con i micoplasmi.
Adesso andiamo a parlare di una numerosissima serie di microrganismi che sono le Spirochete.
Microbiologia - Medicina e Chirurgia polo A 2012/2013 - sbobinature lezioni
66
Ordine: Spirochaetales;
Famiglia:Sono due,Spirochaetaceae e Leptospiraceae;
-La famiglia delle Spirochaetaceae ha diversi generi,tra cui:Borrelia,Spirochaeta,Treponema.
-La famiglia delle Leptospiraceae ha un solo genere:Leptospira.
Caratteristiche delle Spirochete:
-Enormemente grandi,molto pi dei batteri,si avvicinano quasi alle dimensioni dei protozoi,quindi cellule
eucariote;
-Lo dice il nome stesso,hanno il corpo avvolto a spirale,per sono diversi dai vibrioni,perch li vi era la
parete cellulare arcuata,qui,invece,hanno un corpo allungato percosso tutto,da un estremo allaltro,da un
fascio di flagelli,che non sono inseriti sulla parete, ma ne fanno lo scheletro,quasi. Contraendosi danno un
caratteristico movimento a tutte le spirochete;
-La parete interna ed ondulante e hanno tecnicamente la parete cellulare dei gram negativi,quindi mentre
tutti gli altri gram negativi hanno questa parete a fuso,a virgola, a spirale, ma rigida,in questo caso il
peptidoglicano c,la membrana esterna pure,per caratteristicamente la parete ha una sua flessibilit
molto differente;
-I movimenti sono caratteristici;
-Lhabitat in cui vivono specialmente quello liquido,tale da permettere il caratteristico movimento;
-Sono molto labili e non sopravvivono allessiccamento;
Come facciamo a vederli?La diagnostica in questo caso si fa anche con una semplice osservazione a
fresco,senza nemmeno la colorazione, e si vedono con il microscopio ottico, si dice, in campo scuro, dove si
osservano i movimenti. Ovviamente,se lo si vuole,si possono colorare,ma con la colorazione non si
osservano i movimenti perch sono morti, ma hanno delle caratterestiche molto tipiche.
Non si parla di colorazione di gram, la prendono poco, si colorano pi con le colorazioni istologiche tipo la
giemsa o la colorazione argentica. Se visti al microscopio, in campo scuro risaltano come chiari, con un
colorante fluorescente assumono queste altre caratteristiche. Questi flagelli che fungono da scheletro sono
costituiti da tanti fasci di fibre differenti. Sono flagelli ma hanno questa conformazione caratteristica. Sono
inseriti longitudinalmente, cio nello spazio periplasmatico, quindi la parete in certi punti vicina al
flagello, in punti opposti se ne allontana. Quindi la parte centrale sono proprio i flagelli, il numero dei
filamenti varia, i pi numerosi sono nelle borrelie, le leptospire ne hanno spesso uno solo (leptospira = spira
sottile). Sono batteri per scissione, sono la maggior parte anaerobi obbligati ( ad esempio il treponema), ma
con le conoscenze che si hanno oggi si sa che alcuni sono ossidanti, cio se sono ossidanti hanno il ciclo di
krebs, se hanno il ciclo di krebs devono avere lossigeno, se hanno lossigeno devono avere le citocromo
ossidasi, ma quelli che ci interessano maggiormente, essendo anaerobi verranno trattati con antibiotici
contro gli anaerobi.
Vediamo i diversi generi:
spirochetacee, genere treponema.
Microbiologia - Medicina e Chirurgia polo A 2012/2013 - sbobinature lezioni
67
Il genere spirocheta un microrganismo che si trova nelle mucose, ne ritroviamo tantissimo nel cavo orale.
Treponemi: ve ne sono tantissime specie; alcune sono abitatori normali delle mucose, ad esempio del cavo
orale, altri sono patogeni e di questi abbiamo il treponema pallidum.
La specie treponema pallidum esiste in diverse sottospecie. La sottospecie pallidum lagente eziologico
della sifilide; laltra sottospecie endemicum e pertenue sono responsabili di due sottospecie non veneree e
tropicali. Il treponema carateum responsabile di una patologia che si chiama carate. Il treponema
pallidum sottospecie pallidum diffuso in tutto il mondo ed la prima e pi grave infezione trasmessa
anche perch non solo si trasmette per via orizzontale ma anche per via verticale causando danni congeniti
ai figli.
Il treponema sottospecie endemicum causa una forma che si dice endemica in determinati paesi, una
sifilide differente, si ha per contatto ma non per via sessuale.
Il treponema sottospecie pertenue diffuso in zone tropicali con localizzazione cutanea. Il treponema
carateum diffuso sempre in zone tropicali.
La sifilide: una malattia che ha solo luomo, non presente negli altri animali e si trasmette
orizzontalmente e verticalmente. Il treponema pallidum patogeno poich: con i suoi movimenti entra e
riesce a farsi spazio tra le cellule , non produce tossine, le proteine che ha in superficie non hanno attivit
immunologica, rimane fuori dalle cellule e si crea la sua nicchia. Ovviamente allesterno deve avere delle
sostanze che interferiscono con le difese immunitarie ed esattamente il complemento ( sistema di sostanze
presenti nel sangue che hanno importanza anche a livello immunitario; questo si attiva quando deve
combattere delle sostanze). Il punto di ingresso la cute, quindi le prime lesioni, le mucose sono degli
ingrossamenti che si chiamano sifilomi. Non entrano nelle cellule per si creno gli spazi ed entrano nel
sangue. le spirochete dopo lingresso nel sangue distribuite in moltissimi organi.
La sifilide primaria: in cui i microrganismi si isolano dalle lesioni cutanee della mucosa; poi passa nel sangue
( i sintomi sono aspecifici: mal di testa, febbre, anoressia, ecc), dal sangue passano alla pelle dove
provocano il rash cutaneo classico dello stadio secondario della sifilide. Dopo di ch, anche a distanza di
anni, la sifilide se non curata rimane latente, si ha il terzio stadio che porta delle complicanze al SNC, infatti
si chiama neurosifilide. Quindi si la lo stadio della neurosifilide: gomme luetiche ( lesioni a pelle, cartilagini e
ossa), danni vascolari, indurimento delle radici spinali posteriori con sintomi quali cecit, demenza, ecc..
La sifilide ha una storia molto particolare, come ad esempio nella letteratura, ha rappresentato sempre una
piega sociale.
La terapia ,ai tempi, veniva fatta in centri con dei bagni di mercurio. Le complicanze di queste terapie (dato
che si usava mercurio) erano peggiori della malattia stessa.
Oggi la sifilide si cura. Curata in tempo abbastanza sensibile agli antibiotici ( la penicillina, le tetracilline
sono valide).
La diagnosi: se la madre ha uninfezione primaria il rischio di infezione al 100 %; se secondaria al 90%;
se latente il rischio minore; se allultimo stadio non ci sono rischi.
La sifilide congenita gravissima, porta a morte del feto, malformazioni gravi per tutta lavita, e infezioni
latenti. una delle peggiori cause di deformit: tibia a sciabola, il naso a sella, ispessimento della clavicola,
incisivi a forma di cacciavite, ecc..
Microbiologia - Medicina e Chirurgia polo A 2012/2013 - sbobinature lezioni
68
Treponema pallidum sottospecie endemicum: sifilide non sessualmente trasmessa, d una malattia che si
chiama bejel. Treponema pallidum sottospecie pertenue d una malattia chiamata frambesia. Tutte
infezioni tropicali con presenza di papole, ulcerazioni, ecc..
Lultima altra specie il treponema carateum che lagente eziologico della pinta, anche questa delle zone
tropicali e le lesioni sono pi o meno le stesse. Lesioni che si manifestano sulla cute lungo lo stato
secondario. La diagnosi abbiamo detto che basta una osservazione in campo scuso. Non si guardando sul
microscopio in chiaro. un meccanismo particolare che consente di vedere in vivo i movimento. I
treponemi non si sono mai potuti coltivarli in terreni, ma in animali di laboratorio. Si conservavano dei
cuscinetti plantari dei topi, il terreno di trasporto, ma siccome sono studi cruenti e gli animali si tende oggi
a non utilizzarli, la diagnostica in laboratorio si basa solo sullesame batterioscopico. Naturalmente non
basta. Quindi la diagnostica ha preso altre strade. Quindi anche la diagnosi istologica se un esame la
colorazione sul vetrino quella basta per fare diagnosi. Questa a fluorescenza, tanto scusa etc... . Per la
diagnostica ovviamente ci dobbiamo avvalere di altre tecniche. C una diagnostica indiretta che si fa dal
sangue osservando la presenza di anticorpi; una diagnostica molto complicata e molto ben differenziata
perch linteresse per la sifilide tanto a tal punto che vi sono dei test treponemici e non treponemici. I test
non treponemici, tra cui la c la classica reazione di Wassermann, che per legge da utilizzare quando si
inizia un posto di lavoro etc. Quindi la diagnostica non treponemica utilizza per cercare gli anticorpi
contro i treponemi degli antigeni che non sono treponemi ma delle sostanze che fungono da antigeni
treponemici. Ad esempio nella reazione di Wassermann si usa la cardiolipina che estratta dal miocardio
del bue ed la reazione pi comune che viene fatta normalmente. La diagnostica treponemica rileva gli
anticorpi utilizzando antigeni treponemici. Le reazioni sono tantissimi perch tutte queste tecniche come la
glutinazione, limmobilizzazione etc..sono tutte tecniche treponemiche. Le reazioni non treponemi che
sono altrettanto numerose e rilevano gli anticorpi utilizzando per antigeni, non antigeni treponemici, ma
sostanze che si sono sviluppate e che contengono altri antigeni come la cardiolipina. Tutte le diagnostiche
le saltiamo e andiamo avanti.
Altro genere la Borrelia; un genere di grande attualit e di grande interesse per i reumatologi perch la
borrelia burgdorferi lagente eziologico della malattia di Lyme. Altre specie di borrelia possono causare
febbre ricorrente. Ricorrente perch in relazione alla divisione e alla moltiplicazione dei batteri nel
sangue. Sono sempre mobili (hanno un numero enorme di flagelli). Il batterio si piega in maniera tale che
in alcuni punti la parete vicina e in atri punti ondulante, morbida. Tutti i fasci di flagelli in sezione
allinterno del borrelia. Non producono tossine e si diffondono attraverso il circolo ematico. Siccome sono
trasmessi da artropodi molto spesso sono le zecche che inoculano questi microrganismi. Anche la febbre
ricorrente causata da artropodi e da grattamento che si verifica a seguito della puntura. La borrelia nel
sangue quindi per la diagnostica serve un semplice preparato qua colorato con la colorazione di Gims, la
colorazione pi classica nei preparati istologici. Questa la zecca che induce la formazione dei processi
responsabili della malattia di Lyme che si sviluppa a seguito della puntura o dellingresso del microrganismo
con una zona che muta (si chiama eritema migrante) che mette in evidenza la presenza di questa malattia.
Scompare e ricompare. Questa la lesione della borellisioni di Lyme, le deformazioni alle articolazioni, le
manifestazioni a livello delle mani etc. Quindi la diagnostica si fa sia con il vetrino, sia con la ricerca degli
anticorpi e degli antigeni.
Lultimo genere la Leptospira, che siccome sottile, difficilmente visibile. lungo ma non osservabile
bene al microscopio. Sono aereobi, si coltivano e la leptospira ha delle spire molto sottili e una forma
Microbiologia - Medicina e Chirurgia polo A 2012/2013 - sbobinature lezioni
69
caratteristica che rende ragione del nome della specie pi importante, la leptospira interrogans, un punto
interrogativo.
Come viene la leptospirosi? La leptospirosi una infezione di roditori e di altri animali. una infezione che
si localizza a livello del rene ed un microrganismo che viene eliminato con le urine. Sopravvivono
nellacqua (lambiente delle spirochete infatti lambiente liquido) e, se qualcuno si fa il bagno in acqua
infetta da urina di topo o da altri animali malati ( e la leptospirosi abbastanza frequente), assume
attraverso la cute questa leptospira che causa una malattia che inizialmente passa inosservata perch
sembra una influenza. In relazione alla difese immunitarie del soggetto spesso asintomatica o molto
blanda con una serie di sintomi simili allinfluenza. Dopodich il microrganismo arriva nel sangue, raggiunge
il sistema nervoso e a quel punto c poco da fare. Poco tempo fa sul giornale cera la notizia di una ragazza
morta perch aveva fatto il bagno in un laghetto e aveva contratto la leptospirosi. Quindi sono malattie di
tipica pertinenza degli infettivologi con una accurata anamnesi.
La diagnosi volendo si fa su terreni di coltura speciali. Si colorano soprattutto in immunofluorescenza e
facilmente tutti questi microrganismi sono sensibili ad antibiotici molto semplici come le tetracicline,
macrolidi o anche penicillina.
Questo il treponema. La forma delle spirochete osservate insieme ai globuli rossi sono molto grandi.
Arrivano a 250 millimicron. [Link] di 1 micron. Quindi sono 250 volte un [Link] o qualsiasi altro Bacillo. Il
diametro arriva a 3 micron. Quindi tre volte un [Link]. sono abbondantemente visibili, quasi a occhio nudo.
un quarto di mm. Questa una immagine in campo scuro e se si volesse di vedrebbero i movimenti.
Chiaramente ci sono anche altri genere. Noi parliamo di quelli di importanza medica, gli altri sono
commensali, o umani o di altri animali presenti nellambiente, ma non hanno importanza. Ma le
spirochaetales sono anche queste tantissime, numerosissime, tutte con queste caratteri.
Questa una visione chiara della parete cellulare morbida invece dei flagelli che fanno da scheletro in tutti i
treponemi. Questa limmagine della rete di flagelli, un lungo assemblamento di flagelli, avvolto da una
parete cellulare elastica e morbida attorno. Le spire sono diverse. Leptospira vuol dire una spira pi sottile.
La borrelia quella pi rappresentata dai flagelli. Qui vi fa vedere le spirochete che entrano nelle cellule.
Hanno una particolare capacit di inserirsi con questo movimento. La leptospira ha soli due endoflagelli. La
leptospirosi non da trascurare ma abbastanza frequente anche sul territorio. Tetraciclina, macrolidi,
penicillina come antibiotici.
Per la febbre ricorrenti le pi tipiche sono la burdorferi e la ricurrentis.
La malattia di Lyme. Intorno a una cellula tutte queste varie borrelie colorate con immunofluorescenza.
Tutte le varie complicanze della malattia di Lyme. Tetraciclina, macrolidi, penicillina come terza scelta.
Le febbre ricorrenti sono sempre trasmesse dagli animali.
Il treponema. Questi sono tutti anaerobi obbligati che devono essere trattati con antibiotici adatti contro gli
anaerobi. Sono treponemi perch come tutte le specie che si trasmettono per via sessuale sono molto labili
nellambiente esterno. Se sono labili significa che la maggior parte dei disinfettanti, ma anche laria e
lessiccamento, li fa morire e anche i saponi bastano per ucciderli. La tassonomia dei treponemi molto
ben rappresentata. Il treponema vincentii quello associato a molte patologie dei cavo orale, tra cui la
parodontosi. Mentre il treponema pallidum e il treponema carateum sono da ricordare. Il treponema
pallidum si pu coltivare. Le affezioni del cavo orale sono di interesse odontoiatrico. Si depositano nelle
tasche gengivali.
Microbiologia - Medicina e Chirurgia polo A 2012/2013 - sbobinature lezioni
70
Il treponema e la silifide. Sifilide primaria, secondaria, terziaria, quaternaria. La sifilide congenita sulle
patologie ossee dei neonati. La terapia: penicillina. Se non si possono fare, tetraciclina. Non c prevenzione
n vaccino, ma la prevenzione solo di natura igienico-sanitario. I casi stimati sono 12 milioni nel mondo, di
cui in Asia e area sudestasiatica 4 milioni, nordamerica e america latina 3 milioni, sudafrica 3 milioni e cos
via.
Lezioni secondo semestre micologia N.B. le lezioni che seguono non sono organizzate secondo un ordine cronologico, perch durante il
semestre un giorno ci sono state lezioni di micologia e laltro lezioni di virologia. Ho ritenuto pi utile
suddividerle in due blocchi, il primo di micologia e il secondo di virologia. Ale Bella .
Lezione 1
Linvenzione del microscopio consent la scoperta di microorganismi che stanno alla base
dellorganizzazione cellulare. In questo scenario sincontrano anche i funghi che ,essendo degli
eucarioti,sono stati riconosciuti per tanto tempo come degli organismi vegetali proprio per la loro parete
cellulare. In realt essi sono organismi appartenenti ad una specie diversa da quella animale o vegetale,pur
rientrando nellambito del regno degli eucarioti.
I funghi occupano una posizione molto importante nel regno dei viventi, anche se larea meno conosciuta
alluomo;essi sono dei potentissimi degradatori,oltre ad essere stati necessari per lo studio del DNA (si
pensi al Saccharomyces cerevisiae comunemente detto lievito,avente un cromosoma pi grande e perci
meglio analizzabile rispetto quello E. coli ).
Inoltre i funghi sono molto importanti per la produzione di proteine (soprattutto enzimi come i
fermentatori),o degli antibiotici come la penicillina. I funghi sono in grado perci sia di dare benefici
alluomo,sia danneggiarlo (si pensi che ci sono funghi in grado di deteriorare gli altri organismi).Di fatto vi
erano delle aree ,a partire dal dopo guerra soprattutto negli Stati Uniti, in cui nacquero delle infezioni
micotiche al livello dellapparato respiratorio,per cui si sent lesigenza di condurre una ricerca in campo
medico sulla micologia,il cui padre fondatore fu [Link] Africa si presentarono patologie strane dovute alla
presenza di una variet maggiore di funghi dovuta al clima sub tropicale, ambiente adatto allo sviluppo di
questi organismi.
Intorno agli anni 70-80 si sviluppa lHIV ,virus che sviluppa lAIDS che a sua volta aumenta la possibilit di
contrarre malattie [Link] maggior parte delle malattie fungine che troveremo sar dovuta ad un
adattamento di questi organismi,in quanto lospite crea un ambiente adatto alla sua crescita.
Mentre i batteri inoltre ,contrariamente ai funghi, hanno una frequenza di mutazione pi elevata rispetto a
questi ultimi.
I funghi sono organismi eucariotici provvisti di parete cellulare,inoltre essi possono essere suddivisi in:
-organismi unicellulari (lieviti)
-organismi pluricellulari (muffe)
Microbiologia - Medicina e Chirurgia polo A 2012/2013 - sbobinature lezioni
71
Hanno inoltre una riproduzione :
-sessuata (forma perfetta o pteriomorfa)
-asessuata (forma imperfetta o anamorfa)
Tutti i funghi sono organismi aerobi; possibile riconoscere gli aerobi obbligati(le muffe) o facoltativi (i
lieviti).
Inoltre sono chemioorganotrofi eterotrofi: cio sono organismi che prendono energia da sostanze
organiche (chemiorganotrofi) dallesterno(eterotrofi) producendo enzimi in grado di digerire le sostanze
organiche(enzimi che vengono usati nel settore alimentare soprattutto).
La cellula fungina presenta una parete cellulare in cui assente il peptidoglicano (che invece presente nei
batteri).La membrana plasmatica analoga a quella delle cellule animali,ma differenza di queste presenta
ergosterolo al posto del colesterolo. Il nucleo circondato da doppia membrana, presenta un grosso
volume ed spesso associato ad un grande vacuolo, luogo in cui vengono depositate le sostanze di riserva
(la maggior parte delle volte nn si riesce ad evidenziare il nucleo proprio perch nascosto dal vacuolo).
Inoltre presentano mitocondri e reticolo endoplasmico.
(Il professore evidenzia alcune differenze tra batteri e funghi aiutandosi probabilmente con una diapositiva
che io nn ho trovato da nessuna parte)In
questa cartella si tenta di fare un confronto tra batteri e funghi:
-il volume: mentre per i funghi si usa il 40x in microscopia elettronica,per i batteri useremo il 100x proprio
perch i volumi sono decisamente diversi.
-riproduzione: la cellula batterica si riproduce in 30 minuti circa a differenza dei funghi che hanno bisogno
di circa due ore ,proprio perch vi una maggiore organizzazione cellulare di questi ultimi
-nucleo: eucariotico nei funghi, procariotico nei batteri
-organuli: presenti nei funghi, non nei batteri
-parete cellulare:con peptidoglicano nei batteri, senza nei funghi, ma con presenza di glucani mannani e
chitina
-dimorfismo: assente nei batteri, caratteristico dei funghi
PARETE CELLULARE la maggior parte della parete fatta da polisaccaridi, con una sostanziale presenza di
lipidi e proteine(queste ultime importanti dal punto di vista patogenetico).
Un ruolo importante hanno i polisaccaridi:
-chitosano, proprio dei zigomi ceti con legame glicosidico beta1-4
-chitina, presente negli ascomiceti con legame glicosidico beta 1-4(la cellula dei basidiomiceti ha una
quantit molto pi grande rispetto agli ascomiceti)
-mannani,polimeri di dimannosi
-glucani,polimeri di di glucosio aventi legami glicosidici beta 1-4 o 1-3
Microbiologia - Medicina e Chirurgia polo A 2012/2013 - sbobinature lezioni
72
Esistono due ipotesi in merito alla struttura della parete:
-modello a blocchi in cui si formano chitina e mannani che si sistemano in mattoni che determinano la
forma della parete
-struttura lineare che presuppone il fatto che al di fuori della membrana ci sia la chitina che crea
unimpalcatura insieme ad uno stato di beta 1-6 glucani e un altro di mannoproteine, che si sistemano su
strati diversi,con i glucani che sistemano in mezzo ai due strati creati da chitina e mannoproteine. mentre i
glucani possono nn essere presenti allinterno della struttura ,le mannoproteine sono presenti in tutti, ed in
tuttte le cellule si sistemano allesterno.
I glucani conferiscono rigidit alla cellula,mentre le mannoproteine svolgono un meccanismo di adesione
cellulare. in compenso la chitina determina lestensione della parete e perci il suo accrescimento. in
particolare le mannoproteine hanno un ruolo immuno modulatorio: aspetto attuale ci spiega perch un
fungo in particolare ,candida albicans si sviluppato e come soprattutto. Candida infatti ha anche un
aspetto positivo nel nostro organismo al livello del nostro sistema digerente.
MEMBRANA PLASMATICA ricca in ergosterolo derivante dallo squalene ,
che determina un composto intermedio chiamato lanosterolo(penso si chiami cos) prima di dare
lergosterolo.
Le spore sono il prodotto della riproduzione sessuale ,anche se si parler pi precisamente di
conidi,utilizzati soprattutto nella riproduzione asessuata LE IFE=proprie delle muffe,sono cellule cilindriche
che vanno a formare dei tubuli, che presentano dei setti che vanno a compartimentale le cellule allinterno
delle ife(nn tutte presentano per delle ife settate). Queste ife presentano dei pori che regolano la
concentrazione di acqua e Sali.
RIPRODUZIONE la maggior parte dei funghi si riproducono per gemmazione ,anche se possiamo trovare
casi di scissione binaria;da specificare il fatto che la cellula figlia sar sempre pi piccola della madre. Le
cellule nn presentano centrioli, ma un corpo polare che si trova sulla membrana del nucleo che
,duplicandosi andr a dirigere la divisione del corredo cromosomico.
Prendendo come esempio Candida Albicans,esso presenta un corredo diploide, anche se non conosciamo
tuttora la maodalit di riproduzione ,proprio a causa del suo completo adattarsi in altri organismi.
Sappiamo per che essa forma sulla mucosa ,in certe condizioni, un tubulo germinativo che dar luogo ad
un ifa;essa a sua volta si accresce dalla cellula apicale che aumenta di volume; il fungo perci capace di
trasformarsi da uno stadio in cui praticamente lievito ad una fase in cui pu formare ife, stadio in cui esso
esprime la sua massima virulenza.
Linsieme delle ife poi former un micelio vegetativo che a sua volta si differenzia in micelio riproduttivo (nn
lo capisco bene 1.15.16) ; esempi tipici sono le colorazioni in verde delle muffe ad esempio nelle arance ,in
cui si ha un accrescimento apicale con produzone di nuovo citoplasma e parete in cui si formano ife o
settate o genocitiche.
Funghi dimorfi temperatura dipendenti= sono funghi che vivono come muffe, ma che in particolari
condizioni ambientali,riescono a svilupparsi come lieviti e perci a creare infezioni,tossiche per luomo. Ci
che incide maggiormente nel dimorfismo di questi particolari tipi di funghi la temperatura corporea,
Microbiologia - Medicina e Chirurgia polo A 2012/2013 - sbobinature lezioni
73
ambiente adatto allo sviluppo dei funghi come lieviti(si nota una grande produzione di alfa glucani che
sostituiscono i beta).
Le spore sono risultato di processi meiotici,a differenza dei conidi che originano da processi mitotici.
Lorigine de conidi pu essere tallica, cio il conidio pu essere derivato da una trasformazione della cellula
vegetativa,con un tratto dellifa che si trasforma in conidio (tallo conidio)..(parla di origine blastica ma nn
chiaro1.28.30).
Nel caso dei blastoconidi, il conidio viene prodotto ex novo come il caso dei lieviti.
La riproduzione sessuale comporta la fusione di cellule aploidi che portano ad un nucleo diploide con
produzione di nuove spore aploidi; nel caso dei basidiomiceti esiste una fase dicariotica cio, quando due
ife si sono unite, presentando un nucleo bianco ed un nucleo nero, si avr la cosiddetta connessione a fibia
che assicura che un nucleo vada verso un versante opposto allaltro. Le connessioni a fibia sono perci
tipiche di una cellula avente due nuclei (dicariotica). La fusione porta allo zigote che a sua volta determina
la formazione di [Link] ascomiceti sono caratterizzati da spore formate allinterno di aschi, il
quale asco pu essere contenuto allinterno di corpi fruttiferi, anche qui si avr la fusione di due ife che
portano alla formazione dello zigote.
(1.37.35 il professore mostra una diapositiva incui si nota il meccanismo di riproduzione asessuata).
Infine gli zigomiceti,che sono delle strutture primitive che si producono sessualmente con strutture
chiamate sporangi;anche se le ife nn sono settate, un setto comparir comunque perch si dovranno
limitare due cellule aploidi che unite insieme daranno un zigosporangio e successivamente una zigospora di
natura aploide, in grado di promuovere la riproduzione sessuata.
Si parler allora di:
-anamorfi, i miceti che presentano riproduzione asessuata
-teriomorfi i miceti che presentano riproduzione sessuata
-olomorfi le presentano entrambe
I miiceti sono suddivisibili perci in .
-zigomiceti
-basidiomiceti
-ascomiceti
-deuteromiceti(sono tutti quei funghi di cui nn si conosce il loro stadio perfetto)
Lezione 4 Meccanismi di Patogenicit
I funghi causano malattia attraverso 3 meccanismi principali:
1. "Meccanismo della risposta immunitaria di tipo allergico". Ci sono casi, anche se non molto frequenti di
rinosinusite allergica fungina, aspergillosi broncopolmonare, cio i funghi possono mediare la loro azione
patogena attraverso lo sviluppo di una ipersensibilit da parte dell'ospite (ma questo lo fanno cos come
possono fare anche altri allergeni)
Microbiologia - Medicina e Chirurgia polo A 2012/2013 - sbobinature lezioni
74
2. "Ingestione di tossine". Avete studiato il Clostridium Botulinum, per fare un es., ed in quel caso non
tanto il batterio quando l'ingestione delle tossine a dare patogenicit. Anche i funghi producono tossine, e
la loro azione patogena pu manifestarsi sotto 2 aspetti, uno lo chiamiamo micetismo e l'altro
micotossicosi. Fondamentalmente il micetismo dovuto all'ingestione di funghi, che si pensano essere
eduli e invece contengono tossine che causano avvelenamento da funghi. La micotossicosi invece un
processo meno evidente, ma importante.
3. "Infezione dei tessuti superficiali e profondi" e quindi le MICOSI.
Il micetismo non lo tratteremo, anche perch oggi vengono tenuti corsi per la conoscenza delle varie specie
velenose, si tratta quindi di un fenomeno piuttosto raro. Da tenere presente magari che alcuni funghi
presentano tossine termolabili, e dunque questi funghi sono velenosi crudi, ma innocui quando cotti.
Un breve cenno sulle micotossicosi, sulle quali non ci fermeremo. Quello che occorre sapere che la
micotossicosi associata all'ingestione di un alimento. Vi ho fatto l'es. del Clostridium Botulinum, ma con i
funghi la situazione un p pi complessa. Perch? Perch questi funghi che producono le tossine sono
soprattutto di campo, si trovano nelle nostre colture e dunque parassitano le piante.
Seconda cosa, la produzione di tossina da parte di questi funghi legata da un lato all'avere i GENI per la
produzione della tossina, inoltre devono esserci le condizioni ambientali adatte perch si verifichi la
produzione della tossina. ATTENZIONE per: IL FATTO DI ESSERE UN FUNGO TOSSICOGENICO NON
SIGNIFICA CHE C' ANCHE LA MICOTOSSINA, la tossina deve essere ricercata perch NON fungo uguale
tossina (lo stesso vale per il clostridium botulinum). La produzione della tossina legata a precisi parametri
di temperatura, umidit, presenza di acqua libera, il fungo va in uno stadio di metabolismo secondario.
Nelle cellule si distingue un metabolismo primario, atto alla produzione di massa cellulare; ed un
metabolismo secondario, in cui si ha l'arresto del metabolismo primario e la produzione di metaboliti
secondari, come ad es. nei funghi le tossine o anche gli antibiotici.
Il grado di tossicit (della micotossina) dipende dall'et, dal sesso e dallo stato nutrizionale del soggetto.
L'analisi dell'alimento sospetto rivela sempre segni di attivit fungina (potreste anche non trovare il fungo,
cio magari non visibile l'ammuffimento, ma di fatto la micotossina potrebbe esserci).
La micotossicosi pi visibile dai nostri colleghi veterinari.
Come funghi che producono micotossine nelle slide ho riportato 3 es. :
- ASPERGILLUS (aflatossine)
- PENICILLIUM (acrotossine)
-FUSARIUM (zearalenoni)
Vi sono altre specie ovviamente. Come tossine abbiamo, come vediamo, ad es. per l'aspergillus le
aflatossine. Le aflatossine sono importanti poich ad esse si deve un'azione MUTAGENA, ed stata vista
una correlazione significativamente dimostrata tra consumi di alimenti ricchi in micotossine e insorgenza
dell'epatocarcinoma (si sta studiando anche su altre micotossine, e qui a Catania stanno mettendo a punto
tecniche di studio per rilevare presenza di micotossine nei liquidi biologici, e vedere cos che incidenza ha la
catena alimentare sul fatto che una persona possa avere micotossine nei suoi liquidi biologici ).
Ci sono alcune patologie umane correlabili all'ingestione di tossine.
Quindi cosa c' da sapere sulle micotossine: innanzitutto il fungo pu parassitare questi prodotti quando
essi si trovano in coltura, nel campo. Quando poi i prodotti vengono raccolti e conservati nei silos, come ad
es. accade anche col fieno, cio coi mangimi animali, a seconda delle condizioni in cui sono i luoghi di
conservazione i funghi hanno la possibilit di accrescere la loro massa miceliale e produrre tossine.
Questo importante perch le tossine si accumulano durante la catena alimentare, ed ad es. le afatossine
sono termostabili e resistenti ad alcuni trattamenti chimici, allora qual' il punto? Se le tossine sono gi
Microbiologia - Medicina e Chirurgia polo A 2012/2013 - sbobinature lezioni
75
presenti nel foraggio, esse verranno ingerite dall'animale e si accumuleranno nel latte, dal latte nei derivati,
e da qui passeranno al consumatore.
Infatti la movimentazione delle merci (importazione ed esportazione) anche sottoposta a controlli per
rilevare micotossine, il nostro gruppo di agraria ha ricercato nel vino presenza di otratossine.
L'atro aspetto quello delle MICOSI, il pi importante.
Le micosi sono patologie da infezione.
Ho messo questa frase:"i funghi sono microrganismi poco virulenti, le malattie da essi causate sono
malattie in genere da ritenersi opportunistiche" mi piace sottolinearlo per ricordarvi che nei funghi si sono
soprattutto affermati GENI di ADATTAMENTO.
I fattori che favoriscono lo sviluppo di micosi sono deficit immunitari, tumori e quant'altro.
Le micosi sono prevalentemente patologie non contagiose, fanno eccezione solo alcune dermatofitosi.
Le fasi che portano alla malattia da infezione sono:
- Esposizione al patogeno
- Aderenza alla cute ed alla mucosa
- Invasione attraverso l'epitelio
- Colonizzazione e moltiplicazione con produzione de fattori di virulenza
I fattori di virulenza sono essenzialmente di 2 categorie: quelli che favoriscono l'invasivit del
microrganismo; quelli che ne favoriscono la produzione di tossine, attraverso le quali il microrganismo da
malattie.
- Danno tissutale
E quindi alla fine malattia da infezione.
Questo vale sia per i funghi che per i batteri, ma per il fungo c' un passaggio in pi da sottolineare: spesso i
funghi devono competere con il microbiota microbico commensale. Cio il fungo deve competere con i
batteri che colonizzano cute e mucose dell'organismo, tant' vero che spesso la cura antibatterica,
antibiotica, predisponente all'insorgenza di micosi.
I principali meccanismi di difesa del nostro organismo, a vari livelli,nell'interazione funghi-uomo sono:
1. microbiota batterico
2. integrit barriere muco-cutanee
3. immunit innata
4. immunit acquisita
L'immunit un fattore importante, perch quando sospettiamo un'infezione fungina dovremmo sempre
prima chiederci "chi questo paziente?" com' combinata la sua immunit acquisita e innata.
Nel rapporto immunit- infezione vi porto l'es. dell'aspergillus (il prof si riferisce ad una slide con un grafico
presa da un sito dedicato all'apergillus). Prendiamo la specie pi importante di aspergillus, l'aspergillus
fumigatus, e vedete che AL VARIARE DELL'OSPITE VARIA IL TIPO DI PATOLOGIA, cio lo stesso fungo se
cambia l'ospite modifica la patologia, e questo un dato importantissimo per quanto riguarda l'interazione
funghi uomo.
Infatti per quanto riguarda l'aspergillosi invasiva acuta l'avremo soprattutto quando aumentano i fenomeni
di immunodeficienza, ad es. nei pazienti neutropenici (nel paziente che per via di determinate terapie ha
assenza di neutrofili, infatti in questi pazienti fatta profilassi).
Nei pazienti "normali", che non hanno grandi problemi immunitari, troviamo una serie di patologie (come
tracheobronchite, aspergillosi cronica fibrosante). Nel paziente che magari dal punto di vista immunologico
sano ma ha una lesione delle vie aeree, come una brutta bronchiectasia, l'aspergillus pu andare a
colonizzare la cavit e sviluppare la malattia che poi diventa ASPERGILLOMA. Noi riteniamo l'aspergilloma
Microbiologia - Medicina e Chirurgia polo A 2012/2013 - sbobinature lezioni
76
una malattia da colonizzazione, in quanto il fungo arriva, non viene eliminato poich l'organismo non
riesce, e pu svilupparsi. Quindi nel paziente sano trovo lievi disfunzioni, che anche difficile percepire, che
possono portare all'adattamento del fungo.
Infine abbiamo le allergie, in questi casi non ho il paziente immuno-depresso ma ho il paziente iperreattivo.
In base a ci chiaro che le condizioni del paziente, il paziente in se quello su cui pi dobbiamo
concentrarci quando sospettiamo una micosi.
Vi do adesso delle definizioni sulla classificazione delle micosi. Gli americani sono stati pi decisi nella
classificazione, distinguendo: SUPERFICIALI e PROFONDE. Cio hanno fatto questo tipo di ragionamento:
consideriamo le barriere. L'integrit delle barriere, abbiamo detto, un punto focale per difenderci dalle
infezioni. bene, tutte le infezioni che si sviluppano al di fuori della barriera (come le infezioni mucocutanee) sono SUPERFICIALI; quelle che invece sono oltre la barriera, comprese tutte le sottocutanee,
sono invece PROFONDE.
In realt invece in passato si preferiva fare una distinzione pi dettagliata, che ci utile in clinica:
- Micosi superficiale
- Micosi cutanee
Tra queste 2 la differenza la fa essenzialmente la significativa reazione immunitaria dell'ospite.
Ho infezioni superficiali quando esse interessano strutture cheratinizzate come le ciglia (la cosiddetta
"pietra bianca", infezione da trichosporon cutaneum che provoca noduli nelle ciglia), la stessa oligomicosi
(infezione esclusiva della lamina), l'infezione della lamina ungueale pur essendo una patologia non si porta
dietro una reazione immunitaria. Quindi fondamentalmente tra la micosi superficiale e cutanea la
differenza la fa una significativa risposta immunitaria.
Tra le forme cutanee abbiamo ad es. la tinea corporis, che io vi ho gi citato, che da una tipica lesione
circolare. O anche la tinea capitis, diffusa nei bambini.
- Micosi sottocutanee
Esse sono messe a parte poich hanno una patogenesi molto particolare. Possono essere causate da funghi
diversi, ma hanno un punto di partenza ben definito: il fungo arriva al sottocutaneo PER IMPIANTO
TRAUMATICO, cio il fungo arriva al sottocutaneo o perch c' una soluzione di continuit o perch magari
il paziente si conficcato una spina, c' una lesione. L'infezione sottocutanea si diffonde per contiguit, o
attraverso il linfatico, e c' una rilevante risposta immunitaria dell'ospite. Possiamo rilevare micosi
sottocutanee anche in pazienti normali.
- Micosi profonde
Sono determinate da patogeni temperatura-dipendenti. Sono solitamente infezioni polmonari, ma possono
disseminare anche per via ematica; c' una reazione immunitaria da parte dell'ospite (con patogeni
primari). Nel caso in cui si tratti di un patogeno opportunista non c' risposta, e l'infezione diventa
profonda proprio perch manca la risposta immunitaria, e questo il caso ovviamente di pazienti
immunodepressi. Quindi la via elettiva di infezione profonda quella aerea, per poi dal polmone diffondersi
ad altri organi.
A seconda del tipo di micosi l'approccio sar diverso. Inoltre nel caso di micosi sottocutanea non sempre la
lesione visibile, ma pu fistolizzarsi nel sottocutaneo.
Modalit d'infezione
1. Contagio diretto o mediato da fomiti.
Le dermatofitosi ad es. possono essere trasmesse per contatto diretto, o attraverso animali, o ancora
tramite fomiti (cio oggetti come pettini, forbicine ecc... che possono trasportare le cellule fungine dalla
sorgente all'ospite)
Microbiologia - Medicina e Chirurgia polo A 2012/2013 - sbobinature lezioni
77
2. Inalazione.
3. Impianto attraverso la barriera cutanea. Ho portato per questo caso l'es. delle sottocutanee, ma abbiamo
in ospedale il cateterismo.
4. Per traslocazione dalle mucose.
Nell'animale da laboratorio immuno-depresso stato visto che le ife, o i lieviti, dalla mucosa intestinale
potevano diffondere. Nell'uomo lo spieghiamo con le candidosi. Allora le mucose possono diventare
sorgenti dalle quali possono partire cellule lievito che arrivano al sangue, quando la mucosa alterata.
Quindi si ritiene che i lieviti, in particolare candida albicans, possano avere questo fenomeno di
traslocazione, cio passare dal loro abituale sito (la mucosa) al circolo.
5. Per accidentale inoculazione intravasale (era il caso dei tossicodipendenti, la zigomicosi cerebrale cos
contratta)
[Valentina fa una domanda, per non riporto la risposta perch il prof non credo abbia capito cosa
intendesse dire e quindi ha impolpettato cose a caso]
IMPORTANTE. Dirvi che c' un'origine esogena ed una endogena per le infezioni non nulla di nuovo.
L'altro aspetto che l'epidemiologia delle micosi, cos come per i batteri, pu anche essere vista sia
nell'ambito ospedaliero che comunitario. Non che queste siano situazioni diverse, per vero che nelle
situazioni ospedaliere si creano situazioni tali da avere particolari condizioni di epidemiologia, da avere cio
infezioni che sono tipiche dell'ospedale. Nei casi di micosi ospedaliere o comunitarie noi abbiamo tutti i tipi
di funghi, che ovviamente hanno un vario grado di adattamento all'uomo, e li ho voluti distinguere in
questa maniera, intanto distinguendo tra:
- PATOGENI PRIMARI
- PATOGENI OPPORTUNISTI
I patogeni primari sono quelli che possono dare infezioni nel paziente sano. Inoltre tra i patogeni primari ho
voluto distinguere: parassiti FACOLTATIVI e parassiti OBBLIGATI, obbligato quando il fungo non ha altro
habitat e il parassitismo l'unica via per la sua sopravvivenza. Alcuni dermatofiti sono parassiti obbligati.
Mentre i facoltativi sono quei dimorfi temperatura-dipendenti.
Tra i patogeni opportunisti abbiamo poi gli ENDOSAPROBI-COMMENSALI.
Tutti questi funghi sono variamente adattati all'uomo.
Abbiamo poi i non adattati, che sono i SAPROBI (che si trovano nel terreno)
Il patogeno primario parassita facoltativo, qui ho messo il coccidioides immitis; fondamentalmente la
trasmissione dall'ambiente al mammifero, non c' trasmissione da malato a malato. Pur essendo
patogeno primario dall'ambiente. Questi sono parassiti facoltativi perch COMUNQUE realizzano il loro
ciclo vitale nell'ambiente esterno, ed occasionalmente possono parassitare un organismo causando
malattia.
I patogeni primari parassiti obbligati, un es. un dermatofita, il trichophyton mentagrophytes. In esso
abbiamo trasmissione mammifero-mammifero perch pu passare dall'animale all'uomo.
Tra i parassiti obbligati molto adattati all'uomo c' il caso del trichophyton rubrum, tanto adattato da dare
infezioni subcliniche.
Patogeni opportunisti-commensali, come esempio abbiamo la malassezia, un fungo lipofilo che vive sulla
cute di varie specie animali e dell'uomo. Alcuni tipi di malassezia sono adattati solo a specie animali, altri
circolano tra uomo ed animali.
Endosaprobi commensali, il caso di candida albicans che ha una nicchia nell'uomo ma anche in altre
specie. Da commensale colonizza la mucosa gastro-intestinale, in maniera pi o meno stabile, e pu poi
passare ad altre mucose. NON C' PERSONA CHE NON SIA VENUTA A CONTATTO CON LA CANDIDA. Quando
Microbiologia - Medicina e Chirurgia polo A 2012/2013 - sbobinature lezioni
78
noi facciamo il test alla candidina ad un individuo, non lo facciamo per vedere se venuto a contatto con
candida, ma lo facciamo per vedere se alla persona funziona il sistema immunitario, perch diamo per certo
che tutti siano venuti a contatto con questa specie di fungo.
Come meccanismo di patogenicit abbiamo ovviamente l'adesione, lo shift che porta all'infezione
superficiale, inoltre candida ha la possibilit di traslocazione che porta all'invasione vascolare. Quest'ultimo
punto lo testimonia la "candidemia", il fatto che io isolo candida dal circolo. Ed infine candida, attenzione,
esce dal circolo e va a colonizzare tessuti profondi, gli organi interni (e questo tipico). La permanenza di
candida nel sangue limitata, poich va a localizzarsi negli organi interni (vedrete che uno degli esami pi
richiesti per un paziente con sospetta candidosi quello di fare il "fundus oculi", o magari ecografia al
fegato attraverso la quale si possono vedere le cosiddette lesioni ad occhio di bue, tipiche).Ci sono una
serie di lesioni tipiche da candida.
Infine i saprobi, come l'aspergillus fumugatus. Essi vivono nel suolo.
VERSO TUTTI I SAPROBI NOI ABBIAMO EFFICACI DIFESE NATURALI, il pilastro della difesa oltre l'integrit
della barriera l'immunit innata. Sono opportunisti nell'ospite compromesso.
Nelle micosi ospedaliere troviamo soprattutto endosaprobi-commensali e saprobi. Questo perch in
ospedale con la cateterizzazione, le patologie che vengono curate, e le terapie somministrate, abbiamo i
pazienti pi a rischio per queste infezioni opportunistiche (come candidosi, o aspergillosi come zigomicosi).
Fattori di virulenza
Li chiamiamo fattori di virulenza anche se in realt sappiamo che di fatto sono fattori di adattamento del
fungo.
1. ADESIVITA'. Nel fungo pu poggiarsi su meccanismi specifici o aspecifici (complementariet sterica dei
recettori cellulari dell'ospite e adesine della cell. fungina le mannoproteine). Il meccanismo di adesione pu
essere diretto, o pu verificarsi attraverso un ligando bivalente che costituisce un ponte tra il parassita e i
recettori delle cell. superficiali; e questo ligando bivalente pu essere una molecola, una proteina, una
macromolecola, ma pu essere anche un microrganismo, un batterio. I batteri possono avere recettori che
legano il recettore fungino, ed al contempo un recettore che leghi la cell.
[Link]. Da distinguere tra quello temperatura-dipendente, che studieremo con i patogeni primari;
e quello non strettamente dipendente dalla temperatura, che tipico di candida albicans, di malassezia.
Il dimorfismo senza dubbio un fattore molto caratteristico di virulenza dei funghi.
3. PRODUZIONE DI ENZIMI. Come la cheratinasi (una proteinasi specifica per la cheratina); proteinasi;
fosolipasi e cos via.
4. PRODUZIONE DI TOSSINE. Attenzione per, non mi riferisco alle micotossine (che vengono ingerite con
gli alimenti), ma alle tossine che il fungo pu produrre durante l'invasione, la fase invasiva.
5. PARTICOLARI COMPONENTI CELLULARI. Es. pigmenti, capsula, mannoproteine, che possono interferire
con le difese immunitarie. E per la capsula da tenere presente il cryptococcus neoformans, perch
l'unico fungo a possedere una capsula (infatti per esaminarli si pu fare un esame per contrasto su fondo
nero, o anche rilevare gli antigeni).
A me interessa che ricordiate i fattori di virulenza,e qualche esempio.
"BIOFILM"
Tra i batteri molti producono il biofilm, mentre tra i funghi ve ne una percentuale minore.
Si dice che quando ad es. abbiamo candidemie date da ceppi che produco biofilm, la prognosi peggiora,
cio si visto che la mortalit pi alta. Anche per le candidemie associate a cateteri, sui quali pi facile
si crei il biofilm, stato visto abbiano una mortalit pi elevata rispetto a quelle non associate a cateteri. La
rimozione del catetere rappresenta uno dei rimedi immediati da attuare.
Gli studi sul biofilm di candida sono stati fatti prendendo in considerazione un unico ceppo, ma in pratica
clinica poi ci troveremo spesso davanti a biofilm misti.
Microbiologia - Medicina e Chirurgia polo A 2012/2013 - sbobinature lezioni
79
Formazione del biofilm, seguendo studi eseguiti su candida (il prof indica e commenta la slide).
La prima fase ovviamente l'adesione. Abbiamo una fase iniziale, una fase intermedia ed una fase di
maturazione del biofilm.
Nella fase iniziale ad es. stato visto che c' un aumento di espressione di geni che controllano le pompe
di efflusso CDR e MDR, ed ovviamente comincia anche la formazione di quei composti che vanno a
costituire il cosiddetto QUORUM SENSING, cio sostanze che servono a far comunicare tra loro le cell. e far
avenire il processo di accrescimento e moltiplicazione. E' chiaro che non ci pu essere biofilm senza
adesione, per cui la prima fase caratterizzata dall'adesione, quindi ad es l'espressione delle proteine ALS o
le stesse proteine di membrana avranno un ruolo importante.
Durante la fase intermedia, prima della maturazione, avremo non solo la moltiplicazione, ma anche (e
questo il caso di candida) la formazione di ife. IL biofilm di candida albicans caratterizzato da questo
importante passaggio, nel biofilm il fungo va incontro alla trasformazione dalla fase di lievito alla fase ifale.
E questo lo dimostra sia la presenza di proteine che sono tipiche della parete ifale (come HWP, hypal wall
protein) o il fattore EAP1.
Il tutto porta ad avere uno strato di cell basali adese al substrato (fatto in prevalenza da lieviti), uno strato
nel quale vanno in alto le ife, i tubuli germinativi che si sono formati; ed questo strato che via via
aumenter di spessore.
Il biofilm si pu formare sia su superfici inerti, come cateteri o protesi, ma si pu anche formare sui nostri
tessuti. Studi fatti su animali hanno provato ci.
Quindi quella del biofilm una caratteristica che deve essere necessariamente attenzionata.
Nell'aspergillus abbiamo la stessa situazione riscontrata per candida. Guardando le sue fasi abbiamo:
- Adesione del conidio.
- Germinazione
- Filamentazione
- Biofilm maturo
Come molecole, meccanismi in gioco: inizialmente abbiamo le adesine, via via poi, avendo la cell gi
aderito, si perde l'importanza delle adesine. Anche in aspergillus un ruolo importante lo hanno le pompe di
efflusso, che devono pompare fuori materiale per garantire la produzione del materiale extracellulare, che
poi conterr tutto l'insieme delle ife.
Questo biofilm ad es importante nella resistenza ai derivati azolici. Questo importante perche quando in
protesi o cateteri vengono a formarsi biofilm probabilmente il farmaco che somministriamo serve, ma per
la forma plantonica (cell disperse nel brodo) non per cell protette da biofilm.
Utilizzando dei marcatori immunologici, degli anticorpi marcati, rilevabili anche in microscopia elettronica a
trasmissione (per aspergillus) hanno iniziato a vedere che nella matrice del biofilm ci troviamo il
galattomannano (che un antigene che usiamo per rilevare infezioni da aspergillus), ed anche il
galattosaminogalattano, un altro polisaccaride; ci troviamo gli alfa 1-3 glucani; ci troviamo proteine.
La natura idrofobica del biofilm stata chiarita per la presenza delle idrofobine. Ci sono poi anche dei
pigmenti, come la melanina.
Quindi fondamentalmente: proteine, carboidrati, pigmenti, MA ANCHE DNA. Nel biofilm si riscontra la
presenza di DNA. questo DNA non dovuto all'autolisi di qualche cel che ha cos liberato il suo DNA, ma
un DNA che ha una funzione nel biofilm. La funzionalit del DNA nel biofilm stata provata dal fatto che
trattando il biofilm con delle dnasi si modifica l'azione del farmaco (questa una strategia che oggi
perseguita: trattando il biofilm con dnasi e farmaco stato visto che il farmaco riesce ad avere maggior
efficacia, maggior azione. Sono le ultime ricerche, del 2012)
Microbiologia - Medicina e Chirurgia polo A 2012/2013 - sbobinature lezioni
80
Quindi batteri-funghi a formare un biofilm misto. NON tutti tutto, ma alcune specie batteriche con alcune
specie fungine. Da tempo si parla della sinergia tra stafilococcus e candida, ed adesso abbiamo studi che
chiarisco ci.
Lezione 5
PATOGENI PRIMARI:
Abbiamo cominciato a conoscere i funghi e abbiamo parlato di patogeni primari. Questo un modo di dire,
di classificare i funghi, in quanto noi siamo abituati a classificare, a creare dicotomie, sebbene nelle
discipline biologiche non tutto sempre dicotomico. Esistono situazioni di continuum: anche parlando della
simbiosi come mutualismo, commensalismo e parassitismo questi sono modi di classificare da parte nostra
la conoscenza acquisita sui rapporti tra i vari organismi, ma chiaramente vi sono anche situazioni di
transizione da uno stato allaltro e ne abbiamo gi cominciato ad accennare. Per non possiamo non dire
che allinterno di questo gruppo di microrganismi che ci interessano dal punto di vista medico, ovvero i
funghi o miceti, esiste un gruppo che possiamo sicuramente considerare come patogeni primari.
In questa lezione si parler esattamente di questo.
Per prima cosa si parler dei DERMATOFITI, che nella loro collocazione come anamorfi sono nella classe
degli ifomicetes. Questo perch quelli che noi abbiamo definito funghi imperfetti li abbiamo distinti in base
alla loro organizzazione cellulare:
-unicellulari blastomiceti
-pluricellulari ifomiceti, perch lunit fondamentale lifa
In questo gruppo dei deuteromiceti vi sono ovviamente gli anamorfi di ascomiceti e basidiomiceti. Quindi
tolti gli zigomiceti, che sono primitivi e vedremo cosa implicano nella patologia umana, gli ascomiceti e
basidiomiceti sono tutti tra i deuteromiceti e sono gli anamorfi che a noi interessano, distinti in -(non
comprensibile)- e ifomiceti.
DERMATOFITI:
questo termine dal greco ha il significato di piante del derma. Piante perch erano stati classificati tra i
vegetali della cute, in quanto sin dallinizio ci si accorse che questi funghi erano capaci di dare malattie a
livello cutaneo.
Sotto questo termine dermatofiti si raggruppato in modo pratico (non tassonomico) tutte quelle specie
che si sono dimostrate patogene per luomo, ovvero quelle che hanno dato malattie alluomo, malattie che
in medicina di fatti definiamo dermatofizie.
Sono tutti funghi filamentosi ialini, monomorfi, in grado di metabolizzare la cheratina.
Ovvero non sono dimorfi ma sono sempre in fase miceliale. Sono ialini, quindi non hanno pareti
pigmentate. Oltre alla melanina, di cui si gi parlato, esistono altri pigmenti che rendono i funghi a parete
scura, a volte nera. Tali funghi vengono detti demaziacei o meglio feoifomiceti. Non questo il caso.
Sono in grado di metabolizzare la cheratina. Vi ho presentato questa tabella storica (vedi slides per seguire
ragionamento professore) per far vedere che Sabouraud allinizio del secolo scorso li aveva classificati in
Microbiologia - Medicina e Chirurgia polo A 2012/2013 - sbobinature lezioni
81
base al parassitismo del pelo, poi Langeron ed Emmons nel 1934 con una classificazione di tipo botanico.
Ancora oggi manteniamo la distinzione in questi tre generi:
MICROSPORUM
TRICHOPHYTON
EPIDERMOPHYTON
Questi tre generi racchiudono le specie che interessano luomo e sono evidentemente conosciute da
tempo.
I dermatofiti causano malattie in soggetti immunocompetenti e generalmente invadono soltanto le
strutture cheratinizzate superficiali. Le specie zoofile e antropofile sono da considerarsi parassiti obbligati.
Lespressione clinica delle dermatofitosi varia fortemente sia dallospite che dalla specie fungina. Questi
sono concetti fondamentali da tenere presenti, anche per la pratica clinica.
Come si distinguono i tre generi?
Fondamentalmente li distinguiamo oltre che per le
caratteristiche macroscopiche delle colonie che si sviluppano nel terreno ( in teoria avremmo dovuto
approfondire in questa parte del corso anche queste conoscenze biologiche elementari, ma non lo faremo),
da caratteristiche fondamentali dal punto di vista della riproduzione asessuata, in quanto sono tutti allo
stato imperfetto, con formazione di macroconidi e microconidi. Ad esempio il genere dellepidermophyton
non ha microconidi, mentre gli altri due generi li presentano. La caratteristica della forma, della
dimensione, del modo in cui sono raggruppati e della parete (echimulata presente nel microsporum; liscia
in trichiphyton) riferite ai macroconidi di fatto fanno la differenza tra i tre generi. Dunque quando isoliamo
in laboratorio un dermatofita lo dobbiamo identificare oltre che dalla colonia anche dalla conidiogenesi. La
osserviamo al microscopio e identifichiamo il fungo per lo meno a livello dei generi, in quanto in questo
modo non sempre possibile a livello di specie.
Ma le nostre conoscenze sono andate al di l delle osservazioni macroscopiche e microscopiche ed anche
per i dermatofiti sono stati fatti studi filogenetici e di tassonomia molecolare. Vi presento qui questa tabella
(si rimanda alle slides) che evidenzia la filogenesi della specie di dermatofiti che ci possono interessare.
Questa tabella, che ritroverete tra le diapositive, vi prego di attenzionarla bene. Innanzitutto vi sono tre
colori: nero, rosso e verde.
Il nero si riferisce alle specie antropofile;
Il rosso si riferisce alle specie zoofile;
Il verde si riferisce alle specie geofile;
Vedremo che i dermatofiti hanno degli habitat diversi ed alcuni hanno habitat resi quasi esclusivi, in quanto
si detto che le specie antropofile e zoofile sono parassiti obbligati, ovvero non hanno pi uno stadio di
vita libera nel suolo. Quindi per poter continuare a perpetuare la loro specie devono per forza raggiungere
altri ospiti, luomo oppure altri animali.
In questa tabella evidenziata unaltra cosa importante: vedete che sono riportate non solo le specie con la
nomenclatura dello stato imperfetto (amorfo), ma anche dello stato perfetto, ovvero dove c scritto:
Microbiologia - Medicina e Chirurgia polo A 2012/2013 - sbobinature lezioni
82
A. vanbreuseghemi (T. interdigitale) si traduce in Arthroderma vanbreuseghemi - Trichophyton
interdigitale.
Dove scritto Artroderma gypseum ( M. gypseum) Microsporum Gypseum.
Quindi dentro la parentesi trovate gli anamorfi, fuori parentesi i teleomorfi.
Questa tabella serve a riassumere tre cose fondamentali:
Distinguere i dermatofiti antropofili, zoofili e geofili.
Se le specie abbiano o meno uno stato perfetto.
Filogenesi, che una caratteristica pi biologica degli studi e che a noi interessa relativamente.
Allora in relazione alle probabili fonti di isolamento si detto che epidemiologicamente si possono
distinguere tre grandi categorie: antropofili, zoofili e geofili.
Dermatofiti antropofili: si sono adattati principalmente al parassitismo umano, raramente infettano gli
animali, si riscontrano eccezionalmente nel suolo allo stato saprofitario, le infezioni si trasmettono in modo
prevalente per contatto diretto o meno frequentemente per contatto con strumenti contaminati come
forbici, spugne ecc Questo un punto fermo. Quando ho un paziente del quale sospetto una tinea
corporis, lo posso curare come fanno la maggior parte dei colleghi, senza preoccuparsi di sapere se un
microsporum, trichophyton ecc Ma se io faccio condurre delle indagini per sapere chi lagente
responsabile, io posso anche avere dal laboratorio delle informazioni utili, ovvero conoscere la specie, che
in qualche modo mi aiuta ad intervenire da un punto di vista epidemiologico sul territorio.
I dermatofiti geofili si trovano generalmente nel terreno, ricco di materiali cheratinizzati. In certe
condizioni sono in grado di causare infezioni nelluomo e negli animali.
Infine gli zoofili si isolano inizialmente negli animali, sebbene possono risultare patogeni anche negli
uomini. Non presentano un ciclo di vita saprofitario nel suolo.
Da questa diapositiva vediamo quello che avviene nella pratica:
- dal malato al sano vi pu essere infezione
- dallanimale alluomo vi pu essere trasmissione diretta
- dallanimale vi pu essere contaminazione del suolo (in quanto verosimile che uno zoofilo possa
temporaneamente arrivare al suolo) e dal suolo pu arrivare alluomo
- dal suolo i geofili possono direttamente infettare luomo, ma possono anche infettare lanimale e
dallanimale arrivare alluomo
Queste sono ipotesi che sono state verificate. Ho visto recentemente alcuni casi di Microsporum Gypseum
per i quali lipotesi il contatto con lanimale, sebbene il M. Gypseum sia un fungo geofilo e viva nel suolo.
Allora lipotesi : dal suolo allanimale, dallanimale alluomo.
Tutto questo si traduce nella pratica clinica: se abbiamo un paziente che ha uninfezione da Microsporum
Canis (che per intenderci ha il nome canis ma si trova soprattutto nel gatto) e un altro paziente che vive
nello stesso stabile verosimile che vi sia di mezzo un gatto che ha contaminato prima luno poi laltro.
Microbiologia - Medicina e Chirurgia polo A 2012/2013 - sbobinature lezioni
83
Dunque, sapendo qual il fungo responsabile, possibile dal punto di vista medico ipotizzare la sorgente
dellinfezione. Lo stesso vale anche per gli antropofili: se abbiamo un paziente nel quale viene isolato il
Trichphyton Rubrum, posso verosimilmente pensare che vi sia una circolazione esclusivamente
interumana e dunque poter eventualmente dare suggerimenti e intervenire per limitare la diffusione.
Questo il motivo per cui noi attraverso la conoscenza della specie che ne responsabile possiamo fare un
passaggio dal singolo episodio del singolo paziente che io curo ad un problema di comunit, perch vi di
mezzo la trasmissione del fungo antropofilo attraverso vie che possono anche essere conosciute.
E contagioso? Si trasmette?
In studi sperimentali in cui sono stati creati dei modelli di substrati di cute e di lamine ungueali, si visto
che il numero di conidi aumenta in funzione del tempo, che ladesione degli artroconidi (.) massima a sei
ore e la germinazione inizia dopo circa quattro ore. Sulla lamina ungueale ladesione alla germinazione
stata rivelata invece a sei ore. Quindi fondamentalmente se nel modello sperimentale noi mettiamo in
condizioni ideali lo strato corneo dellepidermide a contatto con questi conidi si sono viste tali
caratteristiche. Quindi in realt il contatto dei conidi con la superficie deve essere prolungato, perch se vi
fosse un contatto con la sorgente da parte del paziente, ma questo lavandosi asportasse i conidi o le cellule
dalla pelle, non avverrebbe contagio. Dunque il contagio pu avvenire, ma linfettivit molto bassa
rispetto ad altre situazioni a cui noi siamo abituati (per i virus soprattutto, ma anche per qualche batterio).
Durante la fase di adesione in microscopia elettronica sono state osservate delle proiezioni dalla parete
verso lo strato corneo. Inoltre le proteasi secrete dai dermatofiti possono facilitare o anche essere
necessarie per unadesione efficiente.
Quindi come prima fase: adesione di artroconidi (o se volete qualche frammento di ifa) al nostro epitelio
cheratinizzato o alla nostra lamina ungueale.
Le cheratinasi sono delle proteasi, ma delle proteasi particolari, in quanto servono a digerire la cheratina,
che una particolare proteina che richiede tali speciali enzimi. E stata dimostrata una relazione diretta tra
cheratinasi e patogenicit. Quindi i fattori di virulenza sono rappresentati dalle cheratinasi.
Tuttavia stato visto che laddove la cheratina pi dura, la lamina ungueale, dove ci sono soprattutto pi
legami realizzati tra amminoacidi che presentano zolfo, quini legami disolfuro, le proteasi non hanno azione
diretta in questo caso, ma hanno bisogno che questi ponti vengano rotti. E stato scoperto nei dermatofiti
un gene, che l SSU1, che codifica per una pompa di efflusso che permette leliminazione di solfiti. Si
pensa che questo meccanismo sia una possibile via di detossificazione per il fungo, ma questo importante
perch la rottura dei ponti disolfuro rende le proteine pi accessibili dalle proteasi. Quindi lazione delle
proteasi diventa efficace e lazione patogena dei dermatofiti, soprattutto di quelli in grado di attaccare le
cheratine pi dure (la lamina ungueale), correlata a questi geni. Allora sorge una domanda: tutte quelle
specie elencate in tabella possono dare tutte qualsiasi tipo di patologia dermatologica? Non cos.
Altro fatto evidenziato stato che nonostante lalto grado di omologia tra i corrispondenti geni ortologhi, vi
una grande variabilit tra le proteine e tra il profilo di secrezione delle proteasi prodotte da diversi
dermatofiti nello stesso terreno di induzione. Ovvero esiste una variabilit tra diverse specie molto
importante. Quindi il grado di infiammazione prodotto in un dato ospite correlato alla differente
regolazione dellespressione delle proteine secrete. Infine la patogenicit durante linfezione pu dipendere
anche da altri processi piuttosto che dalla sola azione diretta dei soli enzimi. Ho messo insieme tutto questo
per darvi un minimo di comprensione della variabilit dei quadri clinici che osserverete. Vedrete che uno
stesso fungo in un ospite diverso dar un quadro clinico diverso, cos come dermatofiti diversi daranno
Microbiologia - Medicina e Chirurgia polo A 2012/2013 - sbobinature lezioni
84
quadri diversi. Quello che noi osserviamo dal punto di vista clinico sono forme che interessano sia infezioni
della cute che delle unghie e dei peli, dunque cute e annessi.
Quindi rispondiamo alla domanda di prima: tutte le specie sono in grado di dare indifferentemente
parassitismo nella cute, nei capelli, nei peli, nelle unghie? Evidentemente no.
Tutte sono in grado di dare infezione e malattia a livello della cute. I peli e la unghie si visto sono infettati
da alcune particolari specie che hanno appunti fattori di virulenza che ne consentono il parassitismo.
Per quanto riguarda i peli, fin dallinizio del secolo scorso si osservato un tipo di parassitismo diverso nei
peli da parte di dermatofiti diversi:
-un primo tipo detto ECTOTHRIX, ovvero il fungo, oltre a crescere nello strato cheratinizzato
dellepidermide, arriva nel follicolo pilifero e si stratifica attorno al pelo, dallesterno.
-un secondo tipo detto ENDOTHRIX, nel quale troviamo il fungo localizzato allinterno del pelo, perch
alcuni dermatofiti hanno la capacit di parassitarlo dallinterno.
Quindi noi abbiamo una trentina di specie di dermatofiti che possiamo riscontrare nella pratica clinica,
sebbene di fatto noi nel nostro territorio non ne riscontreremo pi di sei o sette, a meno di emigrati o
reduci da un viaggio allestero che possibile trasportino qualche fungo che non tipico della nostra area.
Questo un fatto normale per i dermatofiti, che hanno degli areali in cui maggiormente presente una
specie piuttosto che unaltra, anche se con la migrazione vi stata una diffusione di specie che prima erano
localizzate solo in alcuni areali.
Come le chiamiamo le malattie? Le chiamiamo TINEE.
La tinea prende poi il nome dalla sede. Qui ne abbiamo messe alcune:
tinea capitis
tinea barbae
tinea corporis
tinea cruris
tinea pedum
tinea manuum
tinea unguium
tinea favosa (M. gypseum)
La tinea favosa non tale per la localizzazione ma per la modalit con la quale si presenta la malattia: il
favo della T. Schoenleinii.
Come ci difendiamo?
Pur essendo dei patogeni primari abbiamo dei meccanismi di difesa. In linea di massima dobbiamo mettere
tra le difese aspecifiche:
il microbiota cutaneo;
la fisiologica desquamazione cutanea (importante meccanismo di difesa, in quanto man mano che
la nostre cellule vengono allontanate, vengono eliminati anche gli elementi del fungo);
Microbiologia - Medicina e Chirurgia polo A 2012/2013 - sbobinature lezioni
85
il sudore e alcuni lipidi della superficie cutanea (si visto come alcuni acidi grassi, soprattutto a
catena di media lunghezza, pare abbiano un ruolo importante nel controllo dellinfezione);
gli ormoni androgeni;
fattori sierici termolabili;
la transferrina insatura presente nel derma;
le alfa2-macroglobuline;
la temperatura di 37C.
Anche la temperatura un meccanismo di difesa. Vi chiederete allora: a che temperatura crescono i
funghi? Tranne due specie, il venucosum e lo schoenleinii, che crescono bene a 37 C, tutti gli altri
dermatofiti crescono meglio ad una temperatura minore. La cute e la lamina ungueale non hanno una
temperatura di 37C, ma un po pi bassa. Questi per sono dati che mettiamo insieme dagli studi
sperimentali in vitro e da quello che osserviamo nelluomo.
Oltre alle difese aspecifiche vi sono quelle specifiche: riguardano ovviamente la risposta immunitaria sia
umorale che cellulare. Alla base di tutto la risposta pi valida e pi efficiente quella della
IPERSENSIBILITA di tipo RITARDATO. Questa quella che ci garantisce la difesa, tanto che a volte vi sono
delle guarigioni spontanee. Il grado di infiammazione varia per in funzione della specie di dermatofita,
della specie dellospite e del suo stato fisio-patologico. Questo un dato ormai acclamato, per cui anche
per i dermatofiti, a fronte di una forma acuta di dermatofitosi associata alla risposta di ipersensibilit di
tipo ritardato e quindi ad un controllo dellinfezione, c laltro aspetto di una malattia persistente che
corrisponde ad una ipersensibilit IMMEDIATA, con produzione di livelli di IgE e IgG4 e la produzione di
citochine legate alla risposta di tipo TH2 e non invece TH1. Per cui vi saranno soggetti in cui osserverete delle
dermatofizie croniche, non legate al particolare fungo, ma alle situazioni dellospite. Vedrete che nella
pratica clinica sar molto importante, tanto che vi dico che lesposizione alla sorgente molto pi ampia
delle malattie che noi vediamo, perch sicuramente in alcuni soggetti linfezione non attecchisce. Cio i casi
che noi vediamo di malattia sono quei casi in cui, oltre al fungo, vi lospite che con le sue caratteristiche
stato permissivo allinfezione. Naturalmente una stessa tinea corporis che vedete in un soggetto atopico, in
un paziente HIV o in un paziente immunodepresso pu assumere quadri clinici completamente diversi.
Quello che vi voglio sottolineare sono le numerose varianti cliniche che vi possono essere alla tinea
corporis. Questo uno dei motivi per cui noi facciamo spesso parecchie indagini di laboratorio in forme
cliniche assolutamente atipiche e ogni tanto becchiamo le positivit.
Ma la dermatofitosi pu non localizzarsi semplicemente nello strato superficiale, pu raggiungere anche il
derma. In realt ci sono delle situazioni che sono legate essenzialmente al parassitismo del pelo e al
successivo impegno del derma. Possiamo avere un parassitismo del pelo che pu anche verificarsi in
assenza delle tipiche chiazze anulari, per cui non si osserva la solita lesione da tinea corporis, eppure a
livello del pelo si osserva una follicolite che ricorda quella batterica. In questo caso il fungo comincia a
parassitare il pelo e pu dare qualcosa a livello pi profondo:
una follicolite con perifollicolite che non implica la rottura del follicolo/pelo, ma c l induzione di
uninfiammazione che dal punto di vista clinico un parassitismo di tipo ectothrix.
una degenerazione invece della parete follicolare, la rottura e ovviamente una reazione
granulomatosa del derma abbastanza ampia, con forme anche pi impegnative dal punto di vista
clinico.
Microbiologia - Medicina e Chirurgia polo A 2012/2013 - sbobinature lezioni
86
Quindi vero che il dermatofita si ferma nello strato superficiale corneo, ma anche vero che con il
parassitismo del pelo pu interessare il derma. Vi dir di pi: vi qualche lavoro pubblicato nel quale si
ipotizzata la diffusione del trichophyton mentagrophytes nel circolo, perch stato isolato nellemocoltura.
E possibile? Si, io ho condotto prove sperimentali su un paziente che aveva una forma infiammatoria molto
elevata a livello del capo, a cui avevano fatto un drenaggio dellascesso che si era formato e nella fase
successiva avevano fatto delle emocolture. Verosimilmente durante queste manovre gli artroconidi
presenti a livello del derma si sono diffusi in circolo e sono stati rilevati. Quindi il fungo pu crescere, ma di
fatto non abbiamo localizzazioni profonde perch quei meccanismi di cui vi parlavo ci difendono bene dalle
invasioni dei tessuti profondi da parte dei dermatofiti. Per stato biologicamente possibile, tanto che lo
hanno isolato dallemocoltura perch accidentalmente era stato diffuso il fungo per manovre che erano
state fatte durante la pulizia di questa lesione ascessuale imponente.
Per chiudere: i dermatofiti possono localizzarsi nelle strutture superficiali, ma attraverso soprattutto i
follicoli piliferi potrebbe dare una rezione anche notevole a livello del derma, quindi una forma profonda.
Passiamo ad un altro gruppo di funghi patogeni primari.
FUNGHI DIMORFI TEMPERATURA DIPENDENTI:
Anche qui siamo tra gli ifomiceti e dunque tra i deuteromiceti: parliamo di funghi dimorfi, temperatura
dipendenti. Il fatto che siano dimorfi indica che sono caratterizzati da almeno due anamorfi, uno dei quali
rappresentato da ife, quindi dallo stato miceliale. Nelle specie termicamente dimorfiche la temperatura
rappresenta il principale fattore condizionante. Avevamo accennato nella scorsa lezione che nellambiente
naturale (nel suolo in generale, ma anche nella vegetazione) il fungo vive allo stato miceliale, si riproduce
asessualmente con formazioni di conidi (non spore). Quando allora il conidio viene inalato attraverso le vie
respiratorie in una animale, compreso luomo, questo conidio non dar luogo allifa, ma dar luogo a alla
formazione di un lievito con organizzazione unicellulare che si riprodurr in genere per gemmazione. Tutto
questo dipende essenzialmente dalla temperatura, ma anche ovviamente dalla disponibilit dellossigeno e
dalla situazione dei nutrienti. E un fatto di adattamento del fungo che dal suolo viene spostato in tessuti
viventi, gli animali. La temperatura il fattore critico.
Questo il dimorfismo: vi dicevo laltra volta che il dimorfismo lo possiamo realizzare anche in laboratorio,
spostando il fungo dai 25 ai 37C in un terreno ovviamente particolare.
Quali sono le specie di funghi termicamente dimorfici? Sono tutti ascomiceti . Qui non vi da definire un
gruppo, una classe, un ordine, un genere, ma le singole specie una per una e si imparano una per una.
Sono sette specie:
- Histoplasma capsulatum
- Blastomyces dermatiditis
- Coccidioides immitis
- Paracoccidioides brasiliensis
- Sporothrix schenckii
- Penicillium marneffei
Microbiologia - Medicina e Chirurgia polo A 2012/2013 - sbobinature lezioni
87
- Coccidioides posadasii
Una volta erano in sei, poi stata aggiunta la Coccidioides posadasii . Ovviamente vi sono le variet di
queste specie. Dobbiamo evidenziare soprattutto le specie Sporothrix schenckii e Penicillium marneffei, di
cui oggi non parler, perch rispetto agli altri si distinguono per un fatto :
-
Sporothrix schenckii : da sostanzialmente micosi sottocutanee, e l ne parleremo.
Penicillium marneffei: un fungo dimorfico ma opportunista, non un patogeno primario.
Quindi noi oggi ci fermeremo a parlare solo dei patogeni primari, parassiti facoltativi in questo caso. Una
prima caratteristica comune il fatto che il loro areale di specie, ovvero non sono diffusi in tutta la
superficie terrestre ma sono presenti in alcune aree geografiche ben precise. Questo un punto che dovete
assolutamente conoscere, in quanto vi potreste trovare in una situazione in cui sospettate ad esempio una
Histoplasmosi. In questo caso dovete chiedere se allanamnesi risulta che il paziente ha lasciato la Sicilia, se
cos non , non possibile una Histoplasmosi perch in Sicilia non mai stato isolato Histoplasma
capsulatum.
Invece guardando le aree geografiche (vedere slides) in cui abbiamo la presenza delle varie specie, sono
abbastanza ben definite. Negli Stati Uniti, nei territori in cui vi histoplasma c addirittura il cartello in
questo suolo c histoplasma , proprio in quanto sono patogeni primari. Nelle aree dellAfrica vi una
variet di histoplasma capsulatum che quella duboisii. Infine questarea del Sud-est asiatico in cui si trova
lunica specie del genere penicillum patogena opportunista per luomo.
Perch non c Sporothrix schenckii ? Perch cosmopolita e vedremo che si trover soprattutto nelle aree
boschive, dove colonizza la vegetazione del sottobosco e i rami tagliati che ne fanno parte. Tanto che la
Sporotricosi una malattia che spesso viene osservata in lavoratori che si trovano in questi territori. Non
endemica di alcuni stati, ma abbastanza diffusa in tutte le aree geografiche.
Abbiamo detto che per questi patogeni primari parassiti facoltativi la trasmissione dallambiente al
mammifero / dallambiente alluomo. Quindi se ho un paziente che stato nel Sud-est asiatico, in quelle
Microbiologia - Medicina e Chirurgia polo A 2012/2013 - sbobinature lezioni
88
aree dellAfrica o nelle Americhe e poi tornato in Italia, possibile rilevare in questo paziente queste
patologie. E difficile per noi diagnosticarli non essendo abituati neanche ad isolare questi funghi, che
impiegano a crescere in laboratorio da 40 a 60 giorni, mentre gli altri che hanno ovviamente pi frequenza
si sono attrezzati diversamente. Adesso le diagnostiche moderne ci possono aiutare in questa direzione.
Quindi:
- infezione in genere contratta per inalazione di conidi e (salvo rare eccezioni) non trasmissibile per
contatto interumano.
- lentit delle manifestazioni cliniche susseguenti allinfezione dipende dalla carica infettante e dalle
condizioni immunitarie dellospite. Negli individui immunocompetenti spesso le infezioni risultano
inapparenti, mentre negli immunocompromessi si pu avere esito fatale in seguito a disseminazione per via
ematica e linfatica, dal polmone agli altri organi interni con formazione di ascessi ed altro.
Possiamo sintetizzare riguardo lHistoplasmosi:
-il fungo vive nel suolo, attraverso la produzione di conidi, questi possono arrivare alluomo
-nelluomo se la carica infettante non alta, se lospite normoergico (ovvero ha una buona risposta
immunitaria) linfezione si realizza, ma viene controllata dallospite, vi guarigione totale e nellospite
rimane limmunit. Se noi nei territori in cui presente histoplasma andiamo a saggiare la popolazione con
lhistoplasmina , troveremo una risposta abbastanza diffusa nella popolazione a fronte del fatto che solo
una piccolissima parte della stessa pu dire di aver avuto lHistoplasmosi. Quindi la maggior parte della
popolazione si immunizza e diventa pi resistente, pochi hanno avuto la patologia tra gli individui sani,
dipende dalla carica infettante. Quindi: INALAZIONE DI CONIDI INFEZIONE-GUARIGIONE.
-Unaltra situazione invece: INALAZIONE DI CONIDI- INFEZIONE MALATTIA.
Oltre a queste due situazioni ve ne una terza, molto importante per i dimorfi:
INALAZIONE DI CONIDI INFEZIONE NON GUARIGIONE ma PATOLOGIA SUB-CLINICA.
Ovvero il fungo permane nei tessuti in una specie di stato di latenza, che dura anni, ma il fungo non
completamente eradicato, ma rimane vitale per diversi anni. E una condizione che pu essere riattivata se
il paziente va incontro a immunodepressione. In Italia abbiamo avuto casi di Histoplasmosi e Penicillosi da
penicillium marneffei in pazienti che erano stati sottoposti a terapie immunosoppressive, i quali erano stati
in territori nei quali endemico il fungo. Questa una situazione che conoscete anche per altre situazioni,
come per la tubercolosi.
Chi diffonde l histoplasma, dove possibile trovarlo? Lipotesi che ci siano di mezzo gli uccelli,
ma anche i pipistrelli. In Sicilia si anche cercato tra le grotte dellEtna, ma non si mai trovato, ovvero per
quanto si dica che in Sicilia vi siano le condizioni climatiche perch nel suolo possa esserci lhistoplasma, di
fatto non si mai trovato. Anche in Italia si trovato un caso autoctono a Bologna in Emilia Romagna in un
cane, ma l resta il dubbio che la diagnosi sia stata fatta correttamente, perch probabilmente si confuse
con la leishmania.
Microbiologia - Medicina e Chirurgia polo A 2012/2013 - sbobinature lezioni
89
Quindi vengono inalati i microconidi a livello polmonare, ma vi pu essere la diffusione ai diversi organi.
Negli Stati Uniti lepidemia di AIDS ha completamente cambiato lepidemiologia dellhistoplasmosi.
(vedere slides di riferimento) Qui vediamo unimmagine di tipo biologico: una coltura su potato dextrose
agar nel quale si avuta la riproduzione asessuata del fungo. Guardate questi macroconidi: questi
difficilmente possono arrivare alle basse vie aeree, mentre i microconidi si.
La
coccidioidomicosi :
anche questa uninfezione respiratoria, abitualmente benigna, che si risolve
rapidamente, spontaneamente quando la carica infettante bassa. Pu provocare una malattia acuta o
cronica, talora disseminata e fatale con interessamento dei polmoni, anche se diffonde ad altri organi come
le meningi, le ossa e anche la cute e il sottocutaneo. Fondamentalmente le aree endemiche sono le zone
deserte del Sud-ovest degli Stati Uniti, anche se proprio a causa dellaumento dei viaggi nelle aree dove
presente il coccidioides sono stati descritti in letteratura casi di canadesi ed europei.
Il Coccidioides immitis nella sua forma di anamorfo e (non si comprende, potrebbe essere ambientale) un
fungo filamentoso e si riproduce formando degli artoconidi. Gli artroconidi possono essere diffusi dallaria e
inalati a livello polmonare. Per esempio il Coccidioides immitis e l histoplasma capsulatum non possono
essere tenuti in laboratorio o comunque non si possono coltivare in laboratori che sono sforniti della stanza
di classe b3 di sicurezza o della cabina chiusa, perch sono microorganismi di classe 3, in quanto tutti i
funghi dimorfi patogeni primari sono inclusi in questa classe di sicurezza. Di fatti aprire una piastra dove c
coccidioides immitis un rischio enorme, perch quella muffa che si forma nella piastra a un certo punto si
trasforma di milioni di conidi di carica infettante, dunque il rischio molto alto anche per loperatore.
Che eccezione fa il coccidioides? Nei tessuti delluomo il fungo non forma lieviti nei tessuti, ma forma
queste strutture che sono dette sferule. Queste sferule originano da un conidio, allinterno della sferula si
producono endospore e la rottura della sferula porta ogni endospora a formare una nuova sferula. Quindi
se ci fosse una elevata carica la malattia potrebbe diventare anche fatale se non riconosciuta. Questa (vedi)
limmagine di laboratorio di una coltura su vetrino a temperatura ambiente di ife che si sono trasformate
Microbiologia - Medicina e Chirurgia polo A 2012/2013 - sbobinature lezioni
90
in artroconidi . Qui potete osservare chiaramente
come questo fenomeno avvenga in maniera
alternata: una cellula si e una no, in modo che le
cellule intercalari tra due conidi possano andare in
autolisi e liberare i conidi.
La
blastomicosi:
uninfezione
cronica
granulomatosa e suppurativa delluomo e degli
animali, quindi una forma leggermente diversa.
Vedremo che si avranno pi facilmente forme di
tipo cutaneo. La malattia diffusa soprattutto tra i
maschi tra i 40 e 60 anni ed endemica nelle valli
del Mississippi , dell Ohio, con focolai anche in
altre parti degli Stati Uniti e del Canada.
Guardate questa cellula lievito particolare, a base
larga, tipica del Blastomyces dermatitidis. La via sempre quella inalatoria, per vi possono essere delle
forme cutanee sia primarie che secondarie: secondarie da disseminazione, ma vi possono essere quelle
primarie (infezioni transcutanee) che sono molto frequenti a seguito di possibile inoculazione da parte di
strutture vegetali nei quali pu trovarsi anche il fungo.
Guardiamolo dal punto di vista biologico :
1)lievito, base larga di gemmazione
2)fungo nel suo stato miceliale con la produzione di conidi, responsabili dellinfezione
La
paracoccidioidomicosi:
anche qui lo sviluppo simile a quello della blastomicosi e della
coccidioidomicosi, per il Paracoccidioides brasiliensis limitatao ad aree dellAmerica Centrale e
Meridionale.
Inoltre
determina
uninfezione polmonare inapparente,
ovvero la prima infezione in genere
sempre quella inalatoria, ma al polmone
difficilmente riusciamo ad osservare
qualcosa. Successivamente si diffonde
producendo dei granulomi ulcerativi
della mucosa della bocca, del naso e
occasionalmente del tratto gastrointestinale. Quindi queste patologie sono
viste nella fase di osservazione clinica del
naso e della bocca.
Il
paracoccidioides
brasiliensis
caratterizzato a livello tissutale da una
Microbiologia - Medicina e Chirurgia polo A 2012/2013 - sbobinature lezioni
91
caratteristica forma a ruota di timone, con la cellula centrale e gemmazioni multiple a base stretta. Quindi
rispetto allhistoplasma e al blastomyces, qui abbiamo questa gemmazione multipla che possibile vedere
ed isolare nei tessuti. Ovviamente queste sono forme che qui da noi sono difficilmente osservabili.
Domanda al professore: essendo la prima localizzazione polmonare, vi possono essere delle formazioni simil
tubercolari?
- Si, soprattutto per l histoplasma. Negli Stati Uniti uno dei primi punti che esaminano la diagnosi
differenziale tra tubercolosi e histoplasmosi attraverso uno specifico approccio diagnostico-molecolare che
permette di riconoscere rapidamente leziologia della patologia, perch se si aspetta che cresca il primo
batterio di tubercolosi o l histoplasma, che impiega in entrambi i casi pi o meno una trentina di giorni, il
paziente si aggrava molto. Altrimenti unaltra diagnosi si pu fare a livello microscopico: isolando i bacilli
acido-alcol resistenti sar di fronte ad un caso di tubercolosi; se osservo cellule lievito, non tubercolosi
sar altra infezione. Ma questa via diagnostica difficile, per cui per lhistoplasma sono stati sviluppati test
sierologici. Questo perch in queste infezioni profonde la risposta del sistema immunitario forte, infatti
per lhistoplasmosi si fa la ricerca delle precipitine su gel di agarosio. Quindi la diagnosi si basa non
sullanalisi della coltura, ma sulla risposta sierologica dellospite. Oggi con lintroduzione della diagnosi
molecolare abbiamo un ulteriore e pi rapido supporto diagnostico.
PATOGENI OPPORTUNISTI:
I patogeni opportunisti rappresentano la maggior parte dei funghi. Il primo che ho messo il pneumocystis.
Oggi non lo ritroviamo pi tra i protozoi, ma tra i funghi. Non ha pi il nome di carinii (da un biologo italiano
da cui fu dato il nome): una volta era infatti detto P. carinii s.f. (species formalis) hominis (canis, ecc),
perch inizialmente come protozoo si era visto che fosse ampiamente presente tra i mammiferi, anche
domestici, per cui si ipotizzava una circolazione tra uomo ed animali. Il nome ad esempio jirovecii deriva dal
fatto che il primo a descriverlo fu proprio Jrovec. Perch si passato da P. carinii [Link] a jirovecii?
Ora lo vedremo.
Caratterisitche del pneumocystis:
Diffusione ubiquitaria
Via di infezione respiratoria localizzazione polmonare
Possibile infezione primaria
Fattori predisponenti: immunodeficienze e AIDS
La Pneumocistosi : una di quelle patologie insieme alla criptococcosi che si diffonde ampiamente nel
paziente HIV positivo che andato incontro ad AIDS. Ma la ritroveremo anche in terapia intensiva, nel
paziente patologico e che sottoposto a trapianto, per il quale si fa profilassi e trattamento.
Un po di storia ci pu aiutare a capire questa evoluzione. Per la prima volta Chagas vide il fungo in maniera
istologica nel polmone di cavie mentre lavorava sul tripanosoma e fu chiamato: Schizotrypanum cruzi.
Invece Delano lo descrisse come un nuovo protozoo, denominandolo in onore di un italiano, Antonio
Microbiologia - Medicina e Chirurgia polo A 2012/2013 - sbobinature lezioni
92
Carini: P. carinii. Solo negli anni 80 sulla base delle tracce di DNA e su alcune caratteristiche biochimiche
stato classificato come un fungo.
Se si fa lanalisi del DNA ci rendiamo conto che le differenze nelle sequenze dellRNA ribosomiale 18 S tra P.
jirovecii, che deriva dalluomo, e P. carinii, che deriva dal ratto, la differenza almeno del 5%. Questo livello
di divergenza praticamente sufficiente a farlo proporre come una specie diversa.
Per cui il [Link] ritenuto una specie diversa dagli altri. Non bastava per un semplice esame di biologia
molecolare per dire che questa unaltra specie, ma sono state fatte delle prove biologiche che hanno dato
conferma del fatto che veramente jirovecii circoli nella popolazione umana, mentre altre specie animali
sono caratterizzate da altre specie che hanno una specificit di ospite maggiore. Verosimilmente c stato
un ceppo ancestrale unico che si adattato ed evoluto nei vari ospiti. Per cui inizialmente furono descritti
come specie P. carinii species formalis: hominis, canis ecc, poi si vide che tutto sommato vi erano le basi
biologiche e molecolari per poter dire che erano specie diverse. Quindi i vari animali presentano il fungo,
ma diverso e non con la stessa capacit di infettare luomo. La specie che interessa luomo dunque il
[Link], perch lo descrisse per primo Otto Jrovec.
Il problema che stiamo parlando di un fungo opportunista, dunque:
Lo troviamo nelle nostre vie respiratorie?
E un fungo delle vie respiratorie: mentre candida un endosaprobo, pneumocystis un commensale delle
vie
respiratorie.
Si visto che pneumocystis pu diffondersi, infettare e colonizzare luomo anche a partire dallet
pediatrica.
C una colonizzazione e una latenza permanente o transitoria?
Monitorando un soggetto nel tempo e osservando quello che avviene, di fatto c poca evidenza a sostegno
di uno stato di latenza che si prolunghi per tutta la vita, proprio grazie allintervento del sistema
immunitario. Non che non possa permanere, ma tale sistema che contribuisce a mantenerlo allo stato
di latenza. Dimostrare che esso non esiste in pratica impossibile, perch non possibile dimostrare che
questo duri per tutta la vita. Oggi si pensa che ci sia piuttosto uno scenario di colonizzazione transitoria.
Questo deriva dal fatto che andando a fare la tipizzazione molecolare dei ceppi si visto che un individuo
pu ospitare nelle sue vie respiratorie biotipi diversi. Quindi verosimilmente vi una circolazione per cui
uno stesso ceppo dura per un certo periodo, poi magari viene eliminato e il soggetto si ricolonizza. Dunque
le vie respiratorie sono sede di ricolonizzazione transitoria, se volete, di questo fungo.
Se osserviamo il P. jirovecii troviamo questo ciclo vitale: trofozoite aploide, riproduzione sessuale
trofozoite diploide e meiosi, formazione della pre-cisti e della cisti matura, che quella che vediamo nel
polmone. Noi abbiamo parlato di lieviti e di ife, qui parliamo di trofozoiti e di cisti.
Vedremo che cos come altri protozoi, questo fungo sensibile allazione del trimetoprim +
sulfametoxazolo, ovvero del Bactrim, che il farmaco per eccellenza utilizzato nella terapia per questo
fungo. Quindi a livello respiratorio possiamo avere queste forme vegetetative (abbandoniamo il termine
trofozoita e mettiamo questo) e questa forma in cisti (detta cisti per i protozooi) che potremmo chiamare
sporulativa. Qualunque sia il termine che utilizzate, la realt di un ben preciso colonizzante delle nostre
vie aeree, dimostrabile con ricerche nellespettorato sia di tipo morfologico che molecolare.
Il P. jirovecii non facilmente coltivabile. E possibile solo su colture cellulari, come facciamo per i virus, e
non nei terreni di coltura.
Microbiologia - Medicina e Chirurgia polo A 2012/2013 - sbobinature lezioni
93
Riassumendo: qui parliamo di un organismo unicellulare che va incontro a moltiplicazione per scissione
binaria, poi riproduzione sessuale e formazione del trofozoite diploide, che andr incontro al processo
meiotico con formazione di corpi intracistici maturi, che sono le spore ottenute dopo la meiosi.
Vediamo nelle immagini delle cisti a forma di tazza che derivano dalla rottura dei corpi intracistici, con
collasso della cisti stessa e assunzione di tale forma. La cisti la struttura implicata nella trasmissione da
soggetto a soggetto: cos come attraverso le goccioline di Flgge noi riusciamo a trasmettere virus,
verosimilmente diffondiamo la cisti, sempre nello stato di condensazione(?), attraverso le vie respiratorie,
perch non c altra ipotesi. Diffondiamo la cisti (chiamiamola cos), non la forma vegetativa (trofozoiti).
Avviene la colonizzazione: possibile dimostrarlo negli espettorati?
Si, negli espettorati indotti o nei bronco-aspirati andiamo a vedere queste cisti con la colorazione istologica.
A questo punto diciamo che il soggetto colonizzato, perch la presenza del fungo nellespettorato non
indica che il paziente ha la pneumocistosi, ma si sospetta la malattia quando c un certo quadro
radiologico e una certa condizione clinica. Infatti quando questo pneumocystis si moltiplica nellalveolo,
extracellulare e la moltiplicazione tale che ricopre lalveolo inducendo una sete daria nel paziente, in
quanto diminuisce la superficie di scambio per la presenza non solo del fungo, ma anche per la reazione
infiammatoria dellospite. Quindi dal punto di vista radiologico avremo un polmone con aspetto detto a
vetro smerigliato, mentre dal punto di vista clinico avremo una interstiziopatia perch una polmonite
interstiziale. Questo sar il quadro istologico con colorazione delle cisti (l impregnazione argentica
complessa, noi utilizziamo ortotolidina, sebbene abbia degli svantaggi in quanto, se il paziente colonizzato
anche da lieviti, l occhio inesperto pu confondere i lieviti con i pneumocystis), gli esami di laboratorio
invece daranno conferma della patologia.
Dato che non possibile isolare in coltura i pneumocystis , per distinguerli in generale si deve tenere in
considerazione:
-il quadro generale dei colonizzanti presenti in quel momento nellalbero respiratorio
- eventualmente fare una ricerca del DNA specifico per P. jirovecii.
Il dato dal punto di vista respiratorio questo: verosimile che nel soggetto noi possiamo trovare quantit
diverse di questo fungo, correlabili allo stato di patogenicit.
- una quantit bassa di cisti in genere correlata ad uno stato di colonizzazione
- allo stadio di sviluppo e moltiplicazione di questo fungo si avr patogenesi
Per chiudere, le forme cliniche sono:
COLONIZZAZIONE ASINTOMATICA NEGLI IMMUNOCOMPETENTI
POLMONITE AD EZIOLOGIA IGNOTA
POLMONITE EPIDEMICA IN BAMBINI DENUTRITI (descritta bene negli studi condotti sulle
conseguenze cliniche del fungo)
POLMONITE SPORADICA IN ADULTI IMMUNODEPRESSI
Nel caso dell AIDS ha localizzazione anche extra-respiratoria: grazie alle molte autopsie condotte si
ritrovato il P. jirovecii anche in altri organi.
IMPORTANTE:
Un altro aspetto interessante che il pneumocystis nella parete cistica contiene beta-1,3-glucani, e questo
uno dei motivi per cui stato avvicinato ai funghi. Tanto che la diagnosi differenziale pu fare anche
riferimento alla ricerca dellantigene beta-D-glucano cos come per gli altri funghi.
Microbiologia - Medicina e Chirurgia polo A 2012/2013 - sbobinature lezioni
94
Lezione 8
La scorsa volta ci siamo occupati dei patogeni e li abbiamo definiti primari perch in grado di dare patologie
anche nellospite immunoergico, cio normoergico dal punto di vista immunologico, un ospite sano.
Fondamentalmente sono due gruppi: il gruppo dei dermatofiti, tra i quali ci sono non solo parassiti obbligati
ma anche parassiti facoltativi, e il gruppo dei dimorfi temperatura dipendente che abbiamo definito
parassiti facoltativi perch di fatto hanno un loro ciclo vitale in natura, accidentalmente possono infettare
luomo o altri mammiferi dando luogo a patologie pi o meno gravi, e questo dipende molto dallospite.
Ora ci occupiamo degli opportunisti. Abbiamo detto allinizio, e questo il messaggio forte che io voglio
lasciare del corso di micologia, che le micosi sono essenzialmente malattie opportunistiche, quindi
chiedetevi sempre quando un paziente ha una micosi che c dietro a questo, che cosa ha il paziente,
perch questi funghi hanno sviluppato fortemente geni di adattamento, che noi definiamo anche di
virulenza perch poi riescono a causare malattie anche gravi, talvolta mortali.
PNEUMOCYSTIS
Cominciamo con una prima specie che un gruppo strano perch fino ad una decina di anni fa stato
studiato tra i protozoi ed era chiamato Pneumocystis Carini. In realt stato trasferito al regno dei funghi in
tempi recenti perch si visto che, andando ad effettuare delle analisi di biologia molecolare soprattutto
sulla parte di DNA ribosomiale di sotto s, per questo microorganismo si aveva una differenza di almeno il
5% tra il ceppo che stato isolato dalluomo e i ceppi isolati dagli animali, questo livello di divergenza tale
da poterlo considerare una specie differente. Infatti se consultiamo latlante di protozoologia medica si
vede limmagine di Pneumocystis dove mette luomo insieme a tanti altri animali perch si riteneva che
Pneumocystis fosse un protozoo che era comune a diversi mammiferi. In realt questo ora stato
modificato, riconosciuta una specificit di specie per i vari ceppi che infettano diversi animali e quindi,
per quanto riguarda luomo, si dato un nuovo nome che P. Jiroveci.
stato scoperto nel 1909 e per la prima volta lo osserv Chagas, mentre stava lavorando sul gene
tripanosoma, il quale lo chiam inizialmente Schizotrypanum Cruzi perch gli sembrava un protozoo vicino
al tripanosoma, poi nel 1914 lo descrisse come un nuovo protozoo e lo chiam P. Carini in onore di un
biologo italiano, Antonio Carini. Solo alla fine degli anni 80, sulla base delle analisi del DNA e di altre
caratteristiche biochimiche, stato riconosciuto Pneumocystis come un fungo. Nel frattempo P. Carini
veniva designato con la nomenclatura formae specialis hominis oppure formae specialis gattii, a
seconda della specie dellospite si individua questa sottospecie.
stato chiamato Jiroveci perch il primo a descrivere nelluomo un caso di Pneumocistosi, dimostrando la
presenza di questo (ancora possiamo chiamarlo protozoo) nelluomo, fu Jirovec, un cecoslovacco, ed ecco
perch stato proposto questo nome che attualmente in uso; cambiato il nome perch stato
attribuito il nome di specie alla variet isolata nelluomo e dal momento che lha descritto per primo Jirovec
hanno dato questo nome.
Quale il problema che stato posto per questo fungo? Noi osserviamo che lo isolavamo nel tratto
respiratorio anche di soggetti normali, quindi ci si chiesto se questo fungo riesce a realizzare uno stato di
latenza permanente o transitoria, se sta nellalbero respiratorio per sempre o solo per un tempo. In realt
difficile rispondere a questa domanda perch impossibile dimostrare che lo stato di latenza si prolunghi
per tutta la vita. Oggi noi riteniamo, dallanalisi dei biotipi che abbiamo potuto fare sempre nello stesso
soggetto, che in realt c circolazione interumana abbastanza ampia di questo fungo che si trasmette
come gli altri patogeni respiratori, si trasmette da uomo a uomo, e le attuali conoscenze depongono per
uno stato di colonizzazione transitoria, cio ci pu essere un periodo nel quale si pu ospitare questo fungo
senza che ci siano particolari sintomatologie. Naturalmente stiamo parlando di patogeni opportunisti e ci fu
un aumento eclatante di casi nei pazienti HIV positivi che sviluppavano queste polmoniti da P. Jiroveci, si
Microbiologia - Medicina e Chirurgia polo A 2012/2013 - sbobinature lezioni
95
conosceva la patologia ma non cera una frequenza elevata, con limmunodepressione si notato che c
stato un aumento di questa patologia.
CICLO BIOLOGICO
Il ciclo biologico quello tipico di altri protozoi, cio parliamo di un trofozoite aploide il quale si moltiplica
per fissione binaria, per copulazione da origine ad un trofozoite diploide e questo trofozoite diploide dar
luogo, attraverso il processo di meiosi, alla formazione di questi corpi intracistici che poi si troveranno
dentro questa struttura particolare detta cisti. Alla cisti attribuiamo il significato di struttura di resistenza e
di trasmissione del protozoo da un soggetto allaltro, perch le cisti nei protozoi hanno proprio questa
funzione di resistenza e nello stesso tempo di trasmissione, quando la cisti si rompe vengono liberati i
trofozoiti aploidi che continueranno il ciclo. La parete della cisti di Pneumocystis Jiroveci contiene 1-3 beta
glucani (caratteristica che usiamo nella pratica clinica) cosi come la parete del fungo. La diffusione
ubiquitaria, la via di infezione quella respiratoria, ci pu essere una possibile infezione primaria ma
soprattutto i fattori predisponenti sono limmunodeficienza e particolarmente lAIDS.
Dove fu notata questa patologia? E perch si cap subito che ci doveva essere una colonizzazione precoce?
Fu negli Stati Uniti.
Facciamo una parentesi: vediamo questo preparato che colorato con limpregnazione argentica, quindi si
vede scuro, quelle che noi vediamo sono le cisti, ma le cisti vuote perch quando la cisti si rompe si affloscia
proprio e sembra a forma di tazza. Queste altre immagini ci aiutano a capire la patogenesi della malattia,
della pneumocistosi: Pneumocystis un microorganismo che extracellulare, con la sua fase trofozoita
aderisce allo strato di epitelio alveolare e induce una risposta infiammatoria. Il risultato di questa
colonizzazione progressiva che gli alveoli si riempiono di materiale, che dato dalla risposta dellospite,
pi queste numerose cisti, il paziente comincer ad avere la cosiddetta fame daria, uno dei segni clinici
quando un paziente ha la pneumocistosi che il paziente ha difficolt respiratorie perch diminuisce la
superficie di scambio gassoso per la presenza del protozoo a livello degli alveoli polmonari.
stato ipotizzato che c una diffusione abbastanza precoce perch negli Stati Uniti fu notata in bambini
denutriti la forma clinica di pneumocistosi. A questo punto ci si posto il problema di fare una ricerca di
anticorpi verso P. e si visto che gi erano presenti nelluomo anticorpi, quindi stata fatta un ipotesi:
Pneumocystis, che oggi noi riteniamo essere un fungo, si trasmette abbastanza precocemente nella
popolazione, anche nei bambini, pu dare luogo alla risposta immunitaria, non da malattia, pu colonizzare
il soggetto per tempi anche abbastanza lunghi ma noi riteniamo che la colonizzazione sia transitoria; in
presenza di deficit dellimmunit cellulo-mediata, di immunodepressione, in particolare lAIDS ma non solo,
anche nei pazienti ematologici la vediamo spesso e a volte anche in pazienti ricoverati in terapia intensiva,
ecco in questi soggetti pu verificarsi la moltiplicazione del fungo e la manifestazione della patologia.
Mentre noi abbiamo visto le immagini di queste cisti, tanto per entrare nel merito della diagnostica, se noi
usiamo questa colorazione con limpregnazione argentica ma anche la orto-toluidina , che una buona
colorazione, pi semplice, ma quale il rischio quando noi facciamo i campioni respiratori per la ricerca di
Pneumocystis? Quando lalbero respiratorio colonizzato anche da lieviti, se quello che noi raccogliamo si
contamina di lieviti della cavit orale, nel vetrino vediamo anche i lieviti colorati e a volte occhio poco
esperto pu confondere i lieviti con Pneumocystis e la diagnosi viene un po' alterata, ma un occhio attento
sa quali sono le parti pi specifiche che deve cercare, innanzitutto perch queste cisti sono spesso ad
ammassi e poi soprattutto bisogna cercare le cisti vuote, che hanno forme particolari.
Quindi per concludere la pneumocistosi: nellospite immunocompetente c una colonizzazione
asintomatica; sulle polmoniti ad eziologia ignota qualcuno mette un punto interrogativo perch potrebbe
esserci di mezzo anche Pneumocystis, in qualche polmonite soprattutto dove con le radiografie appare
questa forma del polmone a vetro smerigliato; polmonite epidemica in bambini denutriti, questo fu proprio
Microbiologia - Medicina e Chirurgia polo A 2012/2013 - sbobinature lezioni
96
una delle prime dimostrazioni dellazione di questo fungo; polmonite sporadica in adulti immunodepressi;
localizzazione extrarespiratoria in pazienti con HIV, Pneumocystis non solo un patogeno respiratorio, ma
dal polmone pu anche localizzarsi in altre sedi, in particolare in sede cerebrale ma anche in altre.
CANDIDA
Passiamo al genere candida, che il genere pi conosciuto dai medici, non tanto come genere dal punto di
vista biologico quanto per le specie, in particolare la Candida Albicans che pi frequentemente isolata
dalluomo. Il genere comprende circa 200 specie, vivono la maggior parte da sapropri e saprofiti, quindi
sulle piante, ma alcuni hanno anche sviluppato questa caratteristica di essere endosapropri e commensali
per cui possono diventare degli opportunisti nelluomo. Limmagine che vedete quella di una cellula
lievito in cui possiamo osservare le cicatrici delle varie gemmazioni che ci sono state, perch da questi punti
sono state formate nuove cellule figlie; ricordiamoci che il meccanismo di moltiplicazione dei lieviti quello
della gemmazione, in questo caso la gemmazione multipolare perch evidente in diversi punti della
cellula, in alcuni lieviti la gemmazione pu essere unipolare, cio solo da un polo, invece Candida Albicans
multipolare. Le colonie dei lieviti assomigliano a quelle dei batteri, se guardate le colonie dei lieviti e quelle
dei batteri ci sono ovviamente delle differenze per sono abbastanza simili e sono molto diverse da quelle
delle muffe.
Nel caso del genere Candida, in particolare Candida Albicans, noi abbiamo detto che, oltre a presentarsi
come lievito, si pu presentare in forma filamentosa dando origine sia ad ife che a pseudoife, questo vale,
per quanto riguarda le ife, essenzialmente per Candida Albicans. Le pseudoife si generano a partire da
cellule lievito mediante gemmazione, ma la cellula figlia non si distacca dalla cellula madre e si allunga
formando dei filamenti che presentano costrizioni a livello delle giunzioni tra cellula e cellula. Questo lo
abbiamo detto quando abbiamo parlato del dimorfismo di Candida, quindi per C. Albicans abbiamo la
possibilit di osservare vere ife ma anche pseudoife. Le ife si originano sempre dalla cellula in fase lievito
ma consistono in un estroflessione del citoplasma della cellula madre, il tubulo germinativo, che pu
successivamente presentare setti come nei funghi filamentosi dando luogo ad una vera ifa.
Delle 200 specie circa che si conoscono del genere Candida a noi quante ne interessano in micologia
medica? Qui c un elenco sono una quindicina ma vi posso garantire che qui queste prime cinque sono
quelle che poi troviamo nella pratica clinica (le prime cinque dellelenco dovrebbero essere: Albicans,
Tropicalis, Glabrata, Parapsilosis, Krusei) e in particolare Albicans, Glabrata e Parapsilosis. Questo dipende
dalladattamento che la specie ha avuto nei confronti delluomo e quindi dalla nicchia ecologica che
occupano, per cui se C. Albicans la specie che pi si adattata alluomo, che addirittura noi definiamo un
endosaproprio perch ha come habitat lintestino delluomo e di altri animali, chiaro che la specie che
pi frequentemente incontreremo. Delle altre specie ci sono ovviamente degli adattamenti, ma le altre
specie possiamo ritrovarle anche in habitat naturali, possiamo trovarli pi facilmente nellambiente; anche
C. Albicans possiamo ritrovarla nellambiente ma perch diffusa dalluomo e da altri animali, ma non ha un
habitat nellambiente. Questo il punto importante: di tutte le specie di Candida alcune hanno la capacit
di colonizzare le mucose delluomo e allora hanno la possibilit di dare patologie opportunistiche, altre
specie invece vivono essenzialmente nellambiente esterno, possono arrivare alluomo anche con gli
alimenti o dallesterno e dare patologie, ma soprattutto in ospiti immuno-compromessi. Allora c da
chiedersi come mai C. Albicans che vive nelluomo non da malattie nellospite sano? Perch nellospite sano
pu vivere in equilibrio.
Detto questo vediamo un altro aspetto interessante. Le specie che sono pi adattate alluomo e che
incontreremo di pi nella pratica medica hanno teleomorfo non descritto, hanno perso praticamente lo
stato perfetto, perch si sono talmente adattate a vivere da commensali che non hanno pi avuto bisogno
di realizzare un ciclo biologico, come invece realizzano altre specie che hanno lo stato perfetto, quindi ci
Microbiologia - Medicina e Chirurgia polo A 2012/2013 - sbobinature lezioni
97
limitiamo a dire solo in nome dello stato imperfetto che quello di Candida seguito dal nome della specie.
C. Dubliniensis anche questa una specie che non ha lo stato perfetto descritto, una specie molto vicina a
C. Albicans.
Vediamo come queste varie specie si possono distinguere rispetto a tre aspetti: la produzione di
clamidospore, la produzione del tubulo germinativo e la formazione di pseudoife. Il tubulo germinativo
quello che la cellula fa inizialmente per formare lifa, per in laboratorio posso fare un test molto semplice:
prendo una sospensione di cellule lievito, la metto in siero bovino fetale, la tengo due ore in termostato e
vado poi a vedere al microscopio: le cellule di C. Albicans producono tubuli germinativi, e cosi anche C.
Dubliniensis produce tubuli germinativi. Quindi le uniche due specie che mi permettono di essere
differenziate con questo test sono lAlbicans e la Dubliniensis: ho un lievito isolato in laboratorio, faccio il
test del tubulo germinativo e posso subito discriminare se questo lievito una C. Albicans, o Dubliniensis, o
non lo . Stesso discorso per le clamidospore: Albicans e Dubliniensis producono clamidospore, mentre la
Tropicalis produce delle strutture simili alle clamidospore ma non uguali. Le clamidospore sono cellule di
resistenza che noi possiamo dimostrare in laboratorio facendo una microcoltura su vetrino su particolari
terreni. Le pseudoife invece possono essere fatte da tante altre specie, quindi anche la Tropicalis, la
Parapsilosis, Krusei, Dubliniensis, molte fanno pseudoife di tipo primitivo. Quindi molte specie del genere
Candida possono formare pseudoife, solo Albicans e Dubliniensis formano il tubulo germinativo, la Albicans
forma anche le vere ife.
Vediamo che impatto hanno le cose che abbiamo detto sulla patogenesi. Sulle nostre mucose ci possono
stare queste cellule lievito le quali possono andare incontro a moltiplicazione per gemmazione.
Fondamentalmente questo processo di moltiplicazione sulla mucosa pu essere tale da non causare nessun
sintomo ne segno clinico, ma tutto questo si realizza perch il nostro sistema immunitario in grado,
naturalmente innanzitutto ma poi con lo sviluppo dellimmunit acquisita, di tenere sotto controllo C.
Albicans o le altre specie che sono sulle mucose. Nel momento in cui C. Albicans va incontro al processo di
formazione del tubulo germinativo e dellifa esprime dei fattori di virulenza che sono stati studiati e che
spiegano come mai avviene non solo linvasione dei tessuti ma anche la malattia che data dallalterazione
dei tessuti. Il tubulo germinativo esprime molte proteine che sono state dimostrate essere implicate
fortemente nella patogenesi creando dei mutanti. Abbiamo preso dei ceppi, abbiamo deleto alcuni geni,
che sono quelli che codificano per quelle proteine, e abbiamo visto che la loro patogenicit, la loro
virulenza ridotta, come stato visto su modelli fatti da cellule viventi, cellule endoteliali, epiteliali e cosi
via. Se il tubulo germinativo di C. produce maggiori adesine, produce maggiori proteasi ha per sua
caratteristica la maggiore capacit di invasione, non c dubbio che la partizione lievito-ifa il momento nel
quale la C. Albicans passa dallo stato di commensale a quello di parassita. Ecco quello che avviene quando
in un soggetto noi osserviamo una candidosi, se volete superficiale intesa delle mucose (la vaginite da
candida, una candidosi cutanea), quando osserviamo queste patologie di fatto li avvenuto che si passato
dallo stato di commensalismo a quello di parassitismo. Allora per C. Albicans il dimorfismo
importantissimo, tanto che se dobbiamo fare diagnosi di laboratorio della malattia facciamo sempre
osservazioni microscopiche perch losservazione di ife, pseudoife diagnostica, non basta isolare cellule o
colonie di lievito dalla cavit orale, non serve a niente isolare la Candida perch a livello della cavit orale
essa pu stare tranquillamente da commensale, invece importante andare a vedere in quale stato io
osservo le nostre cellule, se sono solo cellule lievito, sono poche, sono molte, se ci sono ife, pseudoife,
questo importante. Quindi il dimorfismo nel caso di C. Albicans un aspetto molto importante e
addirittura i cambiamenti che avvengono nella composizione antigenica della parete cellulare danno
sicuramente un qualcosa in pi riguardo al sistema immunitario. Studi recenti hanno dimostrato che il
tubulo germinativo un fattore importante di immuno-evasione in quanto ostacola lacquisizione di una
Microbiologia - Medicina e Chirurgia polo A 2012/2013 - sbobinature lezioni
98
risposta di tipo TH1, quindi di fatto il dimorfismo di C. tale da interferire anche con la risposta
immunitaria.
Dal punto di vista immunologico sono stati fatti tanti studi che hanno spiegato che cosa avviene
nellinterazione fungo-ospite al punto tale da dire, durante un seminario, che la malattia non la fa il fungo
ma la fa lospite. In una situazione nella quale io non posso oggi non dire che C. Albicans si estremamente
adattata alluomo e altri mammiferi, per cui un fatto naturale che noi vediamo colonizzarsi, in teoria non
c persona che nella sua vita non venga colonizzata da C. Albicans, la nostra evoluzione ci ha portati ad
affermare unimmunit innata, che gi in grado di riconoscere il fungo, e un immunit acquisita che in
grado di regolare tutto questo processo, che fondamentalmente il processo dellinfiammazione, per cui il
problema della patologia legato essenzialmente alla rottura di questo equilibrio. Allora, quando
linterazione tra funghi e sistema immunitario va verso lattivazione della linea TH1 del T regulator in realt
il nostro organismo realizza una tolleranza protettiva, non c infiammazione e non avremo malattia,
quando invece la risposta si orienta verso la risposta del tipo TH2 avremo linfiammazione e quindi la
malattia. La candidosi una malattia opportunistica, sia nella sua forma superficiale, cio delle mucose, sia
nella sua forma profonda; sempre dovuta a fattori che la predispongono, sia nel soggetto genetico sia
anche di tipo iatrogeno a volte.
ENZIMI PROTEOLITICI
Della secrezione degli enzimi proteolitici ne abbiamo parlato in passato, in particolare la aspartyl proteasi
stata dimostrata fondamentale per lespressione della patogenicit: mutanti in cui sono stati deleti i geni
che codificano per questa aspartyl proteasi non danno malattia per esempio nel topo. Ma un altro aspetto
clinico che possiamo ricordare che lintroduzione della nuova terapia antivirale, che fa uso degli inibitori
delle proteasi, ci ha fatto meravigliare perch di colpo si sono ridotte le candidosi in questi soggetti. Ci sono
due ipotesi: una perch abbattendo la carica virale e ripristinando il sistema immunitario la candidosi si
risolve da s; laltra perch probabilmente c anche leffetto di questi inibitori sulle proteasi di C., se noi
inibiamo la produzione delle proteasi ovviamente blocchiamo lespressione della virulenza di C. e questo
stato ampiamente dimostrato. Quindi inibendo anche la transizione lievito-ifa otteniamo lo stesso risultato,
non uccidendo le cellule perch c una differenza, io non debbo eliminare il fungo ma debbo impedire che
il fungo attui la transizione lievito-ifa, commensale-parassita, ed diverso anche dal punto di vista
terapeutico.
Un altro fenomeno che legato a C. Albicans il cosiddetto switching. Questo esperimento nel quale sono
state viste colonie di C. bianca e colonie di C. opache, ecco perch stato chiamato bianco-opaco,
riguardava il fatto che a partire dallo stesso clone ottenevamo colonie differenti, questo fenomeno
morfologico, che osservabile in vitro, stato chiamato switching, commutatore. Di fatto che cosa
avviene? Ci sono in C. Albicans dei tratti del DNA in cui ci sono questi geni che controllano una serie di altri
geni, non solo in posizione cis ma anche in posizione trans nel cromosoma, quindi come se avvenisse ad
un certo punto che C. Albicans da un morfotipo ne fa un altro ma non lievito-ifa, resta sempre cellula lievito
nello switching, solo che la cellula invece di essere pi globosa diventa pi allungata, la colonia invece di
essere bianca diventa opaca e studiandoci sopra si visto che cambia anche lassetto antigenico della
parete cellulare che si modifica. In fondo si visto che con questo fenomeno dello switching C. Albicans in
grado di resistere ad alcuni antimicotici, allazione dei macrofagi, cio un meccanismo con il quale C. si
adatta per permanere nei tessuti dellospite, quindi verosimilmente questo fenomeno di switching, con cui
cambia il suo assetto, un fenomeno di adattamento e noi ci spieghiamo il perch nello stesso soggetto
permane lo stesso biotipo di C., perch sicuramente c una capacit di C. Albicans di cambiare la sua
struttura tale da favorire il suo adattamento alle diverse situazioni. Noi in vitro lo osserviamo con questa
variazione di colore: se io prendo una colonia opaca si vedr che da queste cresceranno anche delle colonie
Microbiologia - Medicina e Chirurgia polo A 2012/2013 - sbobinature lezioni
99
bianche, se io prendo le cellule di una colonia bianca, faccio una sospensione e rimetto nelle piastre, dalle
colonie bianche verranno fuori delle colonie opache, questa la dimostrazione di questo fenomeno di
switching.
TOSSINE
Per quanto riguarda le tossine c da dire che quando c per esempio una candidosi disseminata, una
sepsi, spesso questa indistinguibile da quella dei gram negativi, cio componenti della parete cellulare di
C. Albicans svolgono unazione simile a quella delle endotossine dei gram negativi, sapete che nei gram
negativi hanno molta importanza le endotossine cio le componenti del batterio soprattutto della
membrana lipopolisaccarica. Anche per C. si visto questo aspetto quindi si ritiene che componenti della
parete di C. agiscono esattamente come le tossine dei batteri gram negativi.
Infine per quanto riguarda sempre la patogenesi di C. importanti sono le mannoproteine (ne avevamo
parlato quando abbiamo parlato della parete cellulare) per gli effetti che hanno sul sistema immunitario e
alcuni recettori per il complemento, che sono anche questi molto importanti per consentire a C. di poter
permanere nei nostri tessuti, e il biofilm laltro aspetto abbastanza importante che si visto correlato a
una pi elevata mortalit nei pazienti che hanno biofilm, quindi C. Albicans in particolare esprime la sua
patogenicit attraverso questi meccanismi.
Che tipo di malattie possono dare? Quali localizzazioni possono avere le candidosi? Ci sono a partire da
quelle superficiali, la cutanea, le unghie, le oligomicosi da candida, le pliche cutanee, la vaginite, lesofagite,
lapparato urinario, fegato, polmone, occhio, milza, circolo, endocardite, meningite. Quelle che
osserveremo pi frequentemente sono quelle che chiamiamo superficiali, cutanee e delle mucose; quelle
profonde sono di particolari soggetti, le candidemie, le setticemie da candida sono nei pazienti critici di
terapia intensiva, pazienti chirurgici che possono andare incontro a queste forme.
CRYPTOCOCCUS
Altro genere il genere Cryptococcus che nel suo stato imperfetto contiene una sola specie patogena che
la Cryptococcus Neoformans, c la variet Neoformans, la variet Gattii. In realt del Cryptococcus si
conosceva prima solo questo stato di anamorfo, di lievito. Qui vedete questa immagine nella quale
possibile cogliere questa grande capsula mucopolisaccaridica, oltre che la cellula lievito, nei campioni clinici
che noi otteniamo dal paziente, nel liquor, nelle urine, dalla cute possiamo osservare questa capsula
mucopolisaccaridica che contraddistingue il C. Neoformans. Di questo lievito avendo la capsula si sono fatti
dei sieri per distinguere i sierotipi e di fatto avevamo individuato il sierotipo A, B, C, D e AD,
fondamentalmente tutte queste variet venivano in un certo senso studiate attraverso la sierotipizzazione.
Si visto che il C. diffuso dai piccioni che con le loro feci lasciano nel suolo queste cellule lievito, mentre
unaltra scoperta importante stata quella dellhabitat costituito dagli alberi, in particolare gli alberi di
eucalipto, nei quali stato visto lo stato perfetto. Lo stato perfetto, cio Filobasidiella Neoformans fu
scoperto negli anni 70 da un gruppo americano e hanno potuto dimostrare che questo criptococco era un
basidiomicete, avevano visto le ife, cio si erano resi conto che C. aveva uno stato perfetto e questo poi
stato trovato in natura.
Fondamentalmente il genere C. ha uno stato imperfetto che lievito, uno stato perfetto che sono funghi
filamentosi e che sono basidiomiceti, ma lo stesso fungo, la stessa specie. Quando i lieviti vengono
abbandonati con le feci nel suolo in realt la cellula lievito per un certo tempo pu moltiplicarsi utilizzando
come sorgente nutritiva le stesse feci. Pensate che il C. produce ureasi, e lurea molto presente nelle feci,
pu utilizzare la creatinina, la cheratina, cio ha tutto un pacchetto di enzimi in grado di utilizzare queste
fonti azotate, quindi fin quando c nutrimento si pu moltiplicare, quando finisce il nutrimento, o quando
Microbiologia - Medicina e Chirurgia polo A 2012/2013 - sbobinature lezioni
100
diminuisce lacqua e quindi si asciuga, il C. si trasforma in cellule lievito molto piccole nelle quali produce
nella parete cellulare melanina per difendersi dai raggi ultravioletti.
Quindi queste cellule vivono nel suolo in dimensioni piccole, intorno ai 3 micron compatibili con le nostre
vie aeree, in uno stato di metabolismo inerte, cio non hanno attivit metabolica, in uno stato di resistenza.
Ma come arrivano alle vie aeree? Prima di tutto i piccioni che beccano a terra possono portarlo dentro il
loro intestino e l il C. pu moltiplicarsi e arriva alluomo, o a altri animali, per via respiratoria, cio quando
si solleva la polvere e c vento queste cellule, che sono piccole, sono disperse e questo stato dimostrato:
abbiamo isolato dallaria con degli appositi campionatori delle colonie di C. Neoformans nelle aeree in cui
questo presente in giorni in cui cera sufficiente vento da far sollevare queste cellule. C un altro
meccanismo perch il fungo presente anche sugli alberi e produce basidiospore che sono molto piccole e
hanno un ruolo nellinfezione perch da quelle basidiospore si origina il C., sempre C. Neoformans solo
che nello stato perfetto fa fungo filamentoso, nello stato imperfetto fa lieviti. Allora se noi andiamo a
vedere questa tabella (che stata presa dal sito dottor fungus) vedete che dal punto di vista della sorgente
ambientale sono citati: suoli contaminati dalle feci, dei piccioni in particolare, e gli alberi di eucalipto, ma
anche altri alberi. Si sta facendo una ricerca in Europa sulla variet Gattii perch questa variet si dice che
presente nelle zone tropicali e subtropicali, e tutto sommato noi non ci rientriamo perch non stata fatta
una ricerca attenta, quindi partita una grande ricerca a livello europeo, soprattutto nellarea
mediterranea. Ma guardate i sierotipi: sierotipo D quello Neoformans variet Neoformans, sierotipo A
Neoformans variet Grubii, B e C Neoformans variet Gattii, quindi i sierotipi distinguevano gi queste tre
variet, ma laspetto pi importante questo: mentre le variet Neoformans e Grubii sono state osservate
solo in ospiti immunocompromessi, per la variet Gattii sono state dimostrate patologie in ospiti
immunocompententi ed per questo che si sta facendo questa ricerca perch si rimasti colpiti, la
criptococcosi ha seguito esattamente la diffusione dellAIDS, perch il fungo cera ma non cerano i pazienti
immunocompromessi, se oggi lo osserviamo nei trapiantati significa che il fungo c stato sempre, non
cerano questi ospiti immunodepressi che sviluppano la criptococcosi. Adesso la situazione attuale per
quanto riguarda la criptococcosi questa: abbiamo preso le variet, si sono fatti degli studi molecolari e si
arrivati ad una proposta che quella attuale cio le due variet Grubii e Neoformans in realt sono variet
di una stessa specie che nello stato anamorfo detto Cryptococcus Neoformans, nel suo stato di
teleomorfo detto Filobasidiella Neoformans; per quanto riguarda la variet Gattii parliamo di
Cryptococcus Gattii come anamorfo e Filobasidiella Basidiospora come teleomorfo, il resto lo abbiamo
detto riguardo la distribuzione geografica e la possibilit di coinvolgere ospiti immunocompetenti per cui si
ritiene che questo Cryptococcus Gattii possa essere considerato anche un patogeno primario. Questa
lattuale situazione, quindi la variet Gattii stata elevata al rango di specie.
Linfezione si contrae per via respiratoria, in genere a livello respiratorio subacuta, pu essere anche
disseminazione ematica. I casi di polmonite o interessamento polmonare da criptococco sono stati visti solo
per alcuni malati di AIDS perch i casi che si sono avuti nei trapiantati non sono stati dimostrati quando
cera linfezione polmonare, si sono visti in questa fase cio quando il criptococco dissemina e si localizza a
livello cutaneo, ma il criptococco era gi arrivato nel paziente al polmone e non si vede, non ci sono segni
clinici n radiologici, quindi bisogna inquadrare il paziente, sapere che a rischio e fare unanamnesi pi
attenta e magari poi fare delle ricerche. Ci accorgiamo della criptococcosi o nella forma cutanea o quando il
paziente ha la meningite ma il criptococco arriva certamente come prima sede di localizzazione a livello
polmonare; ovviamente la disseminazione non riguarda solo la cute, si trova anche nelle urine, e le forme
cliniche possono essere varie, a volte il paziente ha la disseminazione ma non ha la meningite.
FATTORI DI VIRULENZA:
Microbiologia - Medicina e Chirurgia polo A 2012/2013 - sbobinature lezioni
101
La capsula, il glucuronoxilomannano, molto importante: ceppi acapsulati non danno malattie
nellanimale, quindi mutanti che non producono la capsula non danno patologia.
La fenolossidasi, enzima molto importante perch quello che sta alla base della produzione della
melanina e che ci spiega il tropismo del criptococco per il sistema nervoso, dove sono molti i metaboliti
utilizzabili dal criptococco, il tropismo che ha il criptococco per le meningi, e possiamo avere anche
localizzazione encefalica che dovuta proprio a questo.
La produzione di D mannitolo.
Non sempre alla prima infezione si ha leradicazione del fungo, cio in genere inalando criptococco lazione
dei macrofagi tale da eliminare tutto, ma pu succedere che si pu avere uno stato di latenza che
permette al fungo di restare a livello dei tessuti e indurre la produzione di anticorpi. Questo fatto della
latenza, esattamente come i dimorfi temperatura dipendente, significa che possiamo contrarre linfezione
anche qualche anno prima, non ci accorgiamo perch non si hanno patologie ma a livello polmonare si
hanno delle localizzazioni latenti di criptococco, se lospite va incontro a immunodepressione potr
sviluppare la criptococcosi. Quindi oltre ai dimorfi temperatura dipendente, che danno questa forma di
localizzazione, anche C. Neoformans produce questo stato di infezione latente per cui una
immunodepressione pu riattivarlo.
MALASSEZIA
Il genere Malassezia lo abbiamo incontrato quando abbiamo parlato dei commensali, in realt la Malassezia
Furfur un lievito dimorfo quindi produce anche ife, non temperatura dipendente, lipofilo e pu
causare malattie in relazione a particolari condizioni predisponenti dellospite. Si diffonde da persona a
persona, direttamente o indirettamente, ma molto importante la predisposizione individuale.
Fondamentalmente Malassezia presente in una certa percentuale che pu variare da un 30% a 60% della
popolazione a seconda delle caratteristiche della popolazione.
Perch si sottolinea questo aspetto della recettivit dellospite? Perch nella pratica clinica si possono
incontrare delle persone che stanno tra di loro a contatto fisico nei quali una magari va incontro per
esempio a una forma di quella patologia, che pi che patologia un fatto estetico, comunemente
conosciuta come funghi di mare, laltro invece niente, non neanche colonizzato. Questo significa che
certamente le caratteristiche della cute, riguardanti la sudorazione, il microbiota, tutto un insieme di fattori
che interessano la cute, sono tali da non rendere recettivo quel soggetto al commensalismo mentre altri lo
sono. Fondamentalmente essendo un lipofilo vive soprattutto nelle zone ricche di ghiandole sebacee, nei
follicoli piliferi.
Le specie del genere Malassezia colonizzano non solo luomo ma anche gli animali, alcune specie le
condividiamo con gli animali, altre specie sono strettamente zoofile, legate agli animali. Si conoscono 11-12
specie e dobbiamo ricordare che sono funghi lipofili che si localizzano a livello della cute e che sono dimorfi.
Quando si ha un paziente che ha delle lesioni, cio delle discromie o ipocromiche o ipercromiche, in questo
caso si osservano delle ife, in genere la presenza di ife indicativa dello stato dellattivit di virulentazione
del fungo. Lazione patogena sicuramente mediata dalla perossidazione dei lipidi, questo uno dei pi
importanti meccanismi patogenetici, e si vanno a formare dei composti che agiscono sulla melanogenesi,
sui melanociti e quindi si hanno le aree discromiche, abbiamo le famose aree chiare, ipocromiche.
Nellospite colonizzato non vedr ife, vedr qualche cellula del lievito di Malassezia, colonizzato quindi
solo commensalismo, ma nellospite in cui invece c una patologia che riferibile a Malassezia osserver
sia cellule lievito sia ife. Ma Malassezia pu dare anche patologie profonde sempre da opportunista, i primi
casi di localizzazione polmonare in bambini che sono deceduti sono stati dimostrati negli Stati Uniti in
terapia intensiva neonatale perch si era contaminato il sistema di alimentazione. Se abbiamo un substrato
Microbiologia - Medicina e Chirurgia polo A 2012/2013 - sbobinature lezioni
102
nel quale Malassezia cresce bene, essendo un fingo lipofilo, e si contamina se Malassezia entra attraverso la
vena o un catetere venoso centrale nellorganismo pu causare patologie anche a livello profondo, infatti
allautopsia hanno dimostrato a livello polmonare la presenza di Malassezia. Quindi ricordiamoci che
Malassezia un commensale della cute, occupa le aree in cui ci sono le ghiandole sebacee, nei terreni di
coltura lattivit enzimatica chiarifica il terreno perch gli enzimi prodotti dal fungo metabolizzano le
sostanze lipidiche che ci sono nel terreno, ha bisogno di terreni lipidici, lunica specie che non lipofila e
che non dipende da acidi grassi, almeno a 12 atomi di C, la Malassezia Pachydermatis.
C una tabella in cui sono elencate tutte le specie di Malassezia e sono indicati alcuni parametri di
laboratorio interessanti, per esempio la temperatura di crescita: a 32 crescono tutte le specie, alcune non
crescono a 37, molte altre non crescono a 40, questo per dire che ladattamento alla cute delluomo o
dellanimale stato tale da favorire questa temperatura ottimale di crescita di 32. Sono riportati anche i
partner di assimilazione ai vari tween, il tween un composto in cui c un acido grasso, il fungo libera
lacido grasso e utilizza questi acidi grassi, quindi si fanno le prove di assimilazione con i tween per
distinguere le varie specie e poi altre prove come la catalasi, ma lo studio di queste specie pi che dal punto
di vista fenotipico stato fatto dal punto di vista genotipico.
Di tutte queste specie quelle che pi frequentemente troviamo nelluomo sono: la Furfur, la Globosa,
qualche volta la Sympodialis, ma dipende dalle aree geografiche; alcune specie sono strettamente zoofile,
per esempio Malassezia Caprae. La Pachydermatis lunica specie che non lipofila, cresce anche nei
terreni normali. Ma se si vuole isolare Malassezia e non si usa un terreno lipofilo non si potr mai isolare in
laboratorio, quindi questo un aspetto importante della diagnostica, quando noi sospettiamo che c una
presenza di Malassezia dobbiamo utilizzare terreni lipofili per poterla isolare.
La cosa importante che ci sono le forme cutanee e la possibilit di contaminare i cateteri, quando c la
nutrizione mediante fonti lipidiche nelle quali Malassezia pu moltiplicarsi se arriva in circolo pu dare
patologie legate a contaminazioni da cateteri, ma non c nel fungo la capacit di passare dalla cute in
circolo, deve arrivare per le vie iatrogene.
Una precisazione: io vi ho presentato i lieviti come blastomiceti nel loro stato di anamorfo, ma sappiate che
Pneumocystis e Candida sono ascomiceti; Cryptococcus, Malassezia e Trichosporon sono basidiomiceti.
TRICHOSPORON
Qui vedete la classica immagine di una pietra bianca, cio di questa infezione del pelo da parte del fungo
senza nessun interessamento del sistema immunitario, questa infezione assolutamente asintomatica
perch la cheratina del pelo che viene attaccata da questo fungo che va a formare questi noduli e diventa
un problema estetico. Queste sono forme superficiali ma in realt il Trichosporon un genere abbastanza
importante perch un dimorfo, pu formare delle ife e moltiplicarsi. Il Trichosporon lo troviamo
interessato in alcune patologie cutanee, ad esempio la specie Asahii, ma questi funghi possono diventare
degli opportunisti e dare luogo a infezioni invasive, che sono state descritte, e certamente la loro frequenza
molto pi bassa di quelle che troviamo per Candida. Sono forme rare dal punto di vista invasivo mentre
dal punto di vista cutaneo si trova nella popolazione, essenzialmente Trichosporon stato visto nella forma
invasiva in pazienti ematologici. Potrebbe esistere uno stato di commensalismo di T. sulla cute, sulle
unghie, ma non come quello di Malassezia perch Malassezia quasi obbligato essendo lipofila, e a livello
cutaneo e delle unghie causa patologie ad esempio a livello del pelo causa la pietra bianca.
Microbiologia - Medicina e Chirurgia polo A 2012/2013 - sbobinature lezioni
103
Lezione 9
Anche oggi ci occupiamo di funghi opportunisti, essenzialmente dei filamentosi, in particolare degli
zigomiceti, che appartengono al filum zigomigota, i pi primitivi come funghi. Hanno un micelio
scarsamente settato e si riproducono asessualmente, mediante la produzione di sporangioconidi, dentro di
sporangi; oppure mediante riproduzione sessuata con le zigospore, o zigosporangio.
Gli zigomiceti, sono i funghi per i quali si sente pi parlare di zigospore, anche per quelli che dovrebbero
essere meglio definiti sporangioconidi (secondo il professore).
I gruppi di maggiore interesse degli zigomiceti, per la micologia medica sono due:
Mucorales, hanno crescita rapida, micelio eretto con colonie cotonose o fibrose.
Entomophtorales, colonie con aspetto cereo; formano conidi primari e secondari.
Pur appartenendo allo stesso filum sono molto differenti, per morfologia e riproduzione, ma soprattutto
per l'aspetto patogenetico, che quello che maggiormente ci interessa.
Alcuni generi dei mucorales, sono cosmopoliti (mucor, rhizopus, rhizomucor); altri sono tropicali, come la
Cunninghamella, di cui per stato individuato un caso a Taranto.
Gli entomophtorales invece hanno localizzazione decisamente tropicale, difficilmente si vedranno qui, loro
infezioni.
CICLO BIOLOGICO
Microbiologia - Medicina e Chirurgia polo A 2012/2013 - sbobinature lezioni
104
Quello nell'immagine il ciclo vitale dello Rhizopus Stolonifer, riportato con due tipi maritali, perch una
specie eterotallica e presenta un tipo maritale ed un tipo maritale +.
Per le specie eterotalliche, che devono riprodursi, necessario l'incontro di due ceppi con tipo maritale
diverso; ed quello che avviene qua. Nel momento in cui dalle ife, che fungono da sospensori, si formano
strutture dette gametangi, necessariamente deve esserci un setto, perch ci sar una cellula con un nucleo
aploide. Per quanto, normalmente, gli zigomiceti non abbiano setti, ma ife gametogeniche, in alcuni
momenti, vengono formati i setti. Uno dei momenti questo, quando si incontrano cellule provenienti da
tipi maritali diversi, che danno origine allo zigosporangio o zigospora, che sar diploide. Quando questa
comincia a germinare, avviene la meiosi e la produzione dello sporangio, all'interno del quale si formano le
sporangiospore aploidi, dalle quali originano i tipi
maritali, che si riprodurranno frequentemente con
riproduzione asessuale, mediante sporangioconidi
che si formano con processo mitotico. Queste
strutture sono assolutamente tipiche degli
zigomiceti e non si incontreranno per altri miceti.
Lo sporangio, pu essere colorato, ed supportato
da una columella, che ha forme diverse; pu
esserci invece un'apophysis, che una forma
tronca delle appendici. In alcuni zigomiceti pu
formassi il merosporangio, dal quale partono
estroflessioni dove si trovano i conidi; in altri casi
gli sporangioli. Possono anche formarsi
clamidospore, cellule a parete pi spessa,
considerate cellule di resistenza, che possono
essere considerarsi cellule dalle quali pu
riformarsi il micelio. In conclusione le
sporangiospore, derivano da un processo meiotico;
gli sporangioconidi da processi mitotici. I
meccanismi di riproduzione sono ad elevata efficienza.
MUCORALES
Sono per lo pi saprofiti ed ubiquitari; alcune specie contaminano gli alimenti (muffa del pane), altre
possono causare malattie negli animali e nell'uomo. L'infezione avviene, per lo pi, per via respiratoria,
anche se possono avvenire per via cutanea (legata soprattutto agli ustionati, che hanno la cute come
tessuto organico alterato) o per via gastrointestinale (legata all'ingestione di alimenti infettati da
zigomiceti). Non possibile osservare un'infezione da mucorales in un soggetto sano e normale, infatti i
soggetti a rischio sono gli immunocompromessi (leucemici, trapiantati, ma mancano i pazienti affetti da
HIV), i diabetici (soprattutto il diabete scompensato che porta a chetoacidosi, un fattore di rischio per
infezioni rinocerebrali) ed infine i tossicodipendenti (inoculazione il circolo ematico di conidi. Spesso la
droga tagliata con certe polveri, favorisce la localizzazione di spore fungine, che una volta inoculate nel
torrente circolatorio, danno origine ad infezioni molto gravi).
Esistono fattori predisponenti per le mucomicosi sono: l'uso di corticosteroidi e antibiotici ad ampio spettro
e il sovradosaggio di ferro. La localizzazione rinocerebrale, prima fra tutte: fin quando l'infezione resta in
ambiente rinosinusale ancora controllabile e contrastabile, ma se passa a livello cerebrale, il paziente
rischia la morte. Nel diabete, le aree di necrosi a livello delle vie nasali, possono avere eziologia fungina e
Microbiologia - Medicina e Chirurgia polo A 2012/2013 - sbobinature lezioni
105
soprattutto da mucorales, perch sono miceti molto diffusi nell'ambiente. L'infezione pu anche localizzarsi
a livello polmonare e gastrointestinale.
Nei soggetti normoergici possono esserci forme allergiche e forme cutanee, per gli ustionati, e pu esserci
qualche caso di onicomicosi rare da Mucor circinelloides.
Patogenesi. Alcuni hanno un tropismo vascolare e nel momento in cui riescono a penetrare nei tessuti, le
ife si muovono verso i capillari, provocano un'ostruzione, una trombosi che porta ad ischemia, infarto e
necrosi del tessuto colpito. Nelle autopsie o nei prelievi bioptici possibile vedere in sezione, le ife che
infarciscono i vasi, a seguito dell'angioinvasione. Molto del meccanismo patogenetico, dipende dalla
produzione di enzimi per la penetrazione e dalle tossine prodotte dai funghi.
ENTOMOPHTORALES
Sono ampiamente distribuiti, ma endemici nei climi tropicali; sono saprofiti, saprobi e parassiti di animale.
Esistono due sole specie eziologiche nell'uomo:
Basidiobuls ranarum
Conidiobuls coronatum
Queste specie, hanno una riproduzione asessuale differente dalle mucorales: gli sporangiofori con
dilatazione subterminale e sporangioli terminali, globosi o piriformi, producono un conidio detto anche
spora singola. Ma in ogni caso, anche questi produrranno zigospore, mediante meiosi.
Per il Basidiobuls ranarum l'infezione sottocutanea e pu essere interessato anche il soggetto
normoergici, oltre che diabetici. In genere il fungo arriva per impianto traumatico, causato da una spina,
una siringa o una puntura d'insetto e a livello sottocutanea da origine ad una micosi tipica. Esistono anche
rari casi di infezione polmonare e gastrointestinale. La micosi dei tessuti profondi, caratterizzata da
infiltrati infiammatori acuti e cronici, senza invasione dei vasi o tessuti adiacenti; ha decorso cronico e
spesso si interviene con la chirurgia per eliminare il fungo, dato che non esistono molti farmaci per
combattere questa infezione.
Il Conidiobuls coronatum detto cos per la sua morfologia, caratterizzata da una serie di appendici e
microvilli, che sembrano formare una corona. I conidiofori sono semplici, corti ed aderenti e le modalit di
riproduzione asessuale sono differenti. Pu dare luogo ad infezioni sottocutanee, ma interessata pi la via
aerea: l'infezione origina a seguito dell'inalazione di conidi, e la patogenesi comincia nella mucosa nasale,
spesso si ha sinusite cronica e la micosi pu verificarsi nei soggetti normoergici, ma molti casi sono presenti
nei cocainomani e negli immunocompromessi, c' un'elevata possibilit di angioinvasione. La micosi da
origine a lesioni granulomatosi e invasione si ha con produzione di lipasi e proteasi maggiore dei ceppi
saprofiti.
Quindi gli entomophtorales, danno origini ad infezioni sottocutanee, se impiantati mediante evento
traumatico, oppure infezioni aeree, se inalati, che per gli entomophtorales danno origini a lesione alle
mucose. Da ricordare che i mucorales sono cosmopoliti, mentre gli entomophtorales sono tipici dei climi
tropicali. I farmaci contro gli zigomiceti sono pochissimi, appena due, e neanche sempre efficienti.
Lasciando gli zigomiceti, passiamo ad altri funghi filamentosi, nell'ambito dei funghi imperfetti o
deuteromiceti, parleremo dell'Aspergillus, del genere fusarium, e del Pennicillum Manneffei, per
concludere con le micosi sottocutanee.
ASPERGILLUS
Microbiologia - Medicina e Chirurgia polo A 2012/2013 - sbobinature lezioni
106
Ha un habitat ambientale, un patogeno opportunista nell'ospite compromesso, ma abbiamo efficaci
difese ambientali. La caratteristica che gli ha permesso si affermarsi quella di avere una riproduzione
asessuata molto efficiente, e di disperdere attraverso l'aria i conidi, i suoi propaguli riproduttivi, che
colonizzano alimenti e le vie aeree e tessuti del corpo.
Il ciclo biologico dell'aspergillus: c' una fase di riproduzione del conidio, che una fase asessuale;
formazione delle ife e produzione di conidospore e conidi. A
volte basta pochissima sostanza organica e di umidit in una
parete per dare origine ad una colonizzazione, in cui si vedr
il fungo con migliaia di teste conidiali, con milioni di conidi
che possono essere dispersi nell'aria. Basta pochissimo quindi
per amplificare enormemente la quantit di conidi nell'aria.
Per quanto riguarda la riproduzione sessuata (non entreremo
nel dettaglio) tipica di un ascomicete, che produce
ascospore, contenute in un asco; questo, nell'aspergillus, non
libero ma all'interno del cleistotecio. Esiste quindi
l'aspergillus si trova nel filum degli deuteromiceti,
l'aspergillus nel filum degli ascomiceti, ed una serie di altri
generi che rappresentano le forme perfette di aspergillus,
come emericella, neosartorya e fennellia.
L'habitat ideale dell'aspergillus, rappresentato da sostanza
organica, animali, legna, formaggi e frequentemente nella
polvere, e spesso dove l'aria viene filtrata; quindi nel
momento in cui si voglio cercare eventuali colonie, bisogna
controllare bene l'ambiente perch spesso si accumula nella
polvere e nello sporco. Una particolarit di una specie che il
fumigatus, quella di riuscire a crescere anche a
temperature superiori a 50 C, ed definito come termofilo.
Se si osserva un aspergillus al microscopio si osservano tutti i conidi, ma se si schiaccia, i conidi si
disperdono ed possibile vere l'ifa. Lungo l'ifa avviene il differenziamento di una cellula, che una cellula
basale e da questa, si produce uno stipite o conidioforo che finisce in una vescicola con una o due file di
cellule. Se la fila una di parla di fialidi, o cellule conidiogene; se le file sono due: quella profonda e data da
medule e quella superficiale da fialidi. Dalle fialidi si producono, con meccanismo basipetalo, i conidi, per
cui si avranno conidi blastici. (questo quello che riguarda la riproduzione asessuale).
Se si osserva invece la riproduzione sessuale si vedr sia cleistotecio che i conidi, perch alcuni aspergilli
sono omeotallici e sono in grado di dare origine ad entrambi i tipi maritali che potranno portare avanti una
riproduzione sessuata. Trovare i cleistoteci importante per la microbiologia.
Si conoscono 250 specie di Aspergilli, 40 di queste riportate come agenti eziologici di aspergillosi, ma le pi
frequenti sono: A. fumigatus, A. flavus, A. niger, A. terreus, di cui fumigatus, flavus e terreus inseriti nella
classe BSL 2 (cio possibile lavorare con questi funghi solo in cabile isolate con flusso bilaminare di classe
2).
nel genere aspergillus, alcune specie diverse hanno un anamorfo molto simile, per cui morfologicamente
sono indistinguibili, senza tecniche genetiche molecolari, i cui risultati vanno integrati con le sezioni. Quelle
che vengono dette sezioni (una volta erano i gruppi), sono il livello cui si pu arrivare, basandosi
sull'aspetto macroscopico della colonia e su quello microscopico della conidiogenesi. Ad esempio all'interno
Microbiologia - Medicina e Chirurgia polo A 2012/2013 - sbobinature lezioni
107
della sezione fumigati, ci sono molte specie diverse dal Fumigatus, che non possono essere distinte senza
analisi molecolare.
Per l'identificazione delle specie, molto utile stata anche la spettrografia di massa, che ha consentito di
mettere su degli strumenti in grado di identificare batteri, lieviti ed anche funghi filamentosi, gi in uso nei
grandi ospedali.
Per concludere il concetto: il genere Aspergillus ha 6 sub-generi e 18 sezioni, che possono essere individuati
solo con gli aspetti macroscopici delle colonie e microscopici della conidiogenesi; per arrivare invece alle
250 specie, bisogna integrare indagini molecolari.
L'A. fumigatus la specie pi patogenica: fino a 20 C la formazione delle colonie uguale per fumigatus,
flavus e niger; a 37 C il niger ha una capacit molto bassa di germinazione, che invece altissima per il
fumigatus.
Per fare coltura, si utilizza un vetrino con un blocchetto di agar e si semina ai quattro lati il fungo; si mette il
copri-oggetto, il fungo cresce e si porta sul copri-oggetto, ma anche sul porta-oggetto, per cui le ife vanno
incontro a conidiogenesi, che potr essere studiata e osservata facilmente.
Quali forme cliniche potremo osservare (con le gi viste comuni allergie, come sinusiti allergiche, per gli
immunocompromessi) in caso di aspergillosi? Ci sono tre forme cliniche:
colonizzazioni (da porre in relazione con l'inalazione di conidi)
infezioni invasive (anche nei normoergici)
manifestazioni allergiche (solo nei neutropenici)
Le molecole di virulenza, che hanno ruolo nella patogenesi, sono le adesine, gli enzimi, le tossine ed i
pigmenti. I geni e le molecole prodotte dal fungo come fattore di adattamento al nuovo ambiente,
diventano fattori di virulenza nell'ospite.
Esiste una gradualit delle forme cliniche, in relazione al grado di immunocompromissione dell'individuo:
ospite normale, oltre alle forme allergiche, si possono avere colonizzazioni del tratto broncopolmonare. Fra le infezioni superficiali, si riconoscono quelle ungueali (si osservando conidi ed ife in
microscopia, che dovrebbero permettere di individuare la specie ed il genere fungino), quelle del condotto
uditivo esterno, dei seni e delle vie aeree bronchiali. Esistono anche le aspergillosi associate a danno
tissutale che sono invasive, come un graffio alla cornea, od un danno alle vie aeree che pu favorire un
aspergilloma polmonare. Queste invasive possono essere legate ad interventi chirurgici.
Ospite immunocompromesso: per eccellenza sono gli individui neutropenici. Un neutropenico che
contrae un'aspergillosi, pu facilmente anche andare incontro a morte; un passo avanti in questo senso
stato permesso dalla ricerca farmacologica che ha prodotto farmaci, da usare in profilassi, che hanno
ridotto le probabilit di morte per questi individui. I neutrofili hanno un'azione killer nei confronti delle ife:
un soggetto normale, oltre ai macrofagi, che tendono a fagocitare le ife, possiede i neutrofili che uccidono
le ife. Quindi la neutropenia un fattore importante nella patogenesi degli apergilli. Le aspergillosi in questi
soggetti sono cutanee, seno-orbitali, polmonari, disseminate, cerebrali e gastrointestinali (legata ad
ingestioni di alimenti con ife e conidi) pi rare.
Aspergillus e Fusarium hanno meccanismi di riproduzione molto differenti, ma patogenesi simile: sono
legati ad infezioni da corpo estraneo (lenti a contatto); danno infezioni superficiali od organizzate a singolo
organo (occhio, orecchio, unghia); possono dare infezioni invasive nell'immunocompromesso. Tuttavia
esistono differenze: in caso di infezione profonda, nelle fusariosi, l'emocoltura risulter positiva, cio si
potr isolare dall'emocoltura; in caso di aspergillosi, sar impossibile isolare l'aspergillo dall'emocoltura.
Microbiologia - Medicina e Chirurgia polo A 2012/2013 - sbobinature lezioni
108
Nel caso di fusariosi, le lesioni cutanee risulteranno disseminate (come nelle criptococcosi) e spesso le
diagnosi vengono fatte su questa base. In generale il fusarium ha habitat ambientale, pu provocare micosi
mediante l'utilizzo di tossine; dal punto di vista microscopico si osservano fialidi, clamidospore e conidi.
Monofialide: il punto di formazione dei conidi unico
Polifialidi: i punti di emergenza dei conidi sono multipli
Macroconidi: quattro cellule
Microconidi: in catene, ammassati a formare una sorta di sfera
Perch i fusarium possono essere isolati dall'emocoltura? Alcuni filamentosi, fra cui i dermatofiti, quando
invadono un tessuto, producono di clamidospore: nelle sezioni da fusarium, nell'organismo possono
diffondersi queste cellule che diffondono nel sangue. Al contrario aspergillus non fa questo, ma le infezioni
disseminate, si hanno per dispersione delle ife.
I generi principali di Fusarium sono i Solani e Oxysporum, che danno infezioni umane a carico di occhio,
unghia, cute, seni mascellari e infezioni profonde.
PENNICILLUM MANNEFFEI
Rappresenta l'unica specie che pu dare infezioni nell'uomo.
Vive nel Sud-est asiatico e si trova nel suolo, in particolare nelle coltivazioni di bamb; a 37 C forma cellule
rotonde o crittiche che si dividono per fissione. Da origine ad un'infezione molto simile alla tubercolosi.
Il soggetto che inala conidi, pu eliminarli (avere infezione e poi una guarigione totale) oppure pu
contrarre un'infezione che poi permane sub-clinica ed asintomatica. L'infezione ha localizzazione
polmonare; molto frequente nel malati di AIDS. L'infezione si trasmette per modalit ambiente-uomo,
mai uomo-uomo.
Per la sua riproduzione molto efficiente (muffa verde delle arance, che contiene milioni di conidi): i conidi
a 37 C danno origine ad ife, e si formano cellule rotonde o ellissoidale (lievito) o a forma di botte con il
setto. La diagnosi di pennicilliosi non molto semplice, e pu essere individuato mediante isolamento da
coltura o con anticorpi.
Ha una caratteristica colorazione rossa nel terreno, e coltivato in laboratorio a temperature maggiore di 30
C danno origine a muffe.
Lezione 13 Il controllo delle infezioni
Voi sapete che il controllo delle infezioni non passa solo attraverso luso di farmaci, antibiotici,
chemioterapici e quantaltro, ma passa anche per esempio attraverso le vaccinazioni. Per la micologia non
abbiamo argomenti di questo tipo, su internet si pu trovare per esempio vaccinazione per i funghi ma
di fatto non sono delle vere vaccinazioni. Delle vaccinazioni vere sono state utilizzate per la micologia in
ambito veterinario per due motivi: uno per i dermatofiti e per le dermatofizie perch quando si diffonde
per esempio in un allevamento di bestiame la dermatofizie e diminuisce il valore delle pelli, ci ha un
impatto economico non indifferente, questi esperimenti hanno non hanno avuto molto seguito.
Recentemente sono stati fatti esperimenti per la immunizzazione contro le micotossine, e quella tutto
sommato interessante, perch se lanimale ingerisce micotossine comunque in grado di trovarsi in una
situazione di immunizzazione. Ma comunque chiudo subito la parentesi perch noi di vaccini non ne
parleremo, ma anche perch nei confronti dei funghi il nostro sistema immunitario ha una elevata
Microbiologia - Medicina e Chirurgia polo A 2012/2013 - sbobinature lezioni
109
efficienza, sia limmunit innata sia quella acquisita. Per dobbiamo parlare degli anti-funginei e vedere
qualche aspetto dal punto di vista clinico.
Alla fine degli anni 50 comincia luso dellamfotericina B che il primo antifungineo ed rimasto fino ad
oggi, prodotto da un batterio e viene utilizzato per la pratica clinica, a seguire poi viene sintetizzata la 5floro citosina e poi cominciano gli azoli (siamo negli anni 70), bisogna arrivare agli anni 90 per cominciare ad
avere il primo triazolo in commercio e quindi la possibilit di cura per via orale, via sistemica, con farmaci
che non presentavano i problemi comuni di tossicit che aveva lamfotericina B. Poi arriviamo agli anni
2000 per avere le echinocandine disponibili nella pratica clinica. Perch questo salto? Il problema che le
micosi profonde sono diventate un vero problema per la medicina, uno per laids, due per laumento di
popolazione a rischio di infezioni funginee invasive. La storia dello sviluppo degli antifunginei sembra
riflettere la necessit delluomo di scoprirne di nuovi e pi efficaci. Adesso ci occupiamo solo dei farmaci
che sono oggi disponibili, possiamo considerare 5 classi in base al meccanismo di azione, anche se devo dire
le prime tre, gli azoli, i polieni e le allilamine tutto sommato hanno come bersaglio lergosterolo di
membrana ma con meccanismi diversi, poi abbiamo inibitori della sintesi del DNA e della sintesi delle
proteine che sono la 5-fluorocitosina e le echinocandine.
Nella membrana cellulare della cellula lievito vi ergosterolo, tutti questi antifunginei i polieni le allilamine
i composti morfolinici e tutti i derivati tiazolici, siano essi imidazoli che triazoli, hanno come bersaglio
lergosterolo di membrana. La scoperta delle echinocandine stata salutata con una grande speranza
perch finalmente si cambiava bersaglio.
Lamfotericina b attualmente il farmaco fungicida pi efficace che ha anche il pi ampio spettro di azione
rispetto ad altri farmaci, ha un meccanismo di azione particolare, cio ha uninterazione diretta e ci perch
i polieni sono caratterizzati dallavere una serie di doppi legami che conferisce a questa parte della
molecola una spiccata idrofobicit, mentre laltra parte che ricca di gruppi OH idrofila, si tratta di una
molecola anfipatica, cosa fa allora amfotericina B?nella sua interazione diretta con lergosterolo, lo lega
inizialmente in maniera reversibile (ma diciamo che in breve tempo il legame diventa irreversibile e questo
un aspetto molto importante) con la parte idrofobica della molecola, mentre la restante altra parte va ad
assicurare la formazione di un canale per cui nella membrana cellulare si aprono come dei pori, si altera la
permeabilit di membrana e attraverso questo poro avviene la fuoriuscita di ioni che sono essenziali per la
vita della cellula. Essenzialmente la perdita di ioni potassio ma anche di cationi, altera molto il gradiente
protonico e porta la cellula a morte infatti i polieni sono ovviamente dei fungicidi, noi lo possiamo
dimostrare in laboratorio mediante una particolare tecnica chiamata time killink cio si misura nel tempo
quante cellule vengono uccise in relazione alla concentrazione del farmaco. Amfotericina B quindi il
poliene che utilizziamo di pi (ma ce ne solo tanti altri, come quelli ad uso topico vaginali) e tra laltro
stata possibile attualmente la sua applicazione perch stata trasformata in forma lipidica che ha il grande
vantaggio di ridurne molto la tissicit.
Laltro gruppo di farmaci invece sono i derivati azolici. (si nota il gruppo imidazolico con tre azoti). Due
sono i capostipiti dei diazoli: il fluconazolo e litraconazolo da cui sono stati derivati gli altri azoli che oggi
conosciamo. Tra i derivati azolici vi sono derivati imidazolici e triazoli. Gli imidazoli sono stati scoperti prima
per tra gli imidazoli non ne usiamo pi nessuno nella pratica clinica per via sistemica a causa della loro
bassa selettivit per il bersaglio, per cui nella pratica clinica avranno usi topico. Con i triazoli abbiamo avuto
il salto di qualit riguardo alla selettivit del bersaglio, perch? Lo capiamo guardando il meccanismo di
azione, che legato ad un passaggio enzimatico nella via biosintetica dellergosterolo che avviene a livello
del citocromo p450 della cellula lievito e soprattutto per la demetilazione del gruppo in posizione 14alfa.
Ora il problema che il citocromo p450 non esclusivo della cellula lievito, ne abbiamo nelle nostre cellule
tantissimo per esempio nelle cellule epatiche, e il problema stato questo, cio nonostante abbiamo
trovato queste sostanze di sintesi in grado di agire nella cellula funginea, quando sono stati sperimentati
Microbiologia - Medicina e Chirurgia polo A 2012/2013 - sbobinature lezioni
110
sullanimale, si sono dimostrati con una certa tossicit soprattutto a livello epatico. Quindi il salto della
selettivit avvenuto con i trizoli a partire dal fuconazolo, certamente non hanno niente a che vedere con i
derivati imidazolici. Lultimo derivato imidazolico che troviamo ancora in compresse ma che ormai
raramente viene utilizzato il ketaconazolo, cio sono stati fatti diversi tentativi di avere farmaci utili nella
pratica clinica, ma con i triazoli si ha avuto il salto di selettivit. Il meccanismo di azione quindi
essenzialmente una inibizione della sintesi dellergosterolo e proprio per questo i derivati azolici sono da
considerarsi dei fungistatici cio in realt la cellula funginea viene inibita nella crescita e non sempre
immediatamente perch la cellula pu utilizzare lergosterolo che ha in riserva nel vacuolo, ma in presenza
di questa inibizione la cellula bloccata nella crescita e nel tempo la cellula andr a morte, questi farmaci li
chiamiamo infatti tempo-dipendenti, cio la loro azione legata al tempo nel quale la concentrazione del
farmaco persista a livelli tali da inibirne la crescita e quindi la formazione di nuove membrane, bloccando la
formazione di nuove membrane nel tempo la cellula perder molte funzioni importanti e morir. I farmaci
come lamfotericina B sono dose-dipendenti invece, perch lazione legata alla dose (questi concetti li
ritroverete in farmacologia). Vi ripresento la diapositiva della prima lezione in cui si vede che partendo
dallacetil-Coa si arriva al lanosterolo e da qui nei mammiferi si ottiene colesterolo, nei miceti ergosterolo,
alcuni enzimi sono comuni, alcune tappe enzimatiche sono comuni alle due vie e questo uno dei motivi
per cui luso dei farmaci tiazolici deve essere controllato. Invece in questa diapositiva possiamo cogliere
quali sono le tappe della via metabolica nei quali agiscono questi farmaci, abbiamo detto gli azoli a valle del
lanosterolo, e il gene che codifica per la 14alfa demetilasi il gene ERG11 e questo importante perch
mutazioni di ERG11 ci hanno spiegato il perch della resistenza intrinseca di alcuni lieviti.
Mentre le allilamine agiscono sulla squalene epossidasi che codificata dal gene ERG1. Altri farmaci come i
derivati morfolinici (che non studieremo) agiscono invece pi a valle. Ormai si conoscono tutti i geni che
sono coinvolti nei processi di biosintesi dellergosterolo. Tutti questi farmaci agiscono sulla via biosintetica
dellergosterolo. La cellula non pu utilizzare ergosterolo dallesterno, ma per formare membrana cellulare
funzionale ha bisogno di ergosterolo prodotto allinterno della cellula, quando in fase attiva di biosintesi
la cellula lo accumula nel vacuolo lergosterolo, e questo fatto che la cellula ha una riserva di ergosterolo,
ha un impatto nella determinazione della minima concentrazione inibente di questi funghi nel determinare
il punto limite.
Lo spettro di azione di questi funghi abbastanza ampio perch riguarda dermatofiti, lieviti, funghi
filamentosi, ad eccezione degli zigomiceti. Ma abbiamo un triazolo che il posaconazolo che attivo anche
sugli zigomiceti, quindi come lamfotericina b lo spettro dazione molto ampio (forse anche pi ampio).
Essenzialmente, quando lazolo attraversa la membrana citoplasmatica e arriva dentro al citoplasma, va ad
interferire in questa via biosintetica, il blocco della demetilazione del lanosterolo porta allaccumulo di uno
sterolo tossico che va ad inserirsi nella membrana citoplasmatica e alla fine avremo larresto della crescita
funginea. A proposito del discorso dellattivit fungistatica, cosa avviene in laboratorio se prendo delle
cellule lievito, metto un brodo e utilizzo fluconazolo, io mi accorger che provoca una lieve crescita che poi
si arresta, ma se dopo 48 ore, prendo un po di queste cellule le lavo e le metto in piastra senza fluconazolo,
la cellula ricomincia a crescere, quindi lazione fungicida deve avvenire in tempi brevi, cio noi diciamo che
lamfotericina B fungicida perch in 8 ore gi porta a morte moltissime cellule funginee, mentre qua
vediamo nel caso dei fungistatici dopo 24 ore prendo queste cellule sono praticamente vive.
Le allilamine abbiamo gi detto qualcosa, la squalene lipossidasi (non mi voglio fermare pi di tanto), non
hanno ampio spettro diciamo che tuttosommato buono. Ma qual la loro caratterstica? Per esempio
sono molto attive per le dermatofitosi! Pero in alcuni casi in associazione con altri farmaci sono state
utilizzate per terapie da funghi molto difficili da trattare. Ma il loro ruolo essenzialmente di farmaco
contro i dermatofiti.
Microbiologia - Medicina e Chirurgia polo A 2012/2013 - sbobinature lezioni
111
Altra classe la 5-fluorocitosina, praticamente stata studiata come anti-tumorale ma non se ne parl
completamente perch non riusciva neanche ad entrare nelle cellule, si vide che aveva una certa attivit nei
confronti dei funghi, soprattuto lieviti e criptococcus e qualche aspergillus. Come mai stata utilizzata in
micologia? stato legato fondamentalmente a questo fatto: i funghi hanno una citosina permeasi che porta
dentro la cellula la 5-fluorocitosina.
Vediamo il meccanismo di azione della 5-fluorocitosina. Dentro la cellula lievito intanto deve
assolutamente deaminata una volta entrata nella cellula, cio deve diventare 5-fluorouracile, la citosina
deaminasi rappresenta un enzima chiave, sottoforma di 5-fluorouracile pu seguire due vie: una quella
che porta a formare il 5-fluoro uridinmonofostato, cio la base entra a far parte del nucleotide che pu
legarsi dentro lRNA messaggero. Allora la presenza di questo nucleotide che porta questa base nellRNA
messaggero, porta al blocco della sintesi proteica, ma stato scoperto un altro meccanismo, che quello
legato al fatto che si pu formare il 5-fluorodeossiuridinmonofosfato che pu seguire la via della
formazione dei nucleotidi che ovviamente servono ad essere incorporati nel DNA. Ma sotto questa forma,
questo composto va ad inibire la timidilato sintetasi, quindi blocca la sintesi del DNA. Quindi la 5fluorocitosina agisce o bloccando la sintesi del DNA o bloccando la sintesi proteica. un farmaco
eccezionale perch attraversa anche la barriera emato-encefalica. Il problema per sta nelle resistenze,
cio si vide subito mentre venne studiato questo farmaco, che cerano delle resistenze primarie, per
esempio per candica albicans di sierotipo B, circa il 70% dei ceppi erano resistendo alla 5-fluorocitosina.
Allora resistenze primarie, innate, e resistenze acquisite, cio in corso di terapia si isolavano ceppi resistenti
perch? ora lo vedremo quali sono i meccanismi della resistenza. Questa via di azione si presta a tanti
punti critici, il primo per eccellenza una mutazione della permeasi che quella pi diffusa, la mutazione
della permeasi blocca lingresso del farmaco dentro la cellula, nonostante questo luso combinato di
amfotericina B e 5-fluorocitosia, in quei famosi anni 70 fino a 90, stata lassociazione fondamentale per la
terapia di micosi profonde e ha salvato sicuramente tante persone, ed lunica vera associazione sinergica
tra farmaci, perch si associano due farmaci? Perch il loro effetto messo insieme molto di pi della loro
somma, perch in questo caso si ha sinergia? Perch essendo il fattore critico soprattutto lingresso del
farmaco nella cellula da parte della 5-fluorocitosina, luso dellamfotericina B anche a dosi pi basse
permetteva di superare questo gap, per cui lamfotericina B aprendo quei pori nella membrana
citoplasmatica, permette lingresso della 5-fluorocitosina per diffusione dentro la cellula. Luso di questi
due farmaci si affermato per terapia di micosi profonde, ed stata la terapia pi utilizzata in quegli anni,
prima che si scoprissero altri farmaci. Oggi che uso facciamo della 5-fluorocitosina? ancora disponibile,
per avere avuto disponibili i triazoli e lamfotericina B ha ridotto luso della 5-fluorocitosina.
Veniamo allultimo gruppo: le echinocandine. Sono state scoperte nel 72, siamo arrivati agli anni 2000 per
avere il farmaco disponibile, ce ne sono disponibili tre, hanno una eccellente attivit contro la maggior
parte delle specie di candida tranne che per candica parapsilosis e candida guilliermondii, per le
echinocandine non agiscono completamente su alcuni funghi, perch? Intanto vediamole dal loro punto di
vista chimico: se guardate le tre echinocandine oggi disponibili vedete che tutto sommato hanno la parte
centrale molto simile tra di loro, quello che cambia la catena laterale, tutte e le tre le echinocandine sono
prodotte da funghi ma in realt poi il prodotto viene trasformato in laboratorio. Quindi essenzialmente da
un lato avevamo un prodotto naturale, un antibiotico, ma non aveva quelle caratteristiche sufficienti per
essere utilizzato nella pratica clinica, allora in laboratorio si sono ottenute molecole differenti. La novit
delle echinocandine che cambia decisamente bersaglio, che lenzima B 1,3 glucano sintetasi, cio non
abbiamo pi un bersaglio di membrana ma un bersaglio di parete. Un punto importante da tenere presente
che lantifungineo deve comunque entrare dentro la cellula, quindi lattraversamento della membrana
citoplasmatica un punto critico. Linibizione di tale enzima porta allo sconvaginamento della parete
cellulare per cui nei confronti della maggior parte della specie di candida c un elevata attivit fungicida
Microbiologia - Medicina e Chirurgia polo A 2012/2013 - sbobinature lezioni
112
per altre specie di funghi invece attivit fungistatica. Nei confronti di aspergillus c un attivit molto
particolare al punto tale che ha richiesto lintroduzione di n nuovo parametro per misurare questa attivit,
noi conosciamo la MIC (concentrazione minima inibente), noi in laboratorio misuriamo il valore del MIC
perch un parametro importante, ma per quanto riguarda lattivit delle echinocandine sullaspergillo
non si potuto utilizzarela MIC perch se noi prendiamo la piastra e mettiamo concentrazione di farmaco
via via crescente, alla fine la crescita c dappertutto, se si va a guardare la morfologia delle ife, si vede che
queste sono completamente diverse, cio a partire da una certa concentrazione le ife diventano pi tozze.
Tutto questo ha permesso, in perfetta concordanza con il dato clinico, di introdurre questo parametro MEC
cio minima concentrazione efficace; quando noi utilizziamo il kit commerciale per fare un saggio in vitro
allaspergillo, se si dovesse leggere il parametro secondo le indicazioni, uno dice resistente, non attiva
lechinocandina, ma noi sappiamo che non dobbiamo misurare lattivit metabolica, ma la morfologia delle
ife, quindi prendiamo dei campioni e osserviamo al microscopio per renderci conto a quale concentrazione
noi abbiamo la cosiddetta MEC. (fa vedere foto). In realt laspergillo si sviluppato in qualche modo
quindi, solo che ad un certo punto la crescita stata arrestata. Tutto questo fatto dellaspergillo stato poi
dimostrato, dimostrando che la Beta 1,3 glucano sintetasi molto attiva nelle ife. Ma come mai allora non
viene bloccato subito laspergillo quando sotto forma di conidi? Perch quando ancora la cellula sotto
forma di conidi la cellula non ha ancora attivato le beta 1,3 glucano sintetasi. E tutto questo possiamo
capirlo attraverso il fenomeno paradosso che avviene con le echinocandine, vediamo cosa : se io preparo
me mie MIC ad un certo punto mi accorgo che ad un intervallo di dosi ho assenza di crescita, ma quando
aumento le dosi il fungo ricomincia a crescere? Ma come mai? Si scoperto che la cellula funginea capace
di rispondere alle condizioni di stress, e come risponde alle condizioni di stress, in questo caso al blocco di
questo enzima? Risponde aumentando la quantit di chitina, cio si visto che vengono attivati i geni della
chitina sintetasi in queste condizioni ad alti livello di farmaco, cos si assicura comunque una parete solida.
Questo fenomeno stato dimostrato in vitro, attualmente in vivo non stato segnalato n nellanimale n
nelluomo.
Se questi sono i meccanismi di azione, dobbiamo anche fare un approfondimento sui meccanismi di
resistenza, cio quali sono le attuali conoscenze rispetto alle resistenze che possono svilupparsi nei
confronti di questi farmaci. Intanto vorrei che voi richiamaste alla mente, se lo avete fatto, il concetto di
resistenza clinica rispetto alla resistenza microbiologica. Nel caso di infezioni funginee ci siamo resi conto
che anche se io ho uninfezione funginea di cui conosco lambiente eziologico e ho fatto un appropriato
trattamento, posso non avere la guarigione del paziente, cio io posso avere un fallimento della terapia che
dipende da un complesso di situazioni che porta a resistenza clinica, diversa la resistenza microbiologica
che distinguiamo in resistenza primaria e resistenza secondaria. (Rimprovera Alfio dicendo lei troppo
agitato oggi!. Quando primaria la resistenza? Quando io ho un ceppo che intrinsecamente resistente al
farmaco senza esserne venuto a contatto invece secondaria quando la cellula resistente dopo aver
avuto contatto col farmaco (questo vale anche per i batteri), sono concetti di base molto importanti. Alla
resistenza clinica concorrono tanti fattori, il fungo, lospite, il farmacocio ci sono tanti aspetti da tenere
in considerazione che portano alla possibilit di un insuccesso terapeutico nonostante il farmaco sia
appropriato. Quali sono i meccanismi di resistenza che abbiamo visto? Modifiche del target del farmaco, se
cambia la struttura del fungo, per esempio il gene ERG11 non uguale in tutte le specie albicans,
sovraespressione delle pompe di eflusso, alterata risposta allo stress cellulare. Questi sono i tre meccanismi
fondamentali che troviamo tra i funghi. Le pompe di efflusso soprattutto CDR e MDR, sono legati alla
resistenza al fluconazolo, mentre gli ABC trasporter sono legati alla resistenza verso tutti gli azoli. Sulle
pompe di eflusso si sono fatti parecchi studi. I tre grandi punti sono: alterazione del bersaglio, alterazione
alla risposta allo stress cellulare e attivazione delle pompe di efflusso.
Microbiologia - Medicina e Chirurgia polo A 2012/2013 - sbobinature lezioni
113
A proposito di biofilm: dobbiamo dire che fondamentalmente i derivati azolici in presenza di biofilm non
riescono ad agire. Mentre invece amfotericine B e echinocandine agiscono anche in presenza di biofilm. Per
i polieni, uno dei meccanismi pi importanti lalterazione della composizione in sterolo della membrana
citoplasmatica, quindi una diminuzione dellergosterolo che viene sostituito da un altro, comporta per
alcune specie anche una resistenza primaria. per la 5-fluorocitosina i meccanismi sono legati alle mutazioni
della permeasi e la deaminasi, o la sovraespressione di geni che codificano per la base normale. Mi fermo
un attimo sulle echinocandine: la Beta 1,3 glucano sintetasi fa riferimento al gene FKS e c isoenzima I e II,
essenzialmente possiamo avere oltre alla risposta allo stress cellulare con produzione di chitina, si ha
resistenza e fallimento terapeutico quando ci sono mutazioni nel gene FKS I, queste mutazioni faranno si
che in futuro quando saremo inseriti nella pratica clinica, non si chieder al laboratorio la MIC del ceppo,
ma se il ceppo presenta mutazioni per lFKS I. perch vi dico questo? perch sul discorso delle MIC con le
echinocandine c stato un grande cambiamento, pensate che fino a qualche anno fa il CLSI ci dava come
criteri di break point (interpretazione dellanti micogramma), minore o uguale a 2 = sensibile, maggiore di 2
= non sensibile, ma quando mai! Nel frattempo veninavo segnalati questi casi di fallimento terapeutico
anche con ceccpi con MIC = 1. A partire da tutti questi ceppi da casi in cui il paziente faceva il farmaco e non
guariva, si sono studiati questi ceppi e oggi sono stati cambiati i break point, ma tutto partito dal fatto che
si dimostrato che esiste una relazione stretta tra mutazione di FKS e lazione delle echinocandine.
Lultima parte la volevo riservare alla parte di laboratorio. Negli anni 70-90 sono stati standardizzati i
metodi di saggio in vitro, per la micologia sono negli anni 90 abbiamo avuto standardizzazioni. Il saggio in
vitro, molto utilizzato per i batteri perch alla fine ci permette di sapere qual il farmaco pi adatto da
utilizzare, per i funghi non stato cos semplice, soprattutto perch le cellule sono differenti, e poi per il
fatto che ci sono problemi legati ai funghi filamentosi. Ci sono due organismi preposti alla
standardizzazione dei metodi: uno quello americano CLSI che si occupa di laboratorio in toto, in Europa
nato lEUCAST che fa questo. Questi due gruppi si sono confrontati e hanno avuto il grande vantaggio di
collaborare e di riuscire ad ottimizzare e fare una proposta oggi ottimale e cio noi 1.25
Quando noi andiamo in laboratorio, possiamo utilizzare i metodi standard del CLSI e EUCAST, per il
problema che ho la sostanza pura del farmaco che devo mettere nei pozzetti per saggiarlo? quelli fuori
brevetto li ho, quelli con il brevetto devo farmeli dare dalle aziende se me li danno. Seconda cosa:
preparare una piastra secondo questi standard richiede tempo! Nella pratica clinica utilizziamo dei test che
sono forniti dallindustria, questo test deve essere validato dal CLSI e dalleucast, oggi abbiamo disponibili
tre possibilit, metodi di microdiluizione in brodo, e qual il vantaggio della microdiluizione in brodo?
Posso determinare la minima concentrazione inibente ma potrei anche calcolarmi la minima
concentrazione fungicida. Semplicit di interpretazione e di lettura, in questo test stato introdotto un
indicatore di colore Blu che misura lattivit metabolica, allora si osserva tutto rosa, rosa poi blu il punto
in cui non c viraggio (MIC), possibilit di saggiare i funghi filamentosi e leggere la MEC. Supponiamo che io
saggio in vitro candica albicans con fluconazolo, se io utilizzassi come criterio di lettura della MIC assenza di
cresceta, dovr dire che il ceppo resistente, ed logico, se la cellula ha ergosterolo nel vacuolo va ad
utilizzarlo e per un certo tempo si moltiplica, allora il CLSI cosa ha fatto? Ha dato questo criterio: quando fai
la piastra e vuoi saggiare gli azoli, il criterio non assenza di crescita (come nel caso di amfotericina B) ma il
criterio la riduzione di almeno il 50% rispetto al controllo, quindi quando c il pozzetto che al meno di
50% quella la MIC. Se il controllo fatto per via spettrofotometrica la MIC tale quando si ha il meno
dell80%. Tutto questo stato in un certo senso superato e favorito dallintroduzione di questo indicatore
che tarato in maniera da misurare unattivit metabolica presente nel pozzetto che ci permette di
misurare bene la MIC.
Microbiologia - Medicina e Chirurgia polo A 2012/2013 - sbobinature lezioni
114
Laltro metodo che i laboratori hanno a disposizione lE test, in quanto c una particolare striscia che ha
il gradiente di concentrazione del farmaco, questi metodi sono di diffusione in agar (?), oggi questo e-test
rappresenta uno dei test pi diffusi perch stato validato da test clinici.
Terza possibilt per i laboratori lautomazione, cio anche per i funghi abbiamo apparecchiature
automatiche che consentono di calcolare la MIC.
Leuropa ha fatto fare questo passo avanti perch ha cercato di separare la condizione clinica dalla
condizione biologica, se noi prendiamo per una specie un tot di ceppi, per WILD-type selvatici, che non
sono venuti a contatto con il farmaco, che non hanno meccanismi di resistenza, se noi saggiamo questi
ceppi col farmaco, abbiamo una distribuzione di tolleranza, significa che in natura di per se questi ceppi si
distribuiscono con queste MIC (credo comunque che faccia riferimento a dei grafici), a questo punto io
posso determinare il cos detto cut-off epidemiologico, cio se noi sappiamo che tutti i ceppi di candida
albicans wild-type hanno nei confronti del fluconazolo un range di MIC che va da 0.5 a 1, io so che 1 pu
rappresentare il cut-off epidemiologico. Poi per abbiamo i ceppi non wild-type, ma quelli che sono gi
venuti a contatto col farmaco, nei confronti di questi ceppi noi introduciamo dei break-point clinici che mi
servono ad interpretare quelle famose MIC che otteniamo dal laboratorio, per cui i ceppi sono separati in
un gruppo sensibile, uno intermedio e un gruppo resistente. Allora tutto questo dal punto di vista
concettuale importante, perch si fatta chiarezza sia sul valore delle MIC che noi otteniamo da certi
ceppi. Quindi si affermato questo concetto di cut-off epidemiologico che serve per riconoscere
precocemente la resistenza, e vedremo che la micologia il peso pi grande che ha la risposta del laboratorio
quando ci segnala che il ceppo resistente. Ovviamente il cut-off epidemiologico ci permette di
distinguere sei i ceppi sono wild-type o no. Invece per i break point clinici si tiene conto degli aspetti clinici
ed epidemiologici e serve a ottimizzare tutto questo. Gli europei hanno corretto drasticamente quello che
era stato in un certo senso fatto, hanno dato delle indicazioni pi chiare riguardo alluso nella pratica
clinica.
Quando devo eseguire un test in vitro ai farmaci antifunginei? Quando c un fallimento terapeutico,
oppure per finalit epidemiologiche. Per perch lo ripetiamo quando si ha fallimento terapeutico? Solo
per avere la conferma che non si tratta di una nuova resistenza. Nel caso delle vaginiti per infezione da
candida, spesso si ha guarigione ma poi si ha una ricaduta, si crede che si sono sviluppati ceppi resistenti e
si chiede analisi di laboratorio, ma non cos, in realt la paziente ha la ricaduta perch ha con se tutti quei
fattori predisponenti che la portano nuovamente alla vaginite e non ha ceppi resistenti, si ottengono
sempre ceppi sensibili solo raramente si trova il ceppo resistente.
(fa vedere poi altre immagini, una tabella con dei valori).
Conclude dicendo che: quando si fa un test in vitro, la sensibilit non predice il successo della terapia, la
resistenza invece sicuramente predice il fallimento terapeutico.
Lezioni secondo semestre virologiaLezione 2
I virus sono parassiti endocellulari obbligati. Generalmente, l'infezione virale si svolge in 2 fasi:
penetrazione del virus all'interno dell'ospite
penetrazione del virus all'interno della cellula
Microbiologia - Medicina e Chirurgia polo A 2012/2013 - sbobinature lezioni
115
Il primo obiettivo quello di distinguere i diversi tipi di infezione virale, distinguere la sintomatologia, la
clinica, le patologie, ricordando che alcune patologie possono essere in comune tra un virus e un altro.
Si cercher anche di capire come differenziare uninfezione virale da altre infezioni indotte da altri
microrganismi, che possono presentare le stesse sintomatologie.
Classificazione delle infezioni virali:
infezione acuta: il virus, alla fine dell'infezione, scompare dall'organismo.
infezione persistente: un susseguirsi di infezioni acute. Il virus non viene definitivamente
debellato.
INFEZIONE ACUTA
esempio:
Patrizia C. anni 16 Studentessa
Genitori viventi ed in apparente buona salute, ha due fratelli, non fuma e non beve alcolici.
Nata a termine da parto eutocico oltre ai comuni esantemi dell infanzia non riferisce precedenti malattie.
dellinfanzia. Tre giorni fa, in pieno benessere, ha manifestato abbondante e persistente secrezione nasale,
senso di occlusione nasale, bruciore e secchezza alla gola.
Accusa, inoltre, perdita del gusto, dell olfatto, senso di peso doloroso alla fronte e modesto bruciore agli
occhi. La temperatura ha subito una modesta elevazione (37,5 37,7 ).
La ragazza, senza nessun tipo di terapia, dopo 2-4 giorni spontaneamente guarisce.
Diagnosi: infezione virale acuta delle prime vie aeree indotta da Rhinovirus (raffreddore comune).
Il virus entra, dopo un'iniziale incubazione vi un'attiva replicazione del virus, esso causa un breve periodo
di malattia che si manifesta con la relativa sintomatologia, dopo di che interviene il nostro sistema
immunitario che attacca e elimina il virus. Uninfezione acuta si ha quando, alla fine, dopo la guarigione,
abbiamo la completa eliminazione del virus.
Linfezione acuta pu essere schematicamente rappresentata come segue:
Microbiologia - Medicina e Chirurgia polo A 2012/2013 - sbobinature lezioni
116
Esempi classici di infezioni acute:
- il raffreddore comune (Rhinovirus)
- linfluenza (Orthomyxovirus)
- alcune rino-faringo-tracheiti (Coxsackie, ECHO, virus respiratorio sinciziale (RSV), Paramyxovirus)
Spesso il virus pu entrare nel circolo sanguigno e raggiungere tutti i distretti del nostro corpo (viremia);
per esempio, il virus della Rosolia un classico esempio di infezione acuta, quindi significa che dopo la
sintomatologia il virus scompare completamente, tranne in pochissimi casi in cui viene classificata come
Rosolia acquisita; in questo caso, il virus della Rosolia non da uninfezione acuta, ma persistente: la
gestante che trasmette il virus al feto. Il virus potrebbe interferire sullorganogenesi del feto. Il bambino
nascer con la Rosolia, che durer per circa un anno, dopodich il virus viene eliminato
INFEZIONE PERSISTENTE
esempio:
Agatino L. 58 anni muratore
Padre morto per cardiopatia imprecisata, madre vivente ed in apparente buona salute; ha quattro fratelli
viventi ed in apparente buona salute. apparente
Sposato, ha 3 figli viventi e sani.
Dei comuni esantemi dell infanzia riferisce la rosolia e la varicella contratta ad 11 anni . delli
Da circa due anni soffre di un eczema cutaneo per cui viene periodicamente trattato con corticosteroidi.
Un mese fa, a causa di un incidente sul lavoro, ha riportato fratture complicate al braccio sx. ed alla gamba
sx. ridotte chirurgicamente; pertanto stato sottoposto a frequenti controlli radiografici.
Circa 6 gg. fa ha accusato dolore acuto e senso di bruciore all emitorace dx. con estensione dorso ventrale.
Il dolore era particolarmente intenso nelle ore notturne allemitorace.
Successivamente osservava nelle zone dolenti la formazione di placche rosso violacee, separate da cute
integra su cui si manifestavano piccole papule.
Diagnosi: al paziente non tornata la varicella, ma lo Zoster, data sempre dallo stesso virus, che fa parte
della famiglia degli Herpes; il suo nome per intero virus della varicella-Zoster: La varicella la prima
infezione, e al suo risveglio d uninfezione da Zoster, localizzata. Non sempre la sintomatologia dell'
infezione da Zoster si manifesta chiaramente.
Microbiologia - Medicina e Chirurgia polo A 2012/2013 - sbobinature lezioni
117
Il virus della varicella-Zoster contratto ad 11 anni si manifesta nel paziente poich esso ha subito diversi
politraumi: il trattamento con corticosteroidi e i raggi X ionizzanti a cui stato sottoposto il paziente hanno
indebolito il sistema immunitario (fattori immunosoppressivi) e hanno contribuito alla riattivazione del
virus.
Anche se il soggetto guarito, il virus rimasto nell'organismo in forma persistente e latente: il soggetto
quindi, in seguito a politraumi, pu andare incontro ad altre ricadute, ad altre riattivazioni del virus. Questo
quindi un esempio di infezione persistente latente: un susseguirsi di infezioni acute.
Linfezione persistente latente pu essere schematicamente rappresentata come segue:
presente un periodo dincubazione, una replicazione attiva del virus, segue un breve periodo di malattia
con la sintomatologia conclamata, dopo di che si avr la scomparsa completa dei virioni, ma non del virus,
cio non si avr replicazione, ma a causa di fattori scatenanti, potrebbe ripresentarsi la stessa
sintomatologia.
I maggiori rappresentanti delle infezioni persistenti latenti si trovano nella famiglia degli Herpesviridae, i
quali comprendono 3 sottofamiglie:
Alphaherpesvirinae danno delle infezioni latenti nelle cellule nervose dei gangli sensoriali.
Queste cellule non permettono la replicazione del virus ma favoriscono la sua latenza.
Microbiologia - Medicina e Chirurgia polo A 2012/2013 - sbobinature lezioni
Simplexvirus: human herpesvirus 1,2 (HSV-1, HSV-2)
Varicellovirus: human herpesvirus 3 (VZV) o virus della varicella-zoster
118
Betaherpesvirinae danno delle infezioni latenti in cellule appartenenti a vari tessuti. Queste
cellule permettono il doppio comportamento del virus, possono replicarsi e rimanere latenti.
Cytomegalovirus: human herpesvirus 5 (CMV)
human herpesvirus 6 (HHV-6 - definito anche Roseolovirus, ma non c'entra niente con la Rosolia;
questo virus invece responsabile della sesta malattia) e 7 (HHV-7)
Gammaherpesvirinae si vanno a latentizzare e anche a replicarsi nelle cellule dei linfoblasti
Lymphocryptovirus: human herpesvirus 4 o Epstein-Barr virus (EBV)
Rhadinovirus: human herpesvirus 8 (HHV-8)
Come avviene la latentizzazione del virus?
I virus a DNA rimangono latenti all'interno della cellula in seguito a un processo di integrazione del proprio
DNA in quello della cellula ospite.
Nei virus a RNA invece, necessario che preliminarmente l'RNA venga replicato in DNA, perch solo in
questa forma pu avvenire l'integrazione del corredo genico del virus in quello della cellula infettata.
Nell'infezione acuta, il virus entra nella cellula, si replica all'interno di essa, ne provoca la lisi, ci causa la
fuoriuscita completa dei virioni e la successiva infezione delle altre cellule. Nell'infezione persistente
latente, il virus si latentizza: il virus, quando si trasferisce da cellula in cellula, rimane sempre all'interno
della cellula, per cui non pu essere attaccato dal sistema immunitario.
Cellule permissive: presentano dei recettori che vengono riconosciuti dall'antigene virale e possono essere
pertanto infettate e successivamente comandate dal virus.
Cellule semi-permissive: il virus entra, ma non comanda immediatamente la sua replicazione, o meglio, la
sua replicazione avviene in modo incompleto: vengono prodotti virus immaturi.
Cellule non permissive: non permettono la replicazione del virus, per grazie al gene LAT i virus riescono a
integrare il proprio acido nucleico con quello cellulare, quindi il virus pu latentizzarsi. Generalmente
rimane in forma episomale, cio legato attraverso il LAT al di sopra dell'acido nucleico cellulare.
Il virus entra attraversando la cute e le mucose, e attraverso i propri recettori, penetra all'interno della
cellula scatenando, nel soggetto non immune, un'infezione primaria (il virus entra x la prima volta
nell'organismo); l'infezione primaria pu essere localizzata, nel soggetto non immune, oppure pu
latentizzarsi in varie sedi, dopo di che, a seconda di fattori scatenanti sia esterni che interni all'organismo, la
latenza pu scatenarsi e la replicazione virale pu essere riattivata: vengono quindi prodotti nuovi virioni
completi (riattivazione).
INFEZIONE PERSISTENTE LENTA
Flavio R. 28 anni disoccupato, vive prevalentemente nel Nord Italia. Tossicodipendente da circa 10 anni;
ha condotto una vita errabonda con permanenze negli USA dove ha frequentato comunit di
Microbiologia - Medicina e Chirurgia polo A 2012/2013 - sbobinature lezioni
119
tossicodipendenti. Nientaltro da rilevare allanamnesi familiare e personale. Otto anni fa stato affetto da
Epatite da virus B curata e rimessa completamente. Cinque anni fa ha presentato ingrossamento delle
linfoghiandole laterocervicali ed inguinali, progressiva perdita di peso, senso di stanchezza, sudorazione
notturna intermittente. Tale sintomatologia si protraeva per due mesi dopodich insorgeva diarrea
intermittente- Ricoverato in un reparto di malattie infettive, veniva diagnosticata una Sindrome
Linfoadenopatica Acuta (LAS). Sottoposto a terapia sintomatica di mantenimento, la sintomatologia
lentamente rimessa. Uscito dall'ospedale, il soggetto non ha intrapreso nessuna terapia specifica e ha
continuato nell'assunzione di droga endovena.
Diagnosi: bisogna fare una serie di analisi tenendo conto che vi sono altre patologie, come la
linfoadenopatia acuta o a infezioni del linfonodi, che possono portare a un decremento dei linfociti. Bisogna
inoltre valutare se il paziente sieropositivo: se il rapporto CD4/ CD8 spostato di molto verso i CD8, allora
siamo in presenza di HIV, precisamente il paziente si trova in una fase di transizione tra la fase LAS (prima
fase dellinfezione da HIV ) e la fase successiva in cui l'AIDS conclamata.
Tramite il test di immunoblotting, si verifica che il paziente sieropositivo: significa che presenta anticorpi
anti-HIV e anche l'antigene virale circolante ad alte concentrazioni. Il virus quindi in un'attiva replicazione:
esso infetta le cellule CD4.
Due mesi fa ha manifestato una ripresa della sintomatologia generale e 10 giorni fa ha presentato
bruscamente disturbi respiratori rappresentati da aumento degli atti respiratori (tachipnea) e tosse, seguiti
da difficolt respiratoria (dispnea). La radiografia del torace dimostra una tipica polmonite interstiziale
bilaterale da Pneumocystis carini confermata dallesame microbiologico dell'espettorato. La rilevazione
dell'acido nucleico virale mediante PCR fortemente positiva ed presente un notevole decremento dei
linfociti T4.
Il soggetto, in questo stato, recettivo alle cosiddette superinfezioni da parassiti opportunisti (il soggetto
malato di AIDS infatti pu andare incontro a morte in seguito a banalissime infezioni).
Il soggetto ha contratto una polmonite interstiziale bilaterale da Pneumocystis carinii, classica
superinfezione in soggetti HIV. Lo sviluppo della patologia si manifestato ben 15 anni dopo (l'infezione
lenta: il virus persiste, ma non si latentizza, nei linfociti T4, e pu avere una continua attivit replicativa
all'interno di essi).
I fattori critici per la diagnosi di AIDS sono:
la tossicodipendenza
lepatite B (infezione facilmente trasmissibile attraverso il sangue), anche se poi il soggetto guarito
il fatto che ha avuto la LAS (sindrome linfoadenopatica acuta)
rilevamento di una quantit di acido nucleico virale elevata in circolo
il soggetto in fase di immuno-deficienza: quasi tutti gli altri microorganismi (commensali, parassiti,
opportunisti) diventano dei patogeni potenziali: microrganismi che in un soggetto immunocompetente non
causano alcun disturbo, per un soggetto malato di AIDS possono essere letali.
Linfezione persistente lenta pu essere schematicamente rappresentata come segue:
Microbiologia - Medicina e Chirurgia polo A 2012/2013 - sbobinature lezioni
120
Il virus, dopo un periodo di incubazione variabile, va incontro a una lenta, continua e costante replicazione,
dopo di che si avr la manifestazione della malattia e la relativa sintomatologia; il virus continua a
persistere e a replicarsi a concentrazioni abbastanza elevate.
INFEZIONE PERSISTENTE CRONICA
considerata come una situazione intermedia tra l'infezione latente e l'infezione lenta.
L'infezione persistente cronica pu essere schematicamente rappresentata come segue:
la replicazione del virus persiste per un tempo che pu essere pi o meno limitato, cio vi una
replicazione del virus all'interno della cellula che attiva solo per certi periodi; il danno provocato non
tanto dal virus, ma dalla risposta del nostro sistema immunitario al virus, o meglio dagli immuno-complessi
che si formano. Gli immuno-complessi sono dati dallunione del virus (o dell'antigene in generale) e degli
anticorpi.
Esempi di infezioni persistenti croniche sono le epatiti (B o C) o le infezioni da Rosolia congenita.
L'epatite B pu dare infezioni sia persistenti croniche sia acute ad esito letale e fulminante.
Il virus della Rosolia in particolari casi pu provocare infezioni croniche: si tratta della Rosolia congenita; il
virus in questo caso non causa danno direttamente, ma sono gli immunocomplessi, ossia il virus legato
all'anticorpo, che essendo liberi e presenti in elevata quantit in circolo, precipitano nelle cellule e causano
citolisi. Ci pu avvenire intorno al 6 mese di gravidanza: il virus in questo caso non causa danni
organogenetici (in quanto l'organogenesi del feto gi completata), non attacca neanche il sistema
immunitario fetale, che in via di sviluppo, ma causa la produzione di anticorpi anti-virus della Rosolia da
parte del sistema immunitario del bambino, il bambino quindi nascer con la Rosolia congenita, cio con la
presenza di virus replicanti legati agli anticorpi, cio con la presenza di immuno-complessi. Il danno non
Microbiologia - Medicina e Chirurgia polo A 2012/2013 - sbobinature lezioni
121
quindi un danno da citolisi, causato direttamente dal virus, ma un danno indiretto dato dalla formazione
degli immuno-complessi.
INFEZIONE PERSISTERNE CITOTRASFORMANTE
Il virus pu causare una citotrasformazione: trasforma cio la cellula che infetta.
Questi virus possono dare una persistenza a livello neurologico; per esempio, il papovavirus pu persistere
in cellule non permissive del sistema nervoso centrale (gli astrociti), che vengono quindi infettate ma non
ne permettono la replicazione. Nei soggetti immunodepressi, dagli astrociti il virus passa e infetta le cellule
permissive, che sono gli oligodendrociti, e a questo punto si ha l'insorgenza della patologia (la
leucoencefalopatia multifocale progressiva) e conseguente demielinizzazione.
Un'altro esempio di infezione citotrasformante causata dal virus del morbillo, il quale un virus che
normalmente da infezioni acute, ma a distanza di 3-4-5 anni dalla prima infezione, cio dopo aver contratto
il morbillo, il virus pu persistere e a livello del SNV pu dare una panencefalite sclerosante subacuta. Nella
maggior parte dei casi il virus viene completamente eliminato, in pochissimi casi pu persistere a livello del
SN dove da una scarsa replicazione virale, scarsa perch le cellule non sono altamente permissive per la
sua replicazione, persistendo in tali cellule pu portare alla panencefalite. Vi quindi una scarsa presenza di
virus maturo: il virus del morbillo ha infettato il soggetto ma non stato eliminato completamente.
Questa infezione viene definita abortiva per differenziarla dalla produttiva, dove vi invece un'attiva e
costante replicazione dei virioni. abortiva perch non produce tutte le proteine che le servono (le
proteine di matrice, dell'envelope, di fusione), non vengono cio prodotte tutte le proteine che fanno parte
del virione. Vi comunque la presenza del virus, ma i virioni sono privi di determinati accessori. Per
esempio mancano le proteine dell'envelope, cio del pericapside, ci non permette al virus di infettare
agevolmente un'altra cellula e quindi di andarsi a replicare, mancano inoltre le proteine di matrice quindi
l'immediata replicazione del virus non pu avvenire, il virus rimane quindi persistente all'interno della
cellula in un'infezione abortiva. Nella forma produttiva invece vengono rilasciati i virioni completi ( ci che
succede per il virione dell'HIV ,il virus pi studiato nel mondo).
Il virione pu essere a DNA o a RNA; a
livello del citoplasma, l'acido nucleico si
assembla con le proteine del capside: si
viene a creare una struttura che pu
essere un nucleocapside oppure una
struttura chiusa
icosaedrica
con
all'interno l'acido nucleico; se il virus
rivestito,
porta
cio
il
pericapside,generalmente si sposta dal
citoplasma alla membrana plasmatica
dove vengono espresse le glicoproteine
virali che vengono prodotte dalla cellula
ma sono [Link] volta
rivestito,si stacca e esce dalla cellula
(eliminazione del virus x gemmazione) in questo caso non si ha lisi della cellula ma si ha liberazione virale
senza morte cellulare. Solo in rari casi si ha una eliminazione virale per gemmazione con lisi cellulare (per
esempio per l'herpes virus 1 e 2). In questo caso il virus si riveste di pericapside non a livello della
Microbiologia - Medicina e Chirurgia polo A 2012/2013 - sbobinature lezioni
122
membrana plasmatica, ma a livello dell'apparato del golgi o del reticolo endoplasmico , sedi in cui vengono
espresse le glicoproteine virali; il rivestimento avviene all'interno di un vacuolo e solo dopo pu avvenire la
lisi cellulare, cio dopo che il virione completo.
La replicazione dell'HIV: il virus dell'HIV d una replicazione particolare, lenta. un virus a RNA, l'acido
nucleico consiste cio di due tratti di RNA monocatenario in senso positivo a cui legato un'enzima, la
trascrittasi inversa, quindi il virus quando infetta la cellula gi pronto per la sua replicazione e
integrazione. Questa trascrittasi inversa permette la sintesi di un tratto di DNA complementare,dopo di che
si ha la duplicazione di questo tratto di DNA e quindi la formazione del provirus, che viene integrato a
livello del nucleo cellulare in questa forma bicatenaria. A questo punto pu rimanere all'interno della
cellula CD4, che replicandosi, dar origine a cellule figlie infettate da HIV, oppure pu attivare la sua
replicazione: vengono sintetizzati nuovi tratti di RNA, che poi diventeranno il genoma del virus, vengono
sintetizzate le proteine del capside, vengono sintetizzati nuovi enzimi e nuove trascrittasi inverse, avverr
l'assemblaggio , la formazione dei virioni e la liberazione.
Ecco le infezioni persistenti con produzione di virus maturi:
le infezioni persistenti senza produzione di virus maturi sono date dalla famiglia degli herpetici: l'infezione
persiste ma non produce virus: i virus vengono prodotti solo nelle recidive, cio solo quando si riattiva.
Microbiologia - Medicina e Chirurgia polo A 2012/2013 - sbobinature lezioni
123
Lezione 3 DIFFERENZIARE L'INFEZIONE VIRALE DA QUELLA INDOTTA DA ALTRI
MICRORGANISMI
Cercheremo di capire come differenziare un'infezione virale da quella indotta da un altro
microrganismo.
Caso clinico Federica C. anni 38, casalinga.
Madre morta a 58 anni per carcinoma metastatico di origine mammaria; padre vivente ed in apparente
buona salute; 2 sorelle ed un fratello viventi e sani.
2 figli nati a termine da parto eutocico viventi e sani. Ha avuto un aborto spontaneo a 30 anni. Non fuma,
modica bevitrice di alcolici.
Oltre ai comuni esantemi dell'infanzia non riferisce altre malattie precedenti.
6 gg. fa manifestava febbre continua (38 C - 39 C) insorta bruscamente con brividi accompagnata da
intenso mal di gola e difficolt alla deglutizione (disfagia).
All'esame obiettivo la mucosa faringea appare intensamente arrossata e ricoperta nella parte posteriore da
uno spesso essudato che si estende nella zona tonsillare.
Le tonsille sono ingrossate e protrudono. Si apprezza ingrossamento dei linfonodi cervicali.
In seguito la signora riferisce che:
da 3 gg. le condizioni generali sono peggiorate con progressivo aumento del dolore, difficolt alla
deglutizione, torpore.
All'esame obiettivo si apprezza essudato purulento di cattivo odore che ricopre tutta la mucosa faringea. La
tonsilla dx, ingrossata e circondata da mucosa edematosa e tumefatta. La zona
corrispondente del collo appare ingrossata (collo proconsolare), dolente e rigida.
Quello che dovete attenzionare per il momento questa febbre continua, alta (38 C - 39 C) che insorge
bruscamente, con brividi, mal di gola, difficolt nella deglutizione.
Cosa potrebbe essere?
Visitate il paziente. Vedete che la mucosa faringea e le tonsille sono molto ingrossate, ricoperte di pus ed
essudato. Inoltre anche i linfonodi cervicali si presentano ingrossati.
ESAME OBIETTIVO: tutta la faringe arrossata, presente una patina bianca dell'essudato, la tonsilla
molto ingrossata e fuoriesce.
Dopo qualche giorno la paziente peggiora: il dolore e quindi la difficolt nella deglutizione
aumentano; inoltre la paziente manifesta un altro sintomo che il torpore. Avete visto che ha
essudato purulento, nella visita avete percepito il cattivo odore. La tonsilla fuoriesce, ingrossata.
La zona che corrisponde a questo ingrossamento viene definita collo proconsolare, molto dolente e
rigida.
A questo punto che ci fate? Che facciamo? Facciamo un tampone faringeo e andiamo anche a raccogliere
quel pus, quell'essudato. E la richiesta che fate qual ? Cosa sospettate a questo punto?
Un'infezione virale o un altro tipo di infezione? Prima delle analisi dobbiamo farci un'idea per
cercare di indirizzare e di chiedere le analisi specifiche.
Facciamo un tampone, andiamo a prendere questo essudato e facciamo una richiesta per l'esame
batteriologico con antibiogramma. Dopo 48 ore circa, dall'essudato, cominciano a crescere queste colonie
di Streptococco Pyogenes.
Sul vetrino (all'esame batteriologico), inoltre, possibile vedere che associato allo Streptococco Pyogenes
troviamo una flora anaerobica, ci sono altri batteri di tipo anaerobico. Dall'antibiogramma andiamo a
valutare a quale antibiotico sensibile e lo
somministriamo alla paziente e dopo qualche giorno la signora guarisce completamente.
Quali sono i criteri che vi hanno portato a questa diagnosi?
FATTORI CRITICI
Microbiologia - Medicina e Chirurgia polo A 2012/2013 - sbobinature lezioni
124
febbre alta e continua;
essudato presente a livello della faringe;
il peggioramento delle condizioni generali che si manifestato dopo qualche giorno.
Alla fine nella cartella clinica della signora metteremo che affetta da una faringotonsillite data da batteri
GRAM + (perch abbiamo isolato lo Streptococco pyogenes),
associati a questi batteri abbiamo anche una flora anaerobica che quella che ha causato il
peggioramento di quella situazione (stato di torpore), riconosciuta facilmente dall'esame obiettivo, dal
cattivo odore emanato. Questi sono alcuni segni che vi dovrebbero portare a pensare a un'infezione
batterica o quantomeno NON virale.
CARATTERISTICHE DIFFERENZIALI DI MASSIMA TRA L'INFEZIONE VIRALE E QUELLA SOSTENUTA DA ALTRI
MICRORGANISMI.
INFEZIONE VIRALE:
Febbre di breve durata, in genere senza brividi, spesso bifasica;
Generalizzazione (infezione generalizzata e in seguito localizzata in un organo);
Localizzazione di organo (meningite, miocardite, ecc);
Mancanza di suppurazione e ascessualizzazione;
Il virus non colpisce mai l'interstizio ma sempre la cellula.
Se l'episodio dura pi di un paio di settimane (2/3) sicuramente non un'infezione virale.
Questi sono dati che vi possono dare un'idea, criteri che vi possono indirizzare nella ricerca dei dati di
laboratorio. Quando fate una richiesta di analisi, mandate il campione in laboratorio, ma non potete
richiedere una ricerca a tappeto su tutti i batteri presenti, dovete indirizzare sempre voi i colleghi del
laboratorio, in base a quello che sospettate. E in base a che cosa indirizzate la vostra richiesta? In base alla
sintomatologia, in base
alla biologia di quello che state sospettando. Ad es. a livello della faringe (in questo caso) non potrete
andare, generalmente, a trovare un virus o un batterio di natura fecale.
La presenza di pus e essudato sono sintomi, segnali di un'infezione batterica. Quando c' la presenza di
molto essudato quasi sicuramente un'infezione batterica, non troveremo un virus. E questo perch in
un'infezione virale manca sempre la suppurazione e l'ascessualizzazione, non da dei focolai infiammatori, in
quanto i virus non colpiscono l'interstizio, ma vanno direttamente alle cellule, penetrando al loro interno.
Generalmente dopo un'infezione acuta da virus, l'agente responsabile viene completamente eliminato
dall'organismo (non esiste una flora virale residente, come succede per i batteri e alcuni miceti).
Non ha alcun senso una flora virale, il virus se entra deve infettare, replicarsi a livello della cellula, dentro la
cellula, non pu risiedere.
Solo in alcuni casi, il virus pu persistere anche per tutta la vita nell'organismo ma solo e sempre associato
a delle cellule (all'interno della cellula), dando un' INFEZIONE PERSISTENTE.
Il virus, finch si trova all'interno della cellula, non potr mai essere attaccato dagli anticorpi.
Quindi una risposta umorale, anticorpale nei confronti del virus non efficace, perch gli anticorpi
(essendo il virus stazionario all'interno della cellula) non possono entrare all'interno della cellula, quindi
possono attaccare il virus solo ed esclusivamente quando questo fuori dalla cellula.
Per i virus che si trovano all'esterno della cellula gli anticorpi funzionano benissimo.
La risposta immunitaria umorale (anticorpi) poco efficiente nelle infezioni virali
I virus vengono sequestrati rapidamente all'interno della cellula
Gli anticorpi non penetrano all'interno della cellula.
Le infezioni virali non sono sensibili al trattamento con antibiotici, perch antibiotici interferiscono
selettivamente su componenti della cellula batterica o su tappe del metabolismo batterico (per esempio
Microbiologia - Medicina e Chirurgia polo A 2012/2013 - sbobinature lezioni
125
sulla produzione della parete batterica) ma non agiranno mai sul virus, non agiranno mai sulla funzione
cellulare (sulla replicazione). Quindi il virus inattaccabile, resistente alle molecole antibiotiche.
IL VIRUS NON E' UNA CELLULA E NON HA UN METABOLISMO SUO, AUTONOMO, ma utilizza quello della
cellula.
Ecco perch si deve fare una diagnosi differenziata. Per il virus dell'influenza non c' bisogno che
somministro l'antibiotico perch tanto non serve a niente, anzi si fa pi danno che altro perch
distrugge la flora batterica, e pu creare delle resistenze. Quindi bene non utilizzare l'antibiotico
nell'immediatezza della sintomatologia, ma utilizzare l'antibiotico successivamente nel momento in cui ci
sono dei sintomi ben precisi di una superinfezione batterica, quindi produzione di muco e di pus, febbre che
si protrae nel tempo e si innalza come temperatura; in quel caso bene iniziare a dare antibiotico (ma solo
SUCCESSIVAMENTE).
PATOGENESI VIRALE: processo tramite il quale l'infezione virale porta alla malattia.
Quindi dobbiamo valutare il rapporto tra l'infezione/malattie: sono sempre due termini che si
riferiscono a due stadi ben precisi, distinti e separati l'uno dall'altro (pu essere che anche se c' l'infezione
pu non esserci la malattia).
"INFEZIONE" quel processo che permette al virus il suo ingresso nell'organismo e pu essere senza
sintomi o con dei sintomi di tipo aspecifico, non correlati al virus, transitori e locali.
"MALATTIA" invece quando il virus raggiunge gli organi bersaglio e causa quei segni e quei sintomi che
sono associati alla malattia, quei sintomi localizzati.
L'esito di un'infezione virale (abbiamo visto che l'infezione virale si esplica in due fasi: prima infezione, cio
l'ingresso del virus nell'organismo e solo successivamente nella cellula) dipende da:
superamento delle barriere dell'organismo: mucose, ecc;
dalla natura dell'interazione virus-ospite;
dalla risposta immune dell'ospite, se il soggetto risponde autonomamente all'infezione;
il ceppo virale (per valutare la natura del virus - se un ceppo altamente virulento);
la consistenza dell'inoculo (se entra un virione non succede niente, ma se entra un'altra
carica virale sicuramente si verificher un'infezione).
Le condizioni generali di salute della persona infettata, queste determinano la gravit, la
durata della malattia e quindi anche se l'organismo riesce a rispondere autonomamente
all'infezione virale.
Per dobbiamo anche tener presente che una risposta di tipo specialmente immunitario spesso pu essere
anche uno dei fattori che scatena la patogenesi dell'infezione.
VIE D'INGRESSO DI UN'INFEZIONE VIRALE, di un virus:
- Vie respiratorie. Paramyxovirus, virus dell'influenza, picomavirus,
rhinovirus, enterovirus, picornavirus, virus della
varicella zoster, ecc (tutti virus che generalmente entrano per via respiratoria,contatto diretto inalatorio)
- Via oro-fecale. Picornavirus, rotavirus
Come vedete alcune famiglie virali hanno la stessa metodica di trasmissione (picornavirus, rhinovirus, ecc)
proprio per questo importante conoscere la biologia del virus (come entrano, come si replicano e dove
vanno). I picornavirus, per esempio, possono entrare durante la respirazione ma generalmente entrano per
via oro-fecale (per via oro-fecale si intende per ingestione), si replicano a livello enterico (appartengono alla
famiglia degli enterovirus), ma non danno patologia a questo livello, poich vengono diffusi per via ematica,
per via linfatica, e vanno a colpire gli organi bersaglio che sono diversi dal sito di penetrazione ( sistema
nervoso centrale, fegato, milza, miocardio,ecc) quindi danno della patologie localizzate e distanti dal punto
di ingresso, e spesso potrebbero anche non essere
Microbiologia - Medicina e Chirurgia polo A 2012/2013 - sbobinature lezioni
126
correlati perch difficile correlare una miocardiopatia con un'infezione da enterovirus. Perch la
correlazione in virologia quando nel posto dove si ha la patologia, dove si ha il danno, si deve isolare il
virus. La correlazione causa-effetto in questi casi molto difficile, ma si pu fare.
Via oro-fecale significa via alimentare, per ingestione, quindi hanno questa via di ingresso.
- Per contatto diretto (tramite lesioni, saliva,oggetti contaminati)
Troviamo tutta la famiglia dei virus dell'herpes (herpes simplex), rhinovirus, paxvirus,
adenovirus
- Zoonosi (animali, insetti). Generalmente sono i virus pi pericolosi. Togavirus (a), flavivirus, orbivirus, virus
della rabbia.
- Attraverso il sangue (mediante trasfusioni, contatto diretto con il sangue)
HIV, HTLV-1, virus dell'epatite B e C, citomegalovirus.
- Attraverso rapporto sessuale. Tutti i virus che vengono trasmessi per via ematica (HIV, HTLV, ecc...), virus
dell'herpes simplex, papilloma virus umano
- Trasmissione materno-fetale. Virus della rosolia, cytomegalovirus, parvovirus
B19, echovirus, virus dell'herpes simplex, virus della varicella zoster
- Genetica (patologie trasmissibili dal punto di vista genetico). Prioni, ed alcuni Retrovirus.
"PRIONI" proteine che hanno la capacit di duplicarsi, di replicarsi, di moltiplicarsi (cosa molto strana,
perch per le nostre conoscenze sappiamo che l'informazione va dal DNA all'RNA, e sono a questo punto
porta alla proteina; in questo caso non cos) si accumulano in aggregati macroproteici e provocano
malattie degenerative.
"VIROIDE" semplice acido nucleido (RNA) capace di replicarsi ma non dar mai patologie.
I viroidi sono RNA in grado di replicarsi, i prioni sono proteine in grado di replicarsi di auto-replicarsi,
sovvertendo dunque i dogmi della biologia.
PATOGENESI DELL'INFEZIONE VIRALE
1. Impianto, ingresso del virus nell'organismo;
2. Diffusione, inizio dell'infezione al sito primario (punto in cui il virus entra);
3. Disseminazione, che corrisponde al periodo di incubazione (asintomatico o prodromico, e quando ci
sono i sintomi questi possono essere aspecifici);
4. Eliminazione, vera sintomatologia. Quindi il virus ha gi colpito l'organo bersaglio, e si sta replicando
nell'organo bersaglio causando danni, e dunque la sintomatologia vera e propria.
A questo punto il virus entrato nell'organismo. Dopo aver infettato l'organismo deve avvenire l'infezione
della cellula.
TIPI DI INFEZIONE VIRALE A LIVELLO CELLULARE come avviene l'infezione cellulare?
Cellula permissiva : possiede dei recettori che vengono riconosciuti dal virus e fornisce il
complesso biosintetico per sostenere l'intero ciclo di replicazione virale;
Cellula non permissiva (localizzate solo in alcuni organi): non possiede recettori, antigeni di superficie,
riconoscibili dal virus, ma anche se li dovesse possedere il virus non si replicherebbe a livello citoplasmatico
e nucleare perch la cellula non permette la replicazione di un particolare ceppo virale, perch non
possiede alcun complesso adatto affinch possa avvenire la replicazione virale;
Cellula semipermissiva : presenta gli antigeni in superficie riconoscibili dal virus e
permette di sostenere solo alcune, ma non tutte, le fasi della replicazione virale (otterremo virus incompleti
alla fine).
Microbiologia - Medicina e Chirurgia polo A 2012/2013 - sbobinature lezioni
127
Quando il virus colpisce una cellula non permissiva, possiamo avere un'infezione di tipo abortivo, cio non
si ha produzione virale poich il virus non si pu replicare; anche se il virus dovesse entrare perch
riconosce degli antigeni della cellula, una volta dentro NON si pu replicare. L'infezione virale avviene solo
nelle cellule permissive.
INFEZIONE CHE COLPISCE UNA CELLULA NON PERMISSIVA
Infezione di tipo abortivo non si ha duplicazione virale, il virus non si pu replicare e non c' nessun effetto
sulla cellula. Il virus anche se entra perch la cellula possiede dei recettori che vengono riconosciuti dal
virus, questo non si lega perfettamente e verr eliminato dall'apparato del Golgi della cellula.
Infezione di tipo citolitica si ha la massima produzione di virus e porta
quasi sempre a morte la cellula.
Infezione PERSISTENTE:
1." Produttiva": produzione di virioni, morte per senescenza e non per lisi da parte del virus;
2. "Latente": il virus persiste all'interno della cellula ma non si ha produzione di virioni e di
conseguenza la cellula non manifester alcun effetto;
3." Trasformante": differenziata tra un RNA virus da un DNA virus. Generalmente da quella data da DNA
virus non si ha una produzione virale ex novo, ma porta ad un'immortalizzazione della cellula. Lo stesso
vale negli RNA virus, si ha l'immortalizzazione della cellula, ma in questo caso si ha la produzione di nuovi
RNA virus.
.
*Immortalizzazione: la cellula diventa immortale, la cellula viene trasformata in una cellula
tumorale, si replica incondizionatamente, si duplicher sempre, a meno che non intervenga
un fattore esterno che la pu bloccare, ma dal punto di vista citologico la cellula non si
bloccher mai nella sua duplicazione. La cellula normale si duplica arrivata a un periodo
della sua crescita (MEIOSI, MITOSI, ecc) da una cellula madre per ottenere 2 cellule figlie e
cos via. Ma quando avviene questo, a livello nucleare la cellula deve dividere
perfettamente il suo corredo genetico, si divider, perch lo stesso corredo genetico deve
andare equamente nelle cellule figlie, dunque per la duplicazione di questo corredo
genetico possono verificarsi degli errori di trascrizione. Quando avvengono questi errori di
trascrizione una cellula normale cerca di correggerli (addirittura, se sono degli errori molto
gravi, la cellula blocca la sua duplicazione, se non li pu correggere va incontro a morte
cellulare programmata - apoptosi). Questo meccanismo di correzione gestito a livello
nucleare: sono i geni cellulari che comandano o meno la riparazione. Questi geni se non riescono a
modificare e/o a bloccare questa modificazione la cellula va incontro a duplicazione, di conseguenza,
significa che la cellula diventa immortale, si duplicher di continuo, portandosi appresso tutti gli errori di
trascrizione, una cellula modificata. Generalmente il nostro corredo cromosomico diploide (2n), per
una cellula trasformata non sar mai diploide, avr un corredo di 3n, 6n e cos via (corredo poliploide).
TIPI D'INFEZIONE VIRALE:
1. ABORTIVA (fallimento) per l'economia virale un fallimento, il virus non riuscito a
infettare la cellula e in ogni caso non riuscito a replicarsi; la sorte a cui va incontro che
viene eliminato immediatamente, va incontro alla scomparsa;
2. LITICA (morte cellulare) il virus riuscito a replicarsi, a infettare quindi nuove cellule;
3. PERSISTENTE infezione senza la morte cellulare in alcuni casi, perch nella persistente
Microbiologia - Medicina e Chirurgia polo A 2012/2013 - sbobinature lezioni
128
cronica non si ha lisi della cellula ma si ha, invece, la produzione di nuovi virioni, anche se
lentamente ma ci sono; nelle latenti sicuramente non si ha replicazione virale ma solo la
sintesi di alcune proteine, alcuni enzimi che permettono la latenza che fungono da tramite
tra l'acido nucleico virale e l'acido nucleico della cellula dove il virus in latenza;
4. LENTE;
5. TRASFORMANTI;
ESITO DELL'INFEZIONE
TRASFORMAZIONE pu avvenire in diversi modi, quella pi classica quella che il
genoma, l'acido nucleico virale si integra con il genoma cellulare e ne altera l'espressione: in questa
maniera l'acido nucleico cellulare (2n) aggiungendo un tratto di acido nucleico virale non pi 2n ma
trasformato, diventa poliploide, cio ha dei geni in pi che sono quelli virali. Il ciclo cellulare non pi
regolato. Oppure la trasformazione pu avvenire mediante il blocco dei geni di controllo cellulare da parte
del virus;
LITICA il virus si replica, la cellula muore ( per esempio nel caso dell'influenza); il virus
dell'influenza entra, si replica a livello cellulare, lisa la cellula, il virus fuoriesce, porta la
cellula a morte o lisando o per gemmazione ma la cellula va sempre incontro a morte e
successivamente infetta le cellule vicine. Il virus viene eliminato e le cellule ritornano
normali;
PERSISTENTE possiamo avere una lenta replicazione del virus all'interno della cellula, di
conseguenza la cellula non muore ma porta il virus e lo fa replicare lentamente (avremo in questo caso le
cosiddette infezioni croniche, epatiti - il virus persiste all'interno
degli epatociti e si replica lentamente ma non li porta a morte);
LATENTE, data dall'herpes come rappresentante, il virus permane nella cellula in uno stato silente
(sottoforma di acido nucleico), da cui si riattiva saltuariamente (la maggior parte dei virus che pu
permettersi questo sono virus a DNA, ed alcuni a RNA);
NON PRODUTTIVA il virus non si replica, la cellula non suscettibile all'infezione.
Quindi non ha nessun tipo di danni.
PROGRESSIONE DELLA MALATTIA, DELL'INFEZIONE
1. INFEZIONE: il virus entra e comincia a crescere nell'ospite, il virus si sta replicando e se le
cellule sono permissive, si ha una grossa produzione di virioni completi, pronti ad andare a
infettare altre cellule;
2. PERIODO D' INCUBAZIONE : periodo in cui il virus si sta replicando, quindi aumenta la sua
concentrazione nell'ospite. Periodo compreso tra l'infezione (quindi il momento in cui il virus entrato) e la
comparsa dei primi sintomi specifici;
3. FASE PRODROMICA: si possono manifestare ancora sintomi NON specifici (febbre, sintomi comuni anche
ad altri tipi di patologie non solo infezioni);
4. PERIODO ACUTO: sintomatologia conclamata e l'esplosione della malattia (picco della
malattia e dei sintomi specifici);
5. PERIODO DI DECLINO: diminuizione dei sintomi e risoluzione dell'infezione. Tutti i virioni
ancora presenti vengono eliminati, o quantomeno stanno scomparendo dal circolo
(se un'infezione di tipo latente);
6. CONVALESCENZA: periodo di recupero totale dell'organismo.
"PERIODO D' INCUBAZIONE" periodo compreso tra l'infezione e la comparsa dei sintomi. Nelle infezioni
virali generalmente un periodo molto variabile, dipende a che tipo di infezione andiamo incontro. Per
Microbiologia - Medicina e Chirurgia polo A 2012/2013 - sbobinature lezioni
129
alcuni virus il periodo di incubazione pu essere di un paio di giorni, ma di altri di alcuni decenni. Nel
periodo di incubazione non c' una sintomatologia chiara, specifica ma tutti segni di tipo aspecifico.
Alcuni esempi:
Influenza 1-2 giorni
Malattie da raffreddamento 1-2 giorni
Herpes simplex 5-8 giorni
Poliomielite 5-20 giorni
INFEZIONE ACUTA - (presenza del virus, manifestazione della malattia, eliminazione del virus, guarigione).
Alcune infezioni acute possono avere degli strascichi nel tempo: classico esempio quello del morbillo che
dopo aver dato la classica manifestazione acuta, a distanza di anni pu dare anche un episodio di malattia
abbastanza grave. Da che cosa dato, considerando che il virus del morbillo un virus caratteristico da
infezioni acute? La seconda patologia viene data a livello del sistema nervoso, quindi? Secondo voi cosa pu
essere successo? Anche se un virus che d infezioni acute e non dovrebbe rimanere, rimane a livello del
sistema nervoso in cellule semipermissive, cio che hanno permesso al virus una lenta replicazione o una
replicazione incompleta. Una volta che arrivato a livello del sistema nervoso centrale, invece di essere
eliminato definitivamente, come nella maggior parte dei casi di morbillo, rimane a infettare delle cellule
semipermissive che gli hanno permesso una lenta replicazione e di tipo incompleto, che una volta
manifestata a distanza di anni causa la patologia vera e propria conclamata. Tra virgolette una latenza, ma
non una latenza.
Mentre un'infezione di tipo LATENTE la possiamo classificare come un susseguirsi e un manifestarsi di
infezioni acute. Esempio della varicella zoster - Prima infezione, la varicella, il virus si latentizza a livello del
sistema nervoso centrale, quindi il suo acido nucleico viene conservato a livello dei neuroni in forma
episomale sull'acido nucleico cellulare, non viene integrato. Dopo di ch stimoli esterni o interni
all'organismo, possono provocare la manifestazione dello zoster. Mentre la varicella un' infezione diffusa
generalmente a tutto il corpo, lo zoster un'infezione localizzata,
cio il ritorno del virus, attraverso i neuroni localizzato solo a livello dei dermatomeri innervati da quei
neuroni; non a tutti i dermatomeri, ma solo a quelli innervati dai neuroni che presentano il virus in latenza.
INFEZIONE CRONICA - non c' la scomparsa del virus, per come vedete (il professore si riferisce a dei
grafici delle slides) l'episodio di malattia pu anche essere breve, quindi per questo non dobbiamo
associare mai un'infezione cronica ad una malattia cronica. Come vedete in questo caso, l'epatite B pu
dare un esempio sia di un'infezione acuta ma anche essere esempio di un'infezione cronica, in quest'ultimo
caso non c' una attiva replicazione del virus e una notevole diffusione del virus, ma c' la presenza dei suoi
antigeni, cio vengono riconosciuti, il virus s replica lentamente a livello degli epatociti o che nel tempo a
cicli si replica attivamente.
Possiamo avere un altro tipo di infezione cronica, dove la presenza del virione, del virus, dei suoi antigeni
protratta nel tempo e solo alla fine abbiamo la malattia conclamata.
INFEZIONI LENTE - dove possiamo considerare un lento, un lungo periodo di incubazione, c' una crescita
virale che cresce con il tempo, non come una cronica tardiva che c' gi un'alta carica virale in circolo,
solo che la patologia la dar solo successivamente, dopo aver causato dei danni nell'organo colpito.
L'infezione lenta rappresentata da Papovavirus JC, dove la malattia si manifester a distanza di tempo dal
momento in cui il virus entrato nell'organismo.
INFEZIONI LITICHE segni macroscopici:
Microbiologia - Medicina e Chirurgia polo A 2012/2013 - sbobinature lezioni
130
La replicazione del virus nelle cellule infettate provoca la lisi cellulare che pu andare da qualche ora ad
alcuni giorni (come per le encefaliti varie, virus dell'influenza, poliovirus) e di queste manifestazioni noi ce
ne possiamo accorgere o in vitro o in vivo.
In vitro (andando ad infettare colture cellulari, tappeti cellulari, suscettibili con un campione patologico ):
1. Lesioni di tipo degenerativo (virus senza pericapside);
2. Effetto di tipo sinciziale (formazione di sincizi e policariociti per fusione delle cellule infette), quando
siamo in presenza di virus con pericapside.
Perch c' questa differenza tra virus rivestiti da pericapside e virus nudi? Perch danno questo effetto
citopatico differente? Il sincizio la fusione delle membrane cellulari che possono mantenere ancora la
morfologia, quindi formare delle cellule multinucleate se si fondono e quindi le membrane diventano un
tutt'uno oppure possono mantenere la morfologia normale ma queste cellule sono aggregate le une alle
altre (poliocariociti). Ma perch c' questa differenza? Il virus quando rivestito di pericapside (esso di
natura glicolipidica e deriva dalla membrana plasmatica ecco perch avviene la fusione, perch
generalmente sulla membrana cellulare vengono espressi degli antigeni virali, delle proteine indotte quindi
di conseguenza, agglutinano, legano, due pericapsidi) e di conseguenza legano due membrane cellulari
infettate.
In vivo (generalmente se arriva una biopsia, un qualcosa diretto dell'infezione, del materiale dove gi c'
stata l'infezione, possiamo andare a vedere su questo tessuto, direttamente preso dall'organismo infettato,
mentre in vitro, le cellule del tappeto cellulare le abbiamo messe noi, abbiamo messo noi anche il campione
patologico sopra per vedere se c'era la presenza del virus, in questo caso andremo a vedere le
degenerazioni cellulari in loco):
1. Degenerazione delle cellule infette, vacuolizzazione, coilocitosi (trasformazione della
morfologia di alcune cellule), degenerazione spongiforme e nucleare;
2. All'interno delle cellule andremo a cercare la formazione di corpi inclusi che a secondo delle tecniche di
colorazione ci aiutano a fare una diagnosi immediata: corpi del Negri, che troviamo con il virus della rabbia
(generalmente fatta su biopsia post mortem, quindi in tessuto nervoso), corpi del Guarnieri (Poxvirus),
corpi del Cowdry (virus dell'Herpes).
[Slides effetto citopatico in vitro, dato dall'Herpes]
Effetto citopatico in vitro, quindi siamo in presenza di una coltura cellulare da laboratorio, infettata con un
campione patologico. Quale campione patologico pu essere preso se si tratta di Herpes? Liquido
contenuto nelle vescichette (liquido che di sicuro non pus, perch se cos fosse si tratterebbe di
un'infezione batterica) con qualche cellula di sfaldamento sul labbro (tipico segno dell'herpes), non si tratta
di pus, perch questo si forma solo in presenza di infezione batterica, e se fosse presente nelle vescichette
saremmo in presenza di una superinfezione batterica. Preso questo liquido lo andiamo a infettare su queste
cellule: quel liquido contiene alte concentrazioni di virus libero e infettante, perch le cellule sottostanti
hanno prodotto e hanno permesso la replicazione del virus che poi viene eliminato in quest'essudato che
viene trattenuto da questa vescichetta. Questo essudato viene utilizzato per fare la diagnosi, viene
posizionato sul tappeto cellulare, si da il tempo di infettare, dopo di che andremo a vedere questo effetto.
Che tipo di effetto ? Effetto di tipo sinciziale, poich in ogni caso il virus un virus rivestito di pericapside e
di conseguenza le membrane cellulari delle cellule infettate si uniscono le une alle altre, per in questo
caso ogni cellula mantiene la sua morfologia, sono tante cellule legate le une alle altre.
Un altro tipo di effetto (slide) da A a B che tipo di effetto ? Anche questo di tipo citopatico, anche questo
quindi un effetto in vitro .Cosa vedete di diverso o di strano? Cosa apprezzate? In A che cosa c'? Si
apprezza un tappeto cellulare non infettato, in B lo stesso tappeto cellulare, infettato, con l'inizio
Microbiologia - Medicina e Chirurgia polo A 2012/2013 - sbobinature lezioni
131
dell'effetto citopatico. E che tipo di effetto citopatico vedete? Di tipo degenerativo, le cellule vanno a
morte, cambiano di morfologia, diventano tondeggianti e vanno incontro a morte (effetto degenerativo
avanzato, non sono rimaste cellule integre).
E questo che tipo di effetto ? Di tipo sinciziale per con la fusione delle membrane, infatti ci sono molti
nuclei ma non c' la differenziazione tra una cellula e l'altra. Questo per quanto riguarda in vitro e questo
per quanto riguarda in vivo, sono delle sezioni di tessuto quindi provenienti dalla biopsia, provenienti
direttamente dall'organismo infetto. Sezioni di tessuto colorate, manifestazione dei corpi del Negri (rabbia).
Queste sono le inclusioni del Cowdry, quindi questo un pezzo del tessuto che porta le cellule infettate dal
virus (cellule epiteliali che portano il virus al loro interno corpi del Cowdry), oppure con questa
manifestazione il nucleo cellulare appare molto addensato.
Questi sono i corpi del Negri in caso di rabbia. Corpi del Guarnieri.
Una manifestazione herpetica, il colore biancastro non dovuto al pus ma al liquido che c' all'interno.
Questo tipo di infezioni sono latenti, e quando siamo in presenza di infezioni latenti spesso, ma per fortuna
non tanto spesso, possiamo anche correre il rischio che si trasformi in infezione trasformante. Per l'herpes
questo molto raro, l'herpes virus di tipo 1, 2 di tipo 3, la varicella e il cytomegalovirus, danno una latenza
a livello del sistema nervoso centrale e qui l'acido nucleico del neurone non si integra con l'acido nucleico
cellulare ma si lega solo a livello episomiale. Ma teniamo presente che alcuni virus della famiglia herpetica
possono dare trasformazioni: questi sono herpes di tipo 8 (sarcoma di Kaposi in soggetti affetti da HIV) e il
virus di Epstein-Barr (EBV) (responsabile di una patologia blanda la mononucleosi, anche responsabile del
linfoma di Burkitt e carcinoma rinofaringeo), danno quindi un'infezione latente ma possono dare anche
un'infezione trasformante.
Per le infezioni trasformanti abbiamo virus oncogeni: virus a RNA, che si presentano come dei veri e propri
geni oncogeni, una volta che infettano la cellula la trasformano. Altri virus come HPV si comportano nel
bloccare e quindi liberare l'attivit di alcuni geni cellulari che controllano le modificazioni cellulari (p53 e
Rb, proteine cellulari che controllano la replicazione della cellula e una volta attive mantengono questo
equilibrio a livello cellulare riposo e replicazione ma una volta che sono liberate o bloccate, l'equilibrio
viene spostato, in fase replicativa e la cellula si replica incondizionatamente non c' alcun gene che riesce a
bloccarla).
E questi sono alcuni esempi di infezioni persistenti (scrapie) , molte di queste sono date anche da prioni
cio particelle proteiche che sono in grado di infettare, quindi possono essere trasmissibili da una cellula ad
un'altra e replicanti, quindi si possono replicare.
Lezione 6 Definire la natura dei virus
Il virus non una cellula. La domanda che storicamente ci si posti la seguente: i virus possono essere
considerati degli esseri viventi? Secondo i naturalisti, quindi da un certo punto di vista, i virus non sono
esseri viventi perch non si replicano autonomamente e questo in effetti vero perch dobbiamo tener
conto che un virus per replicarsi deve essere sempre allinterno di un substrato vivente, deve cio avere un
substrato vivente che gli permetta di replicarsi, non lo possiamo considerare una cellula autonoma. In
ogni caso i virus, anche se non si replicano autonomamente ma hanno bisogno della cellula, sono stati in
grado di arrivare fino ai nostri giorni (sopravvivendo e replicandosi) e probabilmente ci sorpasseranno.
Quindi in realt possiamo definirli in molti modi (parassiti o altro) ma comunque viventi!!!
I virus sono organismi estremamente piccoli non rilevabili al microscopio ottico, ma solo con quello
elettronico. In particolare il virione intero mostrato dalla trasmissione, invece il virus legato alla
cellula o al tessuto che sta infettando dalla scansione. Insomma con quello ottico vediamo solo le
Microbiologia - Medicina e Chirurgia polo A 2012/2013 - sbobinature lezioni
132
modificazioni cellulari indotte dal virus. Con il microscopio ottico si ha una risoluzione che va dal
millimetro al micron, con quello elettronico da 10 a 10 invece Raggi x e risonanza vengono usati
per vedere ci che pi piccolo di un virus. Le dimensioni di un virus vanno dai 20 30 nanometri ai
300 circa. I poliovirus della famiglia dei picornavirus sono i pi piccoli virus che conosciamo e
scomponendo il nome si ha: pico-RNA-virus ovvero virus a RNA pi piccoli!
Nell immagine possiamo notare la differenza
tra un batterio e alcuni virus. Il pox virus il
virus piu grosso che attualmente conosciamo
e si avvicina molto al pi piccolo batterio
noto la Chlamydia.
I virus possono essere considerati come
bioparassiti endocellulari obbligati in quanto
mancano delle strutture, tipiche delle cellule,
necessarie per la sintesi proteica e i vari
processi metabolici. Sono privi di Ribosomi,
Mitocondri, Apparato di Golgi, Reticolo
endoplasmatico
e di
conseguenza
si
moltiplicano su substrati viventi, per esempio
colture cellulari, uova embrionali , animali, e solo cosi manifestano il loro effetto citopatico.
Un virus immesso in un uovo embrionale va a danneggiarne gli annessi quali il liquido amniotico.
Un virus pu essere considerato una aggregazione di macromolecole della materia vivente.
Aggregazione perch costituito da un solo tipo di acido nucleico ( DNA o RNA) e questo rappresenta
anche un metodo per classificarli (virus a DNA e virus a RNA).
Inoltre sono costituiti da proteine di rivestimento articolate in sub unit ( esoni e pentoni )
l
unione di queste proteine costituisce il capside. I vari tipi di acidi nucleici possono essere
morfologicamente a singola catena di DNA, a singola catena di RNA, a doppia catena di DNA,
circolare ecc
Microbiologia - Medicina e Chirurgia polo A 2012/2013 - sbobinature lezioni
133
Lacido nucleico racchiuso in una sorta di contenitore che il capside, formato da esoni e pentoni:
generalmente i pentoni sono proteine che si trovano ai vertici di queste strutture.
La stretta unione dellacido nucleico con le proteine del capside forma il nucleocapside. Se questa unione
non cos stretta si definisce core + capside. Alcuni virus possono presentare un ulteriore rivestimento
di natura cellulare (doppio strato glicoproteico) che dato dal pericapside o envelope.
Le strutture esterne sia nei virus rivestiti che in quelli nudi sono quelle che permettono linfezione. Il
pericapside pu presentare delle strutture esterne di superficie definite spikes, responsabili dell
attacco del virus alla cellula ed al riconoscimento dei recettori cellulari, servono per la fase detta
adsorbimento del virus alla cellula. Nei virus nudi queste strutture si trovano nel capside e devono
essere per forza presenti e attive.
MORFOLOGIA VIRUS HIV
Consideriamo la morfologia di un virus HIV : un virus a RNA rivestito di pericapside.
Il virus porta sempre una proteina legata al suo tratto di acido nucleico, la trascrittasi inversa. Le
proteine non sono strettamente connesse allacido nucleico, ma questo libero dentro il capside.
Il pericapside presenta il doppio strato glicoproteico con dei prolungamenti dati da glicoproteine
natura cellulare (gp120, gp41).
di
Microbiologia - Medicina e Chirurgia polo A 2012/2013 - sbobinature lezioni
134
Lattacco e la penetrazione all interno della
cellula avvengono nel seguente modo: il virus
con la glicoproteina gp120, che la proteina pi
esterna del virione, riconosce il suo recettore
cellulare, il linfocita CD-4 al quale si lega. In
seguito avviene
un piccolo
cambiamento
morfologico della membrana che si allunga e si
dilata in modo da consentire al virus di
coricarsi e riconoscere l altro recettore il CCR-5
per mezzo della gp41, proteina pi interna
rispetto al gp120. A questo punto si ha il
legame con gp 41 e si ha la fusione della
membrana cellulare. In questo modo il capside e
l acido nucleico entrano all interno della
cellula, il pericapside rimane legato alla membrana cellulare. Questo metodo d ingresso per fusione
tipico dei virus dotati di pericapside.
Una seconda modalit d ingresso, che vale sia per i virus con pericapside sia per quelli nudi, consiste
nella formazione di una specie di invaginazione della membrana citoplasmatica che racchiude come
una sorta di fagocitosi il virus intero al suo interno . A questo punto il virus, se ha il pericapisde,
rilascia il pericapside stesso sulla membrana del vacuolo (che della stessa natura lipoproteica) e
successivamente dei lisosomi del vacuolo liberano enzimi proteolitici che scindono il capside e si ha
la fase nota come denudamento del virus seguita dal rilascio di acido nucleico nel citoplasma, fase
detta di eclissi (scomparsa del virus).
Possiamo distinguere 4 fasi:
-ADSORBIMENTO( riconoscimento dei siti recettoriali)
-PENETRAZIONE
-DENUDAMENTO
-ECLISSI (in cui non si pu riconoscere il virus, ma vedremo delle singole proteine nel citoplasma e
qualche tratto di acido nucleico)
-(maturazione completa e rilascio virus)
Ciclo replicativo virale
Una volta che l acido nucleico libero, se RNA di senso positivo si comporta come un RNA
messaggero, andr nei ribosomi e trascriver la sua informazione, verr sintetizzata una proteina
molto lunga, una poliproteina che solo successivamente verr tagliata e dar origine a enzimi,
proteine funzionali e proteine strutturali. Alla trascrizione, gi la cellula ha manifestato qualcosa di
estraneo nella sua membrana, si tratta di glicoproteine o proteine celluleri virus indotte, comandate
dal virus, ma espresse e prodotte dalla cellula sulla sua superficie: non sono altro che gli antigeni
virali. Verranno tradotte le proteine strutturali che daranno origine a proteine strutturali esoniche e
pentoniche e quelle proteine che daranno origine alla formazione del capside. L acido nucleico
verr replicato tante volte e poi si avr il riassemblaggio (riunione tra acido nucleico e proteine del
Microbiologia - Medicina e Chirurgia polo A 2012/2013 - sbobinature lezioni
135
capside) ,maturazione e rilascio del virus. Se il virus che sta uscendo rivestito da pericapside,
non porta a morte la cellula e si sposta a livello della membrana cellulare dove vengono espressi gli
antigeni e viene rilasciato. Un rilascio del genere detto per gemmazione come se nascesse una
gemma dalla membrana citoplasmatica. Invece per i virus non rivestiti da pericapside la cellula andr
incontro a morte, ergo il virus potr uscire per lisi cellulare.
Il ciclo di replicazione dura meno di un ora per molti batteriofagi, 6-8 ore per la famiglia
Picornavirus e pi di 40 ore nella famiglia Herpes virus.
La resa virale durante un ciclo di replicazione variabile, per esempio: cellule infettate con poliovirus
possono dare pi di 100.000 particelle virali per cellula.
I tipi di replicazione virale sono circa 5 e tutti dipendono dal tipo di acido nucleico presente nel
virus. Generalmente i virus a DNA una volta liberati nella cellula formano gli mRNA e conseguente
sintesi delle proteine precoci (non strutturali ma funzionali) che servono per la replicazione dell
acido nucleico originario; poi si ha formazione di nuovi mRNA tardivi con sintesi di proteine tardive
strutturali che daranno origine al capside e infine assemblaggio.
Questo metodo replicativo
caratterizza herpes , pox virus e adenovirus.
Per i virus con acido nucleico a singola catena di RNA di senso positivo abbiamo la presenza di
trascrittasi inversa legata gi all acido nucleico e produzione di un omologo a DNA, duplicazione
di questo tratto di DNA a doppia elica e formazione del provirus, che si pu integrare nel DNA
cellulare. Dopo di che si ha produzione di altri RNA a singola catena, produzione di enzimi,
assemblaggio e maturazione. A questo tipo di replicazione associamo HIV e retrovirus.
Invece quando abbiamo una singola catena di RNA che ha la funzione di RNA messaggero si ha
sintesi di una poliproteina, clivaggio e duplicazione dell acido nucleico. Si tratta di un RNA positivo,
ergo occorrono degli intermedi di senso negativo che fungeranno da stampo per il nuovo genoma
virale. Questo tipo di replicazione tipico dei picornavirus e coronavirus.
I virus con un genoma a singola catena di RNA a polarit negativa si replicano attraverso un
filamento complementare a polarit positiva. Un RNA di senso negativo un portatore
di
informazioni e poco funzionale e viene cosi tradotto in RNA positivi che servono da stampo per
l RNA genomico e in tanti RNA messaggeri che servono per la sintesi proteica. Questo tipo di
replicazione tipica dei paramixovirus (influenza), rabdovirus (rabbia).
Un virus con genoma a doppia elica di RNA, in presenza di RNA polimerasi, dar origine a singole
catene di RNA, che fungeranno da stampo per il nuovo genoma sempre in presenza dellRNA-polimerasi
RNA-dipendente, ed a RNA messaggero, che funger per la produzione delle proteine.
Possiamo dire che ogni virus cambia strategia in base allacido nucleico che porta. I virus non sono i
pi piccoli agenti infettivi, ci sono i viroidi e i prioni altri agenti infettanti e replicanti.
Origine dei virus
Microbiologia - Medicina e Chirurgia polo A 2012/2013 - sbobinature lezioni
136
Come possiamo posizionare i virus nellalbero evolutivo? Da una parte si potrebbe pensare di classificare i
virus come cellule primordiali che si sono evolute e dalle quali poi partita
l evoluzione
(ipotesi evolutiva), oppure i virus
potrebbero derivare da cellule che gi
erano evolute e che sono leggermente
regredite (ipotesi regressiva).
Come si vede dalla diapositiva non ci
possono che essere dei punti
interrogativi.
Unipotesi quindi era quella regressiva,
secondo la quale si riteneva che i virus
fossero stati originati da cellule
complete, il cui acido nucleico avesse
acquistato la
capacit di replicarsi
autonomamente. Si pensava pertanto
che i virus a DNA fossero dei plasmidi o
degli elementi trasponibili, i retrovirus altro non fossero che tratti di retrotrasposoni, che gli altri RNA virus
fossero degli RNA messaggeri.
Unaltra ipotesi invece quella evolutiva, secondo la quale i virus potrebbero essere considerati come la
base dellevoluzione delle cellule, da cui si partiti per avere poi man mano delle strutture organizzate
sempre pi complesse.
. Laltra ipotesi astrofisica dice che originano da comete celesti cadute sulla terra.
Tra le ipotesi quella pi vicina alla realt quella regressiva, perch sappiamo che ci sono costituenti
cellulari che somigliano molto a virus, per esempio, per i virus a DNA, i plasmidi cellulari e batterici che sono
facilmente trasmissibili da una cellula ad un'altra. Per quanto riguarda gli RNA virus di senso positivo
possono essere degli RNA messaggeri cellulari modificati, rivestiti da molecole proteiche, che hanno dato
origine al virus . Ma nessuna di queste teorie stata
confermata e probabilmente mai lo sar!
Simmetria virale
La simmetria virale data dallunione tra la molecola di
acido nucleico e la combinazione con le proteine capsidi:
dalla simmetria virale trae origine una morfologia
differenziata per i diversi virus. Le principali sono la
simmetria elicoidale e la simmetria cubica.
La simmetria elicoidale data da uno stretto rapporto che
esiste tra la molecola di acido nucleico e le proteine. La
molecola di acido nucleico generalmente, nella simmetria
elicoidale, spiralizzata intorno a un cilindro e ogni spira
porta legate le proteine del capside. Questa simmetria si
svolge generalmente intorno a un asse di simmetria, a un
asse principale: questo tipo di virione viene definito
Microbiologia - Medicina e Chirurgia polo A 2012/2013 - sbobinature lezioni
137
nucleocapside, dove c proprio uno stretto rapporto tra lacido nucleico e le proteine del capside.
SIMMETRIA CUBICA Laltra simmetria quella cubica,
dove non esiste pi uno stretto rapporto tra lacido nucleico
e le proteine capsidiche, ma questultime sono unite a
formare le facce di un poliedro che contenga lacido
nucleico. Mentre in precedenza nel nucleocapside lacido
nucleico legato alle proteine capsidiche,
nella simmetria cubica le proteine capsidiche non sono
legate allacido nucleico, ma formano una struttura, un
contenitore poliedrico con tante facce, tante quante ne
bastano per racchiudere e contenere lacido nucleico.
In questo caso non pi presente un asse di simmetria, ma
vi sono diversi assi di simmetria, per cui i virus acquisiscono
diverse morfologie: ogni faccia pu essere data da una
singola molecola proteica o pi molecole.
SIMMETRIA COMPLESSA
La simmetria complessa la terza struttura, la quale rappresenta entrambe le strutture, presenta una
morfologia che pu racchiudere entrambe le simmetrie: infatti leggermente allungato ed come se fosse
icosaedrico al suo interno.
- E il caso ad es. del Poxvirus, cio il virus del vaiolo (il virus umano pi grosso che attualmente
conosciamo)
- Unaltra struttura complessa rappresentata dal batteriofago.
La simmetria virale ci porta alla morfologia virale, infatti:
Una simmetria elicoidale (nucleocapside) generalmente d una morfologia:
- rotondeggiante, caratteristica dei virus influenzali
- bastoncellare, caratteristica del virus del mosaico del tabacco o a morfologia filiforme
- a proiettile, caratteristica del virus della rabbia (Rhabdovirus)
La simmetria cubica, formata da un core (lacido nucleico) pi il capside porta generalmente a una
morfologia:
- icosaedrica, caratteristica degli Enterovirus, Papovavirus, Adenovirus
- a
ruota
di
carro,
caratteristica
solo
dei
Rotavirus
- astro, una morfologia simile agli astri, alle stelle, quindi un capside con diverse punte, caratteristica degli
Astrovirus
La morfologia pu dipendere anche da unaltra struttura, il pericapside, quando questo presente:
-Il pericapside presenta dei prolungamenti e conferisce una caratteristica forma a corona, una morfologia
individuata per i Coronavirus.
Microbiologia - Medicina e Chirurgia polo A 2012/2013 - sbobinature lezioni
138
- gli Arenavirus presentano un aspetto sabbioso non tanto perch loro sono sabbiosi, ma piuttosto perch
portano, trasportano i ribosomi delle cellule sulla loro superficie.
- i Calicivirus presentano una forma di coppa( molto difficile da individuare) dovuta alla presenza di una
depressione sulla loro superficie.
VIRUS NUDO.
PROPRIETA
Resistente ad alte temperature, acidi detergenti, essiccamento.
cellulare.
E rilasciato dalla cellula per lisi
CONSEGUENZA
Facilmente diffuso attraverso oggetti, da una mano a un altra, con polvere o piccole gocce d acqua.
Pu essere essiccato o mantenere l infettivit. Pu resistere alle variazioni di pH e sopportare le
diverse condizioni dell intestino (se entra a livello oro-faringeo e arriva allo stomaco, resiste alle
condizioni acide e arriva allintestino) , pu resistere ai detergenti.
VIRUS CON ENVELOPE
PROPRIETA
Distrutto da acidi, detergenti, essiccamento, calore, modifica le membrane cellulari durante la
replicazione. E rilasciato per gemmazione, non crea lisi cellulare.
CONSEGUENZE
Per essere infettante deve rimanere in ambiente umido; si diffonde con gocce dacqua, secrezioni,
trapianti
d organi, trasfusione di sangue. Non sopravvive a variazioni di pH e quindi nel tratto
gastrointestinale, non uccide la cellula per diffondersi. I virus con envelope sono pi fragili rispetto a
un virus nudo.
Tutto ci importante per la prevenzione.
Consideriamo alcune morfologie:
-Mosaico del tabacco
BASTONCELLO
(che non infetta l uomo ma le piante): forma elicoidale lineare, quindi a
- Il Picornavirus un enterovirus, quindi presenta una morfologia icosaedrica, rotondeggiante
- Per Adenovirus riconosciamo una morfologia icosaedrica del capside, costituito da esoni, con
protuberanze, gli spikes, i pentoni, ovvero gli antigeni pi esterni del virus; non ha pericapside ( virus a
DNA)
- Il Paramixovirus si presenta tutto aggrovigliato, sferico, come un gomitolo di lanae si pu distinguere
anche il pericapside, la parte pi esterna
Microbiologia - Medicina e Chirurgia polo A 2012/2013 - sbobinature lezioni
139
- Il Rhabdovirus il virus della rabbia con la classica morfologia a proiettile con una parte appuntita e una
tronca; si distingue il pericapside
- lHerpes simplex presenta forma icosaedrica con pericapside.
Lezione 7
"Le modalit con le quali avviene la patogenesi delle infezioni virali e come il nostro organismo si difende
dalle infezioni virali."
Vie e modalit di penetrazione.
Abbiamo due tipi di infezione:
Infezione di tipo orizzontale;
Infezione di tipo verticale;
Nellinfezione di tipo orizzontale le vie di ingresso del virus possono essere:
-la barriera cutanea (le superfici corporee) che quando integra unottima barriera nei confronti delle
infezioni virali, quindi il virus non pu attraversarla. Tuttavia il virus usufruisce di altri metodi per
attraversarla, quali per esempio gli eventi traumatici, i morsi di animali e di insetti, le punture di insetti,
lutilizzo di siringhe, qualsiasi mezzo che possa produrre una situazione di continuo tra linterno e lesterno.
-le mucose possono essere anche unottima barriera nei confronti dellinfezione. Tutti gli epiteli
specializzati che rivestono lapparato digerente, le vie respiratorie, le vie genito-urinarie, la congiuntiva.
Queste sono tutte delle barriere che se integre, permettono il blocco dellinfezione virale e non
permettono lingresso del virus nellospite.
Laltro tipo di infezione l'infezione di tipo verticale.
Linfezione trasmessa dalla madre al feto, con il passaggio del virus attraverso la barriera placentare o
attraverso il sangue. Questo tipo di infezione detta anche "endouterina" se avviene allinterno dellutero
o se no linfezione congenita (o endouterina) quando il virus dalla madre attraversa la placenta e arriva al
feto, esempio di questo tipo di infezione, cio di virus che possono attraversare la barriera placentare sono
la rosolia, il cito, lHIV o direttamente attraverso la placenta oppure mediante il passaggio attraverso il
circolo ematico. Linfezione perinatale, linfezione che il bambino acquisisce durante il passaggio attraverso
il canale del parto, al momento del parto, esempi di questo tipo di infezione, oltre allherpes di tipo 2,
possiamo avere gli pneumococchi, i clamidia, gli streptococchi anche di tipo fecale (anzi per la maggior
parte dei casi fecali), escherichia. Linfezione post natale, tutte le infezioni che vengono trasmesse dalla
madre al bambino gi nato, quindi attraverso lallattamento, attraverso il contatto diretto tra madre e
figlio, attraverso la saliva. Sicuramente il taglio del cordone ombelicale, se non fatto sterilmente, pu
causare il tetano e sicuramente quasi tutti i batteri di origine gastroenterica.
Dall'ambiente esterno, attraverso i vari canali di attraversamento dell'infezione o tratto respiratorio, pelle,
tratto uro-genitale, ano, canale alimentare, sono vie che possono permettere un'infezione di tipo virale. E'
evidente che ognuno di queste vie un percorso preferenziale per virus differenti.
TRATTO RESPIRATORIO:
Microbiologia - Medicina e Chirurgia polo A 2012/2013 - sbobinature lezioni
140
Infezione per contatto diretto o per via aerosol, salivare ecc., tutte le infezioni di tipo respiratorio. Questo
tipo di infezioni difficile da controllare, perch queste infezioni si trasmettono troppo velocemente e
troppo facilmente anche in ambienti confinati (facile ambiente di diffusione di questo tipo di infezione),
ma anche in ambienti aperti.
Infezioni di tipo oro-fecale, queste possono essere un po' pi facilmente controllati con una migliore
igiene, mediante derattizzazione, sterilizzazione degli ambienti ecc.
Infezioni di tipo venereo o genitale, sessualmente trasmesse, e questo un fattore molto difficile da
controllare, specialmente per la sanit pubblica, anche se si possono fare delle campagne , per le
campagne devono essere recepite. Quelle che vengono rappresentate nell'immagine vengono definite
come "goccioline di muco", uno starnuto di un soggetto raffreddato, influenzato, pu trasmettere
centinaia e centinaia di virioni che possono resistere anche nell'ambiente esterno, anche per qualche
giorno, i virioni vengono protetti da queste goccioline e arrivano a distanze anche notevoli dal soggetto che
le ha emesse, fino a circa un metro, un metro e mezzo le goccioline pi piccole e leggere, e possono
depositarsi in qualsiasi ambiente e resistere per qualche giorno. La conseguenza la facilit di trasmissione
e diffusione, chiunque passi, infatti, dopo qualche ora, anche se non posizionato di fronte il soggetto,
pu contrarre un'infezione trasmessa da saliva quindi raffreddore, influenza, basta tocchi qualsiasi oggetto
che sia stato contaminato da queste goccioline.
Altre via di trasmissione: il sangue una via molto diffusa. Pu essere trasmesso mediante il sangue,
mediante le trasfusioni, quindi i soggetti politrasfusi sono soggetti a rischio, si possono contrarre infezioni
in ambito operatorio, contaminazioni con teli chirurgici e con ambienti non sterili. Si possono contrarre
infezioni mediante l'uso di siringhe, drogati, persone che fanno utilizzo di sostanze stupefacenti e non
mettono in campo le normali tecniche di igiene, basta cambiare la siringa. Soggetti che fanno dei tatuaggi,
se gli aghi non sono sterili.
I virus che possono essere trasmessi mediante il sangue sono l'epatite, HIV, citomegalovirus (anche se
quest'ultimo d spesso delle infezioni asintomatiche, silenti, per d una latenza enorme, quindi pu
essere facilmente trasmesso anche con il trapianto d'organo.
Altre vie: il rapporto umano imprescindibile, il virus si trasmette da uomo a uomo. Possiamo avere per
anche altre vie di trasmissione come la trasmissione attraverso vettori, attraverso animali, vettori di tipo
zecche e zanzare sono veicoli di infezioni anche pericolose e rare. Un esempio un virus che non un
nemico diretto dell'uomo, perch l'uomo in questo caso un ospite intermedio non voluto dal virus,
perch il ciclo vitale di questo virus rappresentato dall'animale "serbatoio", un vertebrato, ed qui che
si ha la replicazione del virus, il serbatoio naturale del virus (la zanzara non fa altro che far circolare il
virus in altri serbatoi vertebrati e questo il suo ciclo vitale), solo accidentalmente, quando l'uomo si trova
in un ambiente che non il suo o il vettore che si trova in un ambiente non proprio idoneo, pu arrivare
all'uomo e, generalmente, una volta arrivato all'uomo, porta alla chiusura del ciclo vitale del virus, se non
viene diagnosticato in tempo si chiude il ciclo vitale di quel virus portando alla morte dell'uomo.
Nell'economia biologica del virus l'uomo non l'ospite definitivo del virus perch portando a morte l'uomo
porta a morte s stesso e solo accidentalmente noi siamo degli ospiti per questi virus. Altri tipi di virus
utilizzano altri animali come vettori, come trasportatori, e sono animali molto vicini alluomo come gatti e
cani. Il ciclo animale si esplica sempre tra animale vertebrato e animale vertebrato, l'uomo sempre
colpito accidentalmente, quando il cane aggredisce accidentalmente l'uomo, d un morso all'uomo, solo in
quel caso pu trasmettere il virus. Rappresentanti abbiamo la brucellosi, la rabbia, la febbre Q, la febbre
lassa, sono tutte infezioni sia batteriche che virali, che possono essere trasmesse all'uomo, ma solo
Microbiologia - Medicina e Chirurgia polo A 2012/2013 - sbobinature lezioni
141
accidentalmente. La stessa cosa vale quando siamo in presenza di peste, "febbre gialla", il ciclo vitale va dal
ratto al pidocchio, solo quando l'uomo frequenta degli ambienti dove c' la presenza massiccia di topi,
dove si ha avuto un contatto con il topo, si ha il passaggio del virus nell'uomo e quindi l'infezione.
Il virus, generalmente, si moltiplica nel punto di ingresso dell'ospite, solo successivamente, in alcuni casi,
non in tutti, si ha una diffusione dei nuovi virioni attraverso il sangue, attraverso le vie linfatiche, che viene
definita "viremia". Alcuni virus possono direttamente migrare attraverso le fibre nervose e arrivare fino al
sistema nervoso centrale, per il virus riesce in qualche maniera ad arrivare anche in quei distretti che
sono altamente protetti, come il SNC, il fegato, attraverso la placenta, non solo attraverso le terminazioni
nervose, come l'herpes, la latenza dell'herpes. Quando il virus dell'herpes va in latenza non esplica nessuna
funzione patologica, per il virus herpetico anche responsabile di encefalite, di meningite, quindi esplica
una funzione patologica, ma non quando ci arriva attraverso le fibre nervose, la esplica solo quando riesce
ad attraversare le barriere, quindi la esplica direttamente nell'organo, dove si pu replicare e solo in quel
caso esplica la sua funzione patologica, quando ci arriva attraverso le fibre nervose, generalmente esplica
la sua funzione di latenza, il virus rimane latente, ma quando arriva attraverso la barriera veicolato da
macrofagi e da linfociti che ha infettato, i quali non sono in grado di metabolizzarlo e quindi di eliminarlo,
pu esplicare la sua funzione patologica andando a infettare l'organo e andando a replicarsi in loco.
Schematicamente: il virus entra, nel punto di ingresso, che pu essere la cute, le mucose, esplica la sua
replicazione, la prima replicazione, la quale a livello del tessuto linfonodale, regionale e a livello di altri
tessuti, grazie poi agli anticorpi, l'infezione viene localizzata quindi non si ha la diffusione del virus, il virus
successivamente verr eliminato completamente, ma se ci non dovesse accadere, dopo la replicazione
primaria possiamo avere una prima diffusione attraverso la via ematica, la cosiddetta "prima viremia", il
virus diffuso pu arrivare in qualsiasi organo, dove poi sicuramente esplicher una seconda replicazione e
quindi il danno di organi. A questo punto dopo una seconda replicazione possiamo avere una seconda
viremia, sempre attraverso la via ematica, la via linfatica e in questo caso siamo in presenza di una
infezione "disseminata", che potrebbe essere a questo punto difficilmente controllabile.
In presenza di picornavirus, piccoli RNA virus, sono i pi piccoli virus a RNA che conosciamo, che infettano
l'uomo, a questa famiglia appartengono due specie: gli enterovirus e i rinovirus. Hanno una via d'ingresso
preferenziale che quella del cavo orale entrambi. La differenza sta nel fatto che i rinovirus prediligono il
cavo orale, l'orofaringe, per la loro replicazioni e quindi eventualmente per la loro diffusione, gli
enterovirus prediligono l'apparato gastroenterico, si replicano a livello delle placche di Peyer e, una volta
replicati, passano in circolo, la maggior parte dei virioni nuovi viene anche eliminata attraverso le feci, una
parte passa attraverso il circolo e attraverso questo raggiungono degli organi distanti dal punto di ingresso,
quindi sono entrati dalla bocca, si sono replicati a livello dell'apparato gastroenterico ma la loro patologia
la esplicano in organi molto distanti dal punto in cui sono entrati, in cui si sono replicati, gli enterovirus non
sono responsabili di enteriti, ma nella loro seconda viremia gli organi che vanno a colpire sono il cervello,
attraversano la via linfatica ed ematica, attraversano la barriera ematoencefalica e a livello dell'encefalo si
replicano ulteriormente causando encefaliti e paralisi, uno di questi rappresentanti il poliovirus, possono
essere le meningi per quanto riguarda il coxsackievirus, gli ecovirus, possono colpire il fegato per quanto
riguarda l'epatite A, pu essere la pelle per quanto riguarda gli eco e per i coxsackie A, pu essere qualsiasi
tipo di muscolo, preferibilmente il miocardio, per quanto riguarda il coxsackie A e B. Le patologie sono
abbastanza diversificate, in alcuni casi specialmente per quanto riguarda il polio abbiamo la paralisi, una
meningite per quanto riguarda gli eco e i coxsackie, l'epatite per quanto riguarda il virus dell'epatite A, la
malattia di mani e bocca o rash herpangina per quanto riguarda il coxsackie A, e miocarditi e pericarditi per
quanto riguarda i coxsackie A e B e gli eco. Questo percorso che potrebbe sembrare di tipo biologico,
Microbiologia - Medicina e Chirurgia polo A 2012/2013 - sbobinature lezioni
142
conoscere una prima, seconda viremia, un eventuale terza viremia, lo portiamo come esempio per capire
come poter fare una diagnosi di miocardite. Questi virus non danno alcun tipo di problema a livello
enterico, i virus entrano, si replicano, ma non danno alcun tipo di patologia a livello enterico al massimo
sar a livello dell'orofaringe con una costrizione delle prime vie aeree e ci porta a pensare ad un rinovirus o
a qualcosa del genere, ma per quanto riguarda patologie che riguardano degli organi cos distanti dal
punto in cui entrato il virus, quando dobbiamo fare una prima diagnosi di che cosa dobbiamo accertarci
per prima cosa per stabilire la causa e l'effetto? Per quanto riguarda un' infezione batterica possiamo fare
una emocoltura, ma per quanto riguarda una infezione virale non si pu fare una emocoltura per la ricerca
del virus.
L'esame sierologico si pu fare per vedere se c' una presenza di anticorpi o si possono trovare le IgM o le
IgG, ma sempre un'analisi differenziata, indiretta, perch molta della popolazione, per non dire tutta,
sieropositiva per gli enterovirus, cio portiamo anticorpi contro gli enterovirus, contro il polio, la maggior
parte di noi stata anche vaccinata, ma sicuramente la maggior parte di noi stata anche in contatto con il
virus polio selvaggio, contro i coxsackie, contro l'eco, con molta probabilit siamo siero positivi, quindi
presentiamo anticorpi nei confronti di questi virus. Quindi come possiamo associare questi anticorpi con
un'infezione da poliovirus o con un'infezione da eco a livello delle meningi? Il liquor generalmente in corso
di infezioni da virus generalmente molto limpido, possiamo metterlo in coltura, per in corso di
miocarditi, pericarditi, il medico decider che tipo di prelievo fare e che tipo di indagine eseguire. Per fare
una diagnosi che riguarda questo tipo di virus, questo tipo di infezione, generalmente una diagnosi
indiretta che si basa sulla sintomatologia e sulla ricerca indiretta del virus, lontano dal punto, quindi non
possiamo fare un'analisi di causa-effetto che generalmente consiste nell'isolare il virus nel punto in cui
abbiamo avuto la patologia, nelle vescichette dell'herpes presenti sulle labbra, andiamo a isolare il virus,
allora si che possiamo affermare con certezza che quelle vescichette sono date da un'infezione erpetica, l
c' la patologia e l c' il virus perch non abbiamo una flora virale residente, se c' il virus ha esplicato una
replicazione, ha dato un'infezione e quindi ha dato una patologia che pu essere asintomatica o
sintomatica, se ci sono i sintomi c' la manifestazione patologica, se asintomatica possiamo solo
sospettare la presenza e quindi andare alla ricerca, in modo che, cosi dentro le cellule, sospettiamo la
presenza di quel virus in quel determinato organo, posto, lo andiamo a cercare se c' la sua presenza allora
c' l'infezione da parte del virus. Quindi in questo caso la diagnosi viene fatta in modo indiretto, associamo
la sintomatologia clinica alla ricerca del virus nelle feci, quindi un distretto lontano e diverso da dove si ha
la manifestazione clinica, associamo la presenza degli anticorpi con, non la sola presenza nel dire positivo o
negativo, perch molti di noi saranno siero positivi quindi abbiamo la presenza di questi anticorpi, ma
dobbiamo andare a valutare l'incremento di questi anticorpi, perch in corso di replicazione virale
sicuramente vi sar un incremento del titolo degli anticorpi. Quindi, tenendo conto di tutto questo,
possiamo dire se c' un'infezione da poliovirus oppure la paralisi stata data da qualche altra cosa, ad
esempio da un tetano, anche se le paralisi sono leggermente differenti, dal punto di vista sintomatologico,
clinico, solo che all'inizio possono presentarsi in maniera uguale, paralisi l'una paralisi l'altra, paralisi
flaccida o no, per andare poi a vedere se una paralisi data da polio o data da teta dobbiamo eseguire
delle analisi e dobbiamo indirizzare noi i laboratori, non possiamo lasciare al tecnico di laboratorio il
metodo e la via che deve utilizzare nella ricerca.
Come facciamo una diagnosi di miocardite? Nel corso di miocardite, la biopsia del miocardio una tecnica
invasiva, il paziente muore per altri motivi, come per le meningiti prendere il liquor, dobbiamo vedere se
vale la pena prelevare il liquor, perch esso si trova in distretti altamente protetti, sterili, e quindi se
dobbiamo impiegare un ago esso deve essere sterile perch potremmo causare noi un'infezione, se vale la
pena si possiamo prelevare il liquor, generalmente il liquor deve essere sterile, generalmente il liquor
Microbiologia - Medicina e Chirurgia polo A 2012/2013 - sbobinature lezioni
143
durante un'infezione virale limpido, quindi possiamo fare una diagnosi visiva, rispetto ad un'infezione
batterica, ad una meningite batterica, la differenza la si pu valutare direttamente, il liquor per quanto
riguarda un infezione virale limpido, trasparente, per quanto riguarda una infezione batterica torbido,
gi c la crescita dei batteri al livello del liquor. Per il virus abbiamo bisogno di cellule per replicare il virus,
possiamo trovare virioni liberi, ma non possiamo trovare la replicazione del virus nel liquor, mentre invece
questo non succede nei batteri perch troveremo la replicazione, la moltiplicazione dei batteri nel liquor,
di conseguenza una crescita smodata di batteri che porta ad una torbidit del liquor, quindi un primo
esame a occhio lo possiamo fare direttamente.
Qual la differenza dal punto di vista clinico? La differenza tra un'infezione virale, la relazione che viene
istaurata tra il virus, la cellula permissiva e il sistema immunitario (difensivo). Nella maggior parte dei casi
un'infezione virale porta alla morte della cellula mediante lisi, perch per quanto riguarda l'ospite
vertebrato, il virus non ha intenzione di andare incontro a morte ma il suo ciclo quello di replicarsi e di
avere una progenie, siccome cellule ce n' in abbondanza lui non fa altro che infettare le cellule, lisare le
cellule e reinfettare nuove cellule, questo il ciclo degli eventi di un'infezione virale, nella maggior parte
dei casi. Questo ciclo si pu interrompere prima con l'azione degli anticorpi che permette l'eliminazione
del virus, l'eliminazione totale del virus (sempre in alcuni casi), che poi l'eliminazione dei virioni completi,
che sono usciti dalla cellula, che sono liberi nel mezzo pronti a infettare altre cellule. La memoria
immunologica entra qua nel sistema difensivo, la memoria immunologica cio la presenza degli anticorpi
che ricordano quel tipo di infezione se un'infezione primaria oppure una reinfezione. Pu entrare
anche in gioco, oltre alla presenza del virione libero, qualcosa che completamente diverso rispetto
all'origine e cio la cellula permissiva che permette la replicazione del virus. Prima ancora di eliminare il
virus completo, manifesta sulla sua superficie gli antigeni virali, di conseguenza il sistema cellulo-mediato
va a eliminare la cellula che diversa rispetto alle altre perch manifesta sulla sua membrana gli antigeni
virali, quindi per il nostro sistema cellulo-mediato una cellula non self, non nostra, sconosciuta, che deve
essere eliminata. In questa maniera il nostro organismo, blocca questa sequenza di eventi o eliminando
direttamente il virione o eliminando le cellule che permettono la sua replicazione. In alcuni casi l'infezione
virale persiste nell'organismo. Le abbiamo classificate come infezioni "acute" dove c' l'eliminazione
completa dei virioni e quindi poi la guarigione del soggetto e poi abbiamo la persistenza del virus, la non
completa eliminazione del virus. Dal punto di vista clinico la differenza tra "acuta" e "persistente" solo
una questione di tempo, l'acuta subito dopo il virus viene completamente eliminato, la persistente invece
il virus pu esistere nell'organismo per un tempo variabile, che pu andare da qualche settimana, mese,
anno, anche tutta la vita e in questo caso abbiamo delle differenze anche nelle persistenze: una
persistenza lenta, cronica, latente, quindi solo una questione di tempo tra la presenza e l'eliminazione
del virus. Come si esplica la persistenza? Se siamo in presenza di un virus a DNA la persistenza si esplica
con la sua integrazione diretta nel genoma cellulare, invece quando siamo in presenza di un virus a RNA
tramite una strategia e cio il trasferimento da RNA a DNA e quindi solo successivamente l'integrazione di
questo pro-virus a livello del genoma cellulare.
Analizziamo quali sono quei meccanismi che l'organismo mette in campo per difendersi dall'infezione.
Abbiamo due tipi di meccanismi:
Meccanismi di tipo aspecifico che possono essere presenti nell'organismo prima ancora che avvenga
l'infezione e sono: le barriere, i cosiddetti" inibitori aspecifici della moltiplicazione virale" e la" fagocitosi".
Questi sono dei meccanismi che sono presenti nell'organismo prima dell'infezione. Poi sempre tra gli
aspecifici abbiamo quelli che sono attivati a seguito dell'infezione, come la febbre, l'infiammazione, la
produzione di interferon.
Microbiologia - Medicina e Chirurgia polo A 2012/2013 - sbobinature lezioni
144
Meccanismi di tipo specifico che possono essere: l'immunit umorale cio la produzione di anticorpi
specifici. Questi sono sempre a seguito dell'infezione, prima deve avvenire l'infezione. L'immunit cellulomediata con la produzione dei linfociti T e dei macrofagi.
Tra i meccanismi di tipo aspecifico abbiamo la barriera cutanea che se integra, un'ottima barriera nei
confronti dell'infezione virale e il virus non la pu attraversare naturalmente, il virus se risiede sulla cute va
incontro a morte sicuramente, se la cute leggermente aperta il virus pu penetrare e se raggiunge un sito
idoneo alla sua replicazione causare l'infezione.
Gli inibitori.
(Ricordiamo sempre che questi sono meccanismi aspecifici, preesistenti all'infezione.)Il nostro organismo
generalmente presenta delle molecole a basso peso molecolare, peptidi, che hanno una certa attivit nei
confronti di batteri, virus, in modo del tutto aspecifico, non sono mirati verso una determinata famiglia o
verso un determinato batterio ma possono agire in maniera aspecifica. Una di queste molecole,
generalmente sono degli enzimi o dei simil-recettori, il lisozima, presente nella mucosa che in grado di
inibire sia le infezione da virus influenzale che da rinovirus. Poi abbiamo le cosiddette CVI (o CBI 1.18.40),
piccoli peptidi prodotti dalla cellula che generalmente mimano i recettori, quindi vanno a legare qualsiasi
antigene virale" e lo bloccano nella sua fase di adsorbimento perch il virus non potr adsorbire alle
cellule, per evidente che tutte queste molecole non sono il massimo della ricerca, perch dovremmo
avere un quantit cosi enorme di molecole di CVI, una quantit notevole di lisozima, tale da bloccare
qualsiasi tipo di infezione, perch sono di tipo aspecifico e non le possiamo utilizzare nei confronti di un
virus in particolare, perch non lo bloccherebbe completamente e dovremmo avere una quantit notevole
in circolo di queste sostanze. Quindi la ricerca nel campo dei meccanismi di difesa rivolta pi verso i
vaccini, verso la chemioterapia, che diventa un meccanismo di difesa diretto nei confronti del singolo virus,
lo vedremo anche per quanto riguarda la chemioterapia e si cerca di studiare delle molecole che siano
selettive nei confronti di un determinato virus e di una determinata famiglia virale in modo da non causare
danni ad altri organi, perch dobbiamo ricordare che il virus entra nella cellula ed ha bisogno sempre della
cellula, quindi qualsiasi farmaco che deve attaccare un virus potenzialmente tossico e deve distruggere
anche la cellula ma non deve distruggere qualsiasi tipo di cellula, deve distruggere solo ed esclusivamente
quel tipo di cellula che sta portando in quel momento il virus, infatti si sta studiando la selettivit delle
molecole dei chemioterapici in modo che il farmaco possa interagire solo ed esclusivamente con quel tipo
di cellula che in quel momento sta portando il virus. Una reazione che viene messa in campo dall'ospite
successivamente all'infezione la febbre, il rialzo termico dell'organismo.
Noi sappiamo che quasi tutti i virus hanno una temperatura ottimale di crescita che di 37, sbalzi di
temperatura anche di un solo grado, da 37 a 38 hanno portato ad una riduzione della replicazione virale
di almeno il 90% e un ulteriore aumento da 38 a 39 ha bloccato completamente la replicazione virale.
Quindi il nostro organismo nel momento in cui stato infettato, in cui si ha la replicazione del virus, e
quindi la diffusione nelle altre cellule, mette in atto un meccanismo che cerca di controllare questa
replicazione, bloccandola se ne capace. Se noi non ci mettiamo le mani il nostro organismo capace di
bloccarla. Come ci mettiamo le mani? Al primo sintomo di febbre, a 37,5, noi iniziamo a imbottirci di
antipiretici, aspirina, tachipirina che non fanno altro che abbassare la temperatura, ma creare un ottimo
terreno per la replicazione del virus. Quindi l'infezione continuer nel nostro organismo, noi avremo 37 di
temperatura, possiamo uscire e stare tranquille, per sicuramente nel nostro organismo c' una
replicazione del virus in atto. Un altro virus che ha una temperatura particolare il rinovirus che ha una
temperatura di crescita di 34 35, infatti l'organo ideale per la sua replicazione e l'infezione la
Microbiologia - Medicina e Chirurgia polo A 2012/2013 - sbobinature lezioni
145
rinofaringe, l'unica parte del nostro organismo che presenta una temperatura di questo genere per la
ventilazione che avviene, infatti il virus non pu infettare gli organi pi profondi perch gi cambia la
temperatura, nei polmoni avremo 37, a livello dell'orofaringe si replica attivamente perch abbiamo
questa temperatura pi bassa, per nel momento in cui abbiamo il collasso delle cavit nasali, la chiusura
delle cavit nasali per il troppo muco, il virus non si replica pi, perch la ventilazione stata bloccata e
non respiriamo pi con il naso ma respiriamo con la bocca, il naso otturato e soffiamo per questo ci
permette anche una minore diffusione del virus, perch con il naso chiuso stiamo diffondendo sempre
meno virus, quindi la replicazione del virus nel sito sta diminuendo perch non c' pi la ventilazione.
Quando abbiamo il naso chiuso diffondiamo meno virus, quando abbiamo il naso aperto, ventilato stiamo
diffondendo molti rinovirus, perch il virus si sta replicando attivamente nelle nostre cavit nasali. Quindi
bene mantenere, almeno per qualche giorno, se siamo in presenza di infezione virale, bene mantenere
temperature che siano pi elevate, non utilizzando antipiretici se non in casi eccezionali, se non quando
questa temperatura veramente fuori norma, e in soggetti ad alto rischio, come malati cronici, anziani,
bambini in cui bene cominciare a utilizzare un antipiretico, anche se siamo in presenza di infezioni virali.
Un soggetto normodotato non ha bisogno di antipiretici, perch temperature pi elevate hanno bloccato
la replicazione del virus.
L'altro meccanismo che il meccanismo mette in campo l'ipersensibilit, l'infiammazione, che viene
utilizzata mediante la produzione di interferon e di linfochine, attivando la C3 che l'attivazione della via
alternativa del complemento, che viene utilizzata dal sistema immuno competente dagli anticorpi per
combattere l'infezione o qualsiasi cosa che sia estraneo come l'eliminazione di cellule. Questi sono tutti dei
procedimenti che il nostro organismo mette in campo per autodifendersi, mediante l'attivazione della via
del complemento, la via classica, mediante la formazione degli immunocomplessi, mediante
l'ipersensibilit di tipo ritardato di tipo CD4, mediante la citolisi che porter alla citolisi delle cellule diverse
con i linfociti CD8 che anche questi presiedono alla difesa. Tutte queste procedure, portano si al blocco
della replicazione virale, alle nostre difese nei confronti dell'infezione virale, per portano anche ad un
danno a livello tissutale, quindi da un lato ci difendiamo nei confronti del virus, dall'altro lato un controllo
del genere, una messa in campo di queste attivit di tipo auto-immune, porta anche ad un danno di tipo
tissutale, quindi alla distruzione di tessuti, che dato in modo indiretto dall'infezione virale, che non
causato direttamente dal virus, ma il fatto che l'infezione virale ha causato l'ipersensibilit, ha causato
un'infiammazione e di conseguenza tutti i prodotti che vengono messi in campo dal nostro organismo
quando siamo in presenza di infiammazione o ipersensibilit, porteranno ad un danno di tipo tissutale, con
la presenza di polimorfonucleati che indichiamo nel sito di tutti questi polimorfonucleati, porter ad un
danno a livello tissutale. Si pu avere quindi un danno non determinato dal virus, ma successivo
all'infezione virale. Questi componenti sono la produzione di piccoli tratti di RNA, a doppia catena, il DNA
del virus, le glicoproteine stimolate dal virus, che non fanno altro che manifestarsi sulle cellule dendritiche,
sulle cellule immature, sui macrofagi che portano alla produzione delle citochine, dell'interferon e di
conseguenza, come sappiamo le cellule dendritiche sono quelle che esprimeranno sulla sua superficie e
quindi faranno riconoscere al sistema immune gli antigeni virali e poi l'NK che elimineranno queste cellule
diverse. Ecco come si esplica il danno di tipo tissutale, noi abbiamo la produzione degli anticorpi
neutralizzanti, che neutralizzano l'effetto virale, andando a legarsi questi anticorpi, vengono espressi sulla
superficie delle cellule, e si avr la produzione di IgG, IgM e IgA, anticorpi circolanti, questi anticorpi
circolanti altamente specifici nei confronti del virus e degli antigeni virali, verranno espressi
successivamente, le IgA sono molto importanti per esempio l'immunit secretoria, per la difesa nelle
mucose. Dopo di che la reazione antigene-anticorpo mediante il complemento, porter all'opsonizzazione
delle cellule che portano il virus, alla distruzione delle cellule che portano il virus e questo causa danno a
Microbiologia - Medicina e Chirurgia polo A 2012/2013 - sbobinature lezioni
146
livello tissutale. Come vedete in questa sequenza, questi sono dei linfociti citotossici che si vanno a legare
agli antigeni di superficie espressi nelle cellule e nei successivi passaggi, la cellula cambia la morfologia e va
incontro ad apoptosi con la formazione di corpi apoptopici e morte della cellula.
Un'altra reazione che mette in campo il nostro organismo attivare il cosiddetto "sistema interferon".
L'interferon la prima risposta concreta che il nostro organismo mette in campo a seguito di un'infezione
virale, compare ancora prima della produzione degli anticorpi specifici. Se il nostro sistema interferon non
dovesse funzionare la maggior parte delle infezioni sarebbero ben manifeste, perch quando il nostro
sistema interferon funziona di molte delle infezioni noi non ce ne accorgiamo o passano in forma
asintomatica. Questo sistema interferon costituito da proteine glicosilate a basso peso molecolare, che
hanno delle caratteristiche bene precise e generalmente la proteina non presente nel nostro organismo,
ma viene prodotta solo a seguito di particolari stimoli, infatti viene definita una" proteina indotta" , per a
sua volta l'interferon ha la capacit di indurre su cellule recettive la produzione di interferon e la
produzione di particolari sostanze che proteggono la cellula a seguito di un'infezione e quindi bloccare in
ogni caso l'infezione.
Come pu avvenire tutto ci?
Il sistema interferon la prima difesa che il nostro organismo mette in campo, la prima che interferisce
con la replicazione di molti virus andando a bloccare la replicazione virale e andando ad attivare il linfociti
che poi serviranno per l'eliminazione delle cellule infette.
Abbiamo tre tipi di interferon (anche a seconda del tipo di cellula che lo produce): interferon alfa, beta e
gamma.
Il principale induttore di interferon, che stimola la produzione di interferon, sono gli RNA a doppia elica,
quelli che sono intermediari nella replicazione di alcuni virus, come gli mRNA virus, gli RNA messaggeri,
questi non fanno altro che stimolare o indurre la produzione di interferon. Allora possiamo definirlo come
un "induttore" che viene anche indotto e porta in ogni caso a instaurare una resistenza cellulare nei
confronti delle modificazioni cellulari che possono essere dovute a un'infezione virale o alla modificazione
cellulare di una cellula normale in cellula tumorale, a qualsiasi tipo di modificazione cellulare. Quindi
concludendo la definizione, andiamo dalla induzione e produzione di interferon alla azione degli
interferoni che avranno sulle cellule che porter ad uno stato di attivazione cellulare, generalmente una
cellula attivata, una cellula in "allarme" perch resistente all'infezione, pu stimolare la formazione di
altre cellule simili, a seconda del tipo di interferon ed ha anche una funzione di tipo anti-tumorale, cio
blocca la replicazione di cellule nuove, cio la duplicazione di cellule alterate. Questo si definisce tutto
sistema interferon (schema finale). Nel nostro organismo non presente la glicoproteina, ma noi
portiamo generalmente la memoria genetica di questa proteina, cio i geni che precedono la sua sintesi e
la sua induzione. La cellula normalmente non ha presenza di interferon ma presenta un gene che viene
attivato immediatamente a seguito dell'infezione, questo gene una volta attivato presiede alla sintesi della
proteina, che viene liberata nel mezzo, che ha una sorte di comunicazione cellulare, come se ha la stessa
funzione degli ormoni, dei neurotrasmettitori. Innesca questo meccanismo di allarme nei confronti delle
cellule vicine, in modo da rendere le cellule vicine resistenti a quel tipo di attacco verso cui si rivolta la
prima cellula.
Questo porta quindi a mantenere un grado di allarme nell'organismo nei confronti delle cellule anormali.
L'interferon non agisce nei confronti delle cellule virali solo, ma l'interferon agisce anche come
Microbiologia - Medicina e Chirurgia polo A 2012/2013 - sbobinature lezioni
147
immunomodulante, ha una funzione anche antioncogena, infatti una cellula infettata o tumorale una
cellula diversa. Quindi ha queste funzioni oltre a quella di antivirale, ha tre tipi di interferon che si
differenziano in base al tipo di cellule che le produce:
-gli interferon alfa vengono prodotti dalle cellule B, dai monociti, macrofagi (interferon leucocitari)
-gli interferon beta prodotti dai fibroblasti
-gli interferon gamma prodotti dalle natural killer, dalle cellule T. Questo tipo di interferon non fa altro che,
dal punto di visto chimico biologico, attivare all'interno della cellula un sistema di proteine, di enzimi, di
acidi nucleici che porter la cellula a difendersi da una nuova infezione virale.
Lo scopo dell'interferon quello di bloccare la sintesi proteica virale in tutte le sue forme. Quindi o
direttamente bloccare la sintesi delle proteine virali oppure andando a neutralizzare gli RNA transfer o gli
RNA messaggeri virali (che in fondo la stessa cosa, ma sono due step differenti), sia quando un
interferon di tipo RNA dipendente, che quello indipendente.
La cinetica dell'interferon:
l'interferon la prima barriera del nostro organismo nei confronti dell'infezione virale e segue la cinetica
dell'infezione virale, quindi produzione, replicazione attiva del virus e attiva produzione degli interferon in
circolo che entrano ancora prima che si possa manifestare la produzione di anticorpi.
Quindi se questo sistema non funziona, noi abbiamo dato circa 7/8 giorni di tempo al virus di replicazione
attiva e diffusione attiva, quindi difficilmente da controllare. Schematicamente l'interferon agisce in questa
maniera: una cellula che viene infettata, a seguito della sua infezione, dal suo corredo cromosomico attiva
un gene che produrr interferon. La cellula infettata andr a morte lo stesso, perch il virus si sta
replicando, ma questo interferon verr utilizzato come un campanello di allarme per tutte le cellule vicine
le quali presentano dei recettori specifici per l'interferon e, una volta che l'interferon si legato, all'interno
di questa cellula si esplicher l'altra sua memoria genetica, un gene che attiver e esprimer delle proteine
e degli enzimi che metteranno in allarme la cellula. Saranno presenti all'interno del citoplasma di questa
cellula dei tratti di RNA, degli mRNA, delle proteine come la protein chinasi e la adenilato sintetasi che a
seguito dell'infezione di questa cellula dal virus, l'interferon per non specifico per il virus, specifico per
una modificazione, per qualsiasi cosa che diversa, che pu essere una infezione virale o una modifica
tumorale. A questo punto, il virus pu bloccarsi sulla superficie cellulare e non penetrare perch la
membrana citoplasmatica diventa pi resistente oppure nella maggior parte dei casi il virus entra, infetta
la cellula, ma rimarr, si replicher ma i suoi mRNA verranno tagliati, verr bloccata la sua replicazione e di
conseguenza verr eliminato dalla cellula e metabolizzato. Gli acidi nucleici virali, verranno tutti sezionati e
il virus non sar pi in grado di replicarsi all'interno della cellula e questo porter ulteriormente alla
formazione in questa cellula, in modo da difendersi, all'espressione di istocompatibilit nei confronti delle
altre cellule, quindi cambia completamente la cellula. L'interferon una buona molecola che pu essere
utilizzata in terapia. Infatti attualmente l'interferon pu essere utilizzato sotto forma sia sistemica che
locale. Specialmente nei confronti dell'epatite B e C, per via locale, per uso topico per quanto riguarda i
condilomi e papillomi. Non utilizziamo interferon per quanto riguarda le cheratiti erpetiche, perch per
quanto riguarda le cheratiti erpetiche ci sono altri farmaci, chemioterapici specifici nei confronti
dell'herpes. La produzione dell'interferon molto costosa, viene utilizzata per patologie gravi, per
rallentare la replicazione di virus che altrimenti non potremmo rallentare, dove non ci sono dei farmaci
altamente selettivi e specifici oppure per uso locale i papillomi oppure a seguito del trattamento
Microbiologia - Medicina e Chirurgia polo A 2012/2013 - sbobinature lezioni
148
chirurgico, sappiamo che sono delle infezioni riattivanti che possono ricomparire e riattivarsi, quindi
l'interferon ci permette di neutralizzare questa loro eventuale riattivazione.
Lezione 10
Esistono due modi per controllare le infezioni virali:
vaccini;
chemioterapia antivirale.
Queste sono le uniche due tecniche usate contro le malattie virali. Rispetto a quanto detto nelle lezioni
precedenti riguardanti le proteine antivirali, CVI e LISOZIMI, prodotte dal nostro organismo, bisogna dire
che sono fattori specifici, dal momento che non permettono un blocco totale di un'infezione virale.
Con questi due metodi invece si ottengono buoni risultati, per quanto riguarda i vaccini antivirali, che
hanno permesso di sradicare morbi pericolosi, tra cui il VAIOLO, grazie alla vaccinazione di massa. Nei paesi
industrializzati si tengono sotto controllo epidemie di POLIOMELITE, INFLUENZA, PAROTITE, MORBILLO,
EPATITE B, grazie alle vaccinazioni; vedendo infezioni come quella della ROSOLIA, si potrebbe pensare ad
infezioni non molto gravi, in pazienti adulti ed immunocompetenti, differente il caso ad esempio di
un'infezione in donne in gravidanza: avere una sorta di controllo sull'epidemia molto importante. Queste
infezioni hanno dei cicli endemici capaci di essere sconfitti il giorno stesso dell'espressione.
Come stato possibile sradicare il Vaiolo? Non siamo stati vaccinati contro il vaiolo, dal momento che la
vaccinazione di massa avvenuta nelle generazioni precedenti, ed il virus selvaggio non circola pi. Il vaiolo
infatti non possiede un essere serbatoio (parlando di infezioni abbiamo un essere vertebrato, un
mammifero serbatoio, quello che porta il virus), ed un virus stabile, non ha nessun tipo di mutazione;
non come l'HIV e la differenza dal punto di vista biologico, sta nel fatto che con un vaccino standard si
riesce a bloccare un virus stabile.
Altra caratteristica biologica importante il fatto che le mutazioni avvengono maggiormente in virus ad
RNA (come l'HIV) perch si incorre in errori di replicazione; il vaiolo un virus molto stabile, non da
mutazioni, presenta un solo sierotipo (POLIO ne ha tre; l'influenza ne ha tre principali, all'interno dei quali
hanno dei sottotipi), ha un'immunit di lunga durata (non ha bisogno di richiami), non esistevano casi subclinici, cio il soggetto infetto manifestava sicuramente la malattia, dal momento che esistevano due forme
di vaiolo: il MAIOR ed il MINOR, e la manifestazione il pi delle volte era la minor (il maior era il cos detto
Infausto).
Il vaccino stato scoperto nelle mucche, infatti molti allevatori erano sieropositivi e non contraevano mai la
forma MAIOR, al massimo contraevano la minor, perch avevano un continuo contatto con il virus delle
mucche, nonostante fosse leggermente diverso da quello umano, per questo al massimo potevano
contrarre la minor. Il vaccino fu ottenuto dalla purificazione dei liquidi provenienti dalle pustole dei soggetti
malati, ed inoculati nel soggetto, con una completa protezione immunitaria.
Come possiamo quindi controllare l'infezione? Mettendo in pratica una profilassi, di cui ne conosciamo di
due tipi:
ATTIVA (con l'impiego dei vaccini);
PASSIVA (usando sieri con gammaglobuline specifiche, nei confronti di una determinata infezione).
Microbiologia - Medicina e Chirurgia polo A 2012/2013 - sbobinature lezioni
149
Quando possiamo usare l'una e/o l'altra? La passiva viene utilizzata su soggetti non vaccinati, associandola
al vaccino in pazienti che hanno avuto un contatto con il virus, e che quindi presentano un minimo di
anticorpi specifici per quel virus. Queste gammaglobuline vanno utilizzate tramite la vaccinazione dei
soggetti, dopo l'infezione.
Si pu vaccinare un animale prima dell'infezione, per la produzione di anticorpi, oppure nel corso di
un'epidemia, quando l'animale ha gi sviluppato anticorpi contro quella popolazione virale, andiamo cos a
salassare l'animale e a raccogliere il sangue, lo centrifughiamo, e nel sopranatante sono presenti gli
anticorpi specifici che utilizzeremo in un altro soggetto, stando attenti alle risposte autoimmuni e/o
specifiche.
Possiamo per anche isolare solo le gammaglobuline anti-Epatite B, senza usarle tutte nel complesso,
concentrando questi anticorpi ed utilizzandoli nel momento della contaminazione, avendo cos una risposta
immediata (con la loro metabolizzazione nell'arco di 15 giorni).
consigliabile quindi affiancare la vaccinazione a questa terapia, per stimolare l'organismo ad una
produzione autonoma di immunoglobuline specifiche.
Le immunoglobuline standard vengono solitamente utilizzate nel corso di infezioni di Epatite A, morbillo, e
sono delle Ig specifiche, ma non ad alta concentrazione, a differenza delle iperummuni, le pi concentrate,
che vengono utilizzate in corso di Epatite B o Rabbia. Quando andiamo in pronto soccorso per fare la cos
detta antitetanica, dobbiamo esser certi che non facciano una vaccinazione, ma un'immunoterapia,
utilizzando gammaglobuline antitetaniche.
Se la ferita profonda, necessario fare un richiamo del vaccino. Il problema del tetano, non tanto il
bacillo presente nell'organismo, ma le tossine che esso produce e mette in circolo, che diffondono a livello
del sistema nervoso. Il principio del vaccino sta in un'anatossina (tossina detossificata).
Fino ad ora non stato trovato un vaccino capace di eradicare pi virus, dal momento che la struttura virale
differente per ogni virus, che tutti mutano in maniera differente e con tempistiche differenti; alcune
famiglie ad esempio presentano differenti sierotipi, presentano latenza di alcuni virus (non possiamo
correre il rischio di infettare un soggetto che non ha ancora contratto il virus latente). Altro problema
l'oncogenicit di alcuni virus (herpes, papilloma, i quali si integrano con le cellule dell'organismo e
trasformarle).
La vaccinazione pu presentare degli effetti collaterali (sopratutto per quanto riguarda la vaccinazione con
virus interi, vale a dire uccisi, inattivati per interi) come fenomeni allergici; una virulenza latente potrebbe
essere causata da una mancata inattivazione di virus, che potrebbero poi sviluppare una patogenicit, una
reazione anomala del vaccinato, specialmente in corso di successive epidemie dello stesso virus (es.
morbillo).
I vaccini sono solitamente coltivati in cellule che possono essere umani o animali (i virus sono organismi
ENDOCELLULARI OBBLIGATI), e per produrre grandi quantit di virus si necessita di una grande quantit di
cellule che permettano una grande replicazione virale.
Se usiamo cellule umane non abbiamo controindicazioni, a meno che non presentino fattori allergici. Se
usiamo cellule animali, ci sono due rischi da considerare:
Microbiologia - Medicina e Chirurgia polo A 2012/2013 - sbobinature lezioni
150
una reazione del soggetto nei confronti di quel tipo di animale;
i contaminanti virali, cio cellule animali che portano virus animali, che ci portiamo dietro quando
produciamo il virus umano, che potrebbe dare dei problemi all'uomo (il SALTO DELLA SPECIE, replicazione
nell'uomo).
Ad esempio per la POLIO esistono due tipi di vaccini:
il vaccino vivo che attenuato;
il vaccino ucciso.
Inizialmente questo vaccino, prodotto con cellule di scimmia, una volta purificato, al momento
dell'inoculazione si portava dietro dei virus scimmieschi, che non sono molto pericolosi per l'uomo, ma
sierologicamente, l'uomo rispondeva a questi virus, specifici per la scimmia, ma che l'organismo riconosce
come estranei e produce anticorpi.
Per questo motivo, il vecchio vaccino contro la polio non pi usato: ora il vaccino viene prodotto su
fibroblasti umani.
Con il vaccino fatto da virus uccisi, non c' nessun tipo di controindicazione o effetto indesiderato, dal
momento che la patogenicit del virus ucciso nulla.
Adesso vediamo quanti tipi di vaccini possiamo avere:
vaccini prodotti con virus vivi ed attenuati. Il virus replicante, vivo, ma non presenter pi il
trofismo per la patologia virale. Ad esempio la polio ha un trofismo per il sistema nervoso centrale,
nonostante il virus entri e si replichi nell'uomo a livello del sistema gastroenterico (fa parte infatti degli
enterovirus) a livello del quale ha una prima replicazione, successivamente colpisce, con la seconda
replicazione il SNC. La vaccinazione a virus ucciso della polio, deve poter seguire la via del virus selvaggio e
quindi, un percorso a livello dell'apparato digerente. Si usava un vaccino con gocce sublinguali, oppure sulle
zollette di zucchero, dal momento che era molto amaro e cos il virus fa il suo percorso naturale, arriva al
sistema gastroenterico, e anche se va in circolo, non colpisce le cellule nervose perch ha perso la capacit
di replicarsi a livello del sistema nervoso.
Poi avremo i cos detti mutanti avirulenti, come per la polio, che fanno dei ripetuti passaggi a livello
di pi colture cellulari, che permettono di far perdere molte capacit, ma di mantenerne alcune, come
quella di replicarsi a livello delle vie gastroenteriche.
I VIRUS MUTANTI SENSIBILI ALLA TEMPERATURA, questo riguarda pi che altro (sempre
enterovirus, picornavirus) DICLOVIRUS ([Link]) che crescono ad una temperatura di 34/35. Se
modificassimo le temperature, il virus stesso si modificherebbe perdendo certe capacit. Nei trattamenti di
questi virus, a volte vengono usati virus apatogeni.
Vaccini vivi e virulenti, usati solo in medicina veterinaria.
Microbiologia - Medicina e Chirurgia polo A 2012/2013 - sbobinature lezioni
151
Ricapitolando, abbiamo vaccini vivi attenuati, avirulenti (passati pi volte su colture cellulari a livello delle
quali non riescono ad esprimere tutte le parti del corredo cromosomico, perdendo alcune proprie
caratteristiche a livello delle replicazioni in altre linee cellulari, potendo cos individuare il gene specifico
che da la virulenza, modificando/mutando/tagliando la porzione che ci interessa); vaccini con virus
inattivati (chimicamente con formalina, definibili come contenitori proteici che stimolano il sistema
immunitario ma non del tutto, non facendo esplicare una risposta completa del sistema immunitari); poi
abbiamo una nuova generazione di vaccini, i vaccini subvirionici, caratterizzati non da virus vivo, ucciso, o
attenuato, ma da costituenti proteici (glicoproteine di superficie che permettono la stimolazione del
sistema immunitario), costituenti di qualunque origine (clonazione, creati artificialmente, da virus vivi,
morti o inattivati). Infine, vaccini di ultima generazione, i DNA-vaccini, costituiti da molecole di DNA,
plasmidi che portano i geni virali delle proteine virali da cui dobbiamo vaccinarci.
Quindi dal virus viene estrapolato il gene, che viene inserito in un DNA circolare, un plasmide, che viene
inserito in cellule direttamente nell'organismo o in piastrina, permettendo la produzione delle proteine del
gene, proteine virali, che vengono metabolizzate dalle cellule di tutti gli organi, andando verso la
metabolizzazione della proteina virale di produzione cellulare.
Quali sono i vantaggi e gli svantaggi di vaccini con virus vivi e attenuati?
Mimano l'infezione naturale del virus selvaggio, seguendo la stessa via d'ingresso del virus selvaggio
attivando tutto il sistema umorale con produzione di IgA;
determinano un'immunit pi rapida e duratura, perch mimano la stessa risposta di un'infezione
in corso;
hanno un basso costo di produzione;
immunit anche in soggetti vaccinati;
facile somministrazione;
determinano in alcuni casi la scomparsa del virus selvaggio.
Questi sono i pro, ma abbiamo anche dei contro:
la presenza di qualche virus vivo, ma non attenuato che possa magari dare un'infezione virale;
(come nel caso della polio) si pu riattivare la replicazione a livello del sistema nervoso centrale,
bisogna quindi tener conto della mutazionalit del virus;
difficolt di trasporto;
impossibilit di somministrazione a soggetti immunodeficienti o immuno non competenti
(potrebbero sviluppare la patologia contro cui vengono vaccinati).
I vantaggi dei vaccini con virus inattivati;
non danno mutazioni, sono stabili, determinano una sufficiente risposta immunitaria (a seguito
anche di richiami),
possono essere eseguiti su soggetti immuno incompetenti;
Microbiologia - Medicina e Chirurgia polo A 2012/2013 - sbobinature lezioni
possono essere trasportati in paesi con caldo umido senza rischio di morte del virus;
possono essere utilizzati in infezioni pi ampie, come per la RABBIA (molto virulenta).
152
Svantaggi:
mancata induzione di risposta immunitaria in certi soggetti;
somministrazione del vaccino da virus ucciso, che non rispetta la via di ingresso del vaccino
selvaggio (non stimoler la produzione di IgA);
il costo della produzione e somministrazione maggiore rispetto al precedente;
le vaccinazioni sinciziali possono predisporre il paziente ad una risposta allergica o reazioni
verificabili nel corso dell'infezione di quel virus.
Per la polio adesso si usa un vaccino di solco che, anche se non da una risposta immediata e la produzione
delle IgA, fornisce un grande quantit di anticorpi di tipo G, che potrebbero servire al momento della
vaccinazione con il vaccino in vivo ed attenuato. Eventuali mutazioni del vaccino vivo ed attenuato possono
essere controllate benissimo dalla presenza degli anticorpi.
Un esempio di vaccino trivalente quello che immunizza da ROSOLIA, MORBILLO e PAROTITE: il ceppo
manifesta una maggiore predisposizione alla immunizzazione ed un minor rischio di mutazione se il
soggetto gestante (bisogna controllare che il vaccino abbia attecchito, perch pu capitare che il virus
ucciso non attecchisca, e quindi potrebbero essere necessari richiami. Durante una gravidanza impossibile
attuare questa vaccinazione).
Le vie di somministrazioni possono essere varie e tra tutte annoveriamo:
1.
via orale (es POLIO, se il virus vivo ed inattivato va fatto per via intramuscolare);
2.
intramuscolo, stando attenti a non ledere tessuti nervosi o vascolari.
Degni di nota sono dei vaccini a DNA ricombinante, differenziati in due tipi:
vivente: costituito da un virus vaccinico apatogeno, utilizzato come portatore di geni per il virus
verso cui dobbiamo fare vaccini; vengono inseriti a livello del virus vaccinico, i geni che ci interessano (il
virus vaccinico tra i pi grandi esistenti). In casi del genere possono riscontrarsi effetti collaterali.
non vivente: geni di antigeni clonati che esprimono un antigene e vengono utilizzati sistemi di
espressioni quali cellule eucariote, i batteri, i fagi e lieviti. Dobbiamo inserire un gene verso cui dobbiamo
vaccinare, lo inseriamo nelle cellule eucariote, batteriche, fagiche, permettendo loro di produrre le
proteine antigeniche che ci interessano.
Questi vaccini dovrebbero essere i migliori in commercio e da utilizzare, perch presentano pochissime
controindicazioni svolgendo al meglio la loro funzione.
Il plasmide una molecola di DNA modificabile, proveniente dal virus, il quale una volta inserito il virus, a
livello del nostro organismo, non far altro che strascriptare alle cellule muscolari; viene inoculato e la
proteina prodotta, sar espressa sulla superficie cellulare muscolare evocando la risposta immunitaria.
Microbiologia - Medicina e Chirurgia polo A 2012/2013 - sbobinature lezioni
153
Possono essere inoculati diversi plasmidi che stimoleranno il sistema immunitario per una risposta
polivalente a diverse infezioni.
Le proteine prodotte possono essere delle proteine glicosilate, proteine trattate dalla cellula, prodotte
internamente all'organismo e non prodotte esternamente alla cellula; quindi delle proteine virali
processate nel contesto cellulare, la quale dar una risposta come fosse un'infezione vera e propria,
evocando successivamente una risposta cellulo-mediata, avendo, infine, sia la produzione di anticorpi A, G,
etc, ma anche una risposta per quanto riguarda i linfociti natural killer.
Lezione 11
Oggi parleremo del secondo metodo per controllare le infezioni virali. Laltra volta abbiamo parlato dei
vaccini, oggi parleremo della chemioterapia. Fare una chemioterapia antivirale un po difficile, per si
riusciti in qualche maniera ad avere e sintetizzare delle molecole che riescono in qualche maniera, anche in
modo abbastanza selettivo a bloccare almeno alcune infezioni virali.
I problemi della chemioterapia sono rivolti verso lagente che noi andiamo a combattere, per quanto
riguarda la batteriologia c una lunga serie di antibiotici che riescono a bloccare le infezioni batteriche
poich la natura del batterio molto ma molto diversa di quella del virus, il batterio sta al di fuori delle
cellule, tutte le molecole sono utilizzate nei confronti del batterio, contro la sua parete, contro la sua
membrana, contro alcune attivit specifiche del batterio. Per quanto riguarda il virus le molecole che
devono essere utilizzate devono sottostare a dei protocolli ben precisi, devono danneggiare il virus,
bloccarlo nella sua replicazione, eventualmente danneggiare la sola cellula che porta il virus ma non le
cellule vicine, non le cellule non infette. Questi sono tanti problemi che i ricercatori si sono messi davanti
prima di trovare delle molecole adatte e idonee.
I virus sono i pi piccoli agenti infettivi, la loro replicazione molto semplice, sono costituiti da una
molecola di acido nucleico, qualche proteina che la racchiude a formare il capside, alcuni presentano il
pericapside, ma la cosa pi importante che i virus sono tutti parassiti endocellulare obbligati, di
conseguenza i farmaci che devono essere utilizzati hanno avuto un limitato uso poich il farmaco o la
molecola deve essere quanto pi possibile specifica poich deve colpire una funzione specifica del virus e
cercare di non danneggiare la stessa funzione cellulare se no il farmaco diventa molto tossico, quindi deve
attaccare un estratto, prodotto del virus e non lequivalente cellulare. Su questo la chemioterapia ha fatto
molti passi avanti, specialmente spinta dal fatto che per molte malattie non disponibile un vaccino, per
quelle infezioni che riguardano il virus che presentano grossi livelli di mutazione, per quei virus che
presentano grossi problemi di riassorbimento, come linfluenza, esiste il vaccino contro linfluenza per
quando parte lepidemia se non si ancora isolato il virus i problemi sono grossi e il virus si diffonde;
quando ci troviamo in presenza di un virus totalmente nuovo come qualche anno fa che cera il virus
dellH5N1 che era partita questa sorta di epidemia che poi stato tutto un fuoco di paglia, anche se era gi
partita lepidemia, ancora il vaccino non cera bisognava metterlo a punto e quindi ci siamo basati di pi
sulla chemioterapia, su dei farmaci specifici contro linfluenza, se vi ricordate quasi tutti gli stati hanno fatto
incetta di farmaci antivirali, antinfluenzali specifici, pronti per combattere la nuova epidemia; poi ci
troviamo in presenza di nuove infezioni come quelle dellaviaria, la SARS che data da un coronavirus, dove
non esistono vaccini e poi quando siamo in presenza di infezioni o malattie che inducono alle
immunosoppressioni dove il vaccino non pu essere sempre usato, specialmente se un vaccino vivo
attenuato che in corso di immunodepressione non possiamo controllare bene le vie che portano al risveglio
dellattivit patologica del vaccino.
Microbiologia - Medicina e Chirurgia polo A 2012/2013 - sbobinature lezioni
154
Come abbiamo detto per i batteri abbiamo molti antibiotici e quasi tutti selettivi (ci sono quelli per i gram
positivi, quelli per i gram negativi, cefalosporine di I, II, III e IV generazione ecc. sempre pi selettivi) mentre
per i virus abbiamo pochissimi farmaci difficilmente selettivi e in molti casi anche tossici. Quindi per andare
a studiare un farmaco in chemioterapia antivirale dobbiamo vedere la selettivit di questo farmaco, questo
farmaco selettivo, quello ideale, dovrebbe essere un farmaco che blocca alcuni stadi specifici della
replicazione del virus ma non altera la cellula infettata e le cellule vicine non infettate, questa una delle
propriet basilari della chemioterapia che quindi dovrebbe interferire con una funzione del virus specifica e
generalmente o perch questa funzione unica (cio ce lha solo il virus) o perch la sua omologa funziona
meno avida, suscettibile nei confronti della molecola. Quindi alcuni bersagli della terapia antivirale
possono essere tutti quegli enzimi che vengono utilizzati o quanto meno sintetizzati dal virus
principalmente e poi in secondi luogo quegli enzimi prodotti dalla cellula ma utilizzati dal virus per la
replicazione come le proteasi, le neuroaminidasi e cos via. Deve interferire con una funzione che non possa
permettere al virus di replicarsi ed essere specifico (distruggere solo eventualmente la cellula infettata e
non quella vicino). Per questo alcuni farmaci, alcune molecole, agiscono solo dopo il loro ingresso
allinterno della cellula e vengono attivati solo allinterno di una cellula infettata.
Dicevamo anche che il farmaco non deve essere tossico, quindi deve essere rapidamente metabolizzato,
solubile in acqua e non in solventi chimici, deve essere stabile dal punto di vista farmacologico e cinetico,
stabile in circolo nel sangue, deve essere facilmente inglobato dalle cellule perch deve agire allinterno
della cellula (generalmente sono pochissime le molecole o i farmaci che agiscono allesterno della cellula e
non hanno un alto potere di difesa), non deve essere allergenico, non deve essere mutagenico, non deve
essere cancerogeno poich andiamo a combattere uninfezione e causiamo un danno al soggetto.
Questo lindice terapeutico che ci permette di stabilire se un farmaco o meno efficace rispetto al virus,
in questo modo oltre a valutare lefficacia andremo anche a quantizzare questa efficacia, perch andremo a
vedere quale la dose minima di questa molecola o di questo farmaco che ci permette di distruggere il
virus e landiamo a paragonare con una dose che pu essere tossica per le cellule. Questo rapporto deve
essere sempre favorevole alla cellula, minime quantit di concentrazione di molecole per il virus e massime
quantit della cellula in modo che cos ne possiamo utilizzare sempre meno in modo che il rapporto debba
essere 1000-10000-10000 se poi arriviamo a un milione significa che possiamo utilizzare pochi nanogrammi
di sostanza ed essere quasi sicuri che non interferiscono con il metabolismo cellulare.
Quali possono essere alcuni bersagli della chemioterapia antivirale?
Sono tutti gli enzimi virali: il virus per replicarsi utilizza i suoi enzimi prodotti, comandati dal suo genoma
(se un dna-virus le dna polimerasi, se un rna-virus le rna polimerasi, mentre se un retrovirus le
trasfertasi inverse) e poi tutti quegli altri enzimi che servono al virus per costruire il capside, per la sintesi
proteica delle sue proteine, per permettere al virus di integrarsi, per permettere al virus di esprimere gli
antigeni di superficie.
Andiamo a rivedere la replicazione virale:
composta da 7 fasi:
-la prima fase quando avviene il riconoscimento dei recettori cellulari da parte dei recettori virali. Questo
potrebbe essere un ottimo bersaglio ma lunico bersaglio che la chemioterapia utilizza un virus fuori dalle
cellule, quindi ancora prima che questo possa entrare allinterno della cellula.
-la seconda fase quella di penetrazione. Anche questa potrebbe essere un ottimo bersaglio non
permettendo al virus di entrare allinterno lasciandolo in superficie o bloccarlo a livello della membrana
-la terza fase la fase di denudamento che linizio della replicazione virale, cio quando il virus si spoglia
delle sue proteine e lacido nucleico comincia a comandare la sintesi delle proteine, se questo non dovesse
Microbiologia - Medicina e Chirurgia polo A 2012/2013 - sbobinature lezioni
155
avvenire grazie a qualche farmaco il virus verrebbe bloccato allinterno della cellula e quindi poi
metabolizzato, eliminato dalla cellula stessa
-la quarta fase la fase di eclissi dove non riveliamo pi la presenza del virus perch tutto scompaginato
-la quinta fase la fase di replicazione vera e propria quando tutti gli enzimi si attivano e si avr la
replicazione del dna o dellrna a livello del nucleo o del citoplasma
-la sesta fase la fase di liberazione costituita dal riassemblaggio del nuovo genoma e delle proteine del
capside.
-la settima fase la maturazione e la fuoriuscita con eventuale formazione di capside e pericapside
Questi sono tutti probabili bersagli della chemioterapia.
Possiamo bloccare i recettori o bloccare la fusione (questo per i virus rivestiti di pericapside) oppure
bloccare lendocitosi per i virus senza pericapside, bloccare le endocitosi oppure bloccare il denudamento
del virus, eventualmente bloccare lintegrazione dellacido nucleico, bloccare la trascrizione, bloccare le
varie modificazioni proteiche che verranno dopo la sintesi proteica cio la fosforilazione, la glicolisi ecc.
bloccare il riassemblamento del virus e eventualmente anche la sua fuoriuscita.
Un esempio il virus dellHIV rivestito di pericapside sulla cui superficie sono espresse la GP120 e la GP41.
La GP 120 serve come riconoscimento dei CD4 presenti sui linfociti e la GP41 poi successivamente servir
per la fusione del virus con la membrana citoplasmatica E con il pericapside virale. Man mano che vengo
tutti questi passaggi avvengono anche dei cambiamenti conformazionali nella membrana citoplasmatica
che si allunga e si contrae in modo tale da avvicinare almeno 2 GP41, in modo da permettere la fusione del
pericapside.
Quali possono essere i punti dove possiamo agire?
Il primo punto sintetizzare dei peptidi che mimano i recettori cellulari e quindi bloccare il processo di
riconoscimento. Per quanto riguarda lHIV abbiamo i CD4 solubili, dei peptidi che sono dei CD4 liberi che
vanno a legarsi alle GP120 del virus e non lo rendono pi disponibile per legarsi ai CD4 cellulari, queste
molecole sono rapidamente degradate e eliminate quindi si pensato di stabilizzarle in qualche maniera
andandole a legare con delle immunoglobuline quindi unimmunoglobulina legata a un CD4, in questa
maniera il peptide diventa pi stabile e rimane pi a lungo in circolo e in questa modo si avuta una
enorme riduzione del virus perch bloccandolo abbiamo ridotto la carica del virus. Per purtroppo il virus
pu modificare lespressione della GP120 e quindi selezionare dei ceppi resistenti che vengono modificati ,
dovremmo quindi cambiare CD4 ogni minuto,prima andare a isolare il virus vedere in cosa si modificato e
ricambiare la CD4.
Altre proteine sono i cosi detti i polianionici o polisolfati, anche questi interferiscono nella fase di
assorbimento del virus specialmente dellHIV, interferiscono cambiando le cariche elettriche anche per
questi per dopo un periodo di utilizzo avremmo dei ceppi resistenti che si selezionano abbastanza
velocemente. Poi abbiamo un altro punto di ancoraggio della chemioterapia che la fusione, cio andare a
bloccare la fusione che avviene in tutti i virus che presentano pericapside, quindi tutti i retrovirus, i
paramixovirus, la famiglia herpetica. Il processo di fusione per quanto riguarda lHIV oltre al CD4 che
quello che viene riconosciuto, utilizza altri chemiorecettori che sono CCN5 e CXCR4 che vengono
riconosciuti e permettono la fusione della membrana citoplasmatica con il pericapside virale. Alcuni farmaci
come la ND-3100 la TAK-779 non fanno altro che legarsi a questi recettori cellulari e bloccarne lutilizzo da
parte del virus, quindi bloccarne la fusione. La CXCR4 una proteina definita fusina che aiuta a fare
avvenire la fusione fra le due membrane, bloccandola con la ND-3100 non avviene pi la fusione, il virus
legato ma non pu pi entrare perch non pu fondere il capside e rimane bloccato allesterno. La stessa
cosa per la TAK-779 che agisce sui CCR5. Poi abbiamo altri peptidi che inibiscono la GP41, come abbiamo
detto lunione di due GP41 permetter la fusione e quindi lingresso del virus, il fatto che si avvicinino due
Microbiologia - Medicina e Chirurgia polo A 2012/2013 - sbobinature lezioni
156
GP41 dato dal cambiamento conformazionale della membrana citoplasmatica della cellula perch si
allunga e si avvicina, andando a bloccare questo cambiamento conformazionale non potr avvenire la
fusione perch le due GP41 rimarranno distanti, una di queste molecole lEnfurvirtide* questa in grado
di bloccare tutti i cambiamenti conformazionali, bloccandoli le due GP41 non entreranno mai in contatto
quindi non permetteranno mai la fusione della membrana. Questa molecola si visto anche essere attiva
su altri virus che presentano il pericapside e che entrano per mezzo della fusione.
Passiamo ai virus che sono nudi, senza pericapside, che presentano solo la struttura capsidica per esempio
la famiglia dei picornavirus, quindi gli enterovirus ecc. I recettori cellulari che riconoscono il corecettore
virale per quanto riguarda per esempio il polio virus il recettore cellulare il CD155, questo CD155
strutturalmente simile a un anticorpo e lega il virus alla stessa maniera di come si lega un anticorpo
infilando una catena allinterno di una depressione presente nelle facce del virus, delle tasche idrofobiche
che possiamo definire come co-recettore virale, questo viene riconosciuto attraverso studi di cristallografia,
attraverso questa tecnica si visto che linterazione tra tasca e farmaco causa un blocco del capside. Gli
antivirali che vengono utilizzati per questo tipo , per questo scopo sono tutti i derivati WIN delle molecole
abbastanza lunghe che mimano il recettore e la catena dellanticorpo e che presentano a unestremit il
gruppo 3 disossi azoto, questo gruppo quello che verr inserito allinterno della tasca e bloccher il flusso
di ioni che permetterebbe al virus di denudarsi. Quindi il virus non verr riconosciuto dai recettori e non
potr entrare e in pi una volta entrato verr bloccato il suo denudamento e rimarr allinterno della cellula
nel vacuolo senza essere denudato e quindi poi verr eliminato direttamente dalla cellula, quindi come se
fungesse da tappo. Quindi non la molecola che lo distrugge ma interferisce in una sua funzione. Altri
composti WIN molto utilizzati nella terapia sono lArildone, il Pleconaril, che sono utilizzati nelle terapia
contro gli enterovirus, tipo polio, eco e coxaghe. Uno dei farmaci pi antichi (la sua conoscenza risale al
1963 circa) era utilizzato come anti epilettico ed era lAmantadina e dal 1966 si notato che era un ottimo
antivirale, poi nel 93 abbiamo avuto un suo derivato che la Rimantadina e sono tutte delle sostanze
ammine delle sostanze diso sotrope (????????50:27- controsbo. Rimane incomprensibile!) queste sostanze
sia luna che laltra allinizio si pensava con le prime prove che erano state fatte che bloccassero solamente
il denudamento del virus influenzale andando a modificare lambiente allinterno dellendosoma, andando
a innalzare il ph allinterno dellendosoma dove racchiuso il virus. Poi dopo si visto che oltre a bloccare
questo denudamento agivano anche sulla maturazione del virus, quindi sulla sua fuoriuscita. La
maturazione del virus avviene nelle cisterne trans dellapparato del Golgi, e anche queste che erano
ambiente acido, e andando a variare il ph il virus che andava a maturarsi non era pi un virus infettante
perch si avevano delle modificazione alle glicoproteine HA che sono gli antigeni di superficie del virus e
quindi avendo delle modifiche su queste antigene sulla ematoglutinine il virus diventava poco infettante,
anche se maturava, andava a produrre infezioni poco infettanti, quindi non potevano andare a infettare le
cellule vicine. Quindi il risultato era sempre quello, si andava verso la guarigione. LAmantadina e la
Rimantadina sono molto efficaci per il controllo dellinfezione dellinfluenza A ma non per la B, e il dosaggio
di poche unit poich in un soggetto immunocompetente andare a prendere lAmantadina ha poco
significato poich la molecola va agire successivamente allinfezione, quindi linfezione gi avvenuta.
Possiamo bloccare leventuale progressione quindi dal punto di vista terapeutico in un soggetto
immunocompetente possiamo abbassare di qualche giorno la sintomatologia, quindi il soggetto guarir
qualche giorno prima del normale, ma dal punto di vista terapeutico sono poco efficaci, per dal punto di
vista della profilassi si visto che stato ridotto di circa il 90% il corso dellepidemia di influenza, quindi
significa che questi farmaci vengono presi in corso di epidemia ma quando ancora il soggetto non ha
manifestato sintomi, quindi vengono presi da quei soggetti che non possono vaccinarsi, da quei soggetti
Microbiologia - Medicina e Chirurgia polo A 2012/2013 - sbobinature lezioni
157
immunocompromessi, da quei soggetti anziani. Infatti pu essere anche una buona alternativa alla
vaccinazione cio per soggetti che non possono vaccinarsi per un motivo o per un altro.
Abbiamo visto assorbimento, fusione, endocitosi, parliamo un poco della replicazione vera e propria.
Quindi il bersaglio delle molecole antivirali sono gli enzimi utili al virus per replicarsi. Quasi tutti virus hanno
bisogno di altri enzimi, di altre polimerasi. Queste polimerasi generalmente sono tutte sintetizzate dal virus,
una volta che il virus entra il suo acido nucleico la prima cosa che fa andare a sintetizzare queste
polimerasi che serviranno per la sua replicazione: una di questa la timidina chinasi specifica dellherpes.
Le molecole che agiscono in modo specifico sono i cosiddetti analoghi nucleosidici. Gli analoghi nucleosidici
sono quelle molecole molto simili o che differiscono per poco con il nucleoside che viene utilizzato
dallacido nucleico, dalle polimerasi ecc. per inglobarlo nellacido nucleico virale. Questi analoghi
nucleosidici vengono somministrati sotto forma di pro farmaci e solo allinterno della cellula vengono
attivati. Vengono trifosforilati** in questa maniera le polimerasi virali generalmente sono molto pi
sensibili a questi analoghi nucleosidici rispetto a quelli cellulari, e la timidina chinasi (che presente anche
nelle cellule normali) una di quelle molecole, di quegli enzimi sintetizzata dal virus quella che ci d la
specificit del farmaco, perch lanalogo viene attivato dalla timidina chinasi, la prima fosforilazione viene
effettuata dalla timidina chinasi virale, poi altre fosforilazioni possono avvenire a causa della timidina
chinasi cellulare ma non ha molta importanza, sar quella virale o cellulare che continuer la fosforilazione.
E in questa maniera la molecola entra allinterno della cellula nella forma pi leggera, con la sua struttura
pi semplice, e solo allinterno della cellula verr fosforilata, quindi diventer pi ingombrante.
Somministrare la molecola gi trifosforilata si ha un ingombro notevole, non entrer nemmeno allinterno
cellula e non potr nemmeno agire, per questo viene utilizzata in queste maniera da molecola semplice
viene inglobata allinterno della cellula e la sua selettivit data dal fatto che sar poi la timidina chinasi o
lenzima virale che lattiver. In questa maniera lanalogo pu entrare dentro anche altre cellule, ma se
queste cellule non portano il virus e quindi non portano la timidina chinasi non agir, non dannegger le
cellule non infettate.
Cosa portano questi analoghi rispetto al nucleoside normale? Portano delle modificazioni dello zucchero.
Una di queste molecole probabilmente la pi nota, la pi diffusa la pi conosciuta lAciclovir un analogo
guanosinico che presenta uno zucchero modificato.
LAciclovir ha unalta selettivit nei confronti dellherpes, della famiglia herpetica in generale, come agisce?
Come funziona? quale il meccanismo di questa molecola?
LAciclovir viene inglobata nella sua forma semplice la timidina chinasi virale fa avvenire la prima
fosforilazione e successivamente alla fine avremo una cicloguanisina trifosfata quindi simile al nucleotide
che deve essere inglobato nella catena del DNA alla GTP normale quella che ci dar poi lallungamento della
catena dellacido nucleico virale. LAciclovir reagisce sia come competitore della GTP normale perch la
cicloGTP ha unaffinit maggiore per legarsi con la GTP normale, e dar il blocco della catena perch si
andr a legare al posto del GTP normale, per essendo ciclico non permetter pi i successivi legami degli
altri nucleotidi, quindi di conseguenza funger come terminatore della catena, si formeranno delle catene
di acido nucleico incomplete non attive, specialmente nel DNA saranno inutilizzate perch non porteranno
tutto il messaggio virale.
LAciclovir molto attivo nelle cheratiti erpetiche per uso topico, generalmente per endovena per herpes
latente, cio lherpes sempre latente per in questo caso intendiamo delle riattivazioni frequenti
dellinfezione, per il genitale si pu usare in tutte le somministrazioni, per si visto che possono
selezionarsi dei mutanti dei sistemi. La mutazione avviene nel gene della timidina chinasi infatti si sono
selezionati alcuni ceppi virali che vengono definiti VK negativi, ma per fortuna questi ceppi sono poco
infettanti, quindi hanno una scarsa importanza. Le molecole di derivazione dallAciclovir sono delle
Microbiologia - Medicina e Chirurgia polo A 2012/2013 - sbobinature lezioni
158
molecole modificate ma che derivano sempre dallAciclovir: il Famciclovir la forma prodrugs dellAciclovir
(generalmente viene somministrato oralmente), il Penciclovir che gi trifosforilato viene somministrato
solo per uso topico. Questi sono tutti farmaci che hanno la stessa origine e tutti hanno lo stesso
meccanismo di azione, lunica differenza che vengono utilizzati in determinate situazioni come il
Vanciclovir o il Valaciclovir vengono utilizzati nelle super infezioni da citomegalovirus in soggetti in AIDS,
vengono utilizzati perch d meno eventuale resistenza, vengono sensibilizzati meno, quindi lunica
differenza che generalmente per una febbre sul labbro non viene utilizzata il Vanciclovir o il Valaciclovir
ma solo lAciclovir poich pi semplice, pi pronto, anche se pu dare dei ceppi delle resistenze non sono
molto attendibili come resistenze, mentre il Vanciclovir o il Valaciclovir sono delle molecole modificate e
vengono utilizzati in soggetti in cui si hanno delle gravi superinfezioni da parte di citomegalovirus, da parte
dellherpes ecc. in soggetti gi immunocompromessi (come soggetti in aids) in modo da non selezionare dei
ceppi resistenti.
Un altro analogo ladenosina arabinoside la Vidarabina, anche questo ha uno zucchero modificato e il suo
meccanismo dazione quello di andare a inibire la polimerasi virale, che sempre pi sensibile rispetto a
quella cellulare per pu avere dei gravi problemi, dei gravi effetti collaterali: seleziona dei mutanti
resistenti con delle polimerasi alterate, e questo poi difficilmente controllabile, pu provocare delle
rotture cromosomiche e quindi un certo potere mutagenico, si visto che nei topi, nei ratti provoca
tumori,nei conigli teratogeno ed poco solubile in acqua e quindi devono essere utilizzate delle soluzioni.
La sua applicazione generalmente topica appunto perch molto tossico, o in forma sistemica viene
utilizzato in corso di encefalite erpetica, quindi in gravi infezioni encefaliche, in corso di herpes neonatale
quando lAciclovir non riesce a controllare linfezione, ed anche attivo per quanto riguarda lepatite B
essendo inibitore della DNA polimerasi e anche lepatite B utilizza la DNA polimerasi e quindi pu essere
bloccato. Altri farmaci che erano gi conosciuti per i retrovirus o gli RNAvirus oncogeni per erano poco
diffusi, ma dopo lavvento e la diffusione dellHIV questi studi sono stati risvegliati e hanno portato
allutilizzo di molecole come la Zidovudina o AZT, questo un analogo strutturale della timidina che in
presenza di trascrittasi inversa (quindi di RNA virus) viene fosforilata al solito dalla chinasi cellulare in
questo caso non dalle chinasi virali, perch tanto vanno a agire sulle trascrittasi inverse che sono virali,
quindi la specificit non la fa chi lattiva, ma dove va a agire, quindi differente dallAciclovir che viene
attivata dagli enzimi prima virali, qua anche se viene attivata dalla chinasi quindi da un enzima cellulare la
molecola poi trifosforilata andr a agire sulle trascrittasi inversa che di origine virale, quindi competono
con la timidina e arrestano, anche questi attraverso laggiunta di un nucleotide, lallungamento della
catena. Inserendosi al posto di un nucleotide normale e bloccando poi lallungamento della catena una
volta trifosforilato verr trasferito tramite la trascrittasi inversa al posto della timidina normale quindi si
avr blocco e formazioni di catene pi piccole mal funzionanti o poco funzionanti. Questo un farmaco
molto attivo per lHIV.
Altri farmaci che presentano delle modificazioni allo zucchero sono la Dideossinosina (DDI) la
Deossicitosina, questi qua sono sempre degli analoghi e sempre agiscono sulle trascrittasi inverse andando
a legarsi al posto del nucleotide normale e quindi bloccando lallungamento; addirittura la DDI anche
attiva sul DNA mitocondriale, questo porta un danno alla cellula.
Altri composti sono tutti derivati e presentano quasi tutti lo stesso meccanismo di attivazione. Lunica
differenza lutilizzo, come utilizzarlo? Quale utilizzarlo? Ecc. basta conoscere eventuali tossicit del
farmaco e capire se il gioco vale la candela.
Abbiamo dei farmaci meno tossici e pi selettivi che agiscono alla stessa maniera ma, per esempio nel caso
dellherpes encefalico, se abbiamo gi un danno grave la tossicit del farmaco passa in secondo piano
poich avremmo uninfezione gi avviata che ha provocato danni seri.
Microbiologia - Medicina e Chirurgia polo A 2012/2013 - sbobinature lezioni
159
Altri analoghi sono gli alogenati perch portano una molecola di iodio o di bromo o di fluoro ecc. questi
hanno una vecchia molecola che priva di una selettivit di azione, questa un analogo della timina (5iodio
2 desossi ) solo che in posizione in posizione 5 presenta un atomo di iodio, non ha nessuna selettivit e
viene inglobato sia dalla cellula normale che da quella infettata,quindi abbastanza tossico. Luso di questo
analogo, quando ancora si stava studiando lAciclovir che quindi era poco sviluppato, avveniva sotto forma
topica nelle chemioterapie erpetiche, eventualmente nella febbre sul labbro, ma mai in forma sistemica,
quindi il danno del farmaco era sempre localizzato al sito per evitare un danno diffuso. La Sorivudina la
stessa.
Abbiamo poi la Trifluorotimidina dove abbiamo 3 atomi di fluoro, poi abbiamo la Bromodeossiuridina.
Sono tutte molecole analoghe cos detti alogenati perch portano degli atomi o di iodio o di bromo o di
fluoro nellanalogo e di conseguenza non sono per niente selettivi, vengono inglobati sia dalla cellula
normale che da quella infettata.
Altri analoghi sono la Lamivudina o 3TC sono tutti analoghi della citidina che presentano nella molecola di
zucchero al posto dellatomo di C un atomo di zolfo. Questi sono delle molecole che agiscono nella
replicazione dellHIV, possiedono una citotossicit minore, la loro azione quella di competere con la
citidintrifosfato normale.
La terapia di queste molecole limitata poich subito si hanno dei ceppi resistenti, per molto utilizzata
in combinazione. Tenete presente che ora parleremo di pi di combinazione di farmaci.
Abbiamo la Lamivudina e lEfarisen che sono inibitori non nucleosidici non competitivi. La Sulftiva (?) viene
utilizzata in combinazione con la Stavuidina e il 3TC in questa maniera diminuisce enormemente la carica
virale in circolo.
Altri farmaci che bene non utilizzare mai da soli sono la leviclapina ([Link]) i derivati dellerpiridone
([Link] entrambi i termini sono incomprensibili e per assonanza non si trova corrispondenza sul web),
sono tutti farmaci che hanno si una buona attivit per hanno anche unalta probabilit di selezionare dei
ceppi resistenti quindi bene non utilizzarli mai da soli o se non il caso di valutare effettivamente il rischio
correlato allutilizzo.
Altri farmaci inibitori sono: il Foscarnet, lAcido FosfonoFormico, questo ha unazione direttamente sulle
polimerasi di tipo competitivo ed abbastanza selettivo perch gi a una concentrazione di 10, 100 volte
pi bassa rispetto alla DNA polimerasi cellulare e quindi rientra nellindice di selettivit. Anche questo
abbastanza tossico, dopo lutilizzo lo ritroviamo nelle ossa, nei reni in cui molto tossico. Anche questo
forma dei ceppi resistenti e quindi va valutato il suo utilizzo con i rischi che pu dare, il fatto che questo
farmaco si accumula nelle ossa evidente che non si pu trattare il soggetto per mesi e mesi con questo
farmaco, ma gi come si abbassa la sintomatologia si pu cambiare farmaco e utilizzarne qualcuno pi
leggero.
Altri inibitori la Ribavirina che un analogo della guanosina, inibisce sia virus a DNA che a RNA, agisce sulla
formazione dellRNA messaggero , la sua forma monofosfata blocca lenzima cellulare inosina-5-fosfato, e
quindi blocca la sintesi della GTP, della gonosintrifosfato. Generalmente utilizzato per via orale quindi per
aerosol. Anche questo abbastanza tossico e viene usato in corso di infezioni abbastanza esotiche come
per esempio il virus lasse, il virus della febbre emorragica e si pu utilizzare solo se una chiara infezione se
no abbiamo altri farmaci, per esempio nel caso del virus respiratorio sinciziale questo pu essere utilizzato
in presenza di una grave infezione altrimenti si preferisce luso del CHINETTI (??***01.27.01)
Altre molecole sono i RIBOZIMI.
Sono molecole di RNA che hanno unattivit catalitica cio tagliano gli acidi nucleici.
Una di questi lEptazima che spezza, taglia gli RNA di quasi tutti i sierotipi del virus dellepatite C e li taglia
in sezioni che sono altamente conservate, in modo tale di ridurre le possibilit che il virus possa sviluppare
una resistenza. In questa maniera riesce a bloccare la replicazione del virus dellepatite C.
Microbiologia - Medicina e Chirurgia polo A 2012/2013 - sbobinature lezioni
160
Inibitori della sintesi proteica al momento non ne abbiamo. Il virus pu produrre le sue proteine ma
generalmente per molti virus la sintesi proteica non una sintesi proteica diretta, generalmente si ha la
sintesi di proteine lunghe, proteine grosse che al momento non sono attive, solo successivamente sono
attive grazie alla proteolisi, glicolisilazione, al clivaggio. Ricordiamo che lmRNA virale entrato nella cellula
va direttamente nel ribosomi e sintetizza una poliproteina e solo successivamente verr tagliata dagli
enzimi della cellula e diventa attiva. Si formeranno le proteine strutturali e le proteine funzionali quindi altri
enzimi che serviranno alla replicazione del virus. E questo quello che viene anche per lHIV che sintetizza
una glicoproteina che viene definita GP160 che per non attiva, solo unassociazione di questa proteina
con le proteasi permette al virus di diventare infettante, perch le proteasi taglieranno questa proteina in
due, in GP120 e GP41 che mostrate sul pericapside permetteranno al virus di infettare le cellule, ma se noi
la blocchiamo prima del taglio da parte delle proteasi si formaranno dei virioni con una GP160 che non
hanno nessuna caratteristica infettante e quindi il virione non potr infettare nessuna cellula, non
riconoscer nessun CD4 di conseguenza non potr legarsi e non ci sar fusione. Questo genoma dellHIV
dove presente questa poliproteina esprimeranno sia questa proteina che le proteasi che permetteranno il
taglio di queste glicoproteine.
Poi abbiamo anche gli inibitori del processing cio una volta che il virus ha sintetizzato una proteina,
questa proteina deve essere processata, glicosilata per poter essere attiva, e possiamo avere degli inibitori
sia per le proteasi che sono delle corte sequenze amminoacidiche che bloccano le proteasi, questi
utilizzandoli abbiamo un rallentamento della progressione della malattia, ma non il suo blocco, quindi
rallentiamo la carica virale ma non il suo blocco e come controindicazione possiamo avere un accumulo di
mutazioni multiple che porteranno poi questo gene a sviluppare unalta resistenza del virus nei confronti
dei farmaci. Le mutazioni si andranno ad accumulare sempre nel genotipo, il farmaco non reagir pi
perch ci troveremo davanti un virus nuovo che non potr essere bloccato, infatti per questo possiamo
rallentare la malattia ma non bloccarla, poich fin quando non avremo la mutazione del virus il farmaco
agisce, ma una volta che questa molecola reagisce e il virus accumula mutazioni dobbiamo cambiare il
farmaco e ce ne accorgiamo subito ma solo quando aumenter la carica virale in circolo.
Farmaci che inibiscono le proteasi sono il Saquinavir, il Ritonavir, lAmprenavir, questi vengono utilizzati in
corso di terapia per HIV, anche in questo caso non vengono mai utilizzati da soli perch istaurano
frequentemente e velocemente resistenza. Utilizzandoli in associazione si visto che riduce la viremia
notevolmente, addirittura si hanno cellule T4 positive e il paziente riprende in parte una certa
immunoprotezione, quindi non pi tanto immunocompromesso ma il suo sistema immunitario sta
reagendo con la produzione di nuovi linfociti T4.
Il Ritonavir abbassa la mortalit di circa il 58%, lAngersiasi invece un altro inibitore che viene sempre
utilizzato in azione con altri farmaci. LIndinavir riduce la carica dell85% sempre se utilizzato in
associazione con altri farmaci.
Nuovi protocolli di terapia nei confronti dellHIV - Highly Active Anti-Retroviral Therapy
Si visto che in alcuni casi i singoli antivirali anche se abbastanza selettivi, possono portare nellutilizzo in
tempi lunghi a ceppi resistenti, a selezionare dei ceppi virali che hanno aggirato lostacolo. Il virus una volta
riconosciuta la molecola farmacologica mettono in campo delle difese proprie, mutano quel determinato
sito di riconoscimento, quel determinato enzima e diventano resistenti ai singoli chemioterapici. Quindi
bene quando viene messo a punto questo protocollo andare a utilizzare diversi farmaci che abbiano diverse
molecole che abbiano un obbiettivo o un bersaglio differente luno dallaltro, cosi come deve essere
differente il meccanismo dazione. Questa terapia, questo protocollo ritarda di molto la farmaco resistenza,
Microbiologia - Medicina e Chirurgia polo A 2012/2013 - sbobinature lezioni
161
ritarda anche gli effetti tossici poich utilizzando il farmaco singolarmente dobbiamo somministrare delle
concentrazioni di farmaco, che dipendono dalle caratteristiche farmaco cinetiche, tali da essere sempre
disponibili nellarco delle 24 ore e alla stessa concentrazione di cibo e che raggiunga tutti gli organi, quindi
abbiamo bisogno di concentrazioni molto elevate poich possono essere facilmente degradate nel giro di
qualche ora. In questa maniera possiamo utilizzare delle concentrazioni di singoli farmaci molto pi basse
quindi avere un effetto tossico molto inferiore rispetto alla tossicit del singolo farmaco.
Generalmente la terapia chiamata HAART costituita da 3 diversi analoghi nucleosidici, oppure da un
analogo nucleosidico e pi analoghi non-nucleosidici, oppure un analogo nucleotidico, un non analogo
nucleosidico e un inibitore della proteasi, a questi possiamo aggiungere anche un CD4 solubile per bloccare
linfezione virale in tutte le sue fasi. Questa ha portato nellarco degli anni a una riduzione delle
concentrazioni dei singoli farmaci. La terapia anti HIV era segnata nel tempo dalla concentrazione dei
farmaci in circolo, poich dovevano essere ripristinate le concentrazioni immediatamente perch se no il
beneficio che aveva avuto la prima somministrazione veniva vanificato dallassenza del farmaco dopo 4 ore.
Quindi la vita del soggetto sieropositivo era scandita dallutilizzo dei vari farmaci: alle 8 una pillola, alle 9
unaltra pillola che agiva su unaltra molecola e cos via. Oggi si arrivato al punto che bastano 2 pillole a
concentrazione di farmaco molto basse e quindi la vita del soggetto affetto da HIV abbastanza normale e
non scandita dagli orari di ogni pillola. Con questo protocollo si visto che nellarco di poco tempo si
abbassata notevolmente la carica virale in circolo e dopo almeno un anno dallutilizzo di questo protocollo,
di questi farmaci, si azzerata totalmente, non si riscontrava pi acido nucleico in giro. Non diciamo che
guarito ma non c virus replicante in circolo. Quindi non si ha la progressione dei danni eventualmente.
Altro bersaglio farmacologico lestrazione, la fuoriuscita del virus. Uno di questi farmaci attivo sul virus
dellinfluenza perch lunico virus che una volta che fuoriesce ha bisogno per essere completo di due
proteine di superficie che sono lHA (emoaggluttinina) e la NA (neuraminidasi). Lemoaggluttinina permette
al virus di riconoscere il sito e quindi di infettare e bloccare la cellula, mentre la neuraminidasi ha due
funzioni: permette al virus di penetrare nella mucosa , quindi arrivare a livello del tessuto sottostante, e
permette al virus di uscire dalla cellula infettata.
Il Tamiflu e l Oseltamivir sono due farmaci che inibiscono lazione della neuraminidasi virale. I virioni liberi
una volta che sono nel mezzo possono agglutinarsi gli uni agli altri perch lemoaglutinina presente fa
agglutinare gli altri virioni, i virioni liberi tramite lNA possono anche ancorarsi alle mucose e quindi
rimanere bloccati, ma la neuraminidasi che presente permette il rilascio di questi virioni, che si sono
agglutinati quindi pronti per andare a infettare nuove cellule, e permette anche il distacco dei virus che si
sono ancorati alla mucosa. Quindi andando noi con lOseltamivir o il Tamiflu ad inibire la neuraminidasi
virali abbiamo il blocco dellinfezione. Il virus per uscire si deve rivestire del pericapside dove espresso sia
lHA che lNA, ma se per caso fuori c un virus nuovo (un virione completo) questo blocca i siti quindi il
virus non potr pi uscire. Andando a inibire la neuraminidasi che presente nel virione il virus non potr
pi uscire.
*il prof. Sembra dire EFURTIDE, cercando la molecola su internet non riesco a trovare assolutamente
NULLA! Lunico inibitore della fusione che sono riuscita a trovare con un nome simile lENFURVIRTIDE, che
penso essere il farmaco che il prof. voleva citare, nel dubbio aggiungo il link dove questo farmaco viene
descritto.
[Link]
Microbiologia - Medicina e Chirurgia polo A 2012/2013 - sbobinature lezioni
162
** Al min. 58.02 il prof. sembra dire che lattivazione degli analoghi nucleosidici consiste nellessere questi
crifosportati, su internet non ho trovato nulla del genere quindi cercando info ho trovato un file in cui si
spiega che lattivazione consiste nella FOSFORILAZIONE da parte degli enzimi cellulari. Allego il link
[Link]
*** secondo differenti fonti sul web il virus respiratorio sinciziale viene trattato con la ribavidina, di questo
chinetti nessuna traccia!
[Link]
[Link]
Lezione 12
Oggi parleremo di un gruppo di microrganismi responsabili di fetopatie, questi vengono racchiusi sotto
lacronimo TORCH di cui fanno parte virus, protozoi e batteri, questi agenti hanno in comune il causare
infezioni a livello fetale. Possono causare infezioni mediante lattraversamento della placenta, mediante la
via ematica, linfatica e quello che vanno a causare quando va bene laborto, ma anche gravi
malformazioni che il soggetto porter per tutta la vita e diverse sindromi patologiche che spesso si
manifesteranno dopo la nascita anche a distanza di tempo. Capite bene che tutte queste patologie hanno
delle grosse ripercussioni a livello sociale. Se vi ricordate laltra volta abbiamo parlato delle vie di
trasmissione in questo caso di tipo verticale, quindi attraverso la placenta, il contatto madre-feto o
attraverso il cordone ombelicale.
I maggiori responsabili di fetopatie sono il Citomegalovirus, lHIV, la Rosolia, poi abbiamo le infezioni
cosiddette perinatali, contratte al momento dellattraversamento del canale del parto di cui sono
responsabili anche batteri, e infine le infezioni post natali dove rientrano come vie di trasmissione il latte, il
sangue, la saliva, le vie di contatto con la madre.
Cosa si racchiude nellacronimo TORCH?
T : TOXOPLASMA, ne parlerete in parassitologia, un protozoo.
R : ROSOLIA
C : CITOMEGALOVIRUS
H : la famiglia degli HERPES VIRUS
Anticamente nellacronimo era presente anche una S che stava per SIFILIDE che per attualmente stata
levata, non perche scomparsa linfezione da madre a feto ma perch le percentuali di rischio oggi sono
notevolmente diminuite rispetto agli agenti TORCH veri e propri.
O : OTHERS
Nella classe degli others inseriamo HIV, EPATITE B, EPATITE C E PARVOVIRUS, tutti quegli agenti che
possono causare AIDS neonatale o epatite neonatale,. Il parvovirus anche se poco diffuso pu causare
morte neonatale. A questi si aggingono gli ENTEROVIRUS e i COXSACKIE che possono causare malformazioni
cardiache a livello del feto, i PAPILLOMA VIRUS che causano generalmente una papillomatosi post natale. In
passato si credeva che anche virus come quello dellinfluenza e morbillo il morbillo fossero pericolosi per la
Microbiologia - Medicina e Chirurgia polo A 2012/2013 - sbobinature lezioni
163
gestante, oggi si arrivati alla conclusione che questi non danno delle alterazioni dirette al feto e possono
essere controllati facilmente. Negli others troviamo anche dei batteri, quali: STREPTOCOCCO, NEISSERIA,
TREPONEMA (che stato eliminato dallacronimo principale ma rimasto sempre come un fattore di
rischio, in quanto possibile infezione trasmessa da madre a feto), CLAMIDIE (responsabili anche di aborti)
probabilmente anche i MICOPLASMI.
Quali sono le modalit di infezione?
Abbiamo detto che uninfezione embrio/fetale avviene durante la gravidanza, uninfezione perinatale
trasmessa al momento del parto e linfezione neonatale dopo la nascita. Non sempre per uninfezione
sfocia in una malattia, devono concorrere molti altri fattori, sia in un soggetto immunocompetente, che a
maggior ragione in un soggetto gestante, concetto che avevamo gi espresso per tutte le altre infezioni.
Le vie di trasmissione, come arriva questo agente al feto, let gestazionale della gravida, lo stato
immunitario della gestante, la velocit di trasmissione degli anticorpi dalla madre al feto, questi sono tutti
fattori che bisogner tener conto nel momento in cui ci troviamo di fronte ad un infezione in gravidanza.
Ora passiamo alla descrizione dei singoli virus.
ROSOLIA
Questo virus appartiene alla famiglia dei togavirus, genere rubivirus.
Viene trasmesso per contatto diretto, contagio interumano, quindi direttamente da uomo a uomo. un
virus a RNA, singola catena di senso positivo con capside e pericapside. Abbastanza piccolo, tra i 40 e 70
nanometri.
Questo RNA di senso positivo funge da RNA messaggero, una volta denudato dal suo capside i ribosomi
cellulari trascrivono una poliproteina che poi verr attivata in tante proteine pi piccole che sono le
proteina funzionali sia dal punto di vista funzionale che dal punto di vista enzimatico, si avr quindi la
replicazione come abbiamo visto per altri virus.
Vi dicevo che il virus rivestito da pericapside quindi molto labile e perde quindi facilmente la sua
infettivit se trattato con agenti chimico-fisici molto forti, radiazioni, acidi, etere formalina ecc per questo
ha bisogno di una trasmissione diretta da uomo a uomo, non esiste nellambiente esterno. Luomo lunico
ospite e funge da serbatoio, anche se non un vero e proprio serbatoio. La penetrazione avviene
attraverso le mucose respiratorie, d una prima replicazione a livello dei linfonodi cervicali, dopo di che
persiste in circolo almeno una settimana, successivamente si manifesta lesantema e si formano dei
complessi antigene-anticorpo circolanti. Per un paio di settimane lo possiamo ritrovare nel naso-faringe e
questo lunico momento in cui si pu tentare un isolamento, dopo di che il virus una volta dato
lesantema non possiamo pi isolarlo, quindi sar impossibile fare una diagnosi con isolamento del virus.
Nella maggior parte dei casi, soprattutto nei soggetti immunocompetenti, passa in forma asintomatica
subclinica.
In alcuni casi pu essere accompagnata, specialmente nei bambini, da lieve febbre, malessere,
infiammazione della faringe, arrossamento, fotofobia, linfadenopatia, la cosa poi pi evidente lesantema,
che generalmente costituito da lesioni maculo-papulari e ha una progressione che va dal viso, tronco, arti
superiori e arti inferiori.
Perche diciamo tutte queste cose? Tenete presente che questi segni clinici vi servono per fare una diagnosi
differenziata rispetto ad altre malattie esantematiche, come il morbillo
La lieve febbre spesso non rilevata, larrossamento e la fotofobia sono caratteristiche della rosolia, febbre
elevata, macchie di Kplik e lesantema (perch lesantema uguale per entrambe lunica differenza
dove ha avuto origine lesantema) se questo progredisce dal tronco agli arti e poi al viso siamo in presenza
Microbiologia - Medicina e Chirurgia polo A 2012/2013 - sbobinature lezioni
164
di morbillo, se invece lesantema progredisce dal viso al tronco e cosi via quasi sicuramente siamo in
presenza di rosolia, questo se il paziente lo ricorda.
Possiamo avere anche delle manifestazioni transitorie alle articolazioni come poliartralgie, poliartrite,
generalmente questi compaiono in soggetti che sono gi stati vaccinati, in corso di epidemia. Queste sono
delle manifestazioni esantematiche.
Attualmente linfezione in Italia sotto controllo, in America hanno utilizzato invece un protocollo, una
strategia di vaccinazione di massa, a tappeto e linfezione si ridotta di circa il 95% non ci sono quasi pi
casi di rosolia, in questo caso vero che i soggetti sono tutti protetti, non contrarranno linfezione, ci sar
per una sparsa circolazione del virus selvaggio, in questo modo non si avr un impopolamento (???? Min.
33.50) della memoria immunologica e i soggetti saranno tutti vaccinati, avranno il loro titolo anticorpale
non entreranno pi in contatto con il virus e non ci sar una stimolazione anticorpale, i titoli rimarranno
sempre costanti, sempre quelli, lunica protezione che avranno quella che tutta la popolazione stata
vaccinata, sia essa maschile o femminile. In Italia invece si ha avuto una strategia diversa, la vaccinazione
intanto facoltativa in et pediatrica e generalmente quasi obbligatoria nelle donne prima della
gravidanza se le donne sono sieronegative, in questo modo in Italia abbiamo la circolazione del virus quindi
i soggetti che non sono stati vaccinati possono aver contratto linfezione, quindi avere unimmunit propria
e una protezione maggiore rispetto a quella data dal vaccino. In Italia la circolazione abbastanza fluida. In
ogni caso soggetti femminili in et pre-pubere, post puberale ecc bene controllarli ed eventualmente se
sono sieronegativi vaccinare. Una volta vaccinati controllare se il vaccino ha attecchito quindi controllare se
hanno un titolo anticorpale idoneo alla protezione.
Linfezione della madre.
Generalmente il virus della rosolia ha 15 giorni di incubazione, tra i 7 e i 10 giorni va incontro a viremia, a
questo punto il virus libero di arrivare a livello fetale e pu causare uninfezione intrauterina. Cosa
bisogna poi valutare?
Let gestazionale della madre, se siamo in presenza di una fase precoce della gestazione, intorno alla XIIXVI settimana ci sono alti rischi se linfezione passata al feto di embriopatie malformanti, siamo in
presenza quasi dell85%. Se invece siamo in una fase ancora pi precoce, quindi intorno alla IIX settimana
c il 20% di probabilit di aborto nell80 invece abbiamo gravissime malformazioni. Se tutto ci avviene in
una fase tardiva anche se il virus passato a livello fetale nasce senza manifestazione di nessun genere,
quindi il feto ha contratto linfezione ne pi ne meno come un adulto.
Meccanismo patologico del virus.
A livello del concepimento il virus d un blocco della moltiplicazione cellulare, ecco perch necessario
andare a valutare la settimana effettiva di gestazione della madre. D un blocco dellorganogenesi e in base
a quale mese si possono valutare anche eventuali danni, se linfezione viene contratta in fase tardiva
lorganogenesi gi avvenuta, il feto ha tutti gli organi gi formati, funzionanti, quindi il virus non pu pi
bloccare la duplicazione cellulare. Nessun tipo di malformazione fetale. Un solo caso in un particolare
momento della gravidanza,. Il virus della rosolia, abbiamo detto ve lo ricordate, un esempio di infezione
acuta, linfezione successivamente ad eventuali patologie viene eliminata grazie al sistema immunitario del
soggetto, d quindi uninfezione acuta. Il virus in un solo caso pu dare infezioni croniche resistenti
generalmente data solo in gravidanza, non in soggetti adulti e solo in un periodo particolare della
gravidanza, intorno al VI mese quando il feto sta sviluppando il sistema immunitario, in presenza del virus
in loco il feto riconosce il virus come un self, quindi il suo sistema immunitario riconoscer il virus come
qualcosa che appartiene al feto stesso, di conseguenza ci sar presenza del virus, di anticorpi i quali non
elimineranno il virus ma si legheranno al virus con formazione di immunocomplessi, il danno eventuale alla
Microbiologia - Medicina e Chirurgia polo A 2012/2013 - sbobinature lezioni
165
nascita quello dato da immunocomplessi, non direttamente dal virus, questo lunico caso in cui si ha
infezione da rosolia permanente di tipo cronico.
Mostra uno schema che racchiude tutte le patologie a cui si va incontro se linfezione contratta entro il
quarto mese, quindi prima che finisca lorganogenesi, come vedete sono tutte di tipo progressivo e
permanente, molto gravi, la maggior parte di queste patologie permangono per tutta la vita.
Mostra uno schema delle patologie che insorgono tardivamente se linfezione avviene dopo il sesto mese,
alcune anche queste di tipo progressive, lievi se paragonate a quelle del quadro precedente. Come vedete
sono patologie che segnano inevitabilmente la vita del nascituro, tra queste ritroviamo: opacizzazione della
corna, diabete mellito, catarratta congenita che con il tempo potr essere operata, rush emorragico che
pu insorgere tardivamente dopo al nascita.
Quali sono i fattori che danno la criticit dellinfezione?
Pu avvenire linfezione nella madre ma non detto che passi anche allutero, se passa e si ha uninfezione
intrauterina, pu dare delle malformazioni, ma non detto. Questo dipende sempre dallespressivit
dellinfezione, lespressivit data dalla carica virale che passa, dallo stato della madre se riesce a
rispondere velocemente e produrre anticorpi, dal momento della gestazione, la fase precisa della
gestazione, tutto questo dovrebbe essere considerato, questa espressivit dellinfezione deve essere tenuta
conto. Non detto che una volta diagnosticata linfezione primaria da rosolia in gravidanza sia necessario
laborto terapeutico perch i rischi di malformazione sono gravi, bisogna prima valutare i vari rischi in
relazione al momento della gravidanza. Un esempio pu essere dato da alcuni dati di laboratorio:
Soggetto in XIII settimana, quindi in piena evoluzione, presenta alta positivit degli anticorpi, IgG e
IgM nei confronti della rosolia. La ricerca delle IgM fetali risulta positivo, il neonato nascer con titolo
anticorpale IgM elevato e tutta la sintomatologia con malformazione, ecc da infezione da rosolia in
corso di gravidanza.
Soggetto in XV settimana, titolo anticorpale IgG e IgM della madre medio, non sono stati rilevati IgM
fetali, il bambino nasce sano.
Quindi se ci fermiamo solo a questo punto abbiamo il 50 % di probabilit che il bambino nasca malformato
o meno. Anche nel caso di vaccinazione, spesso successo che un soggetto vaccinato senza sapere di
essere in corso di gravidanza, evidente che la vaccinazione non pu essere effettuata in corso di
gravidanza perch stiamo utilizzando un virus vivo ma attenuato, anche se il ceppo virale non un ceppo
che da problemi in corso di gravidanza i rischi noi non li possiamo prevedere. Altri casi in presenza per di
ceppo vaccinale:
Soggetto alla XIII settimana, vaccinato con presenza di anticorpi questa non titoler, andiamo a
saggiare il sangue fetale e troviamo presenza di IgM, il soggetto andata direttamente in aborto,
come se avesse contratto linfezione da virus selvaggio entro il primo trimestre.
Soggetto che presenta anticorpi IgG e IgM a basso titolo, presenza anche di IgM fetali, il neonato
nasce sano, stiamo parlando sempre di un ceppo vaccinale e non di un virus selvaggio quindi dovete
tenere conto della diversa infettivit, molto attutita nel ceppo vaccinale anche se dovesse passare a
livello embrionale.
Nel primo caso ha causato il massimo quindi si attivato in una forma totale, blocco dellembriogenesi e
aborto spontaneo; nel secondo caso il virus ha stimolato il sistema immunitario fetale ma non ha causato
nessun tipo di patologie e cosi via. Ecco perch bene valutare i singoli casi, caso per caso.
Microbiologia - Medicina e Chirurgia polo A 2012/2013 - sbobinature lezioni
166
La vaccinazione, lunico mezzo che abbiamo come profilassi, il ceppo abbiamo visto laltra volta lRA
27/3. Dimenticavo i casi precedenti erano con il ceppo HPV77E5 (o HBV77E5) che stato tolto dal
commercio perch poteva manifestare riattivazione da parte del virus. Sono vaccini attenuati che
detengono una risposta valida dei titoli di protezione, di persistenza di questa immunit, stimolano anche
gli anticorpi di classe A e infatti il ceppo attualmente utilizzato sembra non dia nessun tipo di problema a
livello fetale, diciamo sembra perch non possiamo avere la certezza al 100% .
Per quanto riguarda la rosolia non c nessun tipo di terapia che si possa attuare in corso di gravidanza.
CITOMEGALOVIRUS
Il citomegalovirus fa parte della famiglia degli herpes virus, un virus a DNA rivestito di pericapside.
Linfezione da citomegalovirus molto diffusa si stima che quasi il 70% della popolazione sia sieropositiva.
La diffusione avviene generalmente nella prima infanzia, nella maggior parte dei casi, quindi in et scolare.
uninfezione che pu essere trasmessa anche per contatto sessuale, via ematica, contagio diretto questo
perch il virus d latenza negli epiteli ed contenuto in varie secrezioni quali saliva, urine, secrezioni
vaginali, sperma; trasmissibile attraverso la via ematica, trasmissibile per donazione dorgano quindi con
il trapianto. Ha acquisito molta importanza anche per la sua presenza nei soggetti immunocompromessi
esempio AIDS o per quanto riguarda i trapianti. Il cito ha alte probabilit di essere trasmesso nei casi di
politrasfusi, facilmente trasferibile da un soggetto ad un altro perch non viene effettuato nessun tipo di
screening perch si pensa che essendo cos diffuso anche il soggetto che riceve una trasfusione o un organo
sia positivo quindi che potrebbe gestire linfezione, in quel caso sorgono altri problemi perch linfezione
pu essere esogena o endogena. Endogena se si riattiva un virus gi presente nellorganismo, un soggetto
trapiantato va incontro a immunodepressione e abbassando le difese uninfezione latente da
citomegalovirus si pu risvegliare. Quindi riattivazione endogena. Oppure una riattivazione esogena dove la
trasfusione o lorgano porta un nuovo citomegalovirus, in un soggetto immunodepresso porta gravi
complicazioni, uninfezione che invece nella maggior parte dei casi banale e passa in forma asintomatica.
Quando non si presenta informa asintomatica lunica sintomatologia visibile dal punto di vista clinico una
simil mononucleosi, ma chiaramente si ci pu accorgere di questa infezione solo quando vediamo un
soggetto che presenta una febbre ondulante lunga nel tempo, dei dolori muscolari, e se siamo fortunati dal
punto di vista clinico delle linfadenopatie quindi lingrossamento dei linfonodi non ascrivibile a nessunaltra
cosa. Alterazioni della funzionalit epatica, il virus pu dare un epatite che viene classificata come epatite
non A non B non C, una splenomegalia, con prelievo di sangue ci possiamo anche accorgere indirettamente
della sua presenza andando a valutare i linfociti atipici, pu dare anche degli esantemi che si manifestano
solo su tronco e arti. Sia nellinfezione primaria, quindi nel primo contatto che abbiamo avuto, che nella
riattivazione si possono manifestare come epatiti, andiamo a curare lepatite, la polmonite e non
ricerchiamo il cito. Possiamo avere delle miocarditi o pericarditi, la porpora, unanemia, man mano se non
regrediscono solo successivamente si va a cercare il cito quando la sintomatologia si prolunga nel tempo,
quando i maker delle epatiti sono risultati negativi, se sospettiamo uninfezione da cito per un polmonite
possiamo andare a ricercare il cito, per se la sintomatologia regredisce in presenza di terapia antibiotica
sar stato qualche batterio a causare al polmonite. Pu dare anche un coinvolgimento del sistema nervoso
ecco la sua importanza oltre che nelle gestanti nelle infezioni era quella dei politrasfusi, soggetti AIDS e nei
trapianti.
Quali sono i rischi di uninfezione congenita da cito?
Generalmente sono molto basse le percentuali di rischio di prima infezione nelle gestanti, sono basse
perch dicevamo che il soggetto sar stato infettato, quindi al massimo il soggetto potr avere una
Microbiologia - Medicina e Chirurgia polo A 2012/2013 - sbobinature lezioni
167
riattivazione. Viremia, quindi trasporto del virus mediante il sangue, arriva al feto e nel 30-40% dei casi pu
dare un infezione intrauterina. Nelle riattivazioni, che sono pi frequenti, il virus pu dare una viremia,
quindi circolare con il sangue, possiamo avere uninfezione ovarica se non arriva a livello dellovocita
possiamo avere uninfezione endometriale se la latenza a livello dellendometrio, uninfezione retrograda
cio il risalire del virus dalle zone cervico-vaginali, un po difficile ma alcuni sono stati descritti quindi
bisogna tenerne conto. Linfezione uterina pu avvenire nello 0,5% - 2% dei casi, quindi molto bassa come
rischio. I nati infetti sono circa tra il 10% e il 15% possono manifestare dei sintomi alla nascita. Altrimenti
dal punto di vista clinico la maggior parte sono normali, e solo un piccolissima percentuale potrebbe
manifestare dei difetti solo tardivamente come una mancanza di attenzione del bambino, un bambino
troppo vispo, troppo attivo, o un bambino troppo addormentato, questi sono i segni clinici di una probabile
infezione da cito con difetti tardivi che rientrano tra questi 10-15% dei casi, una sintomatologia
compatibilissima con la vita, difficile distinguere un soggetto che ha avuto infezione da cito da uno che
non ne ha avuta durante la vita embrionale. Questa mancanza di attenzione che si pu manifestare
difficile poi da riportare ad una infezione in gravidanza.
La differenza tra cito e rosolia come danno embrionale che la rosolia d il blocco dellorganogenesi e della
moltiplicazione cellulare, il cito lisa invece direttamente le cellule, quindi non si avr lorganogenesi per
mancanza delle cellule che saranno tutte rotte o lisate, ha un notevole effetto citolitico, distrugge lorgano
anche se met formato. Generalmente nel periodo precoce della gravidanza linfezione porta allaborto,
proprio perch distrugge completamente lorgano. Nel periodo tardivo invece abbiamo una manifestazione
delle varie malformazioni soprattutto a livello neurologico. Vi dar uno schema delle varie patologie
descritte per uninfezione da cito in corso di gravidanza: lesione del SNC, encefaliti, microcefalia, diplegia,
atrofia, cecit, sordit, ritardo mentale di vario grado che pu variare dalla mancanza di attenzione che si
manifester tardivamente fino a d un ritardo mentale vero e proprio. Nel 20% dei casi queste lesioni sono
completamente incompatibili con la vita. Le lesioni viscerali, la cosiddetta sindrome citomegalica, ritardo
nella crescita, ittero, epatosplenomegalia, encefalite, epatite, polmonite sono tutte una serie di
manifestazioni che possiamo anche riscontrare nelladulto, queste intervengono solo occasionalmente, non
sono delle manifestazione che possiamo ascrivere ad un infezione da cito, possono essere delle
conseguenze successive allinfezione, ma ritenere responsabile il cito per un ernia inguinale difficile, una
conseguenza non la causa.
Mostra il quadro radiologico di una calcificazione endocranica in un neonato.
Epatosplenomegalia, il neonato nasce con epatosplenomegalia molto evidente.
Poi abbiamo le infezioni peri e post natali. Abbiamo casi in cui il virus presente nelle secrezioni vaginali e
pu essere trasmesso al feto in corso di replicazione virale, nel momento in cui il feto attraversa il canale
del parto. Oppure abbiamo detto che il virus presente anche nel latte durante lallattamento, questa la
via pi frequente rispetto a quella del canale del parto, qui siamo in presenza circa del 13% dei casi.
Ad oggi non abbiamo nessun tipo di terapia idonea e adatta per un infezione o una riattivazione in corso di
gravidanza. I farmaci abbiamo visto attivi per il cito come il ganciclovir per via endovenosa che non pu
essere utilizzato quindi durante la gravidanza.
Vaccini per il cito non ne sono stati approntati.
Lunica cosa che possiamo fare la prevenzione attraverso il monitoraggio sierologico, quindi andare a
monitorare prima della gravidanza lo stato immunitario del soggetto, se questo sieropositivo se ha
presenza di anticorpi di classe G, dopo di che durante la gravidanza se il soggetto negativo bisogna
ripetere lesame almeno per i primi sei mesi, dopo di che non si pu pi fare nulla. Quindi un primo prelievo
prima della gravidanza o subito dopo il concepimento entro i primi sei mesi, se siamo sieronegativi
completamente controlli per almeno sei mesi, perch dopo di che non si pu pi intervenire dal punto di
Microbiologia - Medicina e Chirurgia polo A 2012/2013 - sbobinature lezioni
168
vista terapeutico perch se le percentuali sono molto alte di malformazioni non si pu pi procedere con
laborto terapeutico. Se il soggetto positivo alle G ma sicuramente negativo alle M, quindi non siamo in
presenza di infezione primaria, linfezione passata e il soggetto protetto, tra virgolette, perch questa
sempre un infezione latente. Se siamo in presenza di G positive e M positive abbiamo uninfezione primaria
acuta in atto, quindi andare a valutare le IgG per vedere se sono state prodotte da pi o meno 3 mesi, a
seconda della sensibilit del test che viene attuato si pu stabilire se sono di tre o sei mesi di distanza e
quindi andare a valutare se linfezione stata contratta tre mesi prima o dopo, in questo modo se gi pi
di tre mesi si possono valutare i rischi, se il soggetto al secondo mese possiamo trovarci in una situazione
dove abbiamo IgG positive e M negative, quindi la madre pu gi proteggere il feto e in base ai dati
possiamo dire che linfezione si presentata prima della gravidanza.
Se invece le IgG sono molto giovani siamo in presenza di prima infezione, quindi con uninfezione in atto si
procede con una diagnosi pi approfondita. Nel caso in cui si abbiano G negative e M positive il controllo
deve essere ripetuto almeno dopo 15-20 giorni in modo cos da valutare il movimento degli anticorpi, se
nel primo prelievo erano G negative e M positive quello che ci aspettiamo che dopo 15gg anche le G
diventino positive se linfezione in atto, abbiamo la siero conversione da negativo a positivo. Se invece
questo prelievo presenta G negative e M positive dopo due settimane si mantiene alla stessa maniera, o le
M si negativizzano si eseguiranno solo dei controlli successivi perch le IgM potrebbero essere
interferenziate, cio non altamente specifiche per il citomegalovirus.
HERPES VIRUS
Linfezione intrauterina dellherpes un evento abbastanza raro, generalmente il responsabile lherpes di
tipo 2, quindi lherpes genitale che solitamente non risale il canale del parto ma rimane localizzato nelle
vesciche. Possono determinare delle infezioni primarie ricorrenti, possiamo avere delle riattivazioni, la
madre pu anche non accorgersi di avere un infezione vaginale.
Linfezione herpetica molto diffusa, o almeno linfezione herpetica neonatale abbastanza diffusa
specialmente in America, in Europa un po pi bassa la frequenza (Italia 3 casi su 10.000) una frequenza
che lascia molto a desiderare perch molte non vengono denunciate.
Le infezioni congenite, quando accertata, la sintomatologia generalmente si manifesta circa dopo 70
giorni dalla nascita con una manifestazione clinica che corrisponde allinfezione nelladulto quindi con
vescicole cutanee con lesioni vescicolari, microcefalia, idrocefalo. Tenendo conto che lherpes un virus
che d latenza a livello del sistema nervoso come fa il virus ad arrivare a livello dellembrione e ad
instaurare uninfezione intrauterina? Abbiamo detto che levento intrauterino piuttosto raro perch
quando il virus localizzato a livello cervico-vaginale difficilmente il virus risale, viene liberato dalle
vesciche e per forza di gravit v verso il basso, nulla vieta che certi virioni risalgano e arrivare al prodotto
del concepimento. Generalmente questo tipo di infezione si ha solo in prima infezione quando la madre si
infetta per la prima volta, quando c la viremia, nelle riattivazioni molto difficile avere una viremia
perch il virus si sposta da cellula a cellula, in prima infezione invece il virus d la viremia e si sposta
attraverso il sangue quindi pu dare infezioni intrauterine, ma generalmente le infezioni erpetiche
riconoscibili nel neonato sono quelle contratte nella fase di attraversamento del canale del parto, quando il
virus presente a livello vaginale, ci sono le vesciche, abbiamo la replicazione del virus in atto, questo viene
definito herpes neonatale. I sintomi si manifesteranno tardivamente e consistono in lesioni cutanee
vescicali abbastanza gravi a livello orale e oculare, encefaliti, interessa il sistema nervoso centrale, i
polmoni, il fegato.
Nel feto, in questo caso il bambino, questo durante lattraversamento del canale del parto entra in contatto
diretto con il virione, non presente nessuna barriera e nessun filtro e il virus entra direttamente
Microbiologia - Medicina e Chirurgia polo A 2012/2013 - sbobinature lezioni
169
attraverso gli orifizi naturali del neonato e arriva direttamente al sistema nervoso del neonato e pu quindi
causare queste infezioni disseminate anche se la madre ha trasmesso gli anticorpi questi non saranno di
protezione perch non avranno il tempo di reagire, perch il virus arriva nellorgano si replica e causa il
danno.
La diagnosi viene fatta in questo caso facendo alla madre lisolamento del virus in colture cellulari, andiamo
a prendere il liquido presente nelle vescichette e se lherpes presente ricondurremo le vescicole
allinfezione herpetica. anche possibile effettuare una diagnosi sierologica andando a ricercare gli
anticorpi. Al neonato sar possibile fare un esame sia tenendo conto della sintomatologia che del rischio
nel contrarre linfezione, nellarco dei 20 giorni necessari per la comparsa dei sintomi se il neonato a
rischio andare a fare tampone del cavo orale, congiuntivale, delle lesioni (se queste si manifestano) e
andare a ricercare lherpes per associare leffetto alla causa, per accelerare ulteriormente pu essere
effettuato un prelievo ematico con ricerca mediante PCR del dna virale sia nel sangue che nel liquor, in
questo caso andiamo a valutare la presenza del virus a livello encefalico e se ha superato la barriera
ematoencefalica.
Una volta fatta la diagnosi si attua la terapia, nel caso della madre se siamo in presenza di infezione
primaria se questo non in gravidanza possiamo fare al terapia con aciclovir, fanciclovir e ganciclovir,
valutando se siamo in corso di gravidanza questo perch questi sono farmaci tossici e anche teratogeni,
quindi valutare il mese di gravidanza e cercare di fare una terapia solo per uso locale e non per via sistemica
se questo possibile.
Nelle infezioni ricorrenti se le lesioni sono in atto e siamo lontani dalla gravidanza la terapia di tipo orale
con aciclovir e con pomate localizzate. Anche in questo caso invece se il soggetto in gravidanza lA terapia
deve essere rigorosamente locale, niente deve essere somministrato per via sistemica. In caso di
riattivazione di uninfezione genitale nellimmediatezza del parto sarebbe preferibile il parto cesareo a
scopo terapeutico, parto cesareo elettivo a membrane integre per se queste non sono pi integre
sempre bene cercare di far partorire il soggetto sempre con parto cesareo entro le 4 ore dalla rottura
perch il virus pu diffondere ugualmente fino al feto, in ogni caso il parto cesareo non ci da una copertura
totale, quindi onde evitare rischi deve essere aggiunta una terapia antivirale dopo la nascita.
Sempre rimanendo nella famiglia degli herpes virus parliamo dellherpes zoster e quindi di varicella. La
varicella uninfezione molto diffusa infatti solo il 10% delle donne circa sieronegativa. La manifestazione
della varicella nelle gravida veramente molto bassa in quanto difficilissimo che una gravida possa
contrarre la varicella perch lavr gi contratta molto prima di entrare in gravidanza. La varicella se
contratta in gravidanza, e precisamente se contratta entro la XX-XV settimana generalmente non in grado
in questo periodo di attraversare la placenta, pertanto linfezione localizzata solo a livello materno senza
trasmissione al feto che non corre grossi rischi. stata anche descritta la varicella congenita che si instaura
quando invece il virus attraversa la placenta, questa comporta ipoplasia, lesioni cutanee, malformazioni
muscolo scheletriche, lesioni nervose, lesioni oculari con cataratta, corioretinite, sono delle evenienze
abbastanza gravi.
Se invece il virus viene contratto dalla madre in un periodo tardivo della gravidanza la varicella molto pi
virulenta, non si riesce a spiegare il perch, pu attraversare la placenta dare un infezione fetale
conclamata, questo decorso dipende molto dalla capacit che ha la madre di trasferire gli anticorpi al feto.
Dal momento in cui insorge lesantema vescicoloso tipico della varicella, che non un tipico esantema ma
piuttosto sono delle vescicole con del liquido allinterno, non un esantema riconducibile dal punto di vista
clinico e obiettivo al morbillo o alla rosolia, lo si distingue chiaramente, tranne allinizio.
La sintomatologia materna pu insorgere 6 giorni o meno prima del parto, il neonato nascer con una
varicella disseminata molto grave e spesso pu essere anche letale. Se la sintomatologia insorge 7 giorni
prima del parto il decorso abbastanza benigno, si avr un feto/neonato che non presenta uninfezione o
Microbiologia - Medicina e Chirurgia polo A 2012/2013 - sbobinature lezioni
170
quanto meno la presenta in forma silente nonostante abbia contratto linfezione, la manifestazione
simile a quella delladulto, ecco la differenza che c nel valutare esattamente i segni clinici a
disposizione, qui la differenza di 24-48 ore questo perch una questione immunologica, fino a sette
giorni prima ci troviamo in una fase in cui il virus passa ma dopo qualche ora passano anche gli anticorpi
della madre, il virus infetta ma viene bloccato dalle IgG materne; sei giorni prima o meno questo non
succede pi, il virus passa, gli anticorpi che passano sono in concentrazione molto bassa, subito dopo il feto
nasce con una concentrazione anticorpale trasmessa dalla madre molto bassa, se il virus arrivato a livello
sierologico pu avere anche esito letale. molto importante in questo caso la diagnosi, la prima cosa da
tener sempre presente durante la diagnosi alla madre la ricerca dellantigene virale mediante
immunofluorescenza nelle eventuali vescicole, se queste si sono manifestate, inutile fare un esame
culturale che impiega diverso tempo perch il virus deve avere il tempo di crescere in coltura, in questo
caso importante sapere velocemente se c presenza di virioni o di prodotti del virus allinterno delle
vesciche, quindi abbiamo una risposta immediata.
Mediante la sierologia si andr a valutare solo la risposta anticorpale, valutando quindi la presenza di IgG e
Igm e eventualmente valutare anche lincremento delle IgG.
Per quanto riguarda la diagnosi prenatale, dato che i rischi sono abbastanza gravi si ci indirizza nella prima
fase verso metodi di diagnosi invasivi, per invasivi intendiamo il prelievo di sangue fetale, il prelievo di
liquido amniotico controllando se c presenza di IgM fetali e dellantigene virale, questo per ci permette
di dire che si, avvenuto il passaggio del virus a livello fetale, ma non possiamo quantizzare lentit del
danno. Seconda fase ecografia di secondo livello andando a vedere se ci troviamo in presenza di idrocefalo,
di microcefalia, se c ipoplasia, calcificazioni. Terza fase risonanza, in questo modo abbiamo al conferma
insieme al quadro clinico e ecografico di linfoadenomegalia, atrofia della corteccia cerebrale.
La prevenzione si attua attraverso limmunizzazione con vaccino vivo ma attenuato che diminuisce e
protegge da eventuali riattivazioni e come tutti i vaccini evitare di entrare in gravidanza per almeno 3-6
mesi dalla data della vaccinazione e controllare se il vaccino attecchito.
La terapia prevede luso per la madre solo se in presenza dellinfezione con grave complicazioni, per
esempio se abbiamo il virus a livello del SNC o se sono presenti gravi polmoniti, quindi la madre gi
compromessa sia attua una terapia antivirale con aciclovir. In donne immunocompetenti possibilmente con
lieve sintomatologia non si attua nessun tipo di terapia, si fa decorrere linfezione naturalmente. In caso di
donna esposta a rischio si inoculano gammaglobuline proteggendo sia la madre che il feto. Per il neonato
alla nascita si prosegue con gammaglobuline specifiche se siamo in presenza di infezione da varicella alla
madre in prossimit del parto, in questo modo si pu riuscire a controllare la varicella congenita.
Lezione 14
Cos un toxoplasma e un proto ? vir? E quali potrebbero essere i problemi legati a una sua infezione in
corso di gravidanza. Questo, spero che dal punto di vista biologico lo sappiate, un protozoo di quitale? Si
pu localizzare in qualsiasi organo o apparato, colpisce sia gli animali che luomo, nella maggior parte dei
casi linfezione quasi sempre asintomatica. La sua importanza riguarda le infezioni in corso di gravidanza,
quindi le infezioni congenite,
le infezioni oculari nelladulto e le superinfezioni in pazienti
immunocompromessi. Il suo ciclo rappresentato da due fasi: la fase sessuata e la fase asessuata. Lospite,
il serbatoio di questo protozoo il gatto. Saltiamo tutte le fasi orzoite o zigote o cisti eccetera, lunica
fase su cui mi soffermo la fase dellovocista che viene liberato dalle feci del gatto quindi nel terreno e
quindi la sua sporulazione?, che avviene nel terreno, e quindi linfezione o la trasmissione alla maggior
parte degli animali erbivori, alluomo con le verdure e cos via. Il tartizoite quella forma vegetativa, quella
libera, quella che viene rappresentata da (di) questi organismi a forma di semiluna, responsabile delle
Microbiologia - Medicina e Chirurgia polo A 2012/2013 - sbobinature lezioni
171
infezioni acute. Le cistodoite? Invece la forma in cui la ritroviamo allinterno degli organi, allinterno della
cellula. Questa responsabile delle infezioni croniche, delle infezioni latenti. Lo spolozoite invece la sua
forma pi resistente, la forma con cui lo troviamo non visto nellambiente esterno; trofozoiti abbiamo
detto la forma a semiluna, sono i pi labili fra i tre sono i pi labili sono inattivati facilmente al calore, basta
50 gradi, il succo gastrico, possono resistere a 4 gradi per 25 giorni e sono quelli che sostengono le infezioni
connatali cio la forma trofozoite quella che attraversa e che attacca la placenta. Si possono riscontrare
anche allinterno degli organi quindi sono responsabili delle infezioni da trapianto e sono anche responsabili
delle infezioni da laboratorio con la loro manipolazione. Unaltra, il cistozoita, leggermente pi resistente,
non molto; si trova nelle carni, resistente un po alla digestione peptica, non resistente per alle
corrette pratiche della cottura, quindi la forma cistozoita quella che riscontriamo allinterno delle cellule,
allinterno del tessuto, responsabile delle infezioni da carne cruda, da carne poco cotta; responsabile
delle infezioni professionali, quindi addetti ai macelli, allevatori; teniamone conto pi in avanti. Lovocisti
invece la forma pi resistente, pu rimanere nel terreno per circa pi di un anno; resistente all acido,
agli enzimi, come vedete le cisti, le ovocisti sono responsabili delle infezioni degli animali e anche delle
infezioni delluomo, quando luomo vegetariano o quanto meno mangia le verdure poco cotte, mal
lavate, pu contrarre un infezione da ovocisti di toxoplasma e spesso sono queste un elenco di tutte le
correlazioni tra patologia e forma vitale del toxoplasma e questo il ciclo che ci interessa un po tenere
conto. Quindi il ciclo del toxoplasma si svolge nellintestino e nellapparato digerente del gatto il quale
pensa a diffondere molto velocemente sia nella lettiera a casa sia allaperto. Poi altri animali possono
aiutarlo a diffonderlo ulteriormente come il topo, gli uccelli. A questo punto lovocisti pu entrare in
contatto con luomo o direttamente la donna in gravidanza che accudisce un gatto, o che ha un gatto, o
attraverso lalimentazione, le verdure poco lavate, verdure crude poco lavate, oppure in forma indiretta,
mangiando le carni degli erbivori, quindi trasfusioni eccetera il contagio pu attraversare direttamente il
tozzo? Pu attaccare e in alcuni casi anche la distrugge la placenta non solo la attraversa pu solo
attraversarla ma addirittura attaccarla direttamente. Le percentuali di trasmissione nella donna: quando la
donna sieronegativa quindi non presenta anticorpi nei confronti di toxoplasma, il rischio di una
trasmissione nel primo trimestre quasi del 25%, pu manifestarsi con laborto, malformazioni congenite;
nel secondo trimestre aumenta e abbiamo la morte intrauterina, possiamo avere morti intrauterine quindi
gravidanza completata embrione morto, oppure le cosiddette forme connatali gravi; terzo trimestre di
gravidanza la percentuale di trasmissione aumenta, per il bimbo pu nascere sano o quantomeno
apparentemente sano, con degli esiti, con delle manifestazioni che si possono presentare pi in l nella
crescita del bambino. Quindi vedete che il rischio maggiore generalmente tra la tredicesima e la
ventiquattresima settimana di gravidanza e ancora la trasmissione molto alta. Teniamo presente anche
che il toxoplasma responsabile, pu essere responsabile di aborti ripetuti entro le prime settimane di
gravidanza; solo in casi limitati e particolari cio ( ci arriviamo? Quali possono essere questi casi limitati e
particolari? dove la donna pu entrare in gravidanza anzi entra in gravidanza e dopo qualche settimana pu
andare incontro ad aborto non per problemi fisiologici, quindi bisogna escludere tutti i problemi fisiologici e
andare a cercare eventuale presenza di toxoplasma, solo quando le cisti di toxo hanno infettato lutero
quindi quando il toxoplasma presente a livello uterino quindi non c pi il tempo, il toxoplasma gi
localizzato a livello uterino e quando la donna entra in gravidanza attacca direttamente lembrione e lo
stacca, aborti ripetuti entro poche settimane di gravidanza. Se accertata un infezione, anche in corso di
gravidanza, questo lunico di tutti gli agenti tork che pu essere trattato con una chemioterapia mirata e
pu essere trattato durante la gravidanza. Come avete visto laltra volta qualsiasi altro tipo di infezione,
specialmente virale, non pu essere trattata durante la gravidanza con farmaci e ? il farmaco d elezione
la spiramicina; questo farmaco attacca i folati di conseguenza, durante il corso della gravidanza, e in corso
di terapia con spiramicina o mida?che vedremo pi avanti, controllare piastrine e acido folico che bisogno
Microbiologia - Medicina e Chirurgia polo A 2012/2013 - sbobinature lezioni
172
alla donna durante la gravidanza. E lunica infezione che pu essere trattata in corso di gravidanza. Ci sono
4 forme di fetopatia toxoplasmica e sono le forme asintomatiche, dove possiamo avere un parto
pretermine con il ritardo della crescita intrauterina, le forme cosiddette diffuse, dove linfezione
disseminata e ha attaccato la maggior parte dei visceri,quindi aborto o parto pretermine con feto morto,
oppure le forme localizzate, a livello neuroculare con la famosa tetrade di Sabio?, idrocefalo, polioretinite ,
convulsioni e calcificazioni endocraniche; e infine le forme tardive, quelle che si manifesteranno, in alcuni
casi, anche anni dopo la nascita, generalmente riguardano la corioretinite e la sordit. Le maggiori
fetopatie, come dicevo, encefalomielite, la tetrade di sabin?, e la cosiddetta toxoplasmosi generalizzata,
con ittero, epatosplenomegalia, disordini ematologici, perdita delludito, deficit visivi, e ritardo mentale. Il
bambino , il feto, questa la classica tetrade di sabin, questa una corio retinite. Abbiamo visto le
patologie, abbiamo visto quello che pu dare, come lo possiamo diagnosticare: lisolamento troppo
indaginoso e abbastanza lungo, quindi per quello che ci da poi la certezza; la sierologia, la diagnosi
sierologica, quella che si fa nellimmediatezza; la diagnosi viene effettuata su un doppio prelievo, quindi
andare a valutare la siero conversione oppure linnalzamento del titolo anticorpale delle igg specifiche di
almeno quattro volte il titolo tale da poter essere significativo questa variazione oppure come dicevo la
siero conversione, primo prelievo negativo, secondo prelievo positivo. Come avete visto pocanzi , primo
trimestre, secondo trimestre, terzo trimestre, molto importante andare a valutare e a individuare
precocemente leventuale infezione; come ? andando a monitorare le donne in gravidanza, con un prelievo
prima, possibilmente o nellimmediatezza della gravidanza, e un prelievo poi successivamente. Se il primo
prelievo risultato negativo, monitorarla per tutta la gravidanza, ogni mese; se il primo prelievo invece
dovesse risultare positivo con presenza di igm, quindi un infezione acuta in atto nella prima fase della
gravidanza, iniziare immediatamente la terapia e poi andare a valutare linfezione. Ma gi al primo sospetto
di infezione, iniziare immediatamente la terapia. Cosa possiamo fare per la prevenzione? abbastanza
deducibile: evitare il contatto con i gatti, dato che sono loro che portano, apriamo una parentesi, i gatti
domestici se li controllate abbastanza bene, non dovrebbero avere problemi di toxoplasmosi, per se il
gatto di quelli abituati a scappare di casa allora meglio monitorarlo; un accurato lavaggio delle verdure,
foglia per foglia con disinfettante se dovete consumarla cruda, se cotta, lavaggio normale; cercare di evitare
di mangiare carni poco cotte o crude, ma le carni, da qualsiasi animale esse provengano, devono essere ben
cotte. Abbiamo visto la terapia: in un primo sospetto di infezione da toxoplasma, spiramicina e nel
frattempo si monitorizza il soggetto se effettivamente ha avuto un infezione da parte del toxo, che rischi
pu correre, quale probabilit ha che questa infezione sia passata al feto; una volta accertata, si aggiunge
alla spiramicina la filmetamina? e i sulfamidici nel secondo e terzo trimestre di gravidanza. Concluso gli
agenti tork.
Una famiglia virale: il papilloma virus
Quando affronteremo lo studio di una famiglia virale, faremo cosi: la famiglia papilloma virus, quanti generi
comprende, diffuso o meno in natura, che caratteristiche presenta, resistente, non resistente,
diffusibile a tutti gli animali, mammiferi, uomo, o solo animali, di tipo specie specifico e quali sono i generi
strettamente legati alluomo. In questo caso rappresentato la.,
molto resistente allessiccamento, infetta varie specie di animali; suddiviso in due: generi che
interessano luomo,gli alfa e i beta papilloma virus,a loro volta gli alfa sono suddivisi in diversi sierotipi
siglati da vari numeri fra i quali non dico fra quelli pi studiati ma pi importanti per la patologia delluomo
sono: 6, 16, 18, 53, 26, con un basso rischio ma 6, 16, 18 sono i cosiddetti papilloma virus ad alto rischio,
responsabili delle lesioni mucosali, responsabili delle evoluzione di una lesione in carcinoma, fra gli altri qua
abbiamo i beta herpes papilloma virus, anche queste sono generalmente infezioni cutanee, responsabili di
infezioni cutanee, ed alcuni di questi anche maligni. Hanno un trofismo quasi esclusivo per gli epiteli
Microbiologia - Medicina e Chirurgia polo A 2012/2013 - sbobinature lezioni
173
squamosi e gli epiteli pluristratificati, determinano delle lesioni molto ploriferative, quali sono gli
., i papillomi, i condilomi e interessano generalmente sia la cute che le mucose;
quindi ogni parte del nostro organismo pu essere infettata da un papilloma, sia cute che mucose, mucose
e come vedete, belle ...........................
Come formato il virus? Il virus un virus nudo, con un capside icosaedrico non molto
grande, il genoma costituito da un filamento di DNA a doppia elica; conosciamo pi di 150 genotipi che ,
abbiamo detto, sono classificati in sedici gruppi, di cui 35 solo genitali; come organizzata la sua struttura?
Il papilloma si mette a livello nucleare, teniamo conto che abbiamo detto che un DNA virus, e dunque la
sua ?replicazione? sempre nucleare. Per prima cosa si ha una trasmissione dei geni precoci e
successivamente di quelli tardivi. La trascrizione di questi geni anche la responsabile della sua variazione
tra un infezione di tipo persistente in un infezione di tipo citotrasformante e questo lo vedremo dopo con il
singolo gene. Il suo genoma organizzato secondo questo schema: Le 1 responsabile della
?rieducazione? del virus, Le 2, Le 3, Le 4 e Le 5 sono responsabili della trascrizione e della ?rieducazione?
del virus. Poi abbiamo due geni un po particolari , che sono Le 6 e Le 7 che sono dei geni che sintetizzano le
proteine E6 e E7 che sono le cosiddette proteine oncogene del virus,E6 specifica per la P53 cellulare, E7
specifica per la proteina 105 del retino blastoma cellulare; poi abbiamo i geni per capside, quindi geni che
sintetizzano lL1 e lL2, e in questa maniera abbiamo formato tutto i .Teniamo conto di queste
due proteine lE6 e lE7 che sono quelle responsabili della ?immortalizzazione? della cellula e della crescita
sproporzionata della cellula. Uninfezione da HPV abbiamo detto si pu per fortuna nella maggior parte dei
casi si svolge come ciclo liquido cio lE 2 quella proteina che riesce a mantenere stabili e a nascondere
lespressione dellE6 e dellE7, quindi mantiene il DNA virale in forma circolare, e permette il legame in
forma episonale con lacido nucleico cellulare. Quindi in questa maniera abbiamo la replicazione del virus,
la crescita del virus, la formazione della verruca, la liberazione dei nuovi viromi?. Ma se questa proteina E2
viene bloccata, viene disattivata, vengono fuori, espresse le due proteine E6 ed E7. Queste due
proteine permettono lintegrazione dellacido nucleico virale a livello del genoma cellulare, in questa
maniera abbiamo la citotrasformazione con il suo stadio integrale. Sempre lorganizzazione delle proteine e
dei geni; A cosa servono queste proteine? Abbiamo parlato della T 53 della cellula che in corso di una
normale divisione cellulare possono in alcuni casi cedere dei danni a livello del DNA, nella depicazione del
DNA della cellula. Nel corso di una duplicazione normale la cellula se ne accorge e corre ai ripari: laccumulo
di T 53 nella cellula, in corso di DNA danneggiato, fa si che la sintesi, la mitosi, viene bloccata nella fase
?gi? in questa maniera la cellula pu provvedere a riparare questo DNA e una volta riparato pu
procedere alla sua divisione senza avere nessun tipo di mutazione. E una forma di autocontrollo della
cellula in presenza di danni al DNA e in presenza di eventuale mutazione. Quando invece ci troviamo in
presenza di una cellula infettata con un papilloma integrato, non in fase ma integrato nellacido
nucleico cellulare, il gene 6 che sintetizza la proteina E6 non fa altro che attaccare la T53, distruggerla,
disintegrarla, quindi in corso di divisione, gli eventuali danni al DNA verranno trasferiti alla progenie figli
quindi si avr un accumulo di mutazione, alla fine noi avremo fra le cellule cosiddette normali, anche delle
cellule modificate che faranno parte della popolazione e che successivamente forse nelle successive
divisioni, prenderanno il sopravvento sulle cellule normali. Come agisce il gene T53, la proteina T53 si lega
al DNA e crea, e blocca la sua replicazione. In corso di presenza dellE6, la T53 viene degradata, grazie anche
allubiquitina?, il DNA libero, non pi bloccato, e quindi continua la sua replicazione, con tutte le
modificazioni che ha, con tutte le mutazioni che sta portando, con gli eventuali danni che ci sono a livello
della sequenza delle basi. La stessa cosa, come scopo finale la stessa, ma come principio il gene dellRB,
del retino blastoma, non fa altro che, in presenza del fattore di elongazione, defosforillare la proteina del
retinoblastoma e quindi nella sua forma monofosforilare e legata al fattore di elongazione? proteica blocca
Microbiologia - Medicina e Chirurgia polo A 2012/2013 - sbobinature lezioni
174
la replicazione nella fase G0 G1, e quindi si addesta? la duplicazione cellulare; in questa maniera si possono
correggere eventuali danni e modificazioni e poi riprendere; in presenza dellE7 questa proteina oncogena
va a legarsi alla proteina libera e attiva del retino blastoma, la T105, la blocca e la neutralizza nel senso che
non la fa pi legare al fattore di elongazione e assieme non si possono pi legare al DNA. Quindi la
replicazione procede, va, arriva in fase S,e di conseguenza le modificazioni, le mutazioni si accumulano
durante la replicazione. E sono i due geni particolari che producono due proteine particolari. Quindi lHPV
responsabile di uninfezione produttiva, quando si ha la moltiplicazione, la crescita del virus, e quindi la
manifestazione patologica, la manifestazione clinica, tra verruche, condiloma ecc., oppure si pu
trasformare anche in un infezione persistente, di natura citotrasformante. E questo pu dipendere dalla
fase di differenziazione della cellula stessa. Come avviene uninfezione da papilloma: CUTE, il virus infetta e
pu infettare solo lo strato basale, solo le cellule dello strato basale presentano i recettori per il virus; ma
come ci arrivano: attraverso una soluzione di continuit arriva allo strato basale, infetta lo strato basale e
poi a livello dello strato basale comincia la prima espressione dei geni virali L1 e L2 e successivamente man
mano che lo strato basale si differenzia, quindi le cellule dello strato basale si differenziano e diventa strato
spinoso, porter con se il virus, il quale comincer ad esprimere anche gli altri geni E4 ,E5; successivamente
i geni per lL1 e lL2 e poi una volta che arrivato, la cellula, differenziandosi ulteriormente, porta il virus ad
uno stadio pi elevato quindi allo strato granuloso, il virione? gi maturo, si gi assemblato, e pu
fuoruscire attraverso lo strato corneo, con leliminazione dei cheratinociti e quindi diffondersi
ulteriormente. Solo le cellule dello strato basale presentano i recettori per il virus, possiamo evidenziare
ogni fase, monitorare dove si va a trovare il virus, in quale fase siamo; man mano che il virus cresce, si
differenzia nelle cellule gi differenziate, oltre a cambiare morfologia alla cellula, (la cellula per esempio
dello strato spinoso infettata, diversa, cambia di morfologia, si allarga, si ingrandisce, se posta su un
vetrino e colorata, assume una colorazione violacea, quindi noi possiamo gi vedere, in che fase siamo
dellinfezione; quando noi andiamo a trovare unabbondante coilocitosi, quindi le cellule dello strato
spinoso modificate, i coilociti, gi vuol dire che siamo in terza fase, uno stadio avanzato dellinfezione, se ci
sono molte cellule, molti coilociti, gi siamo in una fase abbastanza avanzata dellinfezione. Questo ci serve
anche come mezzo per diagnosticare linfezione; dove avviene la ?depicazione? successivamente
lespressione completa del virus quindi lespressione genica completa, con i virus maturi, avviene a livello
dello strato granuloso e quindi poi abbiamo la liberazione attraverso lo strato corneo dei virioni maturi e la
diffusione; ecco come si esplica un infezione dal punto di vista clinico, la presenza del virus a livello dello
strato basale, una moltiplicazione eccessiva dello strato spinoso, strato granulare, strato corneo, fuoriuscita
del virus. Ogni sua fase di depicazione corrisponde anche una fase visiva, diciamo abbastanza visibile dal
punto di vista clinico, possiamo evidenziare in quale fase siamo. La differenza tra infezione normale, tra
virgolette infezione normale, infezione benigna, che abbiamo la completa depicazione del virus, delle
infezioni benigne, una modestissima, quasi nulla, espressione dei geni E6 e E7, questa regressione, questa
repressione dovuta alla secrezione , produzione delle proteine tardive, che riescono a bloccare la propria
espressione e sempre il genoma si mantiene in forma episomale, non mai integrato nel genoma cellulare.
Queste . ipercheratosi e il mantenimento. Quali manifestazioni cliniche d quando
. Epitelio squamoso della cute le verruche, nelle membrane mucosali i papillomi, che
possono essere genitali, orali o congiuntivali, e generalmente inducono sempre una proliferazione
epiteliale. Sono delle infezioni e i sintomi singoli sierotipi dellHPV sono tessuto specifici, la verruca il
risultato dellispessimento dei vari strati dal basale allo spinoso al granuloso. I coilociti e lespressione di
questi cheratinociti ingranditi, visibili e facilmente diagnosticabili, nel giro di 3-4 mesi si possono
manifestare; linfezione quasi sempre localizzata, a meno che non ce la spostiamo; pu regredire anche
spontaneamente, ma teniamo presente che pu essere di tipo ricorrente, quindi scompare una verruca, e
dopo qualche tempo ne ricomparir unaltra, questo perch il virus sar sempre presente nello strato
Microbiologia - Medicina e Chirurgia polo A 2012/2013 - sbobinature lezioni
175
basale, quiescente ma sar sempre presente, saranno le nostre difese a mantenerlo quiescente per
sempre presente. I vari tipi di verruche: abbiamo quelle a trasmissione sessuale, i condilomi acuminati, le
verruche genitali, le verruche lisce, verruche piane, le verruche anali, la papulosi di B , come
vedete anche dal punto di vista clinico sono facilmente diagnosticabili; le verruche non genitali, quindi non
a trasmissione sessuale, le verruche comuni, mani, dita, ginocchio, le verruche nella pianta dei piedi, le
verruche delle mani, il papilloma alla lingua, un papilloma congiuntivale, anche questi sono, dal punto di
vista clinico, facilmente diagnosticabili. Abbiamo detto che alcuni sierotipi sono ad alto rischio, alcuni a
basso rischio, questo perch in quasi tutti i carcinomi del collo dellutero sono stati .
lacido nucleico quindi il DNA del sierotipi 16 e 18; la sua presenza quindi gi ci d una percentuale di
citotrasformazione, e lo abbiamo ritrovato non in forma episomale, ma stato sempre . In
forma integrata; ecco perch lassociazione tra sierotipi a basso rischio e ad alto rischio; la frequenza di
riscontro a livello delle lesioni, quando si ha lintegrazione, vengono generalmente disattivati i geni 1 e 2
quindi bloccano la loro replicazione . Quando integrato non ha bisogno di replicarsi,
quando integrato, fuso con lacido nucleico cellulare, non ha bisogno di replicarsi, non ha bisogno di
diffondersi, sar poi la cellula a diffonderlo ulteriormente e quindi andr a bloccare i geni della replicazione,
e a sovraesprimere i geni E6 ed E7, gli oncogni. Quali sono i meccanismi che stimolano ulteriormente
questa trasformazione o che possono stimolare questa trasformazione: sono dei meccanismi molto diffusi,
molto frequenti, presenti, luce solare e radiazione, mutazione genetica; Fattori ..
immunologici quali immunodepressione, fattori chimici, fisici, quali fumo di sigarette, uso di contraccettivi,
e in pi le cosiddette superinfezioni, o le coinfezioni, con altri agenti che hanno anchessi , che possono
avere anchessi una capacit trasformante, come lHIV, lHSV2, la clamide, sono tutti coagenti, agenti
infettanti, che possono favorire la trasformazione di un papoma, di un papilloma cio, da forma plasmidiale
a forma integrata, e quindi stimolare la citotrasformazione. Cosa succede alla cellula: la cellula ha
uneccessiva proliferazione, viene inibita andando a distruggere la T53, andando a bloccare la retino
blastoma, viene inibita la poptosi, cio la morte cellulare programmata, va incontro allevasione delle
risposte immuni. Il virus invece che fa ? causa uninfezione persistente, con replicazione, quindi
unenorme ed eccesiva diffusione di nuovi ?virioni?, unespressione di proteine virali sia tardive che
precoci, stimola delle mutazioni cellulari, generalmente nelle infezioni persistenti, si manifesta unassenza
della risposta cellulomediatica, quindi lospite non risponde a questa modificazione. Un poco di
epidemiologia: questa infezione generalmente insorge fra i 15 e i 30 anni di et, normalmente
.. si risolve normalmente nel giro di un
paio danni, si possono manifestare con delle anomalie microscopiche e quindi facilmente diagnosticabili,
contrasta con il sistema immune dellospite, ed eventualmente la sua persistenza porta a tumore, infezione
di una cervice normale, abbondante coilocitosi, vedete queste cellule pi larghe, ingrossate, di colore blu,
sintomo di uninfezione in atto e progressiva, eventuale persistenza e trasformazione di queste cellule in
lesioni precancerose; schematicamente quando linfezione di tipo residenziale, il virus presente a livello
delle cellule basali in minima quantit, non lo possiamo rilevare, se non
quando si
. E questo non lo sappiamo pu essere a basso o ad alto rischio. Quindi avremo
pochissime cellule della linea basale infettate e una limitata riproduzione da HPT. Il virus presente, per
risvegliarlo tutti quei fattori che abbiamo visto pocanzi, luci ultraviolette, superinfezioni, coinfezioni,
fumo di sigarette ecc. si pu risvegliare e quindi passare da una infezione residenziale ad una infezione
il virus si attivato, localizzato a livello di nucleo della cellula, i due acidi
nucleici sono ben separati, cio significa che lacido nucleico . al massimo legato sotto
forma di . . Anche questo pu essere ad alto o a basso rischio,
possiamo rilevarlo con dei Pap-test, quindi un Pap-test di tipo anomalo, e pu anche essere rilevato
mediante colposcopia, in questa maniera il virus non pi residenziale, ma si diffuso alle cellule contigue,
Microbiologia - Medicina e Chirurgia polo A 2012/2013 - sbobinature lezioni
176
si sta replicando, quindi espressione dei vari geni 4-5-6-7-e cos via fino al completo rilascio delle particelle
mature. Eventualmente, in alcuni casi, per fortuna non molti, abbiamo la forma integrata, il DNA virale da
circolare si apre, si integra con il DNA cellulare, e questo avviene, e in questo caso siamo sicuri, con tutti
ceppi ad alto rischio; anche questo causa dei PAP-Test anomali, e dal punto di vista colposcopio, lo si pu
anche trattare in loco, quindi genoma integrato, proliferazione, abbondante e diffusa coilocitosi, diciamo
che siamo nella cosiddetta caratterizzazione in C3, le forme precancerose, che possono essere gi
immediatamente trattate, devono essere immediatamente trattate. Abbiamo detto che un virus nudo un
virus altamente resistente, non fornito di pericapside e quindi molto resistente. La trasmissione
diretta, di tipo sessuale, oppure contagio attraverso degli oggetti, delle superfici contaminate, la maggiore
diffusione per esempio nelle docce, nelle piscine, nei pavimenti; questo perch facilitata questa
trasmissione perch abbiamo unalta eliminazione del virus in forma asintomatica, non vediamo la
manifestazione non c, non ci accorgiamo di avere una verruca o un inizio di
condiloma, siamo in una fase precoce tra il residenziale e lintegrato e abbiamo leliminazione del virus, noi
non ce ne accorgiamo e abbiamo una facilit nella diffusione. Viene contratto in forma diretta o tramite
piccole lacerazioni perch in ogni caso deve attraversare la cute, per raggiungere appunto la mucosa o le
cellule basali, pu essere trasmesso in modo diretto con rapporti sessuali e per il neonato
nellattraversamento del canale del parto; queste sono varie ?lenti? .
dove
questo 16 e 18 sar sempre evidenziato in neretto e e sempre dei sierotipi che sono
stati quasi sempre riscontrati con una maggiore frequenza a livello dei carcinoma sia essi cutanei sia essi
genitali sia essi delle vie respiratorie; quando si hanno questi inizi di papillomi, di carcinomi
laringobronchiali c sempre 16 e 18 , cavit orale, quando si trasforma da iperplasia o in carcinoma
responsabile il 16 o il 18, in alcuni casi possiamo avere il 6 e l11, teniamoli presente perch saranno quelli
sierotipi, anche se il 6 e l11 sono a basso rischio, nel basso rischio significa no che non si possono
trasformare, che hanno una frequenza minore di trasformazione. Quali sono le lesioni, generalmente le
verruche volgari, le verruche cutanee, le verruche piane, dermodisplasie verruciforme, questo pu
evolvere in tumore maligno a cellule squamose, poi abbiamo i condilomi acuminati, pene, vulva e zona
perianale, viene diffusa, la trasmissione nel 50% della popolazione,si pensa che sia stata infetta; questa
diffusione data anche dal numero della frequenza dei parti, correlata allet, tra i 15 e i 25 anni,
correlata anche allo stato immunitario, evidente che maggiore nei pazienti HIVpositivi, correlata
anche alle abitudini di vita, dicevamo fumo, alimentazione, uso di contraccettivi, per fortuna scende con
lavanzare dellet. Cosa possiamo fare: una vaccinazione preventiva, ma fino ad oggi abbiamo visto che la
protezione .. di tipo specifico e specie specifica, cosa significa questo, riferita verso quel tipo anzi
quel sierotipo, ancora non stata valutata la protezione, la durata della protezione, se un soggetto
vaccinato protetto per una decina danni o pi. Questi vaccini, attualmente anche in commercio ecc., non
dovrebbero essere efficaci se somministrati dopo il contatto; generalmente sono di tipo polivalente e
dovrebbero essere per avere unefficacia dovrebbero essere somministrati allinizio dellattivit sessuale;
sono tutte pratiche abbastanza intuibili, attualmente si stanno anche studiando dei vaccini non pi rivolti
contro il virus ma dei vaccini rivolti contro le proteine, quelle due famose proteine E6 e E7 che sono
responsabili delloncogenicit dell infezione; sono costituiti attualmente dai vaccini
.. , particelle clonate, che vengono ottenute da substrati procarioti, ve li
ricordate i vaccini, abbiamo parlato come viene formato, come viene prodotto un vaccino; quindi non sono
, ma costituito da un gene, il gene probabilmente dellL1 quindi delle proteine del capside, che
viene inserito, quindi lMRNA del gene dellL1 viene inserito, circolarizzato in C DNA inserito in plasmide, il
plasmide inserito in un organismo ioneo a produrre il saccaromices per esempio, il lievito, il saccaromices
esprimer le proteine di questo gene che corrispondono allL1, le proteine capsidiche del papilloma. Queste
proteine hanno la capacit, come dire, di riassemblarsi, il saccaromices produrr le singole proteine, ma
Microbiologia - Medicina e Chirurgia polo A 2012/2013 - sbobinature lezioni
177
queste proteine hanno la capacit di riassemblarsi e formare una sorta di capside che viene definito
particelle ?insulabri? simili al virus. La differenza fra il virus normale e il capside non c, qua un virus
normale quando un capside composto da L1 e L2 e con il DNA al suo interno; questo invece un capside
composto solo da L1. LL1 una delle proteine che capace di stimolare il nostro sistema immunitario e
quindi abbiamo, tra virgolette, un vaccino che non infettante anche se simile ad un virus ma non un
virus ed altamente immunogeno perch costituito dalle proteine L1 del capside del virioma, lL1 dei
singoli sierotipi; questo quello che vi dicevo pocanzi, le singole proteine che si riassemblano a formare
un capside. Questo L1 solo questo MRNA generalmente sono derivati o dal 6 o dall11 o dal 16 o dal 18
quindi sono specifici, non sono dellL1 comune a tutti i papilloma virus, ma sono dellL1 specifici dei
rispettivi sierotipi. Il gene pu essere, oltre ad essere o ad utilizzare un sistema tipo saccaromices quindi
lievito ecc. pu essere anche inserito lo stesso sistema si pu ottenere con delle cellule eucariote quindi
capside in .. in un sistema di cellule eucariote, le proteine sono leggermente pi licosilate
ecc. la stessa maniera come se viene un infezione naturale che vengono direttamente processate
allinterno dellorganismo. In ogni caso i vaccini attualmente in commercio sono di due tipi: uno il
quadrivalente quindi sempre rivolto verso il 16, 18, 6, 11, e uno bivalente, rivolto verso i ceppi pi ad
alto rischio, 16 e 18. Vengono somministrati alle ragazze, a tutte le femmine comprese tra i 9 e i 26 anni,
almeno 3 dosi a brevi intervalli. Vengono somministrati per via sottocutanea e , come vi dicevo,
attualmente conferiscono buona protezione, e sempre tipo specifica e specie specifica; la durata non la
conosciamo perch ancora siamo in corso di studi, perch la vaccinazione iniziata qualche anno fa, quella
obbligatoria, e come vedete, non sono tutti efficaci se sono somministrati dopo il contatto con il virus,
perch gi abbiamo il contatto con il virus di conseguenza la stimolazione anticorpale gi c. Il massimo
che possiamo ottenere da un inoculazione del vaccino successiva al contatto un titolo anticorpale pi
elevato ma non altamente protettivo perch gi ce lo abbiamo. Quindi come abbiamo detto il vaccino
non ha un effetto terapeutico,
non lo possiamo utilizzare come cura ma le lesioni che
potrebbe prevenire sono solo le 16 e 18 perch sono associate a circa il 60-70% dei carcinomi, il 6 e l11
che come vedete ha una potenza maggiore come infezione ma una frequenza minore come trasformazione.
Attualmente una buona vaccinazione previene nel 98% linfezione sempre riferita al 16,18, 6, 11. Tutti gli
altri sierotipi ce li possiamo .. per le slide quando siete pronti venite in istituto con un CD
e ve li masterizzo; saltata tutta la parte della classificazione e del trattamento, va be li farete in
ginecologia e ostetricia.
Lezioni secondo semestre parassiti
Lezione 15 PARASSITI (protozoi)
Sotto il nome di parassiti dobbiamo includere tutti quei microorganismi o organismi animali che entrando
in relazione con luomo ne causano una malattia. Accanto al parassitismo abbiamo definito la condizione di
commensalismo e di mutualismo, ma le condizioni sono effettivamente abbastanza variabili.
I parassiti in senso stretto comprendono 2 gruppi di organismi. Un gruppo di microorganismi, i protozoi,
che sono unicellulari, una volta inclusi nel regno dei protisti. Laltro appartiene al regno animale, in questo
caso ci occuperemo di cestodi, trematodi e nematodi ma dobbiamo includere anche gli artropodi sia per la
Microbiologia - Medicina e Chirurgia polo A 2012/2013 - sbobinature lezioni
178
loro importante funzione di vettore, ovvero veicolo sia per il parassitismo proprio che vanno a esercitare,
ad esempio i pidocchi che sono ectoparassiti, le zecche
Definiamo un microrganismo un parassita obbligato quando costretto per almeno una parte del suo ciclo
vitale a raggiungere un ospite per completare il ciclo. Quindi noi siappiamo che quel microorganismo non
completer il suo ciclo vitale se non raggiunge lospite.
Invece il parassitismo facoltativo la condizione per la quale alcuni organismi o microrganismi quando si
trovano nelle condizioni, per motivi vari, di instaurare una simbiosi caratterizzata da parassitismo, lo fanno
per opportunismo. In questo caso il microrganismo o lorganismo animale ha il suo ciclo vitale e
occasionalmente pu diventare parassita.
I protozoi li definiamo come organismi unicellulari eucariotici, eterotrofi, con dimensioni che vanno dai 2 ai
7 micron. Nel dire eterotrofi richiamiamo una condizione anche propria dei funghi. Dal punto di vista
metabolico come possiamo inquadrare un protozoo? I protozoi prendono energia da sostanze chimiche,
non dalla luce. Nei processi di ossidoriduzione utilizza sostanze organiche. Cosa caratterizza il protozoo
unicellulare eucariotico rispetto a una cellula lievito unicellulare eucariotica? Il fatto che non ha parete
cellulare. I protozoi non hanno parete cellulare, possono avere delle strutture esterne alla membrana
citoplasmatica, ma non parete cellulare. I protozoi possono esistere in 2 forme: quella di trofozoite che
metabolicamente attiva, e quella di cisti che ha funzione di resistenza e riproduzione.
[Immagine]: La struttura della cellula di tipo eucariotico, con tutti gli organuli che sono presenti nella
cellula eucariotica. Se andiamo a vedere alcune acaratteristice, certamente la menmbrana plasmatica ha un
ruolo importantissimo perch deputata allassunzione di sostanze nutritive attraverso alcuni processi, tra
cui processi osmotici, di pinocitosi, fagocitosi e addirittura in alcuni protozoi si assiste ad una sorta di
differenziamento della cellula a forma di apertura da cui il protozoo assume le sostanze nutritive, il
citostoma. Nei protozoi abbiamo processi presenti anche nelle nostre cellule (ad esempio la fagocitosi, la
pinocitosi). Lescrezione dei cataboliti pu avvenire per diffusione attraverso la membrana oppure per
esocitosi oppure in questi protozoi in cui stato differenziato un citostoma c un citopigio dove va a
scaricare il vacuolo digestivo poich la digestione avviene allinterno del vacuolo. Uno strato pi esterno
attorno alla membrana pu costituire il glicocalice che molto ricco di carboidrati ed ha una sua
importanza a guisa di esomatrice o di glicocalice prodotto dai batteri gram negativi. Quindi
fondamentalemnte la membrana citoplasmatica una barriera chimica e meccanica che delimita il corpo,
importante nellinterazione ospite-parassita per il riconoscimento e lancoraggio a particolari strutture e ha
propriet antigeniche nei confronti dellospite.
Quando il protozoo passa da trofozoita a cisti, la cisti che una struttura di resistenza e di diffusione,
possiede una parete. Il citoplasma contiene diversi organuli, molto importante il citoscheletro che in
alcuni protozoi assume dei differenziamenti che porta a formare delle strutture importantissime allinterno
della cellula. I mitocondri nei protozoi aerobi sono simili a quelli dei metazoi, mentre invece gli altri
protozoi hanno un solo lungo mitocondrio che contiene il cinetoplasto. Nei protozoi anaerobi abbiamo
inoltre degli organuli particolari, gli idrogenosomi. Il resto degli organuli sono lisosomi, apparato del Golgi,
reticolo endoplasmatico. Andiamo al nucleo. Il DNA organizzato in cromosomi di numero e forma
variabile. Possono essere presenti pi nuclei. Questo aspetto tipico dei ciliati che posseggono un
macronucleo e un micronucleo. Il macronucleo preposto ad attivit metaboliche mentre il micronucleo
deputato alla funzione di riproduzione sessuale.
Microbiologia - Medicina e Chirurgia polo A 2012/2013 - sbobinature lezioni
179
[Immagine]: Il citostoma un invaginazione circondata da ciglia, la cellula muove le ciglia a creare una
specie di vortice che serve a catturare microparticelle di sostaze organica o batteri che vengono inglobati
attraverso questo processo nel vacuolo che diventa un vacuolo digestivo perch contiene dei lisosomi che
servono alla digestione delle sostanze. Poi Il vacuolo espleter i cataboliti dal citopigio.
Come avviene il movimento nei protozoi? Pu avvenire in diverse maniere, noi distinguiamo i protozoi
flagellati e ciliati per la presenza di queste appendici. I flagellati sono protozoi unicellulari che possiedono
uno o pi flagelli, mentre parlando di ciliati ci riferiamo allunico parassita delluomo ciliato (Balantidium
coli). Di ciliati ne esistono tantissimi in natura ma parassita ce n una sola specie riconosciuta. Altri
protozoi si muovono con un movimento di tipo ameboide emettendo pseudopodi, le amebe. Le amebe non
hanno appendici di movimento, ma il loro movimento assicurato da un sistema citoscheletrico e dalla
capacit che ha il protozoo di determinare una variazione di densit del citoplasma formando un
endoplasma pi fluido. Il movimento ameboide importante perch consente alle amebe di muoversi e
inoltre permette la fagocitosi, caratteristica tipica delle amebe. In alcuni protozoi come nel Trichomonas e
nel Trypanosoma sono presenti le cosidette membrane ondulanti. In questi protozoi un flagello che
fuoriuscito dal blefaroplasto della membrana ritorna dentro la membrana e la solleva formando una cresta,
la membrana ondulante, che serve al protozoo per muoversi. Per il trypanosoma questo vale anche quando
si muove nel nostro circolo sanguigno. Infine gli Sporozoi presentano dei movimenti ondulatori o per
scorrimento.
Il citoscheletro gioca un ruolo importantissimo nel movimento di tutti i protozoi, soprattutto nei protozoi
provvisti di pellicola esterna.
Qual la patogenesi delle forme parassitarie? Ci vuole unesposizione compatibile con la via di ingresso,
ladesione e la replicazione del parassita, il danno cellulare e tissutale e il sovvertimento o comunque
linattivazione delle difese dellospite.
Le vie di ingresso. Una prima via importantissima lingestione, la via alimentare. Molti parassiti arrivano
per questa via. Laltra via la penetrazione diretta, soprattutto con la puntura di atropodi, poi la
penetrazione diretta transplacentare (caso di toxoplasma gondii), e la penetrazione diretta guidata dallo
stesso organismo, cio quegli organismi le cui larve hanno la capacit di penetrare attivamente attraverso
la cute.
Il problema dellesposizione legato al comportamento: se un parassita eliminato con le feci, la
trasmissione di questo parassita sar assicurata se questo materiale andr a contaminare alimenti o se
contamina a causa di scarsa igiene. Possono inoltre influire vari vettori come le mosche che sono
coprofaghe e vanno a localizzarsi sulle feci e si portano dietro parassiti.
molto importante inoltre la dimensione dellinoculo. I fattori associati alla patogenicit del parassita
trovano nella dose infettiva un punto cruciale. Un batterio, una cisti, una molecola di un virus sono capaci
di per s di dare un infezione/malattia? E molto difficile. Per tutti gli organismi sono state studiate sulla
base di modelli animali le dosi infettanti per capire come varia la patogenicit tra i diversi organismi. Laltro
fattore critico oltre allesposizione la dose a cui uno viene esposto. E sufficiente una singola puntura di
una zanzara infetta affinch luomo si ammali di malaria perch quando la zanzara punge inocula molti
sporozoiti direttamente nel sangue.
Vedi tabella parassiti che indica i philum e i nomi italiani dei protozoi parassiti delluomo:
-
Phylum sarcomastigophora: comprende flagellati e amebe.
Microbiologia - Medicina e Chirurgia polo A 2012/2013 - sbobinature lezioni
-
Phylum sporozoa: comprende i coccidi
Phylum microspora: comprende i microsporidi (recentemente trasferiti nel regno dei funghi)
Phylum ciliophora: comprende i ciliati.
180
I flagellati sono rappresentati da diverse specie. Le due specie di parassiti intestinali che potremmo
sottolineare sono la Giardia Lamblia e la Dientamoeba fragilis, gli altri hanno una caratterizzazione
patogenetica molto dubbia: non hanno quelle strutture di virulenza che possono spiegarci unazione
patogena franca. Troveremo una situazione simile per le amebe, ovvero alcune amebe danno unazione
virulenta (le histolytiche), tante altre non sono associate a situazioni cliniche evidenti. In caso di analisi tutti
i parassiti, anche quelli poco virulenti, devono essere comunque segnalati perch questo dato pu essere
utile dal punto di vista clinico.
Amebe:
-
entamoeba hystolitica: vera specie patogena che d amebiasi
blastocystis hominis : associata a certe sindromi intestinali
I coccidi sono in parte legati a situazioni di immunodepressione: pur completando il ciclo biologico
nellospite normale, la sintomatologia espressa dallospite immunodepresso. Il Cryptosporidium parvum
un parassita che ha uno spettro dospite grande cio parassita non solo delluomo ma di tanti altri
animali, per cui in natura circola abbondantemente e pu contaminare le falde acquifere. Le cisti di questi
parassiti resistono alla normale clorazione dellacqua, quindi anche se ci fosse un acquedotto controllato da
quel tipo di trattamento della clorazione, se ci fosse una contaminazione da parte di questi parassiti, noi
potremmo avere una diffusione del parassita. Quando il parassita si diffonde e arriva nelle giuste dosi
allospite normale, possibile che il parassita attui il suo ciclo biologico nellintestito, ma non ce ne
accorgiamo perch i sintomi sono talmente di breve durata che non si ha il tempo di accorgersene. Ma
quando il Cryptosporidium parvum arriva ad esempio in un paziente con HIV o in un paziente
oncoematologico, d diarrea per settimane o addirittura mesi ed di difficile trattamento. Anche per i
protozoi esistono queste situazioni da differenziare: nellospite normale non d segni evidenti, mentre in
quello immunocompromesso la patologia seria.
Per i microsporidi questo viene soprattutto stressato. I microsporidi sono tutti parassiti di animali vertebrati
e invertebrati. Ma anche qui li troveremo come parassiti responsabili di patologie soprattutto negli ospiti
immunocompromessi. E difficile trovare patologie nellospite sano.
Per i ciliati lunica specie il Balantidium coli.
Quindi per quanto riguarda protozoi parassiti intestinali essenzialmente sono queste specie; nei flagellati e
nelle amebe ci sono tante specie ma le specie di cui ci dobbiamo occupare sono essenzialmente poche.
Attenzioniamo Giardia intestinalis. La giardiasi una parassitosi che troviamo soprattutto nellet scolare,
pediatrica, in quanto il contagio avviene per contagio interumano e per ingestione di acqua o cibo
contaminato. Inoltre nel bambino non maturo il sistema immunitario, soprattutto associato allintestino.
Nelladulto difficile trovarlo, ma in qualche paziente che ha problemi intestinali possiamo trovare dei casi,
anche localizzati, ma sono fatti eccezionali che possono risolversi facilmente. Quando facciamo una
diagnosi di giardiasi abbiamo 2 possibilit: o andiamo a utilizzare come campione le feci e allora se le feci
hanno avuto un transito veloce nellintestino sono feci diarroiche ed possibile trovare ancora il trofozoita,
Microbiologia - Medicina e Chirurgia polo A 2012/2013 - sbobinature lezioni
181
ma se le feci non hanno avuto un transito veloce troveremo le cisti. Ma se io faccio un aspirato duodenale
posso trovare il trofozoita, oppure esiste un altro metodo che consiste nel fare ingerire al paziente una
capsula tenuta attraverso un filo fino a farla arrivare al duodeno, si lascia in permanenza per un certo
tempo e si ritira fuori e vedremo che la giardia si attaccata alla capsula. La Giardia ha un disco ventrale
con il quale si attacca allepitelio dellintestino quindi il meccanismo patogenetico dovuto alladesione da
parte della giardia ai microvilli della mucosa. In sezione istologica si visto come il parassitismo porta ad
atrofia dei villi per unazione non solo meccanica ma anche tossica. Quindi la giardia con questo
meccanismo di adesione ai microvilli dellepitelio porta a quella che si chiamava sindrome da
malassorbimento, perch riduce la capacit di assorbimento da parte dellintestino. Il ciclo molto
semplice perch va dal trofozoita alla cisti e la cisti resiste alla normale clorazione e ha una buona vitalit
(per oltre tre mesi vitale in acqua). Il decorso pu essere sia asintomatico che sintomatico. Quando
sintomatico ci pu essere uno stato acuto e uno cronico. Le forme possono essere:
-
intestinali
epatobiliari
forme eccezionali con sintomatologia extradigestiva
Amebe. Focalizzare Entamoeba histolytica (vuole soprattutto questa, la dientamoeba fragilis non gli
interessa). Una volta si parlava di una forma magna e una minuta (oggi sono le due specie entamoeba
histolytica e dispar) perch le cisti erano tutte uguali per alcune venivano da forme piccole di entamoeba
che si vedevano nelle feci dei soggetti con le tecniche di colorazione (es. con ematossilina ferrica), mentre
negli altri sintomatici con diarrea, muco, sangue nelle feci si trovavano le forme grandi che contenevano
dentro globuli rossi. Nel tempo si capito che pur avendo la stessa struttura cistica, sono due specie
diverse. Quindi quando si trovano queste cisti in un esame parassitologico le cisti sono riferibili sia a
entamoeba hystolitica che a entamoeba dispar, linterpretazione viene dopo. Oggi si possono differenziare
le due forme con metodi molecolari o antigenici. Entamoeba histolytica un invasivo patogeno mentre
entamoeba dispar non invasivo non patogeno. Per quanto riguarda Entamoeba histolytica anche qui
abbiamo infezione per ingestione di cisti mediante cibi e acqua e incistamento nel duodeno e installazione
nel cieco della forma attiva, riproduzione e cos via LEntamoeba histolytica non si ferma allintestino. Il
prof ha anche avuto un caso di pericardite e varie segnalazioni di sospetto ameboma epatico. Lentamoeba
histolytica caratterizzata da invasivit, oltre a formare il classico bottone ulceroso a livello della parete del
colon, supera la parete intestinale ed entra in circolo. Il primo organo che colpisce il fegato. Se supera il
fegato va anche al cuore.
Cryptosporidium parvum. La Giardia e la Entamoeba hanno un ciclo biologico molto semplice perch
alternano il trofozoite, che si moltiplica per divisione binaria, e la forma cistica, di resistenaza, che si
trasmette allaltro ospite e linfezione continua. Il Cryptosporidium parvum (coccide) caratterizzato da un
ciclo biologico pi complesso. Nei coccidi assistiamo alla riproduzione sessuale. Nel caso del
cryptosporidium parvum il contagio pu essere interunamo o attraverso acqua, oggetti, alimenti ecc.
contaminati da altri animali che possono ospitarlo. Il cryptosporidium parvum monoxeno: ha un solo
ospite nel quale completa il ciclo biologico (il toxoplasma gondii dixeno, ha bisogno di due ospiti per
completare il ciclo, uno definitivo nel quale avviene la riproduzione sessuale e uno intermedio nel quale il
parassita si moltiplica per riproduzione asessuale). Nel caso di cryptosporidium parvum lintero ciclo vitale
avviene dentro lo stesso ospite. Il paziente ingerisce cisti, nel suo intestino avr luogo la moltiplicazione
asessuale ma anche la riproduzione sessuale e le oocisti formate saranno eliminate con le feci. Nellospite
immunocompetente linfezione in genere si autolimita a pochissimi giorni mentre nel paziente con AIDS si
Microbiologia - Medicina e Chirurgia polo A 2012/2013 - sbobinature lezioni
182
hanno situazioni drammatiche con diarree che durano mesi con perdite di liquidi notevoli e difficolt di
trattamento. Il cryptosporidium un endocellulare esocitoplasmatico. Il cyclospora cayentanensis un
coccide, ha una diffusione un po particolare, stata segnalata soprattutto negli stati uniti molto legata a
problemi di contaminazione della frutta e della verdura. Il ciclo avviene tutto in un solo ospite:
monoxeno.
I microsporidi. Abbiamo 2 localizzazioni importanti: quella cerebrale e quella intestinale. Quella intestinale
data dallenterocitozoma, quella cerebrale dallencefalocitozoma. I microsporidi hanno un ciclo biologico
molto particolare. Perch sono chiamati microsporidi? Perch essenzialmente sono piccoli, hanno
dimensioni di qualche micron, poco pi grandi di un batterio e la struttura una spora che, anche se cos
piccola, mantiene la struttura eucariota. La struttura molto essenziale: nucleo, un po di citoplasma e una
specie di tubo interno. Fondamentalmente un endocellulare e quando la spora riconosce il recettore
cellulare, si lega al recettore cellulare della cellula intestinale ed espelle il tubo lungo il quale scende il
nucleo. Scendendo il nucleo nella cellula, la va ad infettare con conseguente moltiplicazione del parassita,
distruzione della cellula e liberazione di tante spore che vanno ad infettare altre cellule, diffondendosi
rapidamente. E un ciclo endocellulare.
Il Balantilium Coli il ciliato di cui ci occupiamo a livello intestinale. Ha una struttura caratteristica (nucleo,
ciglia, citostoma e la cisti). Ha come ospite il maiale, diffuso tra i suini. La balantiliosi pi che altro stata
vista in operatori che lavorano in allevamenti di maiali. E difficile la trasmissione tra uomo a uomo, mentre
la contaminazione dal maiale alluomo invece stata descritta. Lunica specie patogena dei ciliati il
Balantilium Coli che abbastanza raro.
Parassiti protozoi emotissutali (non intestinali). Possono stare nel sangue e nei tessuti profondi.
Malaria. Fa parte degli sporozoi ed importante perch ha la pi alta mortalit per parassitosi ancora oggi.
(DA STUDIARE MOLTO BENE). Il genere Plasmodium contiene 4 specie (Falciparum, Vivax, Malariae, Ovale).
Da cosa caratterizzato il parassitismo da parte del trofozoite? E caratterizzato dal parassitismo delle
emazie, cellule nelle quali il parassita trova la sua collocazione per moltiplicarsi e il vettore in genere sono le
zanzare del genere anofele. Il ciclo biologico del plasmodium un ciclo biologico caratterizzato da 2 ospiti:
uomo e insetto, perch anche il Plasmodium ha la riproduzione sessuale. Nellinsetto avviene la
riproduzione sessulale. Se linsetto punge luomo nel circolo trovo i gametociti (maschile e femminile).
Nellinsetto avr lavvio di un processo che il processo sporogonico che porta alla formazione degli
sporozoiti, i quali saranno frutto di meiosi e mitosi. Gli sporozoiti prodotti con questo meccanismo di
riproduzione migreranno tutti a livello delle ghiandole salivari dellinsetto. Nellinsetto avviene il processo
riproduttivo sessuale e alla fine di questo processo troveremo nelle ghiandole salivari dellinsetto una bella
quantit di sporozoiti. Quando linsetto ripunger laltro ospite inocula gli sporozoiti, quindi linfezione
comincia con linoculazione degli sporozoiti. Primo stadio dopo linolulo degli sporozoiti lo stadio epatico,
per prima cosa lo sporozoite raggiunge le cellule epatiche e l pu realizzare uno o pi cicli di
moltiplicazione. Nel caso del falciparum un solo ciclo, infatti poi va in circolo velocemente. Invece nel
vivax e nellovale ci sono pi cicli e nel fegato possono restare delle forme latenti che si chiamano ipnozoiti.
Infatti possibile che un soggetto che abbia avuto un episodio di malaria da plasmodium vivax che venga
curato solo per la fase ematica della malattia pu ripresentare a distanza nuovamente una recidiva per
attivazione degli ipnozoiti che si trovano a livello delle cellule epatiche. Quindi imperativo eradicare il
parassita dalle cellule epatiche. Quando il parassita lascia il fegato, va a livello del sangue e realizza il ciclo
che fatto da una fase molto particolare, cio si forma una struttura del tutto particolare nella quale noi
avremo la mitosi senza la divisione del citoplasma, ci troveremo con una forma chiamata schizonte, fatto da
questa grande cellula con i nuclei. Quando la mitosi finita avviene la plasmodieresi, quindi si separa il
Microbiologia - Medicina e Chirurgia polo A 2012/2013 - sbobinature lezioni
183
citoplasma e il globulo rosso scoppia, libera tutte queste cellule chiamate merozoiti che continueranno il
ciclo. La clinica ora un po cambiata. Una volta nel paziente si poteva trovare la classica sintomatologia
che permetteva di distinguere la malaria in terzana, quartana in base al numero di giorni che trascorrevano
tra un picco febbrile e laltro. A cosa duvoto il picco febbrile? La rottura dei globuli rossi e la liberazione
dei merozoiti liberano sostanze tossiche che causano un picco febbrile. Poi ricomincia il ciclo. Il parassitismo
delle emazie si evolve in maniera esponenziale. Come va avanti questo ciclo biologico? A un certo punto in
alcune emazie il merozoita non andr pi a sviluppare lo schizonte, ma dar luogo allo sviluppo dei
gametociti e qui finisce. Quando io prendo del sangue da un paziente e faccio uno striscio posso trovare
varie forme ed anche gametociti. (Vedi Slide). Oggi con test immunocromatografici e molecolari posso
individuare la specie da cui il paziente affetto. Una volta si faceva su base morfologica.
La malaria va studiata molto bene, fare bene ache il controllo della malaria sul libro, inoltre farmaci e
vaccini. Sulla malaria si sono tentate diverse strade sulla vaccinazione, le prime hanno portato a un
insuccesso e successivamente non sempre si avuta grande risposta perch c il problema della variazione
antigenica dei vari ceppi. Quello che sappiamo che alcune popolazioni sono naturalmente resistenti ad
alcune specie perch nei globuli rossi non hanno il recettore che corrisponde a uno dei sottogruppi sul
quale noi caratterizziamo il fenotipo delle emazie. La malaria richiede unattenta valutazione perch pu
diventare cronica.
Leishmania. E un protozoo flagellato, non ha riproduzione sessuale, dixeno. lagente eziologico della
leishmaniosi. Il ciclo vitale si svolge tra il cane e il flebotomo, luomo e il flebotomo. In altri luoghi possono
esserci altri animali implicati. Abbiamo molte specie (slide con elenco), ma in Sicilia presente soprattutto
la Leishmania donovani infantum. Per la parte latino americana si parla di Leishmaniosi muco-cutanea,
perch inizia dalla cute e si diffonde alle mucose (per es. mucosa nasale). Poi abbiamo la forma viscerale e
quella cutanea. Quando si diffonde lAIDS la forma cutanea si pu trasformare in viscerale. In Sicilia
abbiamo il phlebotomus che non la zanzara, punge di notte. Nellinsetto presente la forma di
promastigote, cio si moltiplica nellinsetto il parassita, formando i promastigoti che sono particolari perch
hanno un flagello allestremit anteriore, un nucleo e anche il cinetoplasto. Nel mammifero abbiamo la
forma di amastigote, perch intracellulare (che se ne fa il protozoo del flagello quando dentro la
cellula?). Quindi nel mammifero allinterno dei macrofagi troviamo queste forme di amastigote. Quando
linsetto inocula il parassita dal mammifero, il parassita si trasforma in amastigote per essere fagocitato dai
macrofagi e dentro i macrofagi si moltiplica.
Cinetoplasto In questi flagellati, nellunico grande mitocondrio il DNA mitocondriale talmente tanto da
essere visto come un organulo, il cinetoplasto non legato al flagello. Il cinestoplasto viene chiamato cos
perch lenergia per il movimento gli viene data dai mitocondri, ma essenzialmente DNA mitocondriale.
Limmagine dellistoplasma capsulato dentro i macrofagi pu apparire molto simile al magrofago infarcito di
leishmania. Labilit sta nel verificare se si tratta di leishmanie o di istoplasma. La differenza la fa il
cinetoplasto: con la stessa colorazione nellistoplasma vediamo il nucleo ma non il cinetoplasto, nella
cellula di leishmania amastigote insieme al nucleo si trova anche il cinetoplasto.
La leshmania pu essere viscerale, ovvero si diffonde dal reticolo endoteliale, si trova a livello dei linfonodi
e avremo un imponente epatospleganomegalia.
In Sicilia la leishmaniosi presente, la pi diffusa la leishmaniosi cutanea e c qualche caso di
leishmaniosi viscerale. Il flebotomo tra luomo e il cane tende ad andare verso il cane. Il cane forma delle
Microbiologia - Medicina e Chirurgia polo A 2012/2013 - sbobinature lezioni
184
ulcere e linsetto si nutre del sangue del cane infetto e si infetta. A questo punto linsetto pu trasmettere
la leishmaniosi alluomo.
Trypanosoma. un parassita ematotissutale. Abbiamo 2 gruppi: Brucei (Africana) e Cruzi (Americana). Tutti
e due sono nati in Africa, in questa grande aria continentale prima che lAfrica si separasse dallAmerica,
quindi sono parassiti motlo antichi. Il cruzi si evoluto affermando nel suo ciclo biologico 3 tipi morfologici,
tripomastigote, epimastigote e amastigote. Lamastigote la forma intracellulare, la troveremo nei muscoli
striati, anche nel cuore. Va a localizzarsi nel muscolo per sfuggire al sistema immunitario. Nel tripanosoma
Brucei si affermato un altro meccanismo che quello della variazione antigenica dello strato superficiale,
ha un meccanismo cos sofisticato dal punto di vista della variabilit antigenica della superficie che riesce a
realizzare una serie di moltiplicazione nel sangue sempre sotto la forma di tripomastigote, modificando
lassetto antigenico esterno. La malattia del sonno per esempio se non viene curata pu portare alla morte
del paziente. C una prima fase cutanea e sottocutanea, poi il parassita va in circolo per un periodo che
pu durare mesi caratterizzato da una serie di parassitemia cui il paziente va incontro. A cosa sono legate le
parassitemie? Il parassita si moltiplica nel sangue, il sistema immunitario lo riconosce, risponde, ma nel
momento in cui il sistema immunitario attiva la sua azione il parassita riuscito a cambiare lassetto
antigenico. Quindi si assiste a una rapida diminuzione del parassita nel sangue, quasi una guarigione ma di
fatto il parassita vitale, cominciano a rimoltiplicarsi le sue forme e riparte il ciclo. Lospite risponde e cos
via fino a quando il sitema immunitario va incontro a stress, fino a quando il parassita si localizza a livello
cerebrale, diventando irreversibile, la famosa malattia del sonno che porta a come. Quindi il genere
tripanosoma, con le sue due specie, vanno visti. A trasmettere la parassitosi sono gli insetti vettori. Il
problema il controllo degli insetti vettori, e non sempre possibile.
Toxoplasma gondii. Ha un ciclo completo, quindi con riproduzione sessuale e asessuale, lospite definitivo
non luomo, ma da noi il gatto. In altri territori sono altri felini. Luomo entra nel circuito come un ospite
intermedio. Ci sono anche altri mammiferi che possono fungere da intermedi (come i maiali) delle cui carni
noi ci nutriamo. Il Toxoplasma ha 2 vie di infezione, anzi 3 se consideriamo quella a trasmissione maternofetale. Una pu essere lingestione di ovocisti che sono eliminati con le feci del gatto e che maturano nella
lettiera e diventano infettanti. Tutti i mammiferi che ingeriscono le ovocisti del gatto possono essere
parassitati dal toxoplasma. Qual il ciclo che si svolge nelluomo e in questi mammiferi? Comincia con una
fase intestinale, ma il protozoo dalle cellule intestinali migra nel sangue, c la fase parassitemica e da
questa fase si passa alla fase di incistamento, con la formazione di cisti dentro i muscoli. Quindi andr a
formare bradizoiti, ovvero protozoi a lenti movimenti dentro le cellule muscolari. La paziente a rischio di
trasmissione materno-fetale della toxoplasmosi la paziente non immune, che va incontro alla prima
infezione. Il nostro sistema immunitario produce unimmunit efficace, ci si pu anche non accorgere di
avere avuto la toxoplasmosi che passa in forma simil-infuenzale con i linfonodi un po ingrossati, un po di
malessere ma dopo qualche giorno scompare tutto. Il toxoplasma si pu essere localizzato nei muscoli o
potrebbe essere anche del tutto eliminato. La localizzazione a livello muscolare per i malati di AIDS ha
comportato in alcuni casi una riattvazione con localizzazione del toxoplasma a livello cerebrale
(neurotoxoplasmosi). La localizzazione nei muscoli negli ospiti intermedi ci spiega la via di infezione
delluomo, che non deriva solo dallingestione di oocisti che derivano dal gatto ma anche di cisti presenti
nella carne consumata non ben cotta. Le oocisti si formano nellepitelio intestinale del gatto. Il gatto viene
infettato dalle cisti, magari mangiando la carne di topo infetta, comincia la riproduzione sessuale c un
ciclo e in alcuni giorni vengono eliminate anche milioni di cisti al giorno con le feci (10^6, 10^7). Poi l
quantit di cisti liberate declina. Loocisti matura nellambiente esterno.
Microbiologia - Medicina e Chirurgia polo A 2012/2013 - sbobinature lezioni
185
Lezione 16
Questultima lezione parliamo di un argomento abbastanza complesso (semplificher questo powerpoint e
lo integrer con alcuni aspetti di diagnostica che siete tenuti a fare durante questo corso). Oggi affrontiamo
largomento che riguarda i parassiti che definiamo METAZOI.
Ovviamente sono tutti organismi pluricellulari. Lasciamo quindi il mondo degli unicellulari anche se con i
funghi abbiamo iniziato a vedere una prima organizzazione pluricellulare ma con differenziamenti tissutali
abbastanza scarsi, quasi nulli, molto relativi. Nei metazoi vedremo che anche in animali semplici il
differenziamento tissutale avviene, incominciano ad affermarsi dei tessuti. Dobbiamo riprendere le nozioni
date ieri sul parassitismo e cercare di cogliere qualche altro aspetto. Ieri abbiamo parlato di parassiti
monoxeni, parassiti dixeni o polixeni nel senso che possono esserci pi ospiti anche intermedi. Oggi
vedremo che alcuni parassiti si sono affermati e si sono adattati alluomo ma non perch sono
esclusivamente delluomo ma perch luomo entrato in alcuni habitat, in alcuni ambienti nei quali era
possibile al parassita portare a termine il proprio ciclo vitale. Alcune parassitosi infatti sono confinate ad
alcuni territori, ad alcune aree geografiche del mondo mentre altre si sono ampiamente diffuse nella
popolazione. La parassitologia ha la capacit di cogliere questo sguardo dinsieme e di farci rendere conto
delle diverse condizioni in cui luomo si trovato relativamente a questa possibilit di contrarre malattie
(perch sono malattie e in alcuni casi possono essere anche gravi) che in fondo sono legate non solo
allorganismo ma anche al modo di vivere, al modo di organizzarsi nella societ, nel territorio.
I due grandi phylum a cui ci interessiamo sono i Platyhelminthes e gli Nematoda.
Ci sono degli interi phylum in cui la maggior parte degli organismi sono parassiti ma non sono delluomo ma
anche degli altri animali. Il problema del parassitismo stato un problema di adattamento di vari organismi
i quali ovviamente per poter sopravvivere si sono adattati a questa simbiosi di tipo parassitistica. Il
parassitismo nel corso dellevoluzione questo un fatto importante- seleziona i parassiti meno virulenti e
gli ospiti pi resistenti perch il vantaggio per tutti e due non soccombere. Se il parassita non vuole
soccombere e ha bisogno dellospite, chiaro che alla fine la selezione e levoluzione hanno premiato
questa situazione. Viceversa il parassita eccessivamente virulento che porta a morte lospite rischia anche
la propria estinzione. Studi dimostrano che i parassiti pi datati, pi antichi sono quelli meno virulenti pi
adattati alluomo. Si sono viste anche delle situazioni per cui i parassiti pi datati, pi antichi sono quelli pi
adattati alluomo ma il sistema immunitario e tutta lorganizzazione del sociale che si sono evoluti, sono
cambiati. Per vedete parassita ne scompare qualcuno e ne compare qualcun altro. perch il
parassitismo, soprattutto da metazoi, ci porta poi a considerare un aspetto importantissimo della nostra
vita che quello dellalimentazione e del modo con cui ci alimentiamo. Vedremo che tanti parassiti arrivano
a noi attraverso la via alimentare, dipende dai nostri costumi, dal nostro modo di nutrirci o di preparare i
cibi. Ieri parlavamo della carne poco cotta, oggi vedremo quanti pesci portano con s la possibilit di
parassitosi. Vi consiglio di leggere la parassitologia con la curiosit del medico che pu trovarsi in presenza
di diagnosi non frequenti ma abbastanza importanti.
Certamente per quanto ci riguarda nel corso dovreste avere unidea dellorganizzazione biologica del
parassita.
Per esempio i platyhelminti hanno:
Microbiologia - Medicina e Chirurgia polo A 2012/2013 - sbobinature lezioni
-
forma allungata e piatta
simmetria bilaterale
parete corporea muscolo-cutanea
intestino incompleto
generalmente sono ermafroditi
186
Un dato importante sono le dimensioni dei parassiti.
Andiamo a vedere i platyhelminti, per quanto riguarda luomo ovviamente le sottoclassi dei platyhelminti
sono molte di pi di queste (si riferisce alla slide)- distinguiamo due grandi classi:
-
i Trematodi
i Cestodi
Allinterno dei trematodi e dei cestodi (lasciate stare lordine e la famiglia) abbiamo tutti questi generi
(slide). Non tutti i generi sono per noi presenti qui nel nostro territorio o hanno la stessa importanza. Alcuni
certamente lo sono, altri un po di meno.
Facendo una stima, dei trematodi si conoscono circa 6000 specie ma solo una ventina interessano luomo.
Dei cestodi se e conoscono 5000 ma meno di 20 interessano di norma luomo. Cio fondamentalmente lo
stesso discorso dei funghi: di aspergillus conosciamo 250 specie ma solo 6/7 specie per quanto riguarda le
forme invasive e considerando anche quelle cutanee massimo una ventina di specie sono state descritte
come patogene per luomo.
Luomo tutto sommato ha un numero di parassiti riconosciuti abbastanza limitato.
I parassiti vanno conosciuti tutti uno per uno perch sono riconosciuti come agenti eziologici di malattia.
Nello studio che dovete fare vi suggerisco di cercare di legare insieme. Parlando di trematodi e cestodi gi
parliamo di due cicli biologici completamente diversi che poi magari si caratterizzano nella caratterizzazione
delle singole specie, nella differenza per gli ospiti intermedi, per la localizzazione geografica ma gi avete
unidea di base che riguarda tutta la classe e poi parassita per parassita focalizzerete la parte che pi vi
interessa.
I trematodi digenei sono tutti parassiti e quasi tutti i vertebrati possono essere ospiti di una o pi specie.
Morfologicamente i digenei differiscono dai monogenei per avere due ventose. Sono tutti ermafroditi
tranne i digenei ematici.
Lermafroditismo, cio il fatto che nello stesso individuo si sviluppano le gonadi maschili e le gonadi
femminili, stato un adattamento e unaffermazione dal punto di vista evolutivo nei parassiti perch il
parassita non sempre ha la possibilit dellincontro tra i due individui di sessi separati e quindi
lermafroditismo assicura comunque la riproduzione. Addirittura nei nematodi c una fase libera in cui gli
individui sono a sessi separati, cio il maschio e la femmina, mentre durante lo stato di parassitismo la
Microbiologia - Medicina e Chirurgia polo A 2012/2013 - sbobinature lezioni
187
femmina diventa partenogenetica cio capace da sola di produrre uova fecondate che daranno sviluppo
alle nuove larve.
Altro aspetto importante: alternanza di una moltiplicazione sessuata con produzione di uova e una
riproduzione asessuata allo stadio di larva. Questo un fatto importantissimo: molti parassiti allo stadio
larvale sono capaci di moltiplicarsi e quindi di aumentare il numero di individui e quindi avere pi
probabilit di raggiungere un ospite. Se alcuni parassiti non avessero avuto questi meccanismi di
riproduzione altamente efficienti si sarebbero estinti. Gli adulti occupano il tratto gastrointestinale, i dotti
biliari o il sistema vascolare dellospite definitivo.
Si passa a vedere i singoli generi.
Il genere schistosoma fatto da trematodi ematici a sessi separati e quindi fa eccezione rispetto a quello
che abbiamo detto. Ne conosciamo diverse specie (riportate nelle slide).
Vediamo le due ventose. Caratterizzazioni tipiche di tutti i trematodi sono la presenza di ventose con le
quali il parassita aderisce ai tessuti dellospite.
Si vede il dimorfismo sessuale, abbiamo la femmina e il maschio qui rappresentati (immagine). Lintestino
diviso in rami ciechi: c unapertura orale ma non c unapertura anale. Lintestino nei trematodi finisce a
fondo cieco, ci sono a volte due ramificazioni a fondo cieco. Sono presenti delle prime cellule che hanno
funzione legata a quello che poi sar il rene, ovvero funzione depurativa, infatti sono dei protonefriti.
Per schistosoma la localizzazione abbastanza localizzata per le varie specie: lo Iaponicum lo troviamo solo
in Cina e Filippine, e cos anche il Mansoni e lIntercalatum sono ben localizzati. Ogni specie ha la sua
localizzazione. Come mai avviene questo? Il perch si trova nel ciclo biologico illustrato in tabella (slide).
[Vi consiglio per quanto riguarda la parassitologia di visitare il sito del CDC o dellOMS].
bene che vi precisi un altro dato epidemiologico: noi qui vediamo un numero modesto di parassitosi ma
nel mondo le parassitosi interessano miliardi di persone. Dobbiamo tener conto che nei paesi a lento
sviluppo economico le parassitosi sono un fatto di notevole importanza. La mia esperienza con alcuni
bambini che venivano dal Nord Africa che facendo dei controlli un fatto normale trovare nelle feci 1 ma
anche 2-3 parassiti.
Vediamo il ciclo biologico del parassita schistosoma: partiamo dalle uova. Vedete due situazioni diverse che
riguardano da un lato lo schistosoma haematobium che trover principalmente nelle urine mentre lo
schistosama mansoni e japonicum si trovano nelle feci. O con le urine o con le feci vengono eliminate le
uova. Le uova sono molto tipiche, sono infatti le strutture che noi utilizziamo per la diagnostica di
laboratorio: si fa la ricerca delle uova nelle feci o nelle urine per la diagnosi di parassitosi. Le uova che
arrivano in acqua liberano una prima larva che il miracidio. Il miracidio viene catturato da chiocciole,
lumache dacqua nelle quali si ha la moltiplicazione dello stato larvale e nel frattempo si sono andate a
formare le cosiddette sporocisti. Il miracidio che viene catturato da questi primi ospiti intermedi dentro
questi ospiti si moltiplica formando sporocisti con le cosiddette redie. Dal mollusco si libera un altro stato
larvale, le cercarie. Le cercarie hanno una struttura con una coda, parte pi affusolata. La cercaria pu
penetrare attivamente attraverso la cute.
Qual il meccanismo dinfestazione (per i metazoi si parla di infestazione e non di infezione)?
Microbiologia - Medicina e Chirurgia polo A 2012/2013 - sbobinature lezioni
188
Quando un ospite, un uomo va in acqua nella quale sono presenti le cercarie rischia la parassitosi per causa
della penetrazione attiva delle cercarie attraverso la cute. Quando il parassita dentro dalla cercaria si
sviluppa lo schistosomulo che attraverso il circolo migra a livello del sangue portale nel fegato. Gli adulti
maturi maturano quando vanno a localizzarsi alcuni nel plesso mesenterico, altri nel plesso vescicale.
Avremo quindi la localizzazione a livello dei vasi nei quali il parassita pu andare incontro a riproduzione
sessuata e la femmina una volta che ha raggiunto la maturit libera le uova. Le uova vengono liberate o
nelle feci o nelle urine a seconda del plesso venoso in cui si sono localizzati i parassiti.
Della schistosomosi (i termini schistosomiasi, tricomoniasi ecc. oggi sono stati cambiati da -iasi a -osi) al
medico cosa interessa? Due cose sono importanti:
1) come entra il parassita. Questa parassitosi arriva perch la larva entra attivamente. La larva si trova
in acque dolci, non nel mare.
2) Cosa fa il parassita una volta entrato, con quale forma entra, come si trasforma, dove si localizza,
cosa esce e attraverso quali vie.
Queste sono le cose da sapere in questo corso. La patologia, la sintomatologia, le terapie sono cose che
vedremo pi avanti anche perch molte parassitosi non dico sono asintomatiche ma sono
paucisintomatiche proprio per il principio di adattamento del parassita alluomo.
Importanti sono le dimensioni del parassita.
Tutti i trematodi hanno un ciclo simile. Magari a volte invece di uno ci sono pi ospiti intermedi ma tutto
passa attraverso almeno questi due stati larvali, quello delle sporocisti e quello delle cercarie, oltre al
miracidio che la prima larva che si libera dalluovo. Gli stati larvali sono quindi molto caratteristici.
Sono stati diagnosticati casi di schistosomosi? Qualche caso stato diagnosticato in immigrati.
Altro trematode, la Fasciola Hepatica. un platelminta. Dalle immagini vediamo chiaramente la ventosa
ventrale, la ventosa orale. C una specie di faringe accennata e due tubi che sono praticamente i ciechi,
rappresentano lintestino. Questi parassiti sono ermafroditi e sviluppano in maniera evidente gli organi
genitali maschili e femminili quindi sviluppo della gonade maschile (testicoli) e anche della gonade
femminile (ovaio con tutti gli annessi, polo genitale, utero). Lermafrodita realizza la fecondazione
allinterno, da se stesso e quindi produce una progenie di uova fecondate.
La Fasciola Hepatica molto diffusa dove c pastorizia, ad esempio in Scozia. Luomo un ospite
accidentale perch il ciclo biologico del parassita si chiude con gli animali.
Guardiamo il ciclo biologico: bovini e ovini liberano con le feci uova non embrionate che si perdono. Le
uova invece embrionate che raggiungono lacqua sviluppano il miracidio. Il miracidio nella chiocciola d la
moltiplicazione larvale per cui dalla sporocisti si formano le redie, dalle redie si formano le cercarie. Le
cercarie vengono eliminate quando c nelle piante acqua (le lumache escono quando piove). La lumaca
libera le cercarie che si incistidano formando le metacercarie sulle piante, sullerba che sono poi mangiate
dagli erbivori. Allinterno dellerbivoro si sviluppa quindi il parassita adulto che dar origine al parassitismo.
La Fasciola Hepatica si chiama cos perch si localizza soprattutto a livello del fegato e quindi anche nelle vie
biliari. Abbiamo la possibilit che il ciclo continui. Un uomo che ha contratto la fasciola cosa ha mangiato?
Verdure contaminate crude (la cottura elimina il rischio).
Microbiologia - Medicina e Chirurgia polo A 2012/2013 - sbobinature lezioni
189
Di fatto questo rischio abbastanza raro (il prof qui a Catania non ne ha mai visto un caso). Per dove ci
sono territori ampi con ampi allevamenti e ci sono verdure consumate crude il rischio potrebbe esserci.
[Non bisogna ricordare i nomi delle specie degli ospiti intermedi, a noi interessa sapere grossomodo nel
ciclo biologico quali sono gli ospiti intermedi in termini generici ma soprattutto come luomo pu contrarre
la parassitosi].
Fasciolopsis buski ha lo stesso tipo di ciclo biologico di fasciola hepatica solo che fasciolopsis buski si trova
nelle aree orientali. L va a rischio di contrarre la parassitosi chi mangia il crescione, uninsalatina che si
mangia cruda nei paesi orientali. Il problema sta quindi nel mangiare alimenti crudi che possono essere
contaminati da metacercarie del parassita. Le metacercarie si formano perch le lumache infestate dal
parassita liberano le cercarie che senzacqua si trasformano nelle metacercarie che si incistidano nel
vegetale. Se cuciniamo le verdure non c nessun problema.
Paragominus, altro trematode. Il percorso lo stesso: dalluovo embrionato, il miracidio, la sporocisti, la
redia, la cercaria che si sviluppa nel crostaceo. Quando il crostaceo ingerisce la cercaria liberata dalla
chiocciola, la cercaria si sviluppa in metacercaria. Allora a questo punto il soggetto a rischio quello che
mangia crostacei crudi, ad esempio gamberi, granchi. La surgelazione un buon sistema per combattere
alcune forme larvali. Vale anche per la carne. La surgelazione e quindi la cristallizzazione in alcuni parassiti
porta a morte gli stati larvali presenti.
Opistorchis: in questo caso la metacercaria si trova nel pesce. Perch alcune specie di parassiti si trovano
solo in certi territori? Perch l hanno potuto realizzare tutto il ciclo vitale. Noi possiamo liberare tutte le
uova che vogliamo del parassita in acqua ma se nellacqua non c lospite intermedio la larva dura solo un
certo tempo.
Opistorchis felineus: Russia
Opistorchis viverrini: paesi orientali
La localizzazione legata al fatto che ci sono delle condizioni ambientali nelle quali ci sono non solo i
molluschi ma anche i pesci che permettono di realizzare il ciclo vitale. Lospite definitivo il mammifero,
non sempre solo luomo ma anche altri mammiferi che mangiando pesce crudo possono sviluppare il
parassita. Spesso il ciclo del parassita mantenuto da altri mammiferi, luomo accidentalmente entra nella
parassitosi perch si nutre in questo caso di pesce crudo.
Una volta inquadrato il ciclo biologico e dettagliate le vie del ciclo biologico utile sapere quali sono gli
alimenti che portano la parassitosi.
Nel Clonorchis sinenses sono chiamati anche i salmonidi e i ciprinidi come pesci, pesci che tutto sommato
consumiamo ma non c una grande diffusione di questa parassitosi qui dalle nostre parti.
Microbiologia - Medicina e Chirurgia polo A 2012/2013 - sbobinature lezioni
190
Attualmente sono stimate circa 40 milioni le persone affette da infestazioni da trematodi. I fattori di rischio
sono innanzitutto legati allo smaltimento dei rifiuti organici, la scarsa igiene e il consumo di piatti con pesce
crudo.
Le misure di controllo sono: ridurre la contaminazione fecale delle acque dolci (se noi sappiamo che sono le
feci eliminate dallospite definitivo a portare le uova nellambiente acquatico, se mettiamo sotto controllo
la contaminazione fecale delle acque dolci riduciamo enormemente il rischio) e ridurre il consumo dei
prodotti crudi.
Laltro gruppo oltre i trematodi sono i CESTODI.
I cestodi hanno unorganizzazione diversa rispetto ai trematodi. Per esempio le dimensioni dei trematodi
sono molto piccole, mezzo centimetro, massimo uno. Le dimensioni sono piccole anche perch i trematodi
si localizzano in fegato, vie biliari e qui non possono starci parassiti di grandi dimensioni. I cestodi che
vivono nellintestino raggiungono metri. Il Diphillobothrium latum ha il primato e pu raggiungere
addirittura i 10 m. Il parassita sta nel nostro intestino che lungo metri (7/8 m).
Il cestode ha una parte anteriore uncinata e delle specie di fossette (si riferisce allimmagine della slide).
Tutto questo secondo voi a cosa serve? Ad ancorare il parassita alla parete intestinale. Il cestode
organizzato in una maniera semplicissima, non ha neanche lintestino.
E come si nutre? Ha sviluppato una specie di sistema nel suo tegumento che fatto addirittura a villi per
aumentare la superficie di contatto con il nostro polo intestinale. Noi digeriamo e il parassita assorbe gli
alimenti da noi digeriti.
Vediamo la struttura di una Taenia. Ha struttura metamerica.
Un cestode fatto da uno scolice, un piccolo collo, uno strobilo fatto da proglottidi cio fatto da strutture
metameriche. Ogni proglottide una fabbrica di riproduzione.
Se andiamo a vedere una proglottide, quelle vicine al collo sono le pi giovani. La proglottide man mano
che si allontana dal collo matura. Cosa c nella proglottide? Si realizzano delle strutture primitive, anche di
collegamento, di tessuto nervoso. C un sistema riproduttivo ermafrodita: una gonade maschile e una
gonade femminile. La proglottide si trasformer in un utero pieno di uova fecondate. Questo
ladattamento parassitario: noi digeriamo, lui utilizza i nostri prodotti della digestione, li assorbe e cresce.
Ecco perch arriviamo a grandi dimensioni.
Gruppi allinterno dei cestodi:
1) Diphillobothrium latum: legato al consumo di pesce crudo, soprattutto era diffuso nel nord Italia
ma anche nel nord Europa dove ci sono i laghi. Il parassita si mantiene nel suo ciclo vitale perch ci
sono altri mammiferi. Luomo anche qui un ospite accidentale. Il Diphillobothrium latum ha
scolice diverso da quello di Taenia, non ha gli uncini, ha solo 2 solchi. Linfestazione diffusa tra
popolazioni che vivono in aree circostanti a laghi e fiumi. Il Diphillobothrium latum d tra le
complicazioni pi gravi lanemia megaloblastica perch depaupera lorganismo di vitamina B12.
Microbiologia - Medicina e Chirurgia polo A 2012/2013 - sbobinature lezioni
191
Prevenzione: - cottura del pesce. I plerocercoidi vengono devitalizzati a 50 per almeno 10 minuti
(attenzione: non sempre alla brace la parte interna raggiunge i 50 e per 10 minuti). congelamento: -18
per 24 ore, -10 per 72 ore.
2) Hymenolepis: se ne conoscono due specie, i nana e i diminuta. Le Hymenolepis contrariamente alle
taenie e al diphillobothrium sono pi piccole, la nana 1-4 cm, la diminuta arriva fino a 60 cm.
Il verme adulto si pu osservare quando eliminato dallospite. Uninfestazione lieve asintomatica. A
volte accidentalmente si trovano queste uova nelle feci.
Lhymenolepis fondamentalmente parassita di roditori. Lospite intermedio un insetto che aggredisce i
roditori. Nelluomo linsetto un fatto eccezionale perch ciene ingerito accidentalmente.
Tra le uova ogni tanto si trova qualche artefatto vegetale.
3) Taenie: sono abbastanza diffuse da noi. Delle tenie ricordiamo le due specie, solium e saginata che
hanno due ospiti intermedi di cui noi ci nutriamo, il maiale per il solium e i bovini per la saginata.
Luomo lospite definitivo di Tenia solium e tenia saginata. Abbiamo lunghezze dellordine dei metri,
dipende da dove si attacca lo scolice. Fondamentalmente linfestazione avviene per ingestione di carni
crude o poco cotte.
A parte lospite intermedio, maiale per solium e bovino per saginata, dal punto di vista diagnostico e delle
complicazioni patogenetiche ci sono delle differenze.
Tenia saginata ha la proglottide con motilit propria che addirittura riesce a forzare lo sfintere anale e a
uscire spontaneamente dallano.
Quando c stato il periodo della mucca pazza e non si pi mangiata carne proveniente dai macelli
controllati ma dalla pastorizia locale si sono verificati casi di tenia saginata. Chi che lascia le uova nel
terreno? luomo che elimina le proglottidi nel territorio. Gli animali, maiale e bovino, completano il ciclo.
Con lallevamento difficile che questo avvenga perch il sistema di alimentazione molto controllato.
Infatti possibile che queste parassitosi prima o poi finiranno perch dipendono dal modo con cui ci
organizziamo. Queste parassitosi sono mantenute in territori dove la pastorizia diffusa.
Tenia solium pu dare complicazioni perch la proglottide esce passivamente e si pu rompere nella bolla
rettale e vengono cos eliminate le uova. Le uova di tenia solium hanno la capacit di aderire alle pliche
anali e possono restare adese. Col test dello scotch si trovano le uova. Se il soggetto che ha infestazione da
tenia solium e per motivi di scarsa igiene dovesse ingerire uova di tenia solium, luomo diventa ospite
intermedio rischiando anche una neurocisticercosi che una forma molto rara. Cio il cisticeppo che si
forma nel maiale in questo caso si forma nelluomo. Il rischio dellinfestazione da tenia solium nelluomo il
rischio di unauto-infestazione per cui nelluomo si svilupper la forma larvale e non quella delladulto.
Si distinguono le proglottidi di tenia solium e tenia saginata molto di pi che non le uova. Le uova sono
molto difficili da distinguere. Le proglottidi si distinguono soprattutto come ramificazioni dellutero (la
solium ha un sistema di ramificazioni minore).
Microbiologia - Medicina e Chirurgia polo A 2012/2013 - sbobinature lezioni
192
Queste immagini (slide) si ottengono iniettando dentro la proglottide un colorante di contrasto che riempie
lutero e permette di controllare le ramificazioni. Per identificare le specie si pu fare anche la
diafanizzazione in acido acetico.
Echinococcus soprattutto lechinococcus granulosus si trova da noi (il multilocularis praticamente da noi
non c). Il caso dellechinococco un caso particolare. Anche questo diffuso dove c pastorizia,
soprattutto gli ovini. Quindi la Sicilia, la Sardegna, la Toscana, il Lazio, Lechinococcus granulosus una
tenia molto piccola ed la tenia del cane. Il ciclo biologico si svolge tra il cane che lospite definitivo e la
pecora che lospite intermedio. Fondalmentalmente per lo stato larvale di questo echinococco
rappresentato dalla cosiddetta cisti idatidea: si forma una struttura che cresce progressivamente dentro la
quale il parassita moltiplica lo stato larvale. Qual il rischio per luomo? Non tanto quello dellospite
definitivo ma quello di diventare un ospite intermedio cos come gli ovini. Quando il cane che elimina le
uova riesce a esporci allinfestazione e luomo sinfesta avviene un fatto veramente grave e spiacevole
perch lo sviluppo della cisti idatidea uno sviluppo di organo: fegato, cervello, pu anche esserci a livello
cardiaco e non facile da curare perch il soggetto inizialmente non se ne accorge, quando viene fatta
diagnosi in stato avanzato, non sempre lintervento chirurgico risolutivo al primo intervento perch si
cerca di fare la migliore pulizia possibile ma se non si riesce s eliminare tutta la cisti questa si riforma.
Talvolta sono necessarie due, tre operazioni chirurgiche.
Il prof mostra immagini di protoscolici invaginati in forma larvale che poi daranno origine alla cisti idatidea.
Queste forme larvali si possono trovare nei tessuti.
Allora abbiamo visto platelminti: trematodi e cestodi. Sono molto diversi. Nei trematodi abbiamo tutte
quelle forme larvali e tutti quegli ospiti intermedi, nei cestodi la cosa pi semplice, c un ospite
intermedio, uno stato larvale, un ciclo abbastanza semplice per con aspetti diversi.
Nel caso dei Nematodi anche qui avremo un gruppo di parassiti che nella fattispecie sono parassiti
intestinali e un altro gruppo di specie che hanno localizzazione diversa, anche ematica, o sottocutanea, o a
livello oculare ecc.
Nematodi:
-
non sono pi vermi piatti ma cilindrici
estremit assottigliate
simmetria bilaterale
intestino completo con unapertura orale e una anale
hanno sessi separati
Microbiologia - Medicina e Chirurgia polo A 2012/2013 - sbobinature lezioni
-
193
compare una muscolatura primitiva e quindi hanno tessuto muscolare e nervoso pi evoluto.
I nematodi sono pi evoluti.
Nel caso dei nematodi individuiamo due grandi sottoclassi (Adenophorea e Secernentea) ma di cui ci
interessa poco. Dobbiamo invece tener conto che a parte lEnterobius che rientrerebbe sempre in questo
gruppo in cui principalmente troviamo parassiti intestinali, in questaltro gruppo troviamo invece le
cosiddette filaghe. Le filaghe hanno localizzazione varia, anche quella ematica.
Dei nematodi ci sono oltre 500 milioni di specie, i cui 7000 parassitano piante e animali, una ventina
parassitano luomo.
I nematodi in agricoltura hanno un impatto notevolissimo, ad esempio alcuni impianti di agrumeti
necessitano che prima il terreno sia disinfestato dalla presenza di nematodi perch possono causare danni
allagricoltura.
I cicli dei nematodi sono apparentemente abbastanza semplici ma qualche particolare va sottolineato.
Ciclo: gli stati larvali nei nematodi si svolgono allinterno di questa struttura che luovo. Linfestazione
avviene per ingestione di uova nelle quali ci sono le larve. La larva nei nematodi ha diversi stadi, L1, L2 e L3.
Cosa avviene nel caso di Ascaris lumbricoides? La prima larva migra dallintestino ai polmoni attraverso il
circolo e questa migrazione serve a realizzare la maturazione della larva. Per un adattamento del parassita
a situazioni ancestrali il parassita ha bisogno di arrivare a livello dei bronchi e dei polmoni perch la larva
fuoriesce dalle vie respiratorie, stimola colpi di tosse, c anche una risposta allergica simil asmatica. La
larva poi viene ingerita nuovamente e portata nellintestino dove dar origine allo sviluppo delladulto.
Quindi ci sono dei parassiti che hanno delle migrazioni allinterno del nostro organismo. Dal punto di vista
sintomatico ci sono delle manifestazioni che vanno tenute in considerazione, per esempio se il paziente ha
uneosinofilia alta.
Ascaris il prototipo di quelle che noi possiamo chiamare le geoelmintiasi. Sono legate allambiente
contadino: i contadini defecavano a campo aperto e lasciavano nel territorio le uova. Le uova poi venivano
contaminando verdure, ortaggi. Quindi la geoelmintiasi realizzata con la fertilizzazione dei suoli. Avendo
sviluppato unorganizzazione sociale migliore non abbiamo pi di questi problemi ma dove ci sono
popolazioni che vivono in queste condizioni le geoelmintiasi sono ancora un problema serio.
Lenterobius vermicularis si adattato in maniera diversa. La trasmissione di enterobius quasi da
soggetto parassitato a soggetto sano. Come? La femmina adulta migra durante la notte allapertura anale e
depone attorno allano le uova. Deposte le uova muore. Queste uova portano prurito intenso. Di notte
quindi si portati a grattarsi o direttamente con le dita o con la biancheria. Questo fa in modo che le uova
che hanno lo strato esterno con alta adesivit si appiccicano nelle dita, nella biancheria per cui
inevitabilmente toccando facile che si diffonda linfestazione per esempio nellambiente familiare.
Quando ci sono casi di psoriasi nei bambini viene trattata tutta la famiglia perch la probabilit di diffusione
dellinfestazione alta. Questa parassitosi legata come la giardiasi allet pediatrica-scolare.
Lo sviluppo larvale avviene tutto dentro luovo quindi lingestione delluovo porta allo sviluppo delladulto
che a livello del cieco si accoppia e si ha la diffusione.
Microbiologia - Medicina e Chirurgia polo A 2012/2013 - sbobinature lezioni
194
Trichuris trichiura d geoelmintiasi.
Il parassita si attacca allintestino per non farsi eliminare con la peristalsi intestinale. Il verme ha la parte
pi sottile dentro le pliche e la parte pi caudale pi ampia dove ci sono gli organi riproduttori rivolta verso
il lume intestinale.
Ancylostoma duodenale: penetrazione attiva della larva attraverso la cute.
Strongyloides stercoralis: ( bene farlo con attenzione) si notato che la possibilit che ha il parassita di
restare a lungo tempo nellospite trova negli stati di immunodepressione, causati anche da un trapianto
dorgano, la possibilit di riattivazione con una infestazione molto grave. In Italia, soprattutto al nord, sono
stati dimostrati parecchi casi di questi.
Ciclo biologico: lo strongyloides ha uno stadio a vita libera nel quale realizza il dimorfismo sessuale quindi
maschi e femmine che si riproducono e danno luogo alle uova, alle larve e quindi nuovamente alladulto.
Quindi c questo ciclo naturale che mantiene il parassita nel territorio. Quando si forma la larva
filariforme, quindi di terzo grado, questa larva pu penetrare attivamente la cute e poi il parassita pu
andarsi a sviluppare soprattutto nelle vie intestinali. Lo strongyloides stercoralis elimina larve nelle feci, noi
non troviamo uova ma bens troviamo larve. Chi fa un esame parassitologico delle feci e cerca solo uova
limita il suo esame. Un esame parassitologico completo dovrebbe riguardare anche la ricerca delle larve. Vi
sono tecniche molto specifiche di laboratorio per fare la concentrazione delle larve o comunque per
evidenziare meglio queste larve. Ecco perch Strongyloides stercoralis spesso passa inosservato.
La Trichinella spiralis un parassita che si incistida nei muscoli. Luomo diventa un ospite intermedio.
A partire dagli anni 50, 60 ci si occupati di questa parassitosi per cui i veterinari sono obbligati prima
della macellazione a controllare le carni per la presenza di questo parassita perch lunico modo per
prevenire la parassitosi la prevenzione. Nel momento in cui la parassitosi si dovesse sviluppare nelluomo
sono problemi seri dato che non si possono togliere dai muscoli a una a una tutte le larve.
Lanisakis un altro nematode che si trova nel pesce azzurro. Lanisakis nelluomo si incistida a livello
intestinale. Quando molto grave si pu intervenire chirurgicamente. Lanisakis non parassita delluomo.
Accidentalmente contamina luomo.
La sindrome della larva migrans, la toxocara canis. I cuccioli di cane vanno sverminati perch c un
parassita che trasmesso dalla madre. Se luomo subisce linfestazione dallo stato larvale realizza la
sindrome da larva migrans: la larva non avendo lospite giusto migra lungo i tessuti. Leosinofilia raggiunge
anche il 40%.
Microbiologia - Medicina e Chirurgia polo A 2012/2013 - sbobinature lezioni
195
[Rilevare tutte queste piccole caratterizzazioni. Non approfondire la nomenclatura degli ospiti intermedi.
Importantissime sono via di ingresso, localizzazione e via di uscita. Lasciare stare le terapie per i platelminti.
Per i protozoi invece vale la pena qualche indicazione sui farmaci attivi].
Potrebbero piacerti anche
- Principi Di Microbiologia Medica 10ed - La Placa - EsculapioNessuna valutazione finoraPrincipi Di Microbiologia Medica 10ed - La Placa - Esculapio876 pagine
- 22 - Anatomia II - 22.03.2017 - RNessuna valutazione finora22 - Anatomia II - 22.03.2017 - R8 pagine
- 01 Fisiologia Degli Apparati IntroNessuna valutazione finora01 Fisiologia Degli Apparati Intro26 pagine
- Biologia - Molecolare - Traduzione e Regolazione TrascrizioneNessuna valutazione finoraBiologia - Molecolare - Traduzione e Regolazione Trascrizione44 pagine
- 30 - Anatomia II - 26-04-2017 - RNessuna valutazione finora30 - Anatomia II - 26-04-2017 - R11 pagine
- Nuova Dispensa Cliniche Chirurgiche AK 2021-2022Nessuna valutazione finoraNuova Dispensa Cliniche Chirurgiche AK 2021-2022239 pagine
- Biologia - Riassunti Di Karp, "Biologia Cellulare e Molecolare"100% (3)Biologia - Riassunti Di Karp, "Biologia Cellulare e Molecolare"75 pagine
- Microbiologia Professioni SanitarieNessuna valutazione finoraMicrobiologia Professioni Sanitarie45 pagine
- Appunti Di Microbiologia GeneraleNessuna valutazione finoraAppunti Di Microbiologia Generale18 pagine
- MICROBIOLOGIA Prof Scalia Università Di CataniaNessuna valutazione finoraMICROBIOLOGIA Prof Scalia Università Di Catania19 pagine
- Zucchero Cosc3ac Celeste Spartito Per Pianoforte PDFNessuna valutazione finoraZucchero Cosc3ac Celeste Spartito Per Pianoforte PDF2 pagine
- Richiesta Di Cessazione (Agosto 16)Nessuna valutazione finoraRichiesta Di Cessazione (Agosto 16)3 pagine
- Guida Alla Compilazione Dell'AutocertificazioneNessuna valutazione finoraGuida Alla Compilazione Dell'Autocertificazione3 pagine
- Metabolismo Cellulare, Glicolisi, Ciclo Di Krebs, Fosforilazione Ossidativa, Metabolismo Lipidi, Metabolismo ProteineNessuna valutazione finoraMetabolismo Cellulare, Glicolisi, Ciclo Di Krebs, Fosforilazione Ossidativa, Metabolismo Lipidi, Metabolismo Proteine11 pagine
- Guida CIA - MODERNA GESTIONE DEL VERDE ARBOREO ORNAMENTALE100% (2)Guida CIA - MODERNA GESTIONE DEL VERDE ARBOREO ORNAMENTALE37 pagine